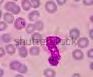

Природничі науки



Максим Рудич, Вікторія Щербина, Ігор Ненашев, Зінаїда Ворона «Природничі науки»
підручник інтегрованого курсу для 6 класу закладів загальної середньої освіти
Видавництво «Ранок»
Створено відповідно до модельної навчальної програми
«Природничі науки. 5—6 класи (інтегрований курс)» для закладів загальної середньої освіти (авт. Білик Ж. І., Засєкіна Т. М., Лашевська Г. А., Яценко В. С.)
ПРИРОДНИЧІ
Інтегрований курс
Підручник
для 6 класу

закладів загальної
середньої освіти
Рекомендовано
Міністерством освіти і науки України
rnk.com.ua/102697
Електронний
інтерактивний додаток
до підручника
Харків
Видавництво «Ранок»
2023
ВСТУП
§ 1. Єдність природничих наук..................................................................6
РОЗДІЛ 1. Досліджуємо живе
§ 2. Гіпотези походження життя на Землі ..................................................8
§ 3. Ознаки живого ................................................................................11
§ 4. Клітина — одиниця живого. Основні положення клітинної теорії .......13
§ 5. Як вивчають клітини .......................................................................16
§ 6. Клітина, її будова ............................................................................18
§ 7. Порівняння рослинної і тваринної клітини (урок-дослідження) ...........20
§ 8. Одноклітинні організми та колоніальні організми ..............................22
§ 9. Багатоклітинні організми .................................................................26
§ 10. Живлення в рослин........................................................................29
§ 11. Живлення й травлення в тварин .....................................................31
§ 12. Дихання. Процеси, що відбуваються під час дихання .......................34
§ 13. Транспорт речовин. Кровоносна система ..........................................37
§ 14. Процес виділення ...........................................................................40
§ 15. Нервова система та нервова регуляція. Поняття про гуморальну регуляцію ..............................................................44
§ 16. Розмноження та його значення. Статеві клітини.
Розмноження в рослин і тварин ......................................................47
§ 17. Ріст. Обмежений і необмежений ріст ...............................................50
§ 18. Розвиток. Докази розвитку рослин, проростання насінини ................53
§ 19. Розвиток тварин. Непрямий розвиток на прикладі комах .................56
§ 20. Прямий розвиток тварин на прикладі людини .................................59
§ 21. Роль ДНК в організмах ..................................................................61
РОЗДІЛ 2. Досліджуємо Землю та життя на Землі
§ 22. Уявлення людей про форму Землі в минулому .................................65
§ 23. Дослідження Землі .........................................................................68
§ 24. Сучасні дослідження Землі .............................................................71
§ 25. Способи зображення Землі. Глобус — модель Землі ..........................73
§ 26. Земля на плані й карті...................................................................75
§ 27. Елементи географічної карти ..........................................................77
§ 28. Математична основа карти ..............................................................80
§ 29. Градусна сітка на глобусах і картах. Географічні координати ............82
§ 30. Орієнтування на місцевості .............................................................85
§ 31. Гіпотези утворення Землі. Вплив Місяця .........................................87
§ 32. Внутрішня будова Землі. Літосфера .................................................89
§ 33. Походження материків і океанів. Геологічний літопис Землі .............92
§ 34. Ендогенні (внутрішні) процеси ........................................................94
§ 35. Екзогенні процеси ..........................................................................97
§ 36. Гірські породи й мінерали ............................................................100
§ 37. Рельєф і його зображення на карті. Планетарні форми рельєфу ......103
§ 38. Рівнини світу та України .............................................................105
§ 39. Гори світу й України ...................................................................107
§ 40. Атмосфера — повітряна оболонка Землі ........................................110
§ 41. Атмосферний тиск........................................................................113
§ 42. Рух повітря внаслідок його нагрівання й охолодження. Вітер .........115
§ 43. Властивості води. Вода в повітрі ...................................................118
§ 44. Гідростатичний тиск. Виштовхувальна сила. Плавання тіл .............121
§ 45. Хмарність та опади ......................................................................123
§ 46. Теплові, оптичні й електричні явища в атмосфері ..........................125
§ 47. Погода. Метеорологічні спостереження. Несприятливі погодні умови 127
§ 48. Клімат. Кліматичні пояси .............................................................129
§ 49. Гідросфера — водна оболонка Землі ..............................................131
§ 50. Світовий океан і його частини ......................................................133
§ 51. Рельєф дна Світового океану. Острови та півострови .......................136
§ 52. Властивості вод Світового океану ..................................................138
§ 53. Рух води в океані. Взаємодія атмосфери й океану ..........................140
§ 54. Мешканці морів й океанів. Пристосування рослин
і тварин до життя у воді ..............................................................143
§ 55. Води суходолу. Річки ...................................................................146
§ 56. Озера ..........................................................................................149
§ 57. Умови життя у прісних водоймах
§ 58. Болота
§ 59. Умови життя болота .....................................................................157
§ 60. Лід у природі Землі. Льодовики
§ 61. Підземні води — наше багатство
§ 62. Штучні водойми...........................................................................165
§ 63. Біосфера — оболонка життя на Землі ............................................167
§ 64. Організм як середовище існування. Поняття про паразитизм ..........169
§ 65. Екосистеми ..................................................................................172
§ 66. Колообіг води, вуглекислого газу й кисню в біосфері ......................174
§ 67. Ґрунти й умови їхнього утворення ................................................176
§ 68. Географічна оболонка ...................................................................179
§ 69. Ліс ..............................................................................................182
§ 70. Степ, лісостеп ..............................................................................185
§ 71. Висотна поясність. Умови життя в горах .......................................188
§ 72. Походження людини ....................................................................194
Підбиваємо підсумки «Ми досліджуємо Землю та життя на Землі»..........191
РОЗДІЛ 3. Досліджуємо діяльність людини
§ 73. Населення планети .......................................................................196
§ 74. Розміщення населення на Землі. Населені пункти ..........................199
§ 75. Речовини й ресурси, що використовує людина ...............................202
§ 76. Природні й синтетичні матеріали ..................................................204
§ 77. Техніка і технології, що розробила людина.
Дослідження людиною космосу .....................................................206
§ 78. Медичні та хімічні технології .......................................................210
§ 79. Харчові технології. Агротехнології ................................................212
§ 80. Вплив людини на навколишнє середовище .....................................214
§ 81. Охорона природи й навколишнього середовища в Україні та світі ...217
§ 82. Сталий (збалансований) розвиток ..................................................220
Підбиваємо підсумки «Ми досліджуємо діяльність людини» ....................222
Шановне українське учнівство!
У 6 класі ви продовжуєте знайомство з природничими науками. Сподіваємось, що вони вже здобули вашу прихильність. А це означає, що ви з цікавістю будете опановувати нові знання. Ми з величезним задоволенням будемо вам у цьому допомагати.
Ознайомтеся зі структурою підручника.
На початку параграфів пропонуємо пригадати матеріал, який ви вивчили раніше, та поміркувати над проблемними питаннями.
Рубрика «Природнича загадка» — це запитання для обговорення
під час вивчення нового матеріалу, яке може потребувати використання додаткових джерел інформації.
У рубриці «Дізнайтеся більше» ви можете прочитати цікаву інформацію, пов’язану з вивченим матеріалом, а також про світових та українських вчених.
У кінці кожного параграфа є рубрика «Ключова ідея», що містить головні думки та висновок.
«Запитання і завдання» допоможуть вам перевірити й закріпити набуті знання. Зверніть увагу, що є запитання, над якими слід поміркувати та скористатися додатковими джерелами інформації.
Наприкінці підручника є «Додатки» з картами, які вам знадобляться під час роботи.
У кінці розділів пропонуються компетентнісні завдання за вивченим матеріалом. Це завдання проблемно-пошукового змісту, на які, можливо, буде непросто одразу дати відповідь. Завдання можна виконувати індивідуально, парами або малими групами. Деякі з них можна взяти як основу для проєктної роботи.
Вивчати природу, спостерігати за нею та аналізувати все, що відбувається з нами та всім навколо, не завжди просто. Саме тому ми спробували зробити складні поняття простими, використовуючи для цього різноманітні цікавинки.
Життя навколо — дивовижне й прекрасне.
Відкрийте для себе світ природничих наук.
Досліджуйте, навчайтеся, здобувайте нові знання!
Ви готові до захопливої пригоди? Тоді вперед!
y Чому географію, біологію, хімію, фізику й астрономію ми відносимо до природничих наук? Що їх об’єднує?
y Чому важливо вивчати природничі науки?
y Що є предметом вивчення біології?
y Що вивчає географія?
y З якою метою проводять прикладні наукові дослідження?
загадка Британська компанія «BeBionic» створила протез, що імітує природні рухи руки людини. Пристроєм, який
складається з 14 надточних двигунів і 337 механічних елементів, керує комп’ютер.
Завдяки яким галузям науки
стало можливим створення такого протезу? Як такі винаходи покращують життя людини?
Наукові дослідження є формою існування і розвитку будь-якої науки. Їх поділяють на фундаментальні дослідження (діяльність, спрямована на одержання нових знань про закономірності розвитку природи, суспільства, людини) та прикладні дослідження, з якими ви вже почали знайомитися в 5 класі. І саме їх найчастіше використовують у природничих науках: біології, хімії, фізиці, астрономії, географії, екології.
Але існують і такі галузі науки, як біохімія, геофізика, біогеографія, астробіологія і багато інших, які також вважають природничими науками та які здійснюють відповідні прикладні дослідження.
Першою значущою книгою з природничих наук уважають працю «Про природу речей» давньоримського поета й філософа Тита Лукреція Кара, який жив у І столітті до н. е.
У поемі було висловлено передові для того часу ідеї і погляди на природу. Лукрецій припустив, що Всесвіт створений та існує без допомоги богів, що матерія складається з дуже маленьких частинок, які перебувають у безперервному русі, випадково стикаються й починають рухатися в іншому напрямку.
Завдяки італійцю Поджо Браччоліні в XIV столітті цю книгу, забуту за часів Середньовіччя, знову була відкрито.
Останні п’ятсот років природничі науки змінювали наше життя та мислення набагато швидше, ніж у попередній період розвитку людської цивілізації.
Видавництво «Ранок»
Сьогодні поступово «розмиваються» та зникають межі між різними науками, і чіткого розподілу, що саме має вивчати певна наука, не існує. Прикладні наукові дослідження стають міждисциплінарними, тобто такими, що стосуються двох або більше наук. Це — біогеохімічні методи пошуку корисних копалин, фізико-хімічні дослідження якості води, біогенетична інженерія, яка вивчає модифікацію живих істот тощо. Прикладом таких досліджень є створення генетично модифікованого цукрового буряка, стійкого до гербіцидів.
А от біоніка (від грец. bion — елемент життя, живе) — відносно молода наука, яка тісно пов’язана з живою природою. Вона застосовує
в техніці, архітектурі та дизайні знання про конструкцію, форму і процеси, що відбуваються в біосистемах. Так, швейцарський інженер Жорж
де Местраль особливості будови плодів будяка використав для розробки застібки-липучки, яку ви можете побачити на одязі чи взутті (мал. 1.1).
Мал. 1.1. Будяк (Carduus) — рід рослин із родини айстрових, широко поширений в Україні
1. Що об’єднує всі природничі науки?
2. Чим фундаментальні дослідження відрізняються від прикладних наукових досліджень?
3. Уявіть, що ви біохімік/біохімікиня. Запропонуйте напрямки та наведіть приклади ваших досліджень. У яких галузях господарства можна використати їхні результати?
Ключова ідея

Природничі науки вивчають різні аспекти природи. Вони ґрунтуються на прикладних наукових дослідженнях, які спрямовані на одержання й використання нових знань для практичних цілей. Чіткі межі між різними науками поступово зникають, тому сьогодні переважають міждисциплінарні дослідження. Усі сучасні технології певним чином використовують явища та закони природничих наук.
Дізнайтеся більше
Біогеохімія вивчає хімічний склад живої речовини, її вплив на поширення хімічних елементів на Землі, розподіл і розміщення елементів
у земній корі, тобто геохімічні процеси в біосфері. Жива речовина — це сукупність усіх
4. Використавши метод скрайбінгу (метод розповіді, що супроводжується графічною ілюстрацією) й додаткові джерела (зокрема інтернет), наведіть приклади використання біоніки для прикладних розробок. Зверніть увагу на важливість вивчення аналогій (подібностей) у живій і неживій природі. Створіть інформаційний лист, брошуру, стінгазету чи відео. Проведіть скрайбінг-сесію або організуйте виставку робіт.
5. Які винаходи з’явилися завдяки природничим наукам?
живих організмів на планеті. Основоположником біогеохімії вважають видатного українського науковця Володимира Івановича Вернадського. 1918 року він відкрив у Києві першу у світі біогеохімічну лабораторію.
y Чому більшу частину часу існування цивілізації люди вірили в божественне походження життя?
y Чи можливе життя на інших планетах?

y Що таке гіпотеза?
y Що таке молекула?
Що було першим: яйце чи курка?
Що було першим: яйце чи курка? Це питання цікавило людство з давніх-давен.
У стародавніх індійських міфах яйце є первинним, а курка — вторинною. У них навіть описано походження Всесвіту із Золотого яйця. А яйце, у свою чергу, було народжене великою силою вогню, що зародився в темних водах океану. Із Золотого яйця виник Брахма, який потім створив Всесвіт, землю, людей і все живе.
У християнських писаннях стверджується, що Всесвіт і все живе й неживе створив Бог: «І був вечір, і був ранок, день четвертий. І сказав Бог: “Нехай вода вироїть дрібні істоти, душу живу, і птаство, що літає над землею під небесною твердю”».
Отже, перша гіпотеза походження живого на Землі: життя було створене надприродними силами (істотами) у певний час. Її підтримує більшість прихильників різноманітних релігійних учень. Зверніть увагу, що гіпотеза (засновок) є ймовірним припущенням. А його достовірність не перевірена і не доведена.
Чи може крокодил народитися з мулу?
Давньогрецький філософ Аристотель, який заклав основи біології
Важливим і потужним мотивом розвитку науки є прагнення чогось нового, поза межами нашого досвіду. І питання щодо появи життя на Землі завжди спонукало людство до пошуків.
Ще стародавні вчені розпочали пошуки відповідей на запитання щодо походження життя і світу в цілому. З’явилася гіпотеза, що виникнення будь-яких живих істот — це суто природний процес. Тобто все живе утворилося в результаті діяльності природних сил, а не боже-
ственних. Так, стародавні єгиптяни вважали, що з мулу в річці Ніл утворюються жаби, миші та, навіть, крокодили!
Давньогрецький філософ Аристотель у IV столітті до н. е. припустив, що молюски, черви й комахи розвиваються з гниючого м’яса, підтверджуючи тим самим гіпотезу самозародження (спонтанного зародження) життя.
Ця гіпотеза була панівною впродовж багатьох століть. Але в середині XVII століття її спростував італійський науковець Франческо Реді, а згодом і французький біолог і натураліст Луї Пастер.
Ще одна гіпотеза походження Землі припускає, що Земля існувала вічно, тобто ніколи й не виникала. Живі організми також існували завжди і майже не видозмінювалися, хіба що змінювалася їх чисельність або вони вимирали. Це так звана гіпотеза стаціонарного стану.
Наприкінці ХІХ століття шведський хімік Сванте Август Арреніус припустив, що життя потрапило на Землю з космосу (мал. 2.3). За його гіпотезою зародки життя у вигляді мікроскопічних частинок-спор поширюються у Всесвіті та потрапляють на планети (докладніше про спори ви дізнаєтеся, коли вивчатимете розмноження організмів). Цю гіпотезу підтримував і український
Франческо Реді провів експеримент зі шматочками м’яса та скляними посудинами.
Дві з них він закрив корком і марлею, а одну залишив відкритою. Результат того, що сталося через декілька днів, зображено на малюнку.
Поясніть хід думок Реді, який довів, що мухи зароджуються з яєць, які відкладають інші
мухи, а не із самого м’яса. Експеримент Ф. Реді Личинки мух
Відкрита посудина
Личинки з’являються на м’ясі
Закрита посудина
Личинки на м’ясі відсутні
Личинки




мух
Мал. 2.3. За гіпотезою Сванте Арреніуса зародки життя поширюються у Всесвіті від однієї планети до іншої
Закрита посудина
Личинки на м’ясі відсутні
Розділ 1. Досліджуємо світ науки

1. Як можна довести чи спростувати гіпотезу?
2. Яка гіпотеза походження життя на Землі була першою і чому?
3. Чи можливе існування життя поза межами Землі?
4. Уважають, що на питання про походження життя на Землі ще немає відповіді. Чому, адже існує багато гіпотез?
5. Яку гіпотезу походження життя на Землі підтримуєте ви і чому?
6. Яку гіпотезу ілюструє фреска «Створення Адама» видатного італійського митця Мікеланджело Буонарроті на стелі Сікстинської капели? З мережі Інтернет дізнайтеся про інші роботи Мікеланджело Буонарроті.
науковець В. І. Вернадський. Противники гіпотези вважають, що будь-який живий організм не може потрапити на Землю, оскільки загинув би від космічного холоду та випромінювання.
2006 року після отримання результатів дослідження речовини з комети Tempel-1, з’ясувалося, що в ній наявна вода і прості органічні сполуки. Це означає, що існує можливість перенесення життя у Всесвіті кометами й іншими космічними об’єктами. Більшість сучасних науковців і науковиць підтримують гіпотезу біохімічної еволюції. Відповідно до цієї гіпотези, життя на Землі виникло природним шляхом: із простих неорганічних молекул почали утворюватися складні органічні сполуки, що могли відтворювати себе. Цей тривалий процес спричинив перетворення окремих органічних молекул на перших примітивних живих істот. Це дало поштовх розвитку органічного світу Землі та процесу біологічного природного добору.
Ключова ідея
Існує багато гіпотез виникнення життя на Землі. Найпоширенішими з них є: створення життя надприродною силою в певний час, самозародження (спонтанного зародження) життя, стаціонарного стану, занесення життя на нашу планету з космосу, біохімічної еволюції.
Дізнайтеся більше 1953 року американські дослідники Стенлі Міллер та Гарольд Юрі здійснили експеримент. За допомогою герметичного скляного приладу було відтворено умови, які існували на Землі в найдавніші часи. Через суміш газів, що складалася з метану, амоніаку й водню, пропускали електричні розряди. Вода на дні приладу, що була імітацією первинного океану, нагрівалася. За певний час вчені виявили в цій замкненій системі амінокислоти, що доводило можливість утворення органічних молекул із неорганічних.
Видавництво
Для всіх живих організмів характерні певні ознаки (властивості). Але живе відрізняється від неживого не за наявністю якоїсь однієї властивості, а за їх сукупністю (множиною). Тобто, якщо розглядати кожну з характеристик живого окремо, то її можна знайти і в деяких неживих об’єктів. Якщо ж об’єкт має певний набір цих властивостей — він живий.
Якщо людство колонізує Марс і Венеру, чи утвориться після
цього на цих планетах біосфера?
y Що вивчає біологія?
y Що таке біосфера?
y Яка відмінність органічних речовин від неорганічних?
Ознаки живого
Ознака Характеристика
Певний хімічний склад
Клітинна
структура
Обмін речовин
та енергії
Здатність до саморегуляції
Фундаментом живих організмів є органічні та неорганічні речовини. Найпоширенішими хімічними елементами живого є: вуглець (С), водень (Н), кисень (О) і азот (N). Ці елементи ще називають органогенами, адже вони становлять основу організмів
Живі організми складаються з клітин — це основні структурно-функціональні одиниці живого. Неживим об’єктам ця властивість непритаманна
Живі системи постійно обмінюються з довкіллям речовинами та енергією, що потрібні для підтримання їхньої життєдіяльності. Обмін можливий завдяки процесам дихання, живлення, виділення тощо
Об’єктам живої природи властиво контролювати температуру, тиск, утворювати й засвоювати біологічно активні речовини, що впорядковують роботу всього організму
Подразливість
Здатність
Живі організми здатні реагувати на зміни в довкіллі та всередині самого організму завдяки нервовій системі. Одноклітинні організми, рослини та гриби не мають нервової системи, але можуть активно змінювати свою життєдіяльність під впливом зовнішніх факторів (подразників)
до розмноження Дозволяє відтворювати собі подібних
Здатність
до росту
й розвитку
Багаторівневість організації
Упродовж свого існування живі об’єкти видозмінюються: ускладнюється
їхня внутрішня будова. Ці зміни відбуваються під час індивідуального
розвитку — онтогенезу. Нові види організмів виникають у процесі еволюції — історичного розвитку живої природи
Усі біологічні системи мають певні рівні організації, у яких організми
1. Досліджуємо світ науки
загадка
Поміркуйте, чому ми називаємо цуценя лабрадора живим
об’єктом, а от фотографію
або ж скульптуру цієї самої собаки — неживим?

Із курсу математики вам відомо, що система — це єдине ціле, яке складається з взаємопов’язаних між собою елементів. До складу біологічних систем належать живі організми або їхні частини.
Живі системи мають певні рівні організації, які відрізняються одне від одного (мал. 3.1.).
Молекулярний. Окремі атоми або групи атомів, що об’єднані в молекули та інші структури
Клітинний. Молекули й органели, які беруть участь у процесах життєдіяльності самої клітини.
1. Чи можна спостерігати всі ознаки живого, наприклад, у гілці сухого дерева?
2. Яка існує особливість організації біологічних систем на Землі?
3. Порівняйте екосистемний і біосферний рівні організації живого. Що між ними відмінне, а що спільне?
4. Використавши метод скрайбінгу, поясніть рівні організації біологічних систем.
5. За допомогою діаграми Венна, поясніть спільні та відмінні ознаки неживих і живих об’єктів. Сформулюйте висновки.
Тканинно-органний. Клітини, тканини й окремі органи організму.
Організмовий. Системи органів живих організмів.
Популяційно-видовий. Сукупність організмів одного виду та їх взаємодія.
Екосистемний. Різні види організмів, що взаємодіють у певному середовищі існування.
Біосферний. Містить усі взаємопов’язані між собою екосистеми на Землі
Мал. 3.1. Рівні організації біологічних систем ніби ланцюжок, ланки якого поступово ускладнюються
Ключова ідея
Усі живі організми мають сукупність властивостей, за якими
їх можна відрізнити від неживих об’єктів. Це — ознаки живого. Живі організми утворюють біологічні системи, які
є складовими систем вищого рівня. Для кожної біологічної
системи характерні рівні організації живого.
Видавництво
Зараз нашу планету населяє близько 8 млн видів живих організмів. Але ця цифра не є остаточною. Наукова спільнота продовжує відкривати нові види.
Першим класифікував живі організми Аристотель, виділивши серед них групи рослини і тварин. А першою науковою системою класифікації організмів уважають систему шведського науковця Карла Ліннея, в якій групи рослин і тварин отримали статус Царств.



Які асоціації у вас викликає слово «клітина»?
y Ознаки та рівні організації живого.
y Рухи клітин.
Американський мікробіолог Карл Річард Воуз 1985 року запропонував клітинні форми життя розподілити на домени: Бактерії, Архебактерії та Еукаріоти (із ними ви
у наступних параграфах) (мал. 4.1). А Віруси, як неклітинні форми життя, були винесені в окрему групу Vira.
А зараз запрошуємо у неймовірний світ клітинних організмів. Усі організми цієї великої групи складаються з клітин, адже клітина — це основна найменша структурно-фунціональна одиниця живого. Клітина має комплекс ознак живого: певний хімічний склад, обмін речовин, здійснення найважливіших процесів життєдіяльності (дихання, живлення, виділення, розмноження тощо). Клітини ростуть, розвиваються і навіть рухаються.
Розрізняють два типи клітин: прокаріотичні (не мають ядра) та еукаріотичні (мають ядро) (мал. 4.2).
А ще клітини можуть існувати як окремий організм. Серед живого є найпростіші організми, які складаються з однієї клітини. Вона виконує всі життєві функції. Тому інфузорій, амеб і багато
Мал. 4.1. Систематика живих організмів за Карлом Річардом Воузом
Бактеріальна Тваринна
Рослинна
Мал. 4.2 Типи клітин
§ 4. Клітина — одиниця живого.
Досліджуємо світ науки
загадка
У грудні 2019 року в лікарні китайського міста Ухань був
зареєстрований пацієнт із дивними симптомами. Лікарі
довго не могли встановити діагноз, адже ознаки не були властиві вже відомим захворюванням. Згодом встановили, що інфекція викликана штамом коронавірусу, а сама хвороба в лютому 2020 року отримала назву COronaVIrus Disease 2019 (скорочено COVID19). Наукова спільнота й досі сперечається щодо вірусів: живі вони чи неживі. Як ви вважаєте, чи можна віруси віднести до живої природи? Які властивості живого можуть якнайкраще їх описати?
Кісткова клітина
Амеба
Евглена зелена Інфузорія-туфелька Мал. 4.3. Найпростіші одноклітинні організми
інших найпростіших можемо вважати одночасно і клітиною, і організмом (мал. 4.3).
Кожна клітина має свою форму, розміри та функції (мал. 4.4). Тому клітину можна вважати біологічною системою. Деякі з клітин можна побачити неозброєним оком, зокрема клітини плодів кавуна, яйцеклітини риб та птахів. Але переважну більшість клітин можна побачити лише в мікроскоп. Попри неймовірну різноманітність, загальна будова клітин однакова і в рослин, і в тварин.
теорія — «документ» про клітину Комплексну науку, яка вивчає клітини, називають клітинною біологією (цитологією). А узагальнені результати досліджень, які наукова спільнота отримала під час вивчення клітин,
Еритроцити (клітини крові)

Яйцеклітина (жіноча статева клітина)

Мал. 4.4. Клітини тваринних


Війчасті епітеліальні клітини
Нейрон (нервова клітина)

Сперматозоїд (чоловіча статева клітина)
Посмуговані м'язові клітини (міоцити)
організмів більш різноманітні, ніж у рослин
Основні положення цієї теорії формувалися впродовж багатьох років. Сучасна клітинна теорія відрізняється від положень, які панували
в ХІХ столітті.
Клітинна теорія ХІХ століття
y Живі організми складаються з клітин або
утворені з них різними способами.
y Клітина є найменшою живою одиницею,
а цілий організм є сукупністю клітин. Поза
клітиною життя немає.
y Ріст і розвиток рослинних і тваринних
організмів пов’язані з утворенням нових
клітин.


y Кожна клітина походить із клітинпопередників.
Сучасна клітинна теорія
y Клітина — найменша структурна й функціональна одиниця живого.
y Ядро — найголовніша частина будь-якої еукаріотичної клітини.
y Клітини розмножуються шляхом поділу.
y Різні клітини схожі за загальною будовою.
y Багатоклітинні організми — складні комплекси клітин, які об’єднані в тканини й органи.
1. Що таке клітина?
Розділ біології, який вивчає різноманіття живих організмів, називається біологічною систематикою. Розрізняють клітинну
й неклітинну форми життя. Клітина — найменша структурна
й функціональна одиниця живого. Клітини вивчає наука — клітинна біологія (цитологія). Клітинні форми життя розподіляють на домени: Бактерії, Архебактерії та Еукаріоти. Віруси — це неклітинні форми життя.
2. Що таке клітинна теорія та які науковці й науковиці працювали над її створенням?
3. Доведіть тезу, що клітина може бути окремою біологічною системою.
4. Представники яких професій застосовують інформацію, отриману в галузі цитології?
5. Поміркуйте, чому клітини тварин різноманітніші, ніж рослинні.
1837 року німецький ботанік Маттіас Шлейден уперше запропонував клітинну теорію для рослин. Пізніше його друг, фізіолог Теодор Шванн, на основі знань М. Шлейдена сформував загальні положення про тваринну клітину. Спираючись на їхні висновки, німецький науковець Рудольф Вірхов 1859 року запропонував нове положення клітинної теорії, що дало поштовх появі науки про клітину — цитології.
стала підґрунтям для формулювання клітинної теорії.

Що заважало науковцям у давнину досліджувати клітини?
y Що таке лінза?
y Чим мікроскоп відрізняється від телескопа?
Кінець
XVI ст.
Людство завжди цікавило питання: із чого складається все навколо, зокрема живі організми. Але відповіді до певного часу отримати не вдавалося, адже людським оком не побачиш клітини рослин, тварин або різні мікроорганізми. Тому до появи мікроскопа найменшими живими істотами, які людина могла спостерігати, були комахи.
Розгляньмо основні етапи історії досліджень клітин.
Поява першого прототипу мікроскопа, який сконструювали голландський майстер із виготовлення окулярів Ганс Янсен та його син Захарія Янсен
1624 р. Ґалілео Ґалілей створив складний мікроскоп, який назвав «оккіоліно» — «маленьке око»
1665 р.
1674 р.
Роберт Гук сконструював мікроскоп, дослідив за його допомогою корок, де побачив
«комірки», з яких той складався. Комірки він назвав «клітинами»
Антоні ван Левенгук удосконалив мікроскоп (можливість збільшення в 270 разів). Він
виявив у краплині води одноклітинні організми, а в зубному нальоті виявив бактерії
1839 р. Теодор Шванн зробив висновок, що клітини рослин і тварин мають спільну будову
1931 р. Ернст Руска створив прототип електронного мікроскопа, що дозволив побачити
об’єкти в тисячу разів менші за ті, яких видно у світловий мікроскоп
Мал. 5.1. Мікроскоп «оккіоліно» Галилео
Галилея. 1625 року Йоганн Фабер
запропонував використовувати для цього

приладу термін «мікроскоп» за аналогією
з терміном «телескоп»
Будова світлового мікроскопа
Різні мікроскопи мають різне збільшення. Воно дорівнює добутку збільшення окуляра та
збільшення об’єктива. Збільшення окуляра та
об’єктива зазвичай зазначені на цих елементах мікроскопа.
Збільшення мікроскопа = = збільшення окуляра × збільшення об’єктива
Проєктна діяльність:
моделі мікроскопа
Пропонуємо власноруч сконструювати мікроскоп. Ця робота потребує допомоги дорослих.
Вам знадобляться: дві лупи або лінзи з них, клей, два аркуші цупкого паперу.
Пофарбуйте папір у чорний колір та згорніть його у дві труби діаметром, що дорівнює діамерту кожної лупи. Довжина першої труби має бути близько 30 см, а другої 10–15 см.
На одному кінці кожної труби закріпить лупи. Надіньте труби одна на одну так, щоб лупи були по краях приладу (а не всередині). Важливо, щоб ці труби легко рухалися одна в одній. Це дозволить зменшувати або збільшувати їхню загальну довжину.
Мікроскоп готовий до роботи! Якщо є бажання, можна спробувати зробити штатив і предметний столик, підсвітку з дзеркала або ліхтарика. Але і в такому вигляді інструмент можна використовувати.
Наведіть на невеличкий об’єкт одну лупу — це буде об’єктив, а спостерігати за об’єктом необхідно через іншу лупу — окуляр.
Ключова ідея Завдяки винаходу мікроскопа в XVII столітті почалося вивчення клітин. Термін «клітина» запропонував Роберт Гук, який побачив їх за допомогою удосконаленого мікроскопа. Антоні ван Левенгук удосконалив мікроскоп та отримав збільшене в 270 разів зображення одноклітинних організмів. Різні мікроскопи мають різне збільшення. Воно дорівнює добутку збільшення окуляра та збільшення об’єктива.
1. Які лінзи (розсіювальні чи збиральні) використовують у світловому мікроскопі?
2. Як дізнатися збільшення мікроскопа?

3. Представники яких професій використовують мікроскопи в своїй діяльності?
4. Чому Антоні ван Левенгука називають «батьком» мікробіології?
5. Які результати дослідження клітин отримали науковці завдяки появі мікроскопів?
6. За допомогою додаткових джерел інформації сформуйте правила безпечної роботи з мікроскопом.

y Чому до 1931 року біологи не могли описати мікроскопічну структуру клітини?
y Що особливого можна побачити в клітині під мікроскопом?
y Що таке клітина та які процеси життєдіяльності в ній відбуваються?
y У чому полягає головна думка клітинної теорії?
загадка
Кожна країна має кордони і територію, власну політичну систему та державні органи.
Як ви вважаєте, чи можна порівняти державу з клітиною?
Що є спільного між ними?
Усі організми складаються з клітин. Життєві функції клітини виконують структурні частини: поверхневий апарат, цитоплазма з органелами та ядро. За наявністю чи відсутністю ядра в клітинах, живі організми поділяють на еукаріотичні (ядерні) та прокаріотичні (доядерні). Визначити, є в клітині ядро чи ні, можна за допомогою світлового мікроскопа, а сучасні електронні мікроскопи дозволяють побачити в клітинах різних організмів значно більше відмінностей.
Прокаріоти (від грец. про — до, каріон — ядро) — це організми, які не мають ядра й більшості органел — постійних структурних елементів клітини.
Розміри прокаріотичних клітин невеликі, вони значно менші, ніж в еукаріотів. А тому такі розміри дозволяють швидко проводити процеси обміну речовин із середовищем існування. До прокаріотів належать бактерії та синьо-зелені водорості (ціанобактерії).
Розгляньте на малюнку 6.1 склад структурнофункціональної одиниці прокаріотів.
Мал. 6.1. Будова прокаріотичної клітини
Еукаріоти (від грец. еу — повністю та каріон — ядро) — це організми, клітини яких мають ядро та розвинену систему органел. Ці клітини значно більші, ніж у прокаріотів. Вони мають складнішу будову, і завдяки цьому набули здатності утворювати комплекси клітин із різноманітним розподілом взаємозв’язків. Це зумовило виникнення багатоклітинних організмів — рослин, тварин і грибів. Розгляньте будову клітин цих організмів. (мал. 6.2). Про те, які функції виконують органели клітин, ви можете прочитати в електронному додатку до підручника.
Хімічний склад клітини
Клітини організмів складаються з «цеглинок» — атомів хімічних елементів. Об’єкти неживої природи також складаються з них. Хімічний елемент — це атоми одного виду. Атоми різних хімічних елементів відрізняються за будовою, властивостями тощо. Докладно про атоми ви дізнаєтеся в курсі хімії. Переважну частину (96–98 %) від маси живої клітини становлять атоми таких хімічних елементів: вуглець (С), водень (Н), кисень (О) і азот (N). Близько 2 % маси клітини становлять ще вісім видів атомів: калій (К), натрій (Na), кальцій (Ca), хлор (Cl), магній (Mg), залізо (Fe), фосфор (P) і сірка (S). Інші види атомів містяться в клітинах у дуже малих кількостях.
Атоми можуть поєднуватися між собою та утворювати неорганічні та органічні сполуки.
Органічні речовини — це сполуки вуглецю.
У складі їхніх молекул, крім атомів вуглецю можуть міститися атоми водню, кисню, азоту й інших хімічних елементів.
Неорганічні речовини — усі інші складні
та прості речовини, у складі яких не містяться
атоми вуглецю (виняток вуглекислий газ, питна сода та ще деякі речовини).
Мал. 6.2. Будова тваринної й рослинної клітин Ключова ідея Усі організми складаються з клітин. За наявністю чи відсутністю ядра в клітинах, організми поділяють на еукаріотичні та прокаріотичні. Клітини еукаріотів значно більші, ніж у прокаріотів і мають складнішу будову. Усі клітини складаються з певних хімічних елементів.
1. З яких структурних частин складаються клітини? Схарактеризуйте особливості їхньої будови та функції.
2. Які органели відрізняють тваринну клітину від рослинної?

3. Наведіть приклади об’єктів природи, в яких можуть утворюватися органічні речовини. У яких об’єктах природи вони не утворюються?
4. За допомогою додаткових джерел з’ясуйте, чому зеленіють бульби картоплі навесні, коли їх дістали з приміщення для зберігання.
5. Які речовини містяться у складі живих організмів: вода, поліетилен, білки, жири, нафта, вуглеводи.
майбутньогопідручника
Видавництво

Будову світлового мікроскопа та правила роботи з ним.

Цей урок — урок-дослідження, на якому ви в ролі цитологів/цитологинь навчитеся виготовляти мікропрепарати та будете досліджувати рослинні і тваринні клітини.
Виготовлення та дослідження

мікропрепарату луски цибулі
Підготуйте цибулину та необхідні інструменти:
• світловий мікроскоп;
• чашку Петрі;

• предметні і покривні скельця;
• пінцет;
• піпетку;
• воду та розчин йоду.
Інструкційна картка
1. Нанесіть піпеткою на предметне скло краплину води і краплину йоду.

2. За допомогою пінцету зніміть із білої лусочки цибулі, яка лежить в чашці Петрі, маленький шматочок прозорої шкірки.
3. Пінцетом покладіть у воду на предметному скельці зняту шкірочку.
4. Розправте її і накрийте покривним скельцем. Мікропрепарат готовий!
5. Підготовлене предметне скло помістіть на предметний столик мікроскопа.
6. Рухайте гвинти для отримання чіткого зображення. Уважно розгляньте мікропрепарат.
7. Порівняйте побачене під мікроскопом із фотографією та підпишіть складові будови клітини.
Рослинна та тваринна клітини:
тваринна клітина має переважно кулясту або еліпсоїдну форми, а от рослинна
у вигляді неправильного квадрата чи прямокутника.

Порівняйте рослинну і тваринну клітини за
наявністю в них різних органел.
Зробіть висновок про особливості будови рослинної клітини порівняно з тваринною.

Додаткові завдання
1. На уроці природничих наук діти за допомогою мікроскопа дослідили будову клітин шкірочки луски цибулі. Який метод біологічних досліджень вони застосували?
а) експеримент в) порівняння б) спостереження г) опис
2. Моделювання клітини з пластиліну.
За допомогою пластиліну чи будь-яких інших матеріалів створіть 3D-модель рослинної або тваринної клітини. Дуже цікавими будуть моделі, створені за допомогою желатину, який буде відігравати роль цитоплазми.
Модель клітини містить різні органели, тому ви маєте уявляти їх форму та зробити різнокольоровими. Колір можна обрати любий, адже кольори малюнків у підручниках не схожі на реальні. А ось форма певних органел має бути властива саме їм. Важливо правильно розмістити всі органели. Наприклад, ендоплазматичний ретикулум (ЕПР) завжди розташований поблизу ядра.
За допомогою желатину можна зробити об’ємну модель з органелами, які перебувають у прозорому середовищі. Оскільки тваринні та рослинні клітини мають різну форму, для формування рослинної клітини оберіть прямокутну
форму, а для тваринної — овальну чи круглу. Щоб потім легко вийняти модель із форми, обгорніть її харчовою плівкою. Спочатку залийте у форму підготовлений желатин, дайте йому трохи охолонути. Тепер можна викласти в желатинову «цитоплазму» всі органели та дати йому застигнути. За 3–4 години модель клітини готова!
3. Прочитайте прислів’я і приказки та проведіть асоціативний ряд, про які саме органели (у переносному значенні) йдеться. Наприклад:
Хату руки держать. Цитоплазматична мембрана.
Всякий двір хазяйським оком тримається.
Працює, як мураха.
У воді стоїть, а води просить
загадка
Вінегрет — неймовірно смачний салат, який складається
з доступних інгредієнтів.
У складі зазвичай є варені квасоля, картопля, морква та буряк, а також солоний огірок і квашена капуста. Коли ми варимо червоний буряк для вінегрету, вода стає червоною, її забарвлює пігмент, що міститься в клітинах буряка. Морква, у хромопластах якої є оранжевий пігмент, воду майже не забарвлює. Як ви вважаєте, чому це відбувається?

Чи може бути клітина окремим організмом?
Яке збільшення має бути в мікроскопа, щоб ви могли спостерігати клітини шкірочки цибулі? Які основні компоненти клітини можна побачити в цих клітинах?
1675 року Антоні ван Левенгук уважно розглядав у мікроскоп краплину води й побачив у ній неймовірний хаос. Там була чимала кількість мікроскопічних організмів, які пізніше назвали найпростішими одноклітинними організмами, а Левенгук став їхнім першовідкривачем (мал. 8.1).

Сьогодні одноклітинні організми продовжують досліджувати. Як виявилося, ці організми з’явилися на планеті близько 3 млрд років тому. Такий висновок зробили в Університеті Каліфорнії (США) після дослідження найдавніших кам’яних порід, які колись перебували у прісноводних водоймах. І хоча розміри одноклітинних від 2–4 мкм до 25 см (у колоніальних форм), проте саме вони дали поштовх для розвитку еволюції живого. Наука про найпростіших — протистологія — визначає понад 70 тис. видів цих організмів. І це ще не остаточна кількість, адже щороку відкривають сотні нових видів.
Мал. 8.1. Парамецій (інфузоріятуфелька) — рід одноклітинних
війчастих найпростіших організмів
Основні риси організації
одноклітинних організмів Розгляньмо схему.
У попередніх параграфах ми розглянули будову прокаріотичної клітини. Вона притаманна тим організмам, у клітинах яких відсутнє ядро, і більшість із них — це бактерії.
Бактерії можуть мати різноманітну форму: кулясті (коки), паличкоподібні (бацили), спіральні (спірили) тощо (мал. 8.2).


Прокаріоти поширені на всій планеті й відіграють важливу роль у біосфері. Вони забезпечують родючість ґрунту, деякі види очищують водойми, інші беруть участь у колообігу речовин. Бактерії використовують для бродіння молочнокислих продуктів, отримання кормового білка, а також у медицині та ветеринарії.
Засновником науки про бактерії — мікробіології — є французький хімік Луї Пастер. Він пояснив, що процеси гниття і бродіння спричинені саме цими мікроорганізмами. Це було дуже важливо для тогочасної медицини, насамперед хірургії.
Одноклітинних еукаріотів, або протистів, можна зустріти на Землі всюди: у річках, струмках, болотах, морях, ґрунті, в організмах тварин, зокрема людини. Але краще з ними не контактувати, оскільки часто це збудники небезпечних захворювань. Вони різняться між собою за формою, будовою, розмірами й способом існування.
Систематизують одноклітинних еукаріотів за типами живлення. Твариноподібні одноклітинні організми не здатні синтезувати органічні речовини, а отримують їх разом із їжею: клітинами бактерій, водоростей, грибів, дрібніших за себе мікроорганізмами. До цієї групи належать інфузорія-туфелька та амеба-протей, яка не має сталої форми тіла. Не дивно, що її названо на честь давньогрецького бога Протея, який за міфами набував різних образів і форм (мал. 8.3 і 8.4 на с. 24).
у процесі життєдіяльності здійснюють фотосин-
Мал. 8.2. Назви та форми бактерій
загадка
Микола з Іванкою вирішили провести дослід. Вони помістили у склянки з чистою кип’яченою водою амебу, хламідомонаду та інфузорію. Через певний час з’ясувалося, що вижила лише одноклітинна водорість. Поясніть, у чому причина загибелі інших.
1. Досліджуємо світ науки
Розміри: 0,2–0,5 мм. Форма: не стала. Місце існування: мулисті стоячі водойми
Мал. 8.3. Клітинна будова амеби-протей
Розміри: 0,05–0,06 мм.

Форма: стала.
Місце існування: мулисті стоячі водойми



Мал. 8.4. Клітинна будова інфузорії-туфельки
тез, адже в їхній будові наявні хлоропласти. Одними з найпоширеніших представників цієї групи є хламідомонада, хлорела — одноклітинні водорості (мал. 8.5 і 8.6). Вони беруть участь в утворенні кисню, очищають стічні води, а ще їх використовують для отримання лікарських препаратів.
Колоніальні
Однотипні одноклітинні організми (а іноді і багатоклітинні) можуть об’єднуватися в колонії для спільного виконання життєвих функцій, але при цьому кожна клітина може сама виконувати всі функції живого.
Розміри: від кількох нанометрів до 40 мм.
Форма: стала.
Місце існування: прісні водойми
Мал. 8.5. Клітинна будова хламідомонади
Розміри: від 1,5 мкм до 12 мкм.
Форма: стала.
Місце існування: прісні водойми, вологий ґрунт
Мал. 8.6. Клітинна будова хлорели
організми
»
Мал. 8.7. Синьо-зелені водорості (ціанобактерії, ціанопрокаріоти) — колоніальні організми, здатні до фотосинтезу
Це і є прикладом колоніальних організмів. Вони складаються з організмів, які зазвичай мають спільний обмін речовин, спільні системи регуляції тощо.
Умови життя клітин у колонії різні. Одні живуть у середині колонії, інші на периферії.
До колоніальних рослин належать різні одноклітинні водорості: синьо-зелені (ціанобактерії), зелені, золотисті, жовто-зелені, діатомові, пірофітові, евгленові (мал. 8.7).
Одноклітинні колоніальні організми можна вважати проміжною ланкою в процесі виникнення багатоклітинних організмів. Детальніше
з колоніальними організмами ви ознайомитеся
в 7 класі Ключова ідея

Одноклітинні є цілісними самостійними організмами. Їм
притаманні такі самі ознаки живого, як і багатоклітинним (тваринам, рослинам і грибам). Одноклітинні прокаріоти
й еукаріоти опанували всі середовища існування земної кулі. Твариноподібними еукаріотичними організмами є амебапротей, інфузорія-туфелька, а рослиноподібними — хламідомонада і хлорела. Колоніальні організми можуть складатися з одноклітинних і багатоклітинних організмів. Дізнайтеся більше Завдяки досягненням біотехнологій із бактерій виділено спеціальні речовини з антибіотичними властивостями. Вони вбивають небезпечні
1. Одна клітина є цілим організмом і має всі ознаки живого. Назвіть ці ознаки.
2. Чим відрізняються між собою прокаріотичні та еукраотичні одноклітинні організми?
3. Наведіть приклади одноклітинних організмів.
4. Чи відрізняються способи харчування різних еукаріотичних одноклітинних організмів?
5. Як особливості будови найпростіших допоможуть зрозуміти існування та функціонування одноклітинних організмів?
6. Як змінився б результат досліду Миколи та Іванки (із природничої загадки), якщо вони помістили б склянки в темне місце, а у воду додали бактерій? За можливості повторіть цей дослід.
7. Обчисліть, скільки може бути бактерій у вашій вітальні, якщо її розміри становлять: довжина — 3 м, ширина — 2 м, висота — 2 м. Зважайте, що в 1 м3 живуть близько 4000 бактерій.
Обчисліть, скільки бактерій може бути в усьому будинку, якщо його площа становить 44 м2.
мікроорганізми, що спричиняють захворювання тварин, зокрема людини.
Чи можуть окремі клітини існувати поза організмом?
y Які
організми належать до одноклітинних?
y Чим колоніальні організми відрізняються від одноклітинних?
y Що таке органи? Які органи людини ви знаєте?
загадка
Давні єгиптяни використовували цей морський багатоклітинний організм як засіб для миття тіла. І не дивно, адже замість кремнеземових голок, ця найпростіша багатоклітинна тварина має ніжну сітку волокон з органічних сполук, що нагадує шовк. Про який багатоклітинний організм йдеться?

У одноклітинних і багатоклітинних організмів клітини функціонують по-різному. Одноклітинний організм залежить від однієї клітини, яка виконує для нього всі функції. А багатоклітинний організм складається із сукупності клітин, групи яких спеціалізуються на виконанні певних функцій. Це відбувається завдяки тому, що кожна клітина має спеціалізовані клітинні структури — органели. І саме вони відповідають за різноманітні клітинні функції: отримання поживних речовин, вироблення енергії, утворення (синтез) білків тощо. Багатоклітинними організмами є більшість рослин, тварин і грибів (мал. 9.1).
У людини різні клітини формуються на початку розвитку організму, щоб згодом стати нервовими
Мал. 9.1.
організмів
клітинами, клітинами шкіри, м’язовими клітинами, клітинами крові й іншими типами клітин (мал. 9.2). Структура клітин пов’язана з їхньою функцією, тобто кожен тип клітин набуває певної форми, щоб найкраще виконувати певні функції.

Групи клітин, які спеціалізуються на виконанні певних функцій, утворюють у багатоклітинному організмі нові структури: тканини, органи, системи органів, між якими є певні зв’язки.
Тканина — це сукупність клітин, що подібні за походженням, будовою та функціями, які вони виконують (мал. 9.3).
Орган — це частина рослинного або тваринного організму, яка виконує певні функції (одну або декілька). Усі органи складаються з різних типів тканин і характеризуються особливостями будови, розташуванням і функціями, які виконують в організмі. Але вони всі пов’язані між собою.
Якщо органи виконують спільну функцію, вони утворюють системи органів, які ще називають фізіологічними системами органів. У багатоклітинних організмів є декілька основних фізіологічних систем. У людини —
Тканини рослин

Тканини тварин, зокрема людини
Мал. 9.3. Типи тканин



1. Досліджуємо світ науки
1. Наведіть приклади багатоклітинних організмів. Чим вони відрізняються від одноклітинних?

2. Поясніть різницю між функціонуванням клітин в одноклітинних і багатоклітинних організмах.
3. Чому колоніальні організми, зокрема вольвокс, які складаються з багатьох клітин, не відносять до багатоклітинних?
4. Як ви вважаєте, яких організмів на планеті більше: багатоклітинних чи одноклітинних? Чому?
5. Які функції виконують органи в багатоклітинному організмі?
Чи можливе існування організму без певних органів?
Обґрунтуйте свою відповідь.
6. Підготуйте повідомлення
чи презентацію про одного з видатних українських
науковців-анатомів (лікар-хірург, анатом Микола Пирогов, анатом і гістолог Володимир Бец, засновники Київської школи анатомів Микола Козлов і Олександр Вальтер, Нобелівський лавреат Ілля Мечников та інше) та презентуйте її однокласникам/однокласницям.

Мал. 9.4. Фізіологічні системи органів людини
це травна, дихальна, видільна, репродуктивна, нервова, серцево-судинна, опорно-рухова, сенсорні, ендокринна, імунна системи (мал. 9.4). Більш докладно з ними ви ознайомитися в наступних параграфах.
основоположником пластичної
анатомії
Ключова ідея

Багатоклітинний організм складається із сукупності клітин, які відрізняються будовою. Групи клітин спеціалізуються на виконанні певних функцій і утворюють тканини, органи та системи органів. Клітини, подібні за походженням, будовою і функціями, утворюють тканини. Органи, які складаються з тканин, виконують певні функції й утворюють фізіологічні системи органів. До багатоклітинних організмів належить більшість рослин, тварин і грибів.
Дізнайтеся більше
Системи органів, їхню будову, роботу та розташування
вивчає наука анатомія. Одним з основоположників наукової анатомії був Леонардо да Вінчі. Його називають «універсальною людиною», адже він був художником, скульптором, письменником, винахідником, натуралістом, анатомом. Леонардо да Вінчі зацікавився анатомією саме як художник. Щоб краще зобразити людське тіло на полотнах, він одним із перших почав робити розтини померлих і робив замальовки. Він першим правильно зобразив різні частини та органи тіла людини і тварини.

У 5 класі ми говорили, що всім організмам для життя потрібна енергія, яка виробляється
в їхніх тілах під час «спалювання» складних органічних речовин, наприклад вуглеводів.
У ґрунті в розчиненому вигляді є необхідні мінеральні речовини, утворені різними хімічними елементами. Під дією кореневого тиску розчинені
у воді неорганічні сполуки всмоктуються, підіймаються стеблом і потрапляють у кожну клітину органів рослин — це висхідний рух. А от рух від листків стеблом до коренів — низхідний. Так у рослині відбувається кругообіг поживних речовин.
Процес отримання з навколишнього середовища
й засвоєння організмом речовин, які використовуються для підтримки життєдіяльності, росту, розвитку й розмноження, називають живленням. У рослин виділяють два типи живлення. Розгляньмо їх у таблиці.
Зовнішній вигляд рослин може багато розповісти про їхній стан (мал. 10.1). У разі нестачі поживних речовин рослини переважно змінюють колір або форму листків (мал. 10.2 на с. 30). Так вони сигналізують про необхідність підживлення ґрунту мінеральними добривами або перегноєм, що утворився в процесі розкладання рослинних і тваринних решток. Мал. 10.1. Вплив різних факторів
Яка частина рослини є важливішою: надземна чи підземна? Як вони допомагають живитися рослинам?
y Із яких органів складаються рослини?
y Що таке фотосинтез та яку біологічну роль відіграє цей процес у рослин?
y Як змінюється зовнішній вигляд рослини, коли їй не вистачає води?
загадка
Виконайте дослідження Візьміть листки пекінської капусти або квітки білої хризантеми та поставте їх на добу в зафарбовану воду. Листки або пелюстки почнуть забарвлюватися. Можна також використати пагін верби, але його потрібно занурити в зафарбовану воду майже на тиждень. Потім разом із дорослими зробіть поперечний надріз стебла. Чи змінилося забаврвлення центральної частини? Чому це відбувається?
майбутньогопідручника
Видавництво
Розділ 1. Досліджуємо світ науки
Типи
Тип живлення Особливості перебігу процесів
Автотрофне живлення
Гетеротрофне живлення
Рослини самостійно синтезують органічні речовини з неорганічних у процесі фотосинтезу з використанням енергії світла
Цей тип живлення властивий паразитичним або комахоїдним рослинам, які отримують органічні речовини з інших організмів. Паразитичні рослини не можуть здійснювати фотосинтез, тому отримують поживні речовини за рахунок інших рослин, на яких оселилися. А комахоїдні, приміром венерина мухоловка, добувають необхідні сполуки з тіл комах, яких вловлюють листковою пластинкою
1. Що таке живлення? Які типи живлення характерні для рослин?
2. Схарактеризуйте, як відбувається живлення в рослин.
3. Які елементи необхідні рослині на всіх етапах її життя?
4. Яку роль у догляді за рослинами відіграє такий метод дослідження, як спостереження?
5. Об’єднайтеся в пари. За допомогою методу «ПРЕС» (« Ми вважаємо, що…», «Тому що…», «Наприклад…», «Отже…») поясніть вислів чеського письменника Карела Чапека: «Людина, по суті, зовсім не думає про те, що в неї під ногами… І жодного разу не подивиться собі під ноги й не похвалить: який прекрасний цей ґрунт!»
Мал. 10.2. Типові симптоми нестачі елементів мінерального живлення в рослин іноді використовують для прогнозування можливого дефіциту поживних речовин
Ключова ідея

Живлення рослин — це процес поглинання й засвоєння необхідних поживних речовин для процесів життєдіяльності. Про нестачу певних хімічних елементів свідчать зміни зовнішнього
вигляду рослин.
«Ранок»

Більшість рослин — автотрофи. Вони синтезують (утворюють) поживні речовини з неорганічних сполук у процесі фотосинтезу. А от тварини на це не здатні. Вони отримують необхідні речовини з органічних сполук разом із поживою, їх називають гетеротрофами.
Процес розкладання складних органічних сполук їжі на простіші речовини називається травленням.
Відповідно до способу живлення тварин поділяють на рослиноїдних, м’ясоїдних (зокрема й кровосисних), всеїдних та тих, хто харчується рештками рослин і тварин.

Чому після вживання деяких страв ми відчуваємо важкість у шлунку?
y Типи живлення рослин. y Яким рослинам притаманний гетеротрофне живлення?
y Які компоненти є у складі харчових продуктів людини?
Яка їх роль в організмі?

загадка
Травна система тварин
Травна система — це сукупність органів, що беруть участь у процесі травлення та засвоєння поживних речовин. Завдання травної системи: добути потрібну кількість необхідних поживних речовин з їжі та доправити їх до клітин.
Іноді ми чуємо вирази на кшталт «і людина, і тварини», які штучно відокремлюють людину від тварин. Це неправильно, адже ми також є представниками тварин. Тому розглянемо травну систему тварин на прикладі людини (див. мал. 11.1. і таблицю на с. 32).
Наукова термінологія часто є перекладом із грецької мови: зоо (грец. zoon тварина), копрос (грец. kopros — гній або послід), некрос (грец. nekros — мертвий), пантос (грец. pantos — усе), сапро (грец. sapros гнилий), трофія (грец. trophe — їжа, харчування), фаги (грец. phagos — їсти, пожирати, поглинати), фіто (грец. phyton — рослина). Як ви вважаєте, чому?
Видавництво
Мал. 11.1. Травна система людини
Ділянки травної системи
Травна система = травний тракт (органи) + залози
Функції
Передня
Ротова порожнина (губи, зуби, язик, слинні залози) глотка, стравохід

Механічна та початкова хімічна обробка їжі Середня
Шлунок, печінка, жовчний міхур
підшлункова залоза, тонка й товста кишки
Хімічна обробка їжі (перетравлення і всмоктування поживних речовин); формування калових мас із неперетравлених залишків їжі Задня Пряма кишка з анальним отвором
Видалення неперетравлених залишків їжі за межі травного каналу Як відбувається процес травлення?
Потрапляючи в організм, їжа проходить складний шлях у травній системі. У процесі травлення відбувається розщеплення білків, жирів і вуглеводів, що містяться в їжі. Травні залози виділяють особливі речовини — ферменти, які розщеплюють певні компоненти їжі. Розгляньмо приклад: у процесі травлення великі молекули жиру не можуть розщеплюватися самостійно. Для цього необхідний фермент, який пришвидшує цей процес, — фермент ліпаза.

1. Наберіть півсклянки води і додайте до неї столову ложку олії. Що спостерігаєте? Чи розчиняється олія у воді?
1. Назвіть основні ділянки травної системи людини.
2. Додайте у склянку декілька краплин будьякого засобу для миття посуду.
2. Що відбувається з молекулами білків, жирів і вуглеводів у процесі травлення?
3. Поміркуйте, чому живлення ≠ травлення?
3. Ретельно перемішайте суміш. Спостерігайте за змінами.
4. Що відбувається? Яку роль відіграє засіб для миття посуду? Зробіть висновки.
У результаті розщеплення компонентів їжі утворюються простіші речовини, які всмоктуються й засвоюються організмом (мал. 11.2). Ключова ідея Тварини — гетеротрофи. За способом живлення їх поділяють на рослиноїдних, м’ясоїдних, кровосисних, всеїдних та тих, хто харчується рештками рослин і тварин. Поживні компоненти надходять разом з їжею і під дією ферментів розщеплюються на простіші сполуки у процесі травлення. Травний тракт людини складається з ротової порожнини, глотки, стравоходу, шлунка, кишківника, клоаки/анального отвору.
4. Загальна площа складок тонкої кишки в людини становить 250 м2. Виміряйте площу вашої парти, класу або своєї кімнати та обчисліть, скільки їх «уміщається» у тонкій кишці.
5. Для перетравлення їжі шлунок дорослої людини виробляє шлунковий сік, який сприяє перетворенню твердої їжі на однорідну масу. Під час одного прийому їжі утворюється близько 400 мл шлункового соку. Скільки шлункового соку на добу виробляє шлунок за умови 4-разового раціонального харчування?
6. За допомогою додаткових джерел дізнайтеся, як покращити перетравлення їжі в шлунку.
7. Прочитайте уривок з поеми Івана Котляревського «Енеїда»: ...Тут їли рознії потрави,
І все з полив’яних мисок, і самі гарнії приправи
З нових кленових тарілок: свинячу голову до хріну
І локшину на переміну; потім
з підливою індик;
На закуску куліш і кашу, лемішку, зубці, путрю, квашу
І з маком медовий шулик.
До яких наслідків може призвести споживання таких

продуктів?

Видавництво

y Коли людина робить перший вдих?
y Що дозволяє нам утворювати звуки?
y Що може означати вислів «кисневе голодування»?
y Який компонент повітря необхідний для дихання?
y Що таке дифузія?
y Яка користь від процесів окиснення?
Дихання — невід’ємна ознака життя. В одноклітинних організмів відбувається дифузне дихання, у процесі якого гази проникають крізь оболонку клітини (мал. 12.1).
У таких рослин, як водорості, газообмін також здійснюється шляхом дифузії через поверхню клітин. А в інших рослин — дерев, кущів, трав’янистих — для дихання на листках і зелених стеблах є особливі утворення — продихи (мал. 12.2). Зелені рослини витрачають на процес дихання 20–25 % органічних речовин, які утворюються під час фотосинтезу.
Типи дихання
Мал. 12.1. Дихання клітини
В організмах тварин розрізняють зовнішній і внутрішній етапи дихання. Також в організмі відбувається транспорт газів. Зовнішнє дихання, або газообмін, забезпечує обмін газами між організмом і довкіллям за допомогою дихального апарату. Відповідно до способу дихання та будови дихального апарату виділяють чотири типи дихання: шкірне (одноклітинні (найпростіші), плоскі вільноживучі черви, земноводні), трахейне (павукоподібні, комахи), зяброве (морські кільчасті черви, ракоподібні, молюски, риби, земноводні (пуголовки)) та легеневе (ссавці, птахи, плазуни, земноводні).
Для повноцінного функціонування організму потрібна енергія, яку тварини отримують внаслідок розщеплення органічних сполук. За цей процес відповідає внутрішнє дихання.
Мал. 12.2. Продихи в рослин
Чи замислювалися ви, як довго організми можуть прожити без кисню? Якщо без їжі організми можуть прожити тижні, без води — декілька днів, то без кисню — кілька хвилин. Зазвичай у процесі дихання використовується кисень. Однак на нашій планеті є організми, які живуть і без кисню.

Тварини суходолу, зокрема людина, дихають киснем, що є в повітрі. Сукупність органів, необхідних для проведення повітря чи води (що містять кисень) та газообміну між організмом і навколишнім середовищем, називають дихальною системою.
Будову й функції органів дихання людини розгляньмо за малюнком 12.3 та таблицею.

Частини дихальної системи Органи Функції
Верхні дихальні
шляхи
Повітроносні
шляхи
Нижні дихальні
шляхи
Носова порожнина, глотка
Гортань, трахея, бронхи
Легені Легені

Зволоження вдихуваного повітря, забезпечення проходження повітря
Забезпечення проходження повітря, розмежування дихальної й травної систем, генерація звуків
Газообмін між зовнішнім середовищем та організмом
Мал. 12.4. Легені — один із найбільших органів у тілі людини
Мал. 12.3. Дихальна система людини Чому легені мають таку назву? Тому, що це єдиний орган, який у разі занурення у воду не тоне, а залишається на поверхні. Наші легені асиметричні. Частина місця в грудній клітці людини зайнята серцем, тому ліва легеня дещо менша, ніж права (мал. 12.4).
Повітря, яке ми вдихаємо, проходить складний шлях дихальною системою.
1. Досліджуємо світ науки
загадка
Під час сходження в гори в альпіністів може статися
запаморочення, а часом
і втрата свідомості. Такий хворобливий стан отримав
назву «гірська хвороба». Із чим це може бути пов’язано?

Мал. 12.5. Процес дихання в людини
1. Наведіть приклади організмів, яким потрібен та яким не потрібен кисень для дихання.
2. Обмін якими газоподібними речовинами відбувається у процесі дихання?
3. Чому лікарі-пульмонологи, які лікують порушення дихальної системи, рекомендують дихати через ніс?
4. Чим відрізняється процес
дихання у водних тварин і мешканців суходолу?
5. За допомогою годинника або секундоміра порахуйте кількість вдихів за 1 хв. Присядьте 20 разів і повторіть вимірювання.
Поясніть різницю у вимірюваннях і назвіть її причину. Як рухова активність вплинула на роботу дихальної системи?
Під час вдиху ребра розходяться в обидва боки, легені наповнюються повітрям і збільшуються (мал. 12.5а). Під час видиху об’єм грудної порожнини зменшується, вона тисне на легені, і з них виштовхується повітря (мал. 12.5б ).
Кисень потрапляє у кров, яка «транспортує» молекули кисню до всіх органів і клітин нашого тіла. Там відбувається обмін молекул кисню на молекули вуглекислого газу, який транспортується назад у легені й видихається назовні.
Отже, дихання в людини — це процес, який забезпечує надходження кисню до організму, використання його в процесах життєдіяльності та видалення вуглекислого газу.
Ключова ідея
Одночасно з надходженням кисню до організму має відбуватись і видалення вуглекислого газу. Цю роботу виконують органи дихання в процесі дихання. У тварин дихання здійснюється за допомогою покривів, трахей, зябер і легень, що визначається їхнім способом життя. Дихальний апарат людини складається з верхніх дихальних шляхів (носова порожнина, глотка) та нижніх (гортань, трахея, бронхи, легені).
Завдяки дихальній системі ми можемо розмовляти й співати. Потік повітря, виходячи з легень, коливає голосові зв’язки і дає можливість видавати різні звуки. А співи сприяють збільшенню ємності легень. 1973 року науко -
вець Хіроші Окамура виміряв легені професійних співаків. Виявилося, що їх об’єм значно більший, ніж у звичайних людей. Так, середня ємність легень становить 2680 мл, а у співаків — 6360 мл!
Видавництво

У попередніх параграфах ми розглянули процеси живлення, травлення та дихання. Завдяки ним в організм надходять кисень і поживні речовини. Сукупність процесів, завдяки яким в організмі відбувається перенесення різних сполук для забезпечення його життєдіяльності, називається транспортом речовин.
Транспорт речовин у рослин відбувається системою трубочок-судин, розміщених в організмі рослини — ксилем і флоем. Діаметр цих трубочок, що переносять воду й органічні та неорганічні сполуки до клітин, дуже малий. Ксилемою вода й мінеральні речовини транспортуються лише вгору (від коренів до стебла й листків), а флоемою транспорт може відбуватися як угору, так і вниз. Схожа система трубочок існує і в тварин. Їх називають кровоносними судинами (мал. 13.2). Розрізняють три вид судин: артерії, вени та капіляри. Артерії несуть кров від серця до органів. Вени повертають кров від органів до серця. Капіляри це численні найдрібніші судини,
Чи може кров бути тканиною?

y Як відбувається живлення рослин?
y Як відбувається насичення організму киснем?
y Де розташовано серце в людини та до якої системи органів воно належить?
Мал. 13.1. Ксилема (деревина) — мертва механічна тканина, а флоема — жива механічна тканина
Мал. 13.2. Кровоносні судини + циркулююча рідина (кров) + орган, який забезпечує рух (серце) = транспортна система (кровоносна)
Проєкт



загадка У ХІХ столітті під час переливання крові, на жаль, виживали лише деякі пацієнти. Чому ж одним хворим переливання чужої крові допомагало, а іншим — ні? 1900 року австрійський лікар та імунолог Карл Ландштайнер вирішив отримати відповідь на це питання. Він дослідив зразок своєї крові та крові п’яти своїх колег. Висновки були настільки важливими, що 1930 року Карл Ландштайнер отримав Нобелівську премією з медицини. Що відкрив науковець?
Карл Ландштайнер


Мал. 13.4. У дощового черв’яка серце відсу тнє. Рух крові відбувається завдяки пульсації спинної та кільцевих судин
більшість яких тонша, ніж волосина. Через них відбувається обмін речовин між кров’ю та іншими тканинами організму (мал. 13.3). Кровоносними судинами циркулює кров — рідка тканина, яка здійснює транспорт речовин.
Двигун для крові. Кровообіг Безперервний рух крові відбувається під дією скоротливого органу — серця або видозмінених кровоносних судин (за відсутності серця) (мал. 13.4).
Серце — це м’язовий порожнистий орган, що ритмічно скорочується (мал. 13.5).

Саме завдяки роботі серця відбувається кровообіг. Кровоносна система може мати один або
Мал. 13.6. Кровоносна система риби
1. Як відбувається
речовин у рослин?
2. Що таке кров?
3. Який взаємозв’язок між кровоносною системою та органами дихання в організмі тварин?
два кола кровообігу. Наприклад, у риб одне коло кровообігу (мал. 13.6).
В інших хребетних тварин два кола кровообігу — мале та велике (мал. 13.7). Мале коло кровообігу ще називають легеневим, оскільки кров циркулює між серцем і легенями. Велике коло кровообігу — це рух крові між серцем і системами органів.
Показники роботи серця

Одним із ключових індикаторів здоров’я людини є частота пульсу. Пульс — це кількість ударів серця за хвилину. Пригадайте, як після вправ на уроці фізкультури вам здавалося, що серце ніби «вистрибує». Це й не дивно, адже після фізичних навантажень або емоційних хвилювань частота пульсу збільшується. Тому важливо контролювати цей показник (мал. 13.8).

Мал. 13.8. Вимірювання пульсу в людини Дізнайтеся
Транспорт речовин — це перенесення різних сполук для забезпечення життєдіяльності організму. У рослин він відбувається завдяки системі ксилем і флоем. У тварин транспортною системою є кровоносна система: кровоносні судини, кров і скоротливий орган — серце.
4. Чому перше, що перевіряють у людини, якщо вона знепритомніла, — це пульс?
5. Серце людини недарма порівнюють із двигуном: щодня воно перекачує до 7600 л крові. А під час змагань серце лижника перекачує 4 т крові за годину! Обчисліть, скільки літрів крові перекачує його серце за 4 години гонки.
6. Робота в парах. Уявіть, що ви лікар/лікарка. Для цього самостійно зробіть простий стетоскоп.
Вам знадобиться: дві пластмасові лійки, повітряна кулька, картонний циліндр від паперових рушників, скоч.
З’єднайте лійки між собою за допомогою картонної трубки. На одну з лійок щільно натягніть повітряну кульку та зафіксуйте за допомогою скочу. До тіла приставляйте саме цей бік вашого стетоскопа.
Послухайте серцебиття одне одного за допомогою стетоскопа. Де його чути найгучніше? Які звуки ви чуєте?
У давнину благородні пани вважали, що їхня кров блакитна. Це було б правдою, якби вони були скорпіонами, павуками, восьминогами, кальмарами, крабами чи раками. Адже в деяких із цих тварин кров дійсно блакитна.
Декілька видів морських хробаків мають зелену кров. А от фіолетовий відтінок крові характерний для деяких видів молюсків.
Запитання
більше
Чи виділяють рослини якісь речовини?
y Як рослини готуються до зими?
y Як відбувається
терморегуляція в людини?
y Як з організму людини виділяється вуглекислий газ?
y До яких систем належать легені, кишечник, печінка?
У процесі життєдіяльності будь-якого організму утворюються речовини, які йому вже не потрібні. Процес виведення з організму цих речовин називають виділенням (мал. 14.1). Для цього в рослин і тварин є спеціальні органи виділення. Кінцевими речовинами життєдіяльності для рослин є вода, кисень, вуглекислий газ та інші продукти обміну речовин (метаболізму).
Процес виділення води через листки у вигляді краплин називається гутація. Гутація відбувається через особливі клітини листків — гідатоди (водяні продихи) за умов підвищеної вологості повітря (туман, дощ тощо).
Деякі рослини виділяють нектар — речовину, що приваблює комах-запилювачів. А листкові пластини рослин-хижаків виділяють травні соки для перетравлення комах, якими вони харчуються (мал. 14.2).
Мал. 14.1. Хижий гриб Гіднел Пека (народні назви «полуниця з вершками», «диявольський зуб») виділяє червоний сік, який використовують
у медицині для розрідження
крові та для виготовлення
натуральних барвників
Для захисту від поїдання тваринами деякі рослини, зокрема кропива, виділяють пекучі речовини.
Спостереження З метою спостереження за процесом гутації та впливом на нього умов навколишнього середовища виконайте дослідження.
Вам знадобляться: три пластикові стаканчики із заздалегідь підготовленими 8-добовими проростками пшениці або кукурудзи, скляний ковпак, дві склянки, розмір яких дозволить поставити в них стаканчик із рослинами, кубики льоду, тепла вода (40 °С).
Порядок дій:
1. Полийте проростки в стаканчиках.
Мал. 14.2. У росички на тонких
ніжках розташовані залози
з клеєподібною речовиною, що


приваблює комах
2. Помістіть один екземпляр разом зі стаканчиком у склянку з льодом.
3. Помістіть другий екземпляр разом зі стаканчиком у склянку з теплою водою та накрийте ковпаком.
4. Залиште третій стаканчик на столі для контролю.
5. Спостерігайте за виділеннями на кінчиках листків у вигляді краплин в усіх рослин.

6. Заповніть таблицю та зробіть висновок, як процес гутації в рослин залежить від умов навколишнього середовища.
Умови Холод Тепло й волога Кімнатна температура
На якій хвилині від початку дослідження з’явилися краплини води
Процеси виділення в тварин
Процес виділення для тварин дуже важливий, адже він підтримує середовище організму в стабільному стані. Завдяки видільній системі
з організму видаляються непотрібні речовини — продукти обміну речовин. Отже, основна функція видільної системи тварин — виведення
з організму надлишку води та продуктів обміну
речовин.
Речовини, що виділяються, можуть бути в різних агрегатних станах: газоподібному, рідкому чи твердому.
Процес виділення в тварин відбувається завдяки спеціальним органам.
У інфузорії-туфельки виділення продуктів обміну речовин здійснюється скоротливою вакуолею (мал. 14.3).


Актинія кінська позбувається продуктів обміну поверхнею тіла шляхом дифузії (мал. 14.4).
загадка

М’ясо акули здавна використовують у їжу народи Китаю, Японії, Океанії тощо. Але іноді, якщо кухар не дотримався технології обробки м’яса деяких представників акул та не вимочив його у воді або молоці, страву буде зіпсовано. У додаткових джерелах
дізнайтеся, чому м’ясо акули в такому випадку буде мати різкий неприємний запах?
Мал. 14.5. Молочно-біла планарія — представниця плоских червів
Видавництво
«
Ранок»
1. Досліджуємо світ науки
Мал. 14.6. Видільна система акули
Мал. 14.7. Сечовидільна система ссавців
У червів уже є система спеціальних видільних трубочок, які виходять на поверхню тіла й утворюють пори (мал. 14.5 на с. 41).
А в риб уже є тулубові нирки (мал. 14.6).
У



більшості хребетних тварин сформувалася сечовидільна система. Вона складається з пари нирок, у яких утворюється продукт життєдіяльності тварин — сеча, та сечовивідних шляхів (мал. 14.7).
Процеси виділення в організмі людини можуть відбуватися за допомогою таких органів як шкіра, легені, печінка, кишечник, нирки, сечоводи, сечовий міхур (мал. 14.8).
Потові залози, що розташовані в шкірі, виділяють піт — водний розчин солей. А сальні
Мал. 14.8. Органи людини, які виконують видільні функції
Мал. 14.9. Будова шкіри людини

залози виділяють речовини (секрети), які змащують волосся і шкіру (мал. 14.9). Шкіра є найбільшим за площею органом нашого організму.
Хоча у процесах виділення задіяні різні органи організму людини, але суто до видільної системи відносять лише нирки, сечоводи, сечовий міхур і сечівник. Функціями видільної системи
людини є фільтрація крові, утворення й виділення сечі, регуляція водно-сольового обміну.
Розгляньмо видільну систему людини за малюнком 14.10 та таблицею.
Органи Особливості будови
Нирки

Сечо -
води
Сечовий
Парний орган бобоподібної форми, в якому відбувається фільтрація, очищення крові від отруйних продуктів виділення з утворенням сечі
Парні трубки завдовжки 30–35 см, якими сеча
потрапляє в сечовий міхур
міхур М’язовий мішок, де накопичується сеча
Сечівник Трубка, якою сеча виводиться з організму
Ключова ідея
Виділення — це процес виведення з організму продуктів обміну речовин. Рослини можуть виділяти воду (гутація), нектар, травні соки, пекучі речовини. Виведення з організму
надлишку води та продуктів обміну — основна функція видільної системи тварин. Видільна система людини складається з нирок, сечоводів, сечового міхура та сечівника.
Дізнайтеся більше
Мал. 14.10. Видільна система людини
1. Назвіть речовини, які виділяють рослини.
2. Чим відрізняється процес виділення у риб і ссавців?
3. Назвіть органи видільної системи людини та їх функції.
4. Рослина кукурудзи за вегетаційний період випаровує майже 700 кг води. Скільки води випаровується рослинами з ділянки в 1 га, якщо за нормами на ньому висівають 50 000 насінин кукурудзи?
5. Із метою профілактики захворювань нирок за допомогою додаткових джерел інформації підготуйте буклет «Як підтримати здоров’я нирок».
6. Поміркуйте, чи можна листопад у рослин віднести до процесу виділення.
Операцію з трансплантації (пересадки) нирки людині вперше виконали
в Україні 1933 року. Лікар-хірург Юрій Вороний «пересадив» нирку молодій жінці на стегно: її приєднали до стегнових судин. Через кілька годин після операції нирка запрацювала. На жаль, за декілька днів сталося відторгнення пересадженого органу. Але про операцію написали у світовій пресі, адже це була перша в світі спроба пересадки окремого органа людині.
Юрій Вороний (1895–1961)

Видавництво «Ранок»

Завдяки чому відбувається взаємодія систем органів?
y Що таке терморегуляція?

y Що таке подразники?

y Назвіть органи чуття.
загадка
Мозок людини часто порівнюють із комп’ютером

і називають його біологічним комп’ютером. Як ви вважаєте, чому?
Одноклітинні організми, рослини та гриби не мають нервової системи, але можуть активно змінювати свою життєдіяльність під впливом зовнішніх факторів (подразників). А от у тварин у процесі еволюції з’явилась особлива система органів — нервова система — яка забезпечує нервову регуляцію діяльності організму за допомогою нервових електричних імпульсів.
Нервова система є сукупністю клітин — нейронів — та інших структур нервової тканини тварин (мал. 15.1).
«Нейрон» у перекладі з давньогрецької означає «волокно», «нерв». Це клітина, що обробляє та передає інформацію у вигляді електричного або хімічного сигналу. Наприклад, м’язи отримують від нервових волокон близько 2500 таких сигналів-«повідомлень» за секунду. А оскільки в організмі людини 100 млрд нейронів, загальна кількість сигналів буде приголомшливою!
У будові нейрона розрізняють тіло клітини, де розміщене її ядро та відростки (мал. 15.2).
До складу нервової системи належать головний мозок, спинний мозок і сукупність нервів (мал. 15.3).
Головний мозок — центральний орган нервової системи більшості тварин. А в деяких функ-
Мал. 15.1. Тканина нервової системи Мал. 15.2. Моделі нейронної клітини
цію головного мозку виконує скупчення нервових клітин, що нагадує вузол.
Головний мозок бере участь у регуляції та координації процесів в організмі. Череп захищає мозок від ушкоджень.

Маса мозку в людей може різнитися: від 1000 до 2000 г. Безпосереднього зв’язку між масою мозку людини та її розумовою діяльністю немає. Коли ми навчаємося, то змінюється структура мозку і збільшується кількість нейронних зв’язків.

Робота нервової системи ґрунтується на рефлексах. Рефлекс — це реакція організму, що здійснюється за участі нервової системи у відповідь
на вплив зовнішніх або внутрішніх подразників. Наприклад, коли людина торкається гарячого або гострого предмета, то рефлекторно прибирає руку перш, ніж отримає пошкодження (мал. 15.4). Так злагоджено працюють спинномозкові нерви.
Мал. 15.3. Нервова система людини

Окрім нервової регуляції в організмі відбувається гуморальна регуляція та координація фізіологічних функцій організму.
Гуморальна регуляція відбувається за допомогою гормонів (від грец. ορμονη — «рухаю, збуджую»), продуктів обміну й навіть вуглекислого газу. Гормони — це специфічні біологічно активні речовини, які поширюються кров’ю та лімфою. «Виробниками» гормонів є спеціалізовані ендокринні залози, які здійснюють гумо-
Мал. 15.4. Нейрони за допомогою своїх відростків передають нервовий імпульс у спинний мозок, а потім до м’яза руки, який сприймає сигнал і скорочується.
У результаті рука відсмикується від голки кактуса
майбутньогопідручникаВидавництво
1. Досліджуємо світ науки
1. Чим відрізняються між собою нервова та гуморальна регуляції?
2. До якого типу рефлексів можна віднести бажання
маленького лисенятка вполювати їжака?
3. Наведіть приклади безумовних і умовних рефлексів, з якими ви можете стикнутися в повсякденному житті.
4. Розгляньте малюнок нейрона (див. мал. 15.2). Схарактери-
зуйте цей біологічний об’єкт
за планом: 1. Опис (форма).
2. Порівняння (з іншими біологічними об’єктами). 3. Асоціації (що спадає на думку? про що змушує думати?) 4. Аналіз будови (склад та як утворений).
5. Застосування (де та як «використовується» в організмі).
6. Ставлення (запропонуйте аргументи «за» або «проти» наявності його в організмі).
5. Доповніть фразу: «Мозок розвивається, якщо…».
6. Мрієте стати лікарем/лікаркою? Проведіть медичне спостереження за колінним рефлексом. Для цього запросіть когось із дорослих зручно присісти на стілець, щоб нога лежала на нозі. Ударте злегка ребром долоні по коліну. Відбудеться скорочення м’язів, що веде до розгинання ноги в колінному суглобі. Визначте рефлекси обох кінцівок і порівняйте їх.
ральну регуляцію, збільшуючи або зменшуючи синтез гормонів. Різні гормони виробляються в організмі людини в певний час доби.
Організм як єдине ціле
Отже, зв’язок між усіма органами організму та контроль за їхнім функціонуванням здійснює нервова система. Вона забезпечує узгодженість роботи органів. Так, наприклад, якщо відбуваються певні зміни в діяльності одного органа, вони впливають на весь організм загалом.
Гуморальна регуляція, яка також контролюється нервовою системою, допомагає підтримувати цілісну єдність організму, забезпечувати його нормальне функціонування. Наприклад, одні гормони впливають на ріст організму, інші — на розумову діяльність.
Ключова ідея
В організмах тварин відбуваються нервова та гуморальна регуляції. Нервова регуляція здійснюється за участі нервової системи через нервові електричні імпульси. Вони передаються за допомогою нейронів. Центральним органом нервової системи є головний мозок. Реакцією організму на подразники є рефлекс. За допомогою гормонів відбувається гуморальна регуляція фізіологічних функцій організму.
Дізнайтеся більше Чи можна поєднати медицину і мистецтво? Видатний біолог Ґреґ Данн досліджує мозок. Нейрони, які він бачив у мікроскопі, надихнули його на написання картин у стилі японського монохромного живопису «сумі-е». Так Ґ. Данн поєднав медицину з живописом, адже кожен
його художній твір дозволяє не лише насолодитися мистецтвом, а ще й досліджувати науку. Знайдіть в інтернеті та перегляньте роботи Ґ. Данна. Поділіться своїми враженнями. Уявіть нейрони та намалюйте їх у стилі «сумі-е».
Видавництво «Ранок»
Однією з властивостей живого організму є здатність відтворювати собі подібних, тобто розмножуватися. Розмноження необхідне для забезпечення безперервності життя.
Шляхом поділу клітин розмножуються, наприклад, відомі вам одноклітинні організми інфузорія й амеба (мал. 16.1).
Під час вегетативного розмноження від батьківського організму відокремлюється частинка, яка розвивається в окремий організм. Так розмножуються більшість рослин і деякі тварини, зокрема гідра (мал. 16.2).
У процесі спороутворення на батьківському організмі утворюються спеціалізовані клітини — спори, які згодом проростають у нові особини. Так розмножуються гриби (мал. 16.3) та деякі рослини.
Статеві клітини

Для статевого розмноження необхідне злиття статевих клітин. Така форма розмноження притаманна деяким рослинам, рибам, земноводним, плазунам, птахам, ссавцям, зокрема людині.

y Як з’являються нові рослини? y Як з’являються на світ тварини?
Ознаки живого.
загадка
Як процес життєдіяльності

одного з видів грибів допомагає спекти хліб?
Мал. 16.2. Вегетативне розмноження гідри брунькуванням
Мал. 16.1. Розмноження інфузорії
Мал. 16.3. Спороутворення у грибів
§ 16. Розмноження та його значення. Статеві клітини.
Розділ 1. Досліджуємо світ науки
Характеристика
Яйцеклітина
Розмір і форма Велика округла

Рухливість
Функції

Де утворюється

Порівняймо статеві клітини.

Малий видовжений
Нерухома
Забезпечує початкові етапи розвитку нового організму поживними речовинами
Яєчники
Мал. 16.4. Чоловічі й жіночі
статеві клітини в різних представників хребетних
Рухливий
Доставляє спадковий матеріал самців до яйцеклітин самок
Яєчка (сім’яники)
У процесі злиття яйцеклітини та сперматозоїда відбувається запліднення й утворюється нова клітина — зигота.
Розмноження рослин

На нашій планеті є величезна кількість рослин. І всі вони розмножуються. Найчастіше — насінинами, які утворюються в процесі статевого розмноження. Однак деяким рослинам властиве вегетативне розмноження (мал. 16.5). Вегетативні органи картоплі називають бульбами, часнику — зубцями, малини — живцями, полуниці — пагонами (вусами), гладіолуса — цибулинами
Розмноження тварин Для розмноження більшості тварин потрібні чоловічі клітини самців і жіночі клітини самиць. Під час зовнішнього запліднення, самиця кісткових риб (мал. 16.6), спочатку відкладає ікру, яку потім запліднює самець.
У птахів відбувається внутрішнє запліднення всередині організму, але вони не виношують пташенят. Більшість птахів висиджують їх із яєць.
Мал. 16.5. Вегетативні органи рослин
Мал. 16.6. Етапи розвитку кісткових риб


Для ссавців також характерне внутрішнє запліднення. Самиці виношують своїх дитинчат до моменту народження. А після появи їх на світ тривалий час вигодовують своїм молоком, навчають добувати їжу і захищають від ворогів (мал. 16.7).
Австралійський кенгуру розмножується раз на рік. Кенгуреня з’являється на світ за 27–40 діб. Воно сліпе й без шерсті. Вага дитинчати не перевищує 1 г, а довжина тіла — не більше 3 см. Щойно народившись, кенгуреня самостійно заповзає в сумку до мами, де живе і харчується молоком до 9 місяців (мал. 16.8).
1. Які форми розмноження притаманні рослинам і тваринам?
2. Що спільного у статевих клітин? Чим вони відрізняються?
3. У зоопарк привезли декілька різних яєць. Які тварини, крім птахів, можуть із них вилупитися? За потреби використайте додаткові джерела інформації.
4. Грецькою gameta означає «жінка», а gametes — «чоловік». Який процес поєднує ці слова?



5. Дізнайтеся назву і спосіб розмноження кімнатних рослин, які є у вас вдома або в класі.
6. Поміркуйте, чому дикі свині народжують поросят лише навесні, а свійські на фермах, — у будь-яку пору року.
Мал.
Ключова ідея Розмноження — одна з ознак живого. Є дві форми розмноження: нестатеве та статеве. У статевому розмноженні беруть участь гамети — статеві клітини. Для рослин типовим є розмноження насінинами. Більшість тварин роздільностатеві. Для запліднення, яке може бути як зовнішнім, так і внутрішнім, необхідно злиття яйцеклітини та сперматозоїда.
7. Ще 100 років тому в Європі ніхто не чув про узамбарські фіалки з Південної Африки. А сьогодні ми можемо милуватися їхнім цвітінням на підвіконнях. Спробуйте себе в ролі квітникаря/квітникарки та за можливості виростіть удома або в класі узамбарську фіалку. Зробити це дуже просто, адже її можна розмножувати за допомогою листків. Для цього достатньо відщипнути листок у дорослої рослини та вкоренити його. Спробуйте зробити це самостійно. Результат дослідження презентуйте у зручний вам спосіб.
Видавництво «Ранок»
y Для чого необхідно поливати рослини?
y Чому одні рослини ростуть краще, а інші — гірше?

y Для чого ми харчуємося?

y Чи може кішка постійно зростати?
y Ознаки живого.
y Як відбувається вегетативне розмноження?
y Що відбувається впродовж життєвого циклу тварин?
y Що таке кількісні та якісні ознаки?
загадка
Найвищою нацією у світі вважають данців, адже середній зріст їх чоловіків становить 183 см, порівняно зі 178 см в українських чоловіків. Жінки цієї країни також у середньому
вищі за українок. Чому всі люди різного зросту?

Що таке ріст?

Ріст — це процес збільшення розмірів і маси живої істоти. Він відбувається або за рахунок збільшення кількості клітин, або за рахунок їх розтягування.
У більшості комах, птахів і ссавців ріст організму після досягнення певного віку припиняється. Це — обмежений тип росту. Рослини, молюски, риби, плазуни ростуть упродовж усього життя. Цей тип росту називають необмеженим. Утім швидкість зростання в такому випадку з віком знижується. Наприклад, після народження крокодила з яйця до трьох років він зростає дуже швидко. А дорослий крокодил може вирости лише на декілька сантиметрів на рік. Але уявіть, до якого розміру може вирости ця тварина, якщо тривалість його життя майже 90 років (мал. 17.1).
Рівномірний ріст — це тип росту, за якого організм зростає поступово. Процес триває доти, поки особина або досягне певних розмірів, або настане її смерть (мал. 17.2).
Якщо періоди збільшення розмірів чергуються
періодами припинення росту, такий тип росту називають нерівномірним. Наприклад, ріст ракоподібних можливий лише в період зміни панцира (линьки). Дорослі особини линяють один раз на 4–5 місяців (мал. 17.3).
з
Мал. 17.3. Линька креветки

Ріст
Рослини ростуть лише за сприятливих умов навколишнього середовища. Особливо важливі для росту рослин температура, волога, повітря, світло та поживні речовини.
Насінини різних культур проростають за різних температур і вологості ґрунту (мал. 17.4 і 17.5).
У багатоклітинних тварин унаслідок росту та збільшення числа клітин (у результаті їхнього поділу) відбувається розростання тканин і формування нових структур (мал. 17.6).
У процесі життєвого циклу тварин їхнє тіло постійно змінюється: зовнішній вигляд, будова та пропорції, робота органів. Тобто відбуваються послідовні кількісні (ріст, маса тіла тощо) та якісні зміни (зір, слух, пам’ять тощо).
Мал. 17.4. Оптимальна температура для проростання насінин деяких сільськогосподарських рослин
Мал. 17.5. Потреба насінин у воді під час проростання

(% від маси)

Мал. 17.6. Під час росту клітин плоду в організмі жінки він збільшується в розмірах

Розділ 1. Досліджуємо світ науки
1. Із запропонованого переліку назвіть організми з обмеженим і необмеженим, рівномірним і нерівномірним ростом:
ведмідь, акула, кульбаба, дуб, виноградний слимак, крокодил, пінгвін, річковий рак, окунь.
2. Озиму пшеницю сіють восени, а яру — навесні. Як ви вважаєте, із чим це пов’язано?
3. Щоб раніше отримати врожай огірків, господарі й господарки накривають грядку поліетиленовою плівкою. З якою метою вони це роблять?
4. За малюнком 17.6 проаналізуйте й установіть відповідність між змінами росту плоду
людини та плодами рослин.

5. Проведіть вимірювання.

1) Визначте свій зріст і зріст когось із дорослих у сантиметрах. Притуліться спиною до
стіни або дверей і проведіть
олівцем позначку над головою.
2) Виміряйте відстань від підлоги до позначки.
3) Виміряйте довжину руки від долоні до плеча.
4) Виміряйте довжину ноги від п’яти до сідниці.
5) Який відсоток від зросту
становить довжина руки та довжина ноги у вас та в дорослих? Порівняйте результати обчислень і зробіть висновок.
Мал. 17.7. Із віком пропорції людського тіла змінюються
Дослідити ці зміни можна, якщо проаналізувати зміни пропорцій тіла на прикладі людини: голова в немовлят зазвичай непропорційно велика порівняно з тілом, нижні кінцівки — коротші, ніж у дорослих. У немовляти довжина голови становить 1/4 довжини його тіла, а в дорослої людини — 1/8 (мал. 17.7).
Ключова ідея

Збільшення розмірів і маси живих істот відбувається за рахунок збільшення кількості або розтягування клітин. Ріст живих організмів може бути обмеженим або необмеженим. Для росту рослин необхідні сприятливі умови. На ріст тварин впливають певні фактори: успадковані ознаки, харчування тощо.
Дізнайтеся більше
Щороку в стовбурі дерева формується так зване річне кільце. Завдяки цьому можна легко порахувати, скільки років було дереву. Узимку дерево майже не росте, а навесні і влітку ріст активний. Клітини стебла, які утворюються навесні, відрізняються кольором від клітин, утворених улітку. Тому на поперечному спилі стовбура видно чергування темних і світлих смуг, що утворюють річні кільця.
Видавництво
У попередньому параграфі ми говорили про ріст рослин. Коли рослина росте, відбуваються кількісні зміни: збільшується маса, об’єм, розмір. А розвиток рослин — це якісні зміни, які послідовно відбуваються в організмі: поява квітки, розкриття бруньки, формування плодів тощо. І за цими змінами ми з вами можемо спостерігати (мал. 18.1).
Сукупність стадій розвитку організму від проростання насінини і до відмирання називають життєвим циклом рослин.
Зміни, які відбуваються під час розвитку кожної рослини, починаючи з проростання насінини, можна легко відстежити. Вони відбуваються за певними фазами. Рослина послідовно проходить їх впродовж життя.
Дерева та чагарники «прокидаються» навесні: у них починається сокорух. Потім набрякають і розпускаються бруньки, з’являються листки. Згодом починається цвітіння. Через певний час відбувається дозрівання плодів і насінин.
А ближче до осені листя починає змінювати колір і врешті опадає. Дерево «засинає» до весни.
Докази розвитку рослин.
Дослідження «Проростання насінини»
Доведемо, що рослини розвиваються за допомогою дослідження.
Вам знадобляться: дві квасолини, скляна прозора банка, картон, ручка та паперові рушники.
1. Згорніть декілька паперових рушників у трубку та поставте в банку.
2. Згорніть в трубку картон та також помістіть у банку, щоб картон притиснув паперовий рушник до скла.
3. Роздивіться квасолини та знайдіть на кожній невеличкий виступ. Він зазвичай розташований посередині.

y Що означає слово «розвиток»?
y Як водорості стали рослинами суходолу?

y Гіпотези походження життя на Землі.
y Що таке ріст?
y Що таке циклічність?
y Ознаки живого.
загадка
Іноді ми чуємо в новинах, що десь в Україні восени зацвів каштан. Чи порушує дерево свій життєвий цикл, коли квітне два рази на рік? Символом якого міста є каштан?
Мал. 18.1. Якісні зміни рослини
18. Розвиток. Докази розвитку рослин,
4. Намалюйте на обох квасолинах стрілку, яка буде вказувати на цей виступ.
5. Покладіть квасолини в банку між паперовим рушником та склом так, щоб в одної квасолини стрілка показувала вгору, а в іншої — униз.
6. Налийте в банку трохи води та стежте, щоб паперові рушники були вологі.
7. Через декілька днів квасолини проростуть: з’явиться невеличкий корінчик, а потім і паросток. Та ви отримаєте паростки квасолі, які потім можна буде посадити в ґрунт.
8. Що сталося з квасолиною, яку посадили «догори ногами»?

Еволюція рослин
Еволюція рослин — це незворотний історичний розвиток рослин на Землі. Вона розпочалася від появи перших фотосинтезуючих еукаріотичних організмів і триває донині. Процес еволюції зумовлений змінами умов існування рослин на Землі. І всі існуючі сьогодні рослини, які ми можемо побачити на нашій планеті, є результатом тривалого історичного розвитку, тобто еволюції. Вона відбувається шляхом ускладнення

Видавництво
Мал. 18.5. Скам’янілі відбитки частин рослин
Мал. 18.6. Скам’янілі відбитки органів рослин
будови рослинних організмів — від примітивних одноклітинних водоростей до квіткових рослин.
Палеонтологія — це наука, яка вивчає вимерлі організми, їхні біологічні особливості для спостереження за перебігом біологічної еволюції. Наприклад, у покладах кам’яного вугілля та торфовищах на викопних породах можна побачити відбитки гігантських папоротей, хвощів, плаунів. Іноді у ґрунтових покладах різного геологічного
віку знаходять навіть квітковий пилок.
Палеонтологічні знахідки викопних решток рослин є найкращими доказами еволюції рослин. Було підраховано, що скам’янілі рештки збереглися в 0,1% усіх видів, які коли-небудь були на нашій планеті. Ключова ідея
Під час розвитку рослин у них відбуваються якісні зміни.
Життєвий цикл рослин поєднує всі стадії розвитку рослинного організму, на яких він послідовно зазнає якісних змін.
Незворотний історичний розвиток рослин (еволюція) триває на Землі понад мільярд років. Усі сучасні представники
рослин є результатом цієї еволюції. Хід біологічної еволюції досліджують палеонтологи/палеонтологині.
Дізнайтеся більше


Чи можуть каштани квітнути двічі за сезон і чому це відбувається? Уважають, що явище може бути пов’язане з тим, що через шкідників дерево втрачає листки. Виникає певна про -
1. Поясніть різницю між ростом і розвитком рослин.
2. Доведіть чи спростуйте твердження: «Процеси росту і розвитку взаємозалежні».
3. Чому березовий сік збирають навесні?
4. Чим життєвий цикл соняшника відрізняється від життєвого циклу яблуні?
5. Уявіть, що з’явилася машина часу, і вам запропонували подорож на 100 млн років тому. Скористайтеся додатковими джерелами інформації та опишіть вашу подорож доісторичним лісом. Які рослини ви там побачили?

6. Папороті, хвощі та плауни з’явилися на Землі близько 300–400 млн років тому. Вони утворювали ліси, адже були справжніми гігантами. Сучасні представники цих видів набагато менші за тих, що існували раніше. Спробуйте пояснити цей факт.
блема в дерева: воно «губиться» у порах року. Також цвісти дерево восени може змусити аномально висока температура, що не притаманна сезону.



y Чи відбуваються якісні зміни в рослин?
y Як можна простежити за змінами розвитку тварин?
y Як відбувалася еволюція рослин?
y Яких тварин сьогодні вже не можна побачити в природі?
У будь-якої тварини після запліднення починається процес формування зрілої дорослої особини. Перший його період називають зародковим. Він триває від запліднення до народження. Потім розпочинається післязародковий період, який триває до смерті. У різних видів він може бути від кількох днів до десятків років. Тварина змінюється впродовж усього життя, відбувається процес її індивідуального розвитку (мал. 19.1). Індивідуальний розвиток тварини — це всі перетворення, що відбуваються з організмом від зародження до кінця життя.
Прямий розвиток на прикладі курки
Післязародковий період розвитку, який починається або виходом зародка з яйцевих оболонок, або після народження, може відбуватися двома шляхами: прямим розвитком або непрямим розвитком (мал. 19.1). У післязародковий період відбувається найбільш активне життя тварин: досягнення статевої зрілості, розмноження, старіння організму та його смерть. Тривалість післязародкового періоду, тобто тривалість життя, у різних тварин може бути різною. Вона може бути від одного дня (муха-одноденка) до понад 500 років (молюск Arctica islandica) (мал. 19.2).
У деяких організмів, приміром у лососевих риб, смерть настає відразу після розмноження.
Непрямий розвиток на прикладі метелика
Мал. 19.1. Післязародковий період розвитку тварин
Мал. 19.2. Муха-одноденка та молюск-довгожитель Arctica islandica

Післязародковий період розвитку тварин


Під час процесу непрямого розвитку личинка, що з’являється з яйця, перетворюється на дорослу тварину.
Розгляньмо цей процес на прикладі комах. Існує два типи непрямого розвитку:
• з повним перетворенням, коли відбувається перебудова всіх органів і систем личинки;


• з неповним перетворенням, коли відбувається перебудова лише окремих органів і систем личинки, адже вона вже схожа за будовою на дорослих особин.
Непрямий розвиток із повним перетворенням на прикладі хруща
Еволюція тварин
Непрямий розвиток із неповним перетворенням на прикладі бабки
Еволюція тварин разом з еволюцією рослин є складовою біологічної еволюції — змін у природі, що відбуваються на Землі.
Початком еволюції тварин можна вважати появу перших тварин на нашій планеті. На думку наукової спільноти, це сталося близько 3,5–4,5 млрд років тому. Першими з’явилися одноклітинні організми: археї та бактерії, у клітинах яких не було ядра (прокаріоти).
За мільярд років виникли організми, у клітинах яких було ядро (еукаріоти). Саме їх вважають пращурами рослин, грибів і тварин.
загадка
У книзі «Парк юрського періоду» американського письменника Майкла Крайтона та в однойменному фільмі американського режисера Стівена Спілберга зображено дуже давніх істот. Митці «оживили» динозаврів, що спричинило справжню динозавроманію: від появи сувенірів до зйомок серіалів і блокбастерів. Динозаври стали невід’ємною частиною нашого життя. А чи живуть динозаври в природі сучасного світу?
майбутньогопідручникаВидавництво
1. Поміркуйте, який тип непрямого розвитку притаманний
жуку-оленю? За допомогою
циклічної діаграми поясніть
його життєвий цикл.
2. Розподіліть перелічених

комах за групами (комахи

з неповним чи з повним перетворенням): капустянка, клопчерепашка, комар, муха хатня, бджола, білан капустяний, сарана, бронзівка, воша, оса, тарган, хрущ, бабка.
3. Чим личинка відрізняється від лялечки, а лялечка — від дорослої особини?
4. Жук-Геркулес у середньому важить 100 г. У скільки разів більший за свою масу тіла вантаж може перенести жук, якщо він переніс на собі 8,5 кг загалом?
5. Як ви вважаєте, чи має якісь переваги прямий життєвий цикл над непрямим?
6. За додатковими джерелами інформації напишіть історію у стилі «сторітелінг» або намалюйте комікс про будь-який вид динозаврів.
трилобіти саламандра Караурус
Мал. 19.3. Скам’янілі рештки давніх тварин: а — ; б —
Приблизно 650 млн років тому Землю вже населяли перші багатоклітинні тварини: губки, медузи, плоскі черви. А потім поступово з’являлися предки ракоподібних і риб, деякі з них вийшли з океану на суходіл і стали пращурами земноводних (мал. 19.3).
225 млн років тому серед рептилій відбулося виокремлення групи динозаврів. Вони панували на Землі впродовж 160 мільйонів років! Припускають, що динозаври були проміжною ланкою між рептиліями та ссавцями.
Приблизно 66 млн років тому відбулося масове вимирання видів, зокрема й динозаврів, але розпочалася епоха ссавців.
Ключова ідея

Усі перетворення від зародження до кінця життя тварини називають індивідуальним розвитком. Після народження тварина може розвиватися прямим або непрямим розвитком. Еволюція тварин — це зміни в тваринному світі, що відбуваються в ході історії Землі.
Дізнайтеся більше Найбільшим жуком на планеті є жук-Геркулес. Його розміри сягають
до 170 мм. назву він отримав на честь давньогрецького міфологічного героя Геркулеса, бо також наділений неймовірною силою. Цей жук може піднімати й переносити предмети, які в декілька разів важчі за нього. Жук-Геркулес розвивається з повним перетворенням. Кожна стадія розвитку має свою тривалість життя: яйце — 4–6 тижнів, личинка — 1,5–2 роки, лялечка — 6 тижнів. А от повністю доросла особина (імаго) може прожити до шести місяців.
Видавництво
У XIX столітті видатний науковець Карл Ернст фон Бер першим виявив у людини яйцеклітину — жіночу статеву клітину. У попередніх параграфах ми говорили, що шляхом з’єднання яйцеклітини та сперматозоїда (чоловічої статевої клітини), здійснюється процес запліднення
з утворенням клітини, яка містить подвійний набір спадкової інформації — зиготи.
Через 24–36 годин після утворення зиготи відбувається перший її поділ, і вона перетворюється на двоклітинний ембріон (у перекладі з давньогрецької — «зародок»).
Зародковий (ембріональний) період триває від моменту утворення зиготи (запліднення) до народження.
За результатами своїх досліджень К. Е. фон Бер виділив певні етапи розвитку ембріона під час зародкового періоду розвитку багатоклітинних тварин, до яких належить і людина (мал. 20.1).
y Які зміни відбуваються з організмом людини впродовж життя?
y Чи відрізняється організм дитини від організму дорослої людини?
y Статеві клітини.
y Який період індивідуального розвитку тварин називають зародковим, а який — післязародковим?
y Що таке прямий і непрямий розвиток?

загадка
Скелет дорослої людини
розвитку Післязародковий період розвитку — це період життя тварин після народження, що три-
відбувається шляхом
складається в середньому з 200–213 кісток. У новонароджених зазвичай близько 270 кісток, більшість з яких дуже маленькі. Це робить скелет гнучкішим, допомагає дитині пройти через родовий канал і швидко рости. Чому в немовлят кісток більше, ніж у дорослих?
прямого
Видавництво
1. Досліджуємо світ науки
Мал. 20.2. Післязародковий розвиток людини
1. Що таке прямий розвиток?
2. Якими є особливості індивідуального розвитку людини?
3. За допомогою таблиці визначте, на якому періоді розвитку перебуваєте ви та ваші близькі.
4. Порівняйте личинку й ембріон: що в них спільного та чим вони відрізняються.
5. Які переваги, на ваш погляд, прямого розвитку над непрямим?
6. Підготуйте презентацію на тему «Довгожителі нашої планети».
ває до природної смерті. Нові організми подібні до дорослих особин, однак у рази менші й статево незрілі. У післязародковий період системи органів продовжують рости й розвиватися, а от загальний план будови організму залишається незмінним. Прямий розвиток у післязародковий період притаманний птахам, рептиліям, ссавцям. Розгляньмо прямий розвиток на прикладі людини (мал. 20.2).
Так само як і в тварин, у людини післязародковий період поділяють на певні вікові проміжки: дитячий період, підлітковий та юнацький, дорослий і старіння. Звісно, вони певною мірою умовні, адже можуть відрізнятися в чоловіків і жінок за часом настання або тривалістю, спадковістю чи способом життя. Для кожного періоду характерні певні ознаки розвитку. Наприклад, у дитячому періоді відбувається перебудова всього організму. Організм росте, розвиваються всі системи органів. У підлітковому періоді починається гормональна перебудова організму. У дорослий період життя робота всіх систем організму є найбільш ефективною. А в період старіння відбувається поступове згасання діяльності систем органів.
Ключова ідея

Під час зародкового (ембріонального) періоду спостерігаються певні етапи розвитку зародка. Після народження починається післязародковий період розвитку. Прямий розвиток притаманний для птахів, рептилій, ссавців, зокрема людини.
Дізнайтеся більше Чи можуть люди, які народилися в один день одного року, мати різний вік? Дата появи людини на цей світ — це дата її народження, відокремлення від організму матері, коли плід і його органи сформовані настільки, що можуть існувати самостійно. Але існує і дата зачаття — це дата злиття батьківських клітин в одну окрему
унікальну клітину. Із цієї клітини через дев’ять місяців виросте й народиться немовля. Тому в Китаї, Кореї та Японії існує східноазіатський розрахунок віку. За ним, коли дитина народжується, вона вже вважається дев’ятимісячною, і до дати народження додають дев’ять додаткових місяців.

Видавництво
Головною функцією ядра клітини є збереження спадкової інформації. У ньому містяться гени — одиниці спадкового матеріалу. Наука, що вивчає структуру та функції генів, називається генетикою.
Ген — це ділянка молекули ДНК. Що приховується за цими трьома літерами? ДНК — це дезоксирибонуклеїнова кислота — найважливіша молекула всіх живих організмів. Вона містить «інструкції», необхідні організму для його розвитку, життя й розмноження. Інструкції розташовані в ядрі кожної клітини та передаються
від обох батьків до нащадків.
ДНК своєю формою нагадує перекручену драбину.
Дослідження.
Виділення ДНК-вмісної суміші з банану
ДНК людини багато в чому збігається з ДНК інших тварин і навіть рослин. Так, ДНК людини схожа з ДНК шимпанзе на 95 %, із ДНК миші — на 70 %, із ДНК банана — на 50 %. Спробуємо виділити ДНК банана.
Вам знадобиться: банан, 1 чайна ложка солі, 1 чайна ложка рідини для миття посуду або шампуню, 120 мл гарячої води (не вище 80°), охолоджений у морозилці 95%-й етиловий спирт, пакет zip-lock, склянка, ситечко або марля, дерев’яна паличка.
Розчиніть сіль у гарячій воді. Банан покладіть у пакет і передавіть на пюре. Додайте до нього сольовий розчин, ретельно розмішайте паличкою. Додайте рідину для миття посуду і знову розмішайте. Через ситечко відфільтруйте суміш у склянку. Це може зайняти до 15 хвилин. Нахиліть склянку вбік і повільно наливайте охолоджений впродовж 2–5 хвилин спирт, поки він не покриє бананову суміш товстим шаром (не менше 2 см).
y Чому в людей різний колір очей і волосся?
y Чому тварини, зокрема людина, мають різну зовнішність?
Яку роль у клітині виконує ядро?
Розалінд Франклін (1920–1958) — британська біофізикиня і хімікиня. Зробила важливі відкриття у розшифруванні структури ДНК. Її рентгенівські знімки ланцюжка ДНК довели, що ДНК має форму подвійної спіралі.

1. Досліджуємо світ науки
Зачекайте 10 хвилин. У склянці має утворитися напівпрозора білувата речовина. Це і є ДНК банана.
Спіраль ДНК «упакована» за допомогою білків — гістонів, що в сукупності між собою складають хромосоми (мал. 21.1).
Мал. 21.1. «Упакування» спадкового матеріалу в ядрі клітини
Слово «хромосома» походить від грецьких слів «хрома» — колір і «сома» — тіло. На початку ХХ століття американські науковці і науковиці виявили подібність хромосом й генів. Вони дійшли висновку, що гени містяться в хромосомах, а їхня функція — передача генетичної інформації від батьків до дітей. У нормі людина має 23 пари хромосом.
Дослідження-гра «Хлопчик чи дівчинка?»
1. Що таке гени? ДНК? хромосома?
2. Поясніть, як передається
спадкова інформація від батька та матері дитині.
3. Як використовують знання про гени?



4. Які функції хромосом?
5. Що спільного між мовою програмування для комп’ютерів та ДНК?
6. Чи згодні ви, що діти та батьки завжди мають спільні зовнішні риси? Обґрунтуйте свою відповідь.
Шанс, хто народиться — хлопчик чи дівчинка, завжди становить приблизно 50/50. Переконатися в цьому нам допоможе гра-дослідження. Вам знадобляться: чотири намистини однакового розміру (три одного кольору і один — іншого), два картонні стаканчики, ручка та папір. Підпишіть стаканчики: «Мама» і «Тато». Покладіть дві намистини одного кольору в стаканчик «Мама». Це будуть Х-хромосоми жінки. В інший стаканчик покладіть дві намистини різного кольору. Це будуть Х та Y-хромосоми чоловіка. Тепер навмання витягніть по одній намистині з кожного стаканчика. Запишіть комбінацію хромосом та визначте стать «дитини»: чоловіча (ХY) чи жіноча (ХХ). Експеримент треба повторити не менше 20 разів. Підбийте підсумки. Кількість «немовлят» жіночої і чоловічої статі має бути приблизно однаковою, адже шанси дитини народитися жінкою або чоловіком становлять 50/50.
Ключова ідея
Найважливіша молекула всіх живих організмів — дезоксирибонуклеїнова кислота (ДНК). Вона містить спадкову інформацію. Форма ДНК — подвійна спіраль. Сукупності спіралей
ДНК складаються в хромосоми, через які передається генетична інформація від батьків до дітей.
1 «Тварі Землі є витвором складного космічного процесу, необхідною і закономірною частиною стрункого космічного механізму, де, як ми знаємо, немає випадковостей», — писав В. І. Вернадський. Яку гіпотезу походження життя на Землі він підтримував?
2 Дослідження «Спостереження інфузорій».
y Пригадайте правила користування мікроскопом.
y Налаштуйте мікроскоп і помістіть мікропрепарат з інфузорієютуфелькою на предметний столик. Оберіть потрібний об’єктив, обережно рухайте макро- та мікрогвинти, налаштуйте чіткість. Знайдіть інфузорію-туфельку. Використавши правило правої руки, замалюйте те, що побачили під мікроскопом. Зверніть увагу на особливості будови та руху одноклітинного рганізму. Зробіть
висновки.

3 Ви вже знаєте, що око людини є оптичною системою. А оптичні
системи мають певні характеристики, зокрема роздільну здатність.
Роздільна здатність — це найменша відстань між двома точками або лініями, коли вони ще сприймаються окремо одна від одної та не зливаються. У людини з нормальним зором роздільна здатність
становить 0,18 мм на відстані 25 см — відстані найкращого зору. Тому всі об’єкти, менші за розміром, людське око вже не в змозі розрізнити.
y Наведіть приклад найменшого об’єкта живої природи, який може побачити людина.
4 Дослідження «Діяльність клітин».
y Вам знадобляться: морквина, ваги, ніж, дві склянки, сіль.
y Налийте холодну воду в склянки. В одній розчиніть три столові ложки солі. Морквину розріжте ножем на дві половинки.
y За допомогою вагів
Зважте моркву та порівняйте з попередніми вимірюваннями. Чи стала вона важче? У склянці із солоною водою вода всередині клітин моркви виходила крізь клітинні мембрани. Як це позначилося на морквині? У склянці зі звичайною водою вода надходила в клітини моркви. Який результат ви отримали?
5 Дослідження «Вплив різних факторів на ріст і розвиток рослин» (виконується разом із дорослими).
y Для дослідження потрібно взяти дві рослини (краще однакові), які ростуть у горщиках.

y На першому етапі одну рослину поставте в місце з достатнім освітленням, а іншу — у затінок. Через тиждень порiвняйте зовнішній вигляд рослин та опишіть зміни.
y На другому етапі обидві рослини поставте поруч. Одну рослину поливайте як зазвичай, а другу — не поливайте зовсім. Щоденно разом із дорослими перевіряйте стан другої рослини. Лише ви побачите, що листки почали втрачати пружність, завершуйте експеримент. Через скільки діб це сталося?
y Під час дослідження рослини не повинні загинути!
y Результати дослідження презентуйте в зручний для вас спосіб.
6 Уявіть, що вам потрібно озеленити територію дачного будинку.
Ваше завдання — дібрати квіти для висаджування на двох
клумбах. Які квіти краще посадити, якщо клумба № 1 розташована з північного боку, а клумба № 2 — з південного? Для клумби № 1 урахуйте висоту рослин та їхнє розташування на клумбі.
7 Намалюйте за допомогою піктограм із будь-якого месенджера таке повідомлення: для росту рослин необхідні ґрунт, світло, тепло і волога.
Ми занурюємося у світ природничих наук
y Назвіть три факти, які ви дізналися з розділу.
y Наскільки важливими є ті завдання, які ви виконали?
y Де ви зможете використати знання з вивченого розділу?
y Під час вивчення матеріалу ви досягли певних успіхів. Що ви робили для цього?
y Де вам знадобиться новий досвід?
y Із якими перешкодами ви зіткнулися під час опанування розділу?
y Як ви подолали труднощі?

Форма Землі: диск, сфера, куб…
Уявіть собі печерну людину та її навколишній світ. Вона пересувалася лише на недалекі
відстані, і де б вона не була — земна поверхня здавалася їй пласкою.
Давні індійці уявляли Землю у вигляді півсфери, яку тримають три слони, що стоять на черепасі (мал. 22.1).
Жителі Вавилона зображували Землю у вигляді гори, на західному схилі якої розташована Вавилонія (мал. 22.2).
Достовірні уявлення про Землю та її форму складалися в різних народів не одночасно. Це сьогодні ми знаємо, що Земля куляста, і з легкістю можемо довести, що наш світ не плаский. А от у давнину люди так не вважали (мал. 22.3 на с. 66).
У стародавній Японії панувала думка, що Земля має форму куба. Так само й корінний народ Америки — інки — уявляли, що Земля є величезним порожнім кубом.
А от інші мешканці Америки — ацтеки — були впевнені, що живуть на поверхні, яка складається з п’яти квадратів. Центральний — це
y З яких джерел первісні люди отримували інформацію про навколишній світ?
y Чому наші предки горизонт називали круговидом, кругозором, кругоглядом?

y Яку форму має наша планета Земля?
y Що таке «екватор», «полюс», «меридіан»?
загадка
Близько 13 тисяч років тому наші пращури, які жили на території сучасної Черкаської області, зобразили на уламку бивня мамонта пагорби, ліси, річки. Для чого, на ваш погляд, люди використовували цей бивень?
Мал. 22.1. Уявлення давніх індійців

Мал. 22.2. Карта світу, створена у Вавилонії (кінець
VІІІ — початок VІІ ст. до н. е.)
Межиріч-карта — можливо найдавніша в Україні
Мал.

земна твердь, оточена водою, де живуть боги. А інші чотири квадрати мають свої власні ознаки, зокрема рослин і тварин.
Єгиптяни уявляли нашу планету у вигляді яйцеподібної сфери.
Стародавні греки не мали спільної думки щодо форми Землі: одні уявляли її диском, що нагадує щит воїна, а інші — у вигляді колони, на одному боці якої й живуть люди. Але в обох випадках суходіл омивав Океан-Ріка.

Докази кулястості Землі

Коли людство отримало можливість подорожувати, зокрема морем, поступово почали відкривати нові, невідомі раніше географічні об’єкти: гори, моря, острови, річки. А ще під час таких подорожей люди робили певні висновки щодо природи навколишнього світу.
Наприклад, фінікійці під час подорожі на човнах навколо Африки в 609–595 рр. до н. е. виявили, що Сонце перебуває не прямо над ними, а дещо праворуч. Але якщо Земля пласка, то Сонце завжди мало бути над головою.
Мал. 22.4. Поступова поява корабля з-за горизонту
Давньогрецький науковець Аристотель спостерігав за кораблями, які виходили в море. Він звернув увагу, що коли корабель із високими щоглами пливе за горизонт, то його корпус зникає з поля зору поступово (мал. 22.4). А це можна пояснити, лише якщо Земля має кулясту форму.
Досліджуємо Землю та життя на Землі
Аристотель узагальнив різні ідеї про кулястість Землі та навів нові докази на основі спостережень за зоряним небом. Зокрема він звернув увагу, що після перетину екватора сузір’я на небі змінюються. Так, до прикладу, в Єгипті можна побачити зорі, яких не видно на небі в північних регіонах. А Полярна зоря переміщається по небу все вище в міру просування на північ. Також під час повного місячного затемнення науковець замітив, що тінь, яку Місяць відкидає на Землю, завжди кругла. Так він дійшов висновку, що поверхня як Місяця, так і Землі куляста.
У ІІІ столітті до н. е. Ератосфен, якого сучасники називали Пентатлом (Багатоборцем), бо він займався не лише точними науками, а й філологією, філософією та музикою, зробив важливий науковий крок у доведенні кулястості нашої планети. Припускаючи, що Земля має форму кулі, він обчислив її окружність. Це стало найвідомішим серед його досліджень. Саме він першим назвав науку про землю словом «географія» (від гео — земля, графо — пишу).
Ключова ідея
У минулому панувала думка, що Земля пласка. Це було результатом знань стародавніх людей про навколишній світ. Згодом Аристотель довів, що Земля має кулясту форму, а Ератосфен першим виміряв її розміри.
Дізнайтеся більше
Мал. 22.5. Одним із доказів сферичної форми Землі
стали спостереження під час місячного затемнення, а саме тінь, яку відкидає Земля на Місяць
1. Чому, на ваш погляд, змінювалися уявлення людей про Землю?
2. Поясніть вираз «Ератосфен — “батько” географії».
3. Наведіть наукові факти, що доводять кулястість Землі.
4. Доведіть, що морські подорожі сприяли пізнанню світу.

5. Уважно розгляньте карту світу Ератосфена. Порівняйте її із сучасною картою півкуль (див. Додаток 1). Яких великих географічних об’єктів немає на карті Ератосфена?
Спираючись на звіти мореплавців і сухопутних мандрівників, Ератосфен створив доволі точні карти
відомих йому земель і морів.
У тритомному трактаті «Географія» він описав і зазначив розта-
шування понад 400 географічних
об’єктів.

Карта світу Ератосфена, реконструйована за трактатом
«Географія»
Запитання
y Уявіть себе первісною людиною. Які відкриття ви могли б зробити насамперед?
y Чи можна досліджувати Землю під час туристичних подорожей?
y Завдяки чому змінювалися уявлення людей про форму Землі?
y З якою метою люди подорожували в давнину?
та нових відкриттів
Із давніх-давен людство приваблюють нові об’єкти та новий досвід. Питання «що це?», «чому так відбувається?», «а що там далі?» дуже важливі для розуміння того, як влаштований світ. Але справжні відкриття роблять лише найнаполегливіші та працьовиті дослідники й дослідниці, керовані цікавістю. І саме цікавість спонукала людство до досліджень Землі.
Спочатку Homo sapiens (Людина розумна), яка за науковими даними з’явилася у Східній Африці приблизно 200 тисяч років тому, почала розселятися на інші континенти, зокрема в Європу й Азію, а згодом — в Америку та через острови Індонезії до Австралії (мал. 23.1). І хоча мандрами ці пересування назвати не можна, важливу інформацію про навколишній світ людство таки отримувало.
Мандрівки морем


Мал. 23.1. Розселення людства світом
Морські подорожі значно розширили можливості людства досліджувати навколишній світ. А з появою писемності люди почали ще й обмінюватися інформацією. Так відбувалося формування уявлення про форму й розміри Землі, про природні явища і процеси. Давні єгиптяни у XXVII столітті до н. е. першими почали плавати водами Середземного моря та досліджувати верхню течію річки Ніл (мал. 23.2).
Пізніше, у XII–X століттях до н. е. фінікійці та карфагеняни також плавали водами Середземного моря, а бл. 600 р. до н. е. обігнули на своїх кораблях Африку.
Мал. 23.2. У XXIX столітті до н. е. єгиптяни плавали на своїх кораблях водами Суецької затоки
Давні китайці у VII столітті до н. е. подорожували вздовж берегів Східнокитайського моря, відкрили острів Тайвань та дослідили гирло річки Янцзи.
Географічні знання також формувалися під час військових походів. Китайські завойовники у XIV–X століттях до н. е. дослідили долини річок Хуанхе та Янцзи, дійшли до узбережжя Жовтого й Японського морів, досягли Корейського півострова.
А результатом військового походу ассирійців

у 802–788 рр. до н. е. стали «Листи до Бога», що містили географічну інформації про Сирію, Палестину, Фінікію та східну частину півострова Мала Азія.
Завдяки завойовницький походам давні римляни дослідили все узбережжя Середземного моря ще до початку нашої ери (мал. 23.3.). У II столітті до н. е. вони завоювали Карфаген і вирішили
назвати свою нову провінцію Africa за назвою місцевого племені «афригії» або «африди».
Накопичувалася географічна інформація і під час мандрів у пошуках нових торговельних шляхів. Китайські мандрівники IV–III століть до н. е. склали перші географічні описи територій, що були відомі їм на той час.
А мандрівник Чжан Цянь у II столітті до н. е. дістався річок Сирдар’я та Амудар’я. Для цього йому довелося не лише перетнути степи та пустелі Центральної Азії, а й подолати гори Тянь-Шань і Памір. А його маршрут став славнозвісним «шовковим шляхом».
У цей період прокладали свої торговельні шляхи й індійські купці. Вони також подорожували через пустелі та гори Центральної Азії.
Наукові мандрівки давніх греків
Значних успіхів у вивченні Землі досягли стародавні греки. Під час своїх численних подорожей вони зробили низку важливих наукових відкриттів і винаходів. Фалес Мілетський першим запропонував використовувати поняття «горизонт» та «частини світу» (VII–VI століття
Мал. 23.3. На початку нашої ери римляни досягли берегів Перської затоки та
переправилися через протоку Ла-Манш
загадка
Ось як Геродот описував

Скіфію: « А як перейти Борисфен, то зразу ж перша від моря лежить Лісиста (Гілея), а від неї вгору живуть скіфиземлероби. Ті греки, що живуть над рікою Гіпанісом, називають
їх борисфенітами, а самі себе ольвіополісом. Ті скіфи-землероби займають землі на схід на три дні дороги; досягають ріки, що зветься Пантікап. Поблизу моря Борисфен вже потужна ріка. Тут до нього приєднується Гіпаніс, що впадає в один і той же лиман». Спробуйте розшифрувати записи Геродота та з’ясувати, які ще річки згадує Геродот в наведеному уривку, якщо Борисфеном давні греки називали Дніпро.
майбутньогопідручника
Видавництво «
Ранок»
Розділ 2. Досліджуємо Землю та життя на Землі

Науковий трактат Гекатея Мілетського був доповнений картами всіх відомих на той час земель. Скіфія на карті Гекатея
1. Чому в давні часи дослідники/дослідниці шукали відповіді на питання «де?» і «що?»?
2. Доведіть чи спростуйте думку: «Подорожі віддавна рухають і розвивають людську цивілізацію».
3. На карті півкуль знайдіть регіони, які описав у своєму творі Гекатей Мілетський. Чому, на ваш погляд, він відносив Африку до Азії?
4. Уважають, що Америку для європейців відкрив Христофор Колумб. А хто ще з європейців раніше за Колумба побував в Америці?
5. Чи залишилися сьогодні на карті світу «білі плями»? Обґрунтуйте свою думку.
до н. е.), його учень Анаксімандр у VІ столітті до н. е. для зображення земної поверхні вперше використав масштаб.
Гекатей Мілетський написав трактат «Землеопис». Він складався з двох частин: про Європу та Азію. До речі, Африку він включив до Азії. Гекатея Мілетського вважають засновником описового методу в географії.
Геродот у V столітті до н. е. мандрував південноукраїнськими землями та описав Дунай, що «тече через усю Європу, беручи початок в землі кельтів», Дніпро та зібрав цікаві відомості про народи, які там жили. Це перший опис Скіфії, який дійшов до нас. А вже відомий вам Ератосфен у своїй науковій праці «Географія» зібрав і систематизував усі накопичені на той час знання про Землю.
У І столітті до н. е. римський географ грецького походження Страбон узагальнив описи мандрівок і знання з фізики, математики, історії та астрономії у 17-томній науковій праці «Географія», над якою він працював усе життя.
У пошуках нових земель
Дослідження. Ми всі любимо слухати історії. А розповідати такі історії — то ціле мистецтво, яке сьогодні називають «сторітелінг». Уявіть, що за допомогою машини часу ви перемістилися в певну епоху. Підготуйте цікаву розповідь від імені дослідника/дослідниці Землі про історію їх відкриття. А допоможе вам карта «Географічні відкриття», портретна галерея видатних дослідників та будь-які джерела інформації (книги, фільми, інтернет).
Ключова ідея
Уявлення про Землю формувалося на досвіді мореплавання, військових походів, торговельних мандрівок тощо.
Але найбільший внесок зробили відважні люди — першовідкривачі — які вирушали на пошук нових земель, зокрема в навколосвітні подорожі.
«Білими плямами» називають необжиті, недосліджені райони планети. У ХХ столітті на карті Землі майже не залишилося місць, де б не ступала нога людини. Підкорилася дослідникам і Антарктида. Щорічно на антарктичних станціях працює до 4000 дослідників і дослідниць із понад 40 країн світу. А починалося все з хатини, яку 1902 року збудувала команда Роберта Скотта. Це була одна з перших постійних будівель в Антарктиді. 1903 року з’явилася «Omond House», яку побудувала Шотландська
національна антарктична експедиція (мал. 24.1).
Україна також має сучасну науково-дослідну базу в Антарктиці. 1996 року Велика Британія
за символічну ціну — 1 фунт стерлінгів передала
її нашій державі. Побудована 1947 року станція «Фарадей» була перейменована на Українську антарктичну станцію «Академік Вернадський».
А при Міністерстві освіти і науки України було створено Національний антарктичний науковий центр (НАНЦ) для здійснення наукових досліджень.
1953 pоку люди дісталися й найвищої вершини планети — гори Джомолунгма, або Еверест. Висоту у 8848 метрів подолали новозеландець Едмунд Гілларі та непальський шерп Тенцинґ Норгей.

1960 року людству «підкорилася» й найглибша точка Світового океану — Маріанська западина (жолоб). Батискаф «Трієст», на борту якого були французи Жак Піккар і Дон Волш, занурився на глибину 10 916 м, аж на самісіньке дно!


Через 52 роки потому, 26 березня 2012 року на дно Маріанської западини спустився видатний режисер Джеймс Кемерон. У його фільмі «Безодня» за сюжетом також відбувається занурення в океанічну западину. Згодом Кемерон сам спустився в глибини Маріанської западини та зафільмував його підводний світ.
Чи завершилася, на ваш погляд, епоха великих географічних відкриттів?
Хто і коли відкрив материки? Як це відбувалося?
Мал. 24.1. «Omond House» — перша постійна база в Антарктиді
Едмунд
загадка
Географія туризму надає людям уявлення про різноманітні об’єкти та пам’ятки природи, культури, історії у тій чи іншій країні, знайомить із видами й формами туризму.
Географія туризму використовує методи та інформацію всіх
природничих наук, а також гуманітарних і технічних.
Так з’явилися курортологія
і медична географія.
Як ви вважаєте, що вивчають представники цих наук?
Коли, здавалося б, всі таємниці Землі розкрито, а всі «білі плями» стерті, почали виникати проблеми. Адже людина активно втручається у природу. Тому сучасна географія вивчає відносини між природою і людиною, намагається знайти рішення спричинених людством проблем, радить, як безболісно для природи використовувати ресурси нашої планети. Такі дослідження
є комплексними, адже не можна, наприклад, вивчати проблему забруднення водойм та не зважати на зникнення у зв’язку з цим окремих видів тварин.
Прикладом таких досліджень є дослідження Землі з космосу. Понад 30 років на орбіті перебувають супутники для дистанційного зондування Землі ERS-1 та ERS-2. Вони виведені на орбіту в липні 1991 року та 1995 року, і є першими місіями Європейського космічного агентства (ESA) зі спостереження за Землею).
1. Наведіть приклади сучасних географічних експедицій для вивчення природи нашої планети.
2. Географія — одна з найдавніших наук. На які питання шукає відповіді сучасна географія?
3. Чому сьогодні людство дедалі більше уваги приділяє дослідженню екологічних проблем Землі? Чи є такі проблеми в Україні?
4. Якщо вам запропонують здійснити наукову подорож у будь-який куточок Землі, куди саме ви поїдете і чому? Сформуйте мету вашої подорожі.
5. Чи можна порівняти значення для науки сучасних космічних досліджень і використання астрономічних інструментів у XVI–XVII століттях?
Бортовий радар супутника отримує детальні зображення поверхні Землі і вдень, і вночі. Радіолокаційний сигнал легко проникає крізь хмари, і зображення можна отримати незалежно від погодних умов. Дані супутників допомагають стежити за навколишнім середовищем. Наприклад, за їх допомогою можна виявити нафтову пляму у відкритому морі. Радіолокаційні дані використовують для картографування небезпечних ділянок для судноплавства та для створення карт рельєфу морського дна. Крім того, такі супутники дозволяють вимірювати висоту морських хвиль і спостерігати за вітрами.
Ключова ідея
Людина дісталася найвіддаленіших куточків планети. Але дослідження не припинилися. Сучасна географія вивчає відносини між природою і людиною, щоб знайти рішення спричинених людством проблем і раціонально використовувати природні ресурси.
Ще в давнину людина малювала все, що бачила навкруги. Так з’явилися перші зображення земної поверхні — малюнки. Малюнок — це зменшене зображення земної поверхні, де видно лінію горизонту. Згодом з’явилися плани — зменшені, узагальнені зображення невеликої ділянки земної поверхні, карти та глобуси. Сьогодні до способів зображення Землі додалися аерофотознімки та космічні (або супутникові) знімки. Це фотографії місцевості, виконані з літального апарату, зокрема і супутника, у певному масштабі. Супутникові знімки дозволяють побачити Землю з різних кутів та відобразити особливості її поверхні.
Глобус — модель Землі. Види глобусів
У 5 класі ви дізналися, що глобус — об’ємна зменшена модель Землі. Усі географічні об’єкти позначені на ньому відповідно до їх розташування на земній кулі. Глобус не спотворює розмір і форму великих об’єктів та відтворює кут нахилу земної осі.
За розмірами (діаметром) глобуси поділяють на малі (до 60 см), середні (60–120 см) та великі (понад 120 см). А відповідно до картографічного зображення глобуси бувають загальногеографічні (фізичні) та тематичні. Загальногеграфічні глобуси відображають поверхню Землі без виділення певних її елементів серед інших. А тематичні детально показують окремі характеристики.
На фізичному глобусі зображені материки й океани, рівнини та гори, озера і річки, а також нанесені їхні назви (мал. 25.1 на с. 74).
Найпоширенішим варіантом тематичного глобуса є політичний глобус. На ньому ми побачимо адміністративний поділ світу: країни, їхні кордони, назви столиць і великих міст, найбільші транспортні шляхи (мал. 25.2).
З якою метою створювали перші карти?
y Що таке карта та які вони бувають за обсягом території?
y Яку форму має Земля?

y Що таке модель?
y Що таке глобус?
загадка
Уважають, що першим глобусом, який зберігся до наших часів, є глобус німецького
мореплавця Мартіна Бехайма. На глобусі М. Бехайма крім контурів суходолу та моря було нанесено 1100 власних назв, 48 прапорів, 48 правителів, 15 гербів, знаки зодіаку, кораблі, кити й морські чудовиська. Зображення материків та океанів мають суттєві невідповідності у відстанях і розмірах. На ньому зображені Європа, майже вся Азія та більша частина Африки, а от Америки на ньому не було. Як ви вважаєте, чому?
майбутньогопідручника
Видавництво
Ранок
Мал. 25.1. Фізичний глобус
Мал. 25.2. Політичний глобус
Мал. 25.3. Глобус «Будова Землі»
Мал. 25.4. Глобус Місяця
До тематичних належать також кліматичні, геологічні й тектонічні глобуси, глобуси рослинного і тваринного світу тощо (мал. 25.2–2.4).
Мал. 25.5. Віртуальний глобус Google Earth є найбільшим загальнодоступним сховищем географічних зображень
1. Назвіть способи зображення земної поверхні на площині.
2. За допомогою чого можна найкраще передати форму Землі?
3. Хто може використовувати Google Earth у своїй роботі?



4. Порівняйте шкільний фізичний глобус і Google Earth. У чому їх схожість та відмінності?
5. Розрахуйте масштаб глобуса Unisphere, якщо діаметр Землі 12 742 км.

6. Чи правильно, що глобус зберігає геометричну подібність контурів? Як це можна довести?
Цифровий глобус А чи можна, перебуваючи в класі чи вдома, спостерігати за нашою планетою з космосу? У сучасному світі цифрових технологій це можливо завдяки інтерактивному 3D-цифровому глобусу Google Earth, який поєднав географічні дані, супутникові й аерофотознімки. За його допомогою, зробивши декілька кліків мишкою, ми можемо опинитися в будь-якій точці Землі (мал. 25.5).
Інструменти Google Earth дозволяють робити різні вимірювання та проводити дослідження. Наприклад, ви можете стежити, як відбувається танення льодовиків Антарктиди, повторити подорож Христофора Колумба до берегів Америки, прокласти маршрут власної навколосвітньої подорожі тощо.

Ключова ідея
Способами зображення земної поверхні на площині
є карта, план, малюнок, аерофотознімок і космічний знімок. Найточніше зовнішній вигляд Землі передає її об’ємна
модель — глобус. Існують різні види глобусів, зокрема
загальногеографічні тематичні й цифрові інтерактивні.
Географічними прийнято називати карти, що відображають поверхню Землі або окрему її частину на площині в зменшеному вигляді за допомогою умовних знаків. Наука про географічні карти, методи їх створення та використання отримала назву картографія.
Для створення сучасних карт використовують різноманітні вимірювання, космічні та аерофотознімки. Уперше ділянку Землі над Парижем із повітряної кулі 1858 року сфотографував французький фотограф і повітроплавець Гаспар-Фелікс Турнашон (більш відомий як Надар).
Сьогодні на допомогу картографам приходять дрони. Встановлені на них камери можуть
швидко та якісно фотографувати ділянки земної поверхні.
Картографи проводять обробку таких знімків і всі сфотографовані об’єкти переносять на карту у вигляді умовних знаків.
Сьогодні в Україні працює Державне науково-виробниче підприємство «Картографія», яке займається створенням і виданням паперових карт, атласів, а також розробкою цифрових і електронних карт.
Головними характеристиками географічної карти є її сучасність, достовірність і наочність.
Географічні карти (як і глобуси) можуть відрізнятися за змістом, призначенням, охопленням території, масштабом.
Чому говорять, що без карти немає географії?
y Що таке карта?
y Що таке масштаб та які бувають карти, у залежності від нього?
y Для чого використовують карти?

загадка
Латинське слово charta (карта) означає аркуш паперу. У XVI столітті слово набуло поширення зі значенням «гральна». А у значенні «географічна» його почали використовувати лише у XVIII столітті. Синонімом слова «карта» у значенні карти місцевості є слово «мапа». Отже карта — поняття, що має декілька значень. У яких інших значеннях воно може вживатися?
Запитання і завдання
1. Чому карту називають другою мовою географії?
2. Складіть перелік професій, представники яких використовують карти у своїй професійній діяльності.
3. Поясніть вираз «Карти будьякого змісту та призначення із часом застарівають».
3. Наведіть приклади тематичних карт. 4. Визначте, до якого виду належить карта півкуль (Додаток 1): за змістом, за призначенням, за охопленням, за масштабом.
5. Які переваги (недоліки) мають географічний глобус, географічна карта та план місцевості? Обґрунтуйте свою відповідь.
6. Вольєр для птахів має ширину 10 і довжину 16 м. Обчисліть розміри вольєра на плані присадибної ділянки, якщо його масштаб: в 1 см — 2 м.
та життя на Землі
Мал. 26.1. Аерофотознімок місцевості Мал. 26.2. План місцевості
План місцевості

Залежно від розмірів території, яку необхідно зобразити на площині, для створення карти використовують різні масштаби.
Дослідження
1. З’ясуйте, який масштаб має карта півкуль, розміщена у Додатку 1.

2. Чи підійде такий масштаб для зображення невеликої ділянки земної поверхні?
План місцевості — це кресленик, на якому за допомогою умовних знаків зображено невелику ділянку земної поверхні в зменшеному вигляді. План більш інформативний, ніж аерофотознімки (мал. 26.1 і 26.2). На ньому позначають назви населених пунктів, озер, річок і, навіть, де можна знайти брід, щоб перейти річку, тощо.
Ключова ідея

План і карта — це зображення земної поверхні на площі за допомогою умовних знаків. На карті відображають великі ділянки земної поверхні, а на плані місцевості — невеликі. Карта має бути сучасною, достовірною та наочною. Класифікують карти за змістом, призначенням, масштабом тощо.
Дізнайтеся більше
У ІІ столітті Клавдій Птолемей першим використав слово «планісфера» (латин. planisphaerium) для зображення Землі. Так він назвав зображення сферичної Землі на площині. Унікальна планісфера італійця Урбано Монті, що зберіглася до наших часів, складається з понад 60 аркушів. Її можна переглянути в оцифрованому вигляді на сайті Девіда Рамсі (David Rumsey Map Collection).

Розгляньте карти, розміщені в додатках до підручника та у вашому атласі. Усі вони начебто різні, але всі мають однакові складники — елементи географічної карти. Для того, щоб створити сучасну достовірну карту, недостатньо самих умовних знаків. Зображення на ній складається з таких елементів: картографічного зображення (мал. 27.1), математичної основи, легенди (мал. 27.2), додаткових даних (мал. 27.3) і допоміжного оснащення (автори карти, рік створення тощо).
Умовні позначення
Для зручності «читання» інформації з карти картографи представляють її у вигляді умовних знаків. Легенда карти — це система умовних позначень і текстового супроводу до них. Вона є важливим елементом географічної карти.

Розгляньте топографічну карту, розміщену

в Додатку 2. Знайдіть на ній різні види умовних знаків.
Для зображення різноманітних об’єктів і явищ використовують різні види умовних знаків. Для географічних карт відповідного масштабу вони однакові й загальноприйняті, тому їх не завжди розміщують на самій карті. Існують навіть
Яку інформацію щодо кількісних і якісних ознак живої природи можна знайти на карті чи плані?
y Для чого люди складають карти і плани?
y Що означає вираз «читати карту»?
y Чим географічна карта відрізняється від контурної карти?
y Що таке рельєф?
y Що таке прямі та непрямі вимірювання?
Мал.
спеціальні таблиці умовних знаків. А на тематичних картах у легенді розміщують не лише знаки, але й пояснення до них (мал. 27.3 на с. 79).
Відносна та абсолютна висота


Важливе значення для інженерної та наукової спільноти, які використовують карти у своїй діяльності, має інформація про рельєф місцевості — пагорби, яри, рівнини, гори тощо та їх висоту. Та й туристам не завадить знати висоту пагорба, на який вони збираються піднятися. На місцевості виміряти висоту точки земної поверхні можна за допомогою спеціального приладу — нівеліра (мал. 27.4).

Перевищення однієї точки земної поверхні над іншою називають відносною висотою. Тобто це величина, яка показує, на скільки метрів одна точка розташована вище або нижче відносно іншої.
На карті та плані позначають абсолютну висоту — перевищення точки земної поверхні над рівнем моря, прийнятим за 0. В Україні відлік ведуть від рівня Балтійського моря (мал. 27.5).
Горизонталі, за допомогою яких на картах і планах зображують нерівності земної поверхні, відносять до лінійних умовних знаків.
Мал. 27.5.
та абсолютна висота
Горизонталі — це лінії на плані або карті, що з’єднують точки земної поверхні з однаковою
Мал. 27.6. Зображення нерівностей земної поверхні горизонталями

абсолютною висотою. На горизонталі абсолютну висоту позначають числами (мал. 27.6). Зверніть увагу, що і пагорб, і западина на карті можуть виглядати однаково. Для того щоб уникнути непорозумінь, перпендикулярно до горизонталі ставлять бергштрихи — рисочки, перпендикулярні до горизонталей невеликі штрихи (рисочки), які вказують напрям зниження схилу. Так, на зображенні підвищень бергштрихи будуть спрямовані вільним кінцем назовні, а у западинах — усередину контуру.
Висоту окремої точки місцевості на карті позначають крапкою, біля якої пишуть її висоту в метрах.
Географічні карти містять такі елементи: картографічне зображення, математичну основу, легенду, допоміжне оснащення та додаткові зображення. Інформацію подають
у вигляді умовних знаків. Їх поділяють на масштабні, позамасштабні та пояснювальні. Абсолютну висоту на картах позначають за допомогою горизонталей і підписів до них. Відносну висоту можна виміряти за допомогою нівеліра.
За своїм змістом карти можуть бути дуже різними. Для того щоб зобразити ту чи іншу інформацію, використовують різні візуальні способи її подання. Наприклад, корисні копалини показують значками, для автомагістралей підійде
1. Назвіть обов’язкові елементи географічної карти.
2. Чи можна визначити відносну й абсолютну висоту пагорба, зображеного на малюнку 28.9?
3. За допомогою фізичної карти України визначте абсолютну висоту найвищої точки України.
4. Які елементи карти можна побачити на фізичній карті півкуль та фізичній карті України (Додатки 1 і 3)? У чому полягає їх схожість, а в чому — відмінність?
5. На уроках літератури ви вивчали твори про козаків. Розробіть декілька умовних знаків для карти часів козацтва, щоб зобразити острів Хортиця на Дніпрі, окремі дерева на ньому, стежки та поселення козаків.
6. Обчисліть відносну висоту гори, якщо її абсолютна висота дорівнює 532 м, а горизонталь, яка проходить біля підошви, поєднує точки з абсолютною висотою 300 м.
спосіб лінійних знаків. А для зображення місць, де поширені певні види дерев, обирають спосіб ареалів. Течії в океані зображують знаками руху. Є також способи кількісного та якісного фону, картограм і картодіаграм тощо.
майбутньогопідручникаВидавництво


y Для чого необхідна математична основа карти?

y Чи можна перенести об’ємне зображення на площину без спотворень?
y Назвіть елементи географічної карти.
y Які існують види масштабів?
Виконаємо простий експеримент. Візьмемо мандарин, акуратно його почистимо та спробуємо розкласти шкірку на листі паперу (мал. 28.1). Чи зможемо ми це зробити та зберегти цілісність цієї шкірки? На жаль, нам це не вдасться.
Якщо уявити, що поверхня Землі — це мандаринова шкірка, то зобразити її на пласкій поверхні без розривів чи складок неможливо. На картах ми не бачимо таких розривів, тому що для створення плаского зображення використовують так звані картографічні проєкції — один з елементів математичної основи карти.
Картографічна проєкція — це математично визначений спосіб відображення кулястої поверхні Землі на площині.
Існує багато видів проєкцій, наприклад азимутальна мал 28.2. Більш докладно з ними ми ознайомимося в старших класах.
Мал. 28.1. Експеримент із мандариновою шкіркою
Масштаб. Вимірювання відстаней на карті Наступна складова математичної основи карти — масштаб, який показує ступінь зменшення відстаней певної місцевості, зображених на плані або карті.. Отже, за допомогою масштабу ми можемо виміряти відстань на карті між будь-якими об’єктами, а у багатьох випадках — і їхні розміри. Для цього використовують усі види масштабів (мал. 28.3).
Мал. 28.2. Азимутальна картографічна проєкція
Ще однією складовою математичної основи карти є градусна сітка, яку ми розглянемо в наступному параграфі.
Дослідження.
Вимірювання відстаней на карті
Нам знадобляться: лінійка, циркуль-вимірювач або курвіметр (мал. 28.4).
Мал. 28.3. Види масштабу
1. Пряму відстань на карті між двома точками можна виміряти за допомогою лінійки. Для отримання величини відстані між точками на місцевості в кілометрах чи метрах, одержаний результат вимірювання помножимо на знаменник числового або показник іменованого масштабу.
2. Якщо на карті зображений лінійний масштаб або необхідно виміряти ламану лінію, краще використати циркуль-вимірювач. Для цього ставимо голки циркуля на точки, між якими потрібно виміряти відстань. Потім розхил циркуля переносимо на лінійний масштаб так, щоб він вміщував ціле число великих і малих поділок. Ламану лінію вимірюють прямими відрізками та підсумовують результат.
3. Для точного вимірювання відстані, що представлена у вигляді кривої лінії, наприклад, по залізниці, краще використати курвіметр. Для цього коліщатко курвіметра прокочують вздовж об’єкта, довжину якого необхідно встановити. Результат вимірювання отримаємо на лічильному механізмі приладу. Зараз вже з’явилися і електронні курвіметри 4. Складіть завдання з вимірювання відстаней на карті (можна скористатися Додатками). Запропонуйте їх для виконання своїм однокласникам. Ключова ідея
Для відображення кулястої поверхні Землі на площині використовують картографічні проєкції. Масштаб карти дозволяє проводити вимірювання відстаней. Для цього можна використовувати такі інструменти, як лінійка, циркуль-вимірювач або курвіметр.
Дізнайтеся більше
Сучасні електронні курвіметри оснащені цифровими дисплеями. Встановлене програмне забезпечення дозволяє визначити довжину
лінії в кілометрах одразу під час вимірювання. Для цього слід обрати масштаб карти. Інформацію про вимірювання можна перенести на
Мал. 28.4. Інструменти для вимірювання відстаней на карті

1. Назвіть складові математичної основи карти.
2. Для чого потрібен масштаб?

3. Які одиниці довжини використовують для вимірювання відстаней на місцевості, плані та карті?
4. Назвіть масштаб фізичної карти України (Додаток 3) та масштаб фізичної карти півкуль (Додаток 1). Порівняйте, який із них крупніший, та поясніть, чому.
5. Визначте, в якому масштабі складено карту, якщо відстань між містами у 350 км на карті відповідає відрізку 10 см.
6. Складіть алгоритм знаходження відстані за допомогою цифрової карти Google maps.
комп’ютер і переносити дані в цифровому вигляді для подальшої обробки. А за можливості роботи з цифровими картами, наприклад Google maps, визначити відстань між об’єктами можна без вимірювань.
майбутньогопідручникаВидавництво



Як можна визначити розташування будь-яких географічних об’єктів на поверхні Землі?
y Яку форму має Земля?
y Де та ким були створені перші географічні карти?
y Що таке полюси та екватор?
y Скільки градусів становить повне коло та півколо?
загадка
Чи можна побачити меридіан, назва якого з латини перекладається як «полуденна лінія», у природі?
Ще одним елементом математичної основи карти є градусна сітка. Це система горизонтальних і вертикальних ліній — паралелей і меридіанів, проведених через однакову відстань. Уперше градусна сітка з’явилася на картах Ератосфена та Птолемея (мал. 29.1).
Сьогодні градусна сітка, яка складається з ліній паралелей і меридіанів, є на кожній карті чи глобусі. А ось на місцевості ви її не знайдете, адже ці лінії уявні (мал. 29.2).
Через кожну точку земної поверхні можна провести свій меридіан — найкоротшу лінію, що з’єднує Північний і Південний полюси. Але на картах чи глобусах їх проводять через певну кількість градусів. На фізичній карті півкуль у Додатку 1 меридіани проведені через 10°. Усі меридіани на земній кулі мають однакову довжину 180°, що дорівнює 20 003,93 км. На географічних картах меридіани мають форму дуг або прямих ліній, а на глобусі — півкіл.
Відлік меридіанів починають від нульового — Гринвіцького меридіана. Разом із 180-м меридіаном він ділить Земну кулю на дві півкулі — Західну і Східну.
Екватор — це уявна лінія на земній поверхні, усі точки якої рівновіддалені від полюсів. Він
Досліджуємо Землю та життя

Мал. 29.3. Географічні координати
ділить Землю на Північну та Південну півкулі. Крізь будь-яку точку земної поверхні можна провести лінію, паралельну екватору, — паралель. На фізичній карті півкуль у Додатку 1 вони проведені через 10°. Довжина паралелей різна. Найдовшою є екватор, довжина якого дорівнює 360° або 40 000 км. На північ і на південь від екватора довжина паралелей поступово зменшується до 0 км на полюсах (див. таблицю праворуч).
У II столітті н. е. Птолемей не лише вперше накреслив градусну сітку на карті. Він запропонував визначати за цими лініями положення
Довжина дуг паралелей
Паралелі, градуси

Географічні координати
Розділ 2. Досліджуємо Землю та життя на Землі
точки на земній поверхні, тобто визначати географічні координати: широту і довготу (мал. 29.3 на с. 83).
1. Чи всі меридіани мають однакову довжину? Чи всі паралелі мають однакову довжину?

2. Поясніть, чому довготу та широту вимірюють у градусах.
3. Поміркуйте, що поєднує гру «Морський бій» із визначенням
географічних координат. Аргументуйте свою відповідь.
4. Знайдіть на фізичній карті
півкуль п’ять країн, які ви
хотіли б відвідати (або вже відвідали). Визначте географічні координати їхніх столиць.
5. У назвах яких країн світу є слово «екватор»? Знайдіть їх на Google карті та з’ясуйте, чи дійсно екватор проходить через території цих країн.
6. Якби вам запропонували здійснити найкоротшу навколосвітню подорож, за яким маршрутом вона б проходила?
Намалюйте його на контурній карті.
Щоб визначити географічні координати об’єкта, потрібно визначити паралель, на якій він розміщений (географічна широта), та меридіан, який проходить через цей об’єкт (географічна довгота).
Якщо на карті об’єкт розміщений між двома паралелями, потрібно визначити широту найближчої до об’єкта паралелі (рахуємо від екватора) та додати до значення кількість градусів від цієї паралелі до об’єкта.
Такий самий алгоритм використовуємо для визначення довготи об’єкта, розміщеного між двома підписаними на карті меридіанами (мал. 29.4 на с. 83).
Ключова ідея
Через кожну точку на земній поверхні можна провести
меридіан і паралель, з яких складається градусна сітка. Меридіани — умовні лінії, які з’єднують полюси Землі. Усі вони однакові за довжиною. Паралелі — умовні лінії, які проведені паралельно екватору. Найдовшою паралеллю є екватор. За допомогою географічної сітки можна визначати географічні координати: широту і довготу.
Дізнайтеся більше
1851 року сер Джордж Ейрі визначив місцезнаходження нульового меридіану в Гринвічі для Сполученого Королівства. На той час більшість морських держав уже встановили свій власний початковий меридіан, який зазвичай проходив через відповідну країну. 1884 року на Міжнародній меридіанній конференції у Вашингтоні Гринвіцький меридіан став загальноприйнятим стандартом для відліку меридіанів. Але сучасні прилади GPS-навігації доводять, що через недосконалість інструментів, які використовували в ХІХ столітті, лінія нульового меридіану зміщена на 102 метри на захід від свого фактичного проходження і розташована у Гринвіцькому парку.
«Ранок»

У початкових класах ви ознайомилися зі сторонами горизонту та компасом — приладом для їх визначення. Процес визначення сторін горизонту та свого положення на місцевості відносно сторін горизонту й навколишніх предметів називають орієнтуванням.
Існують чотири основні сторони горизонту та чотири проміжні (мал. 30.1).
Найчастіше напрямок сторін горизонту визначають
стрілка завжди одним кінцем показує на Північ, а другим — на Південь. Але під час орієнтування не завжди необхідно рухатися чітко в напрямку основних чи проміжних сторін горизонту. Тому для більш точного визначення напрямку руху за компасом використовують азимут. Слово «азимут» з арабської перекладається як «шлях, напрям». Це кут між напрямом на Північ та напрямом на обраний об’єкт (мал. 30.2).
Відлік азимута ведуть від напряму на Північ за рухом годинникової стрілки, визначають у градусах і позначають великою літерою А. Величина азимута може змінюватися від 0° до 360° .
Для визначення азимута на плані зорієнтуйте його за допомогою компаса: напрямок на Північ на плані має збігатися зі стрілкою компаса, що вказує на Північ. Установіть компас у тій точці на плані, звідки потрібно вирахувати азимут
y Що означає вираз «мені треба зорієнтуватися»?
y Для чого можуть знадобитися навички орієнтуватися на місцевості?
y Що таке горизонт?
y Які є сторони горизонту?

y Кому та для чого потрібен компас?
y Що таке магнітний полюс?
загадка
Язик до Києва доведе? 2012 року в Житомирі була встановлена 6-метрова скульптура у формі металевого кованого язика, спрямованого в бік Києва. Чи можна зробити висновок, що саме в такий спосіб наші предки орієнтувалися на місцевості? До речі, українське прислів’я «язик до Києва доведе» має продовження. Яке саме?
за допомогою компаса. Його намагнічена
2. Досліджуємо Землю та життя на Землі
Мал. 30.3. Вимірювання величини азимута

1. Визначте, які азимути мають основні та проміжні сторони горизонту.
2. Поясніть, як визначити азимут на карті та на місцевості.
3. Використовуючи алгоритм, наведений у параграфі, за допомогою топографічного плану місцевості (Додаток 2), визначте: азимут між селами Наталівка та Будище.

4. У чому відмінність істинного та магнітного азимутів?
5. Чому, на ваш погляд, компас називають одним із чотирьох великих винаходів людства? З’ясуйте, про які три інші винаходи йдеться.
6. Уявіть, що ви працюєте в туристичній компанії, яка відправляє групи в екстремальні тури в пустелю, тропічні ліси тощо. Підготуйте пам’ятку туристам, як вони можуть зорієнтуватися в тій чи іншій місцевості, якщо відстануть від групи та заблукають.
(точка стояння), та за допомогою шкали визначте азимут на предмет. Виміряти величину азимута на плані можна також за допомогою транспортира. Для цього проведіть олівцем лінію на Північ через точку стояння на плані. На плані місцевості напрям на Північ часто позначають стрілкою. Якщо стрілки немає, то Північ плану буде вгорі. Потім поєднайте цю точку з об’єктом, на який потрібно визначити азимут, і виміряйте кут, що утворився (мал. 30.3).
Дослідження: орієнтування на місцевості за допомогою традиційних і сучасних методів Розгляньте малюнок 30.4 та з’ясуйте, які із зображених способів для орієнтування на місцевості могли використовувати в давнину.
Які інші методи доступні нашим сучасникам?
Мал. 30.4 Визначення напрямів на місцевості
Ключова ідея
Зорієнтуватися на місцевості означає правильно визначити своє положення щодо сторін горизонту. Найчастіше орієнтуються за допомогою компаса. Напрям встановлюють за шкалою компаса, визначивши азимут.

На уроках літератури й історії ви вже ознайомилися з різноманітними міфами та легендами.
У деяких із них йшлося про утворення Землі.
Так, за міфологією стародавніх греків Гея (Земля)
виникла в первісному Всесвіті після безмовного безмежного Хаосу. Вона породила Урана (небо), Понт (море) та створила гори (мал. 31.1).
За однією з українських легенд Земля, Сонце, Місяць і зорі утворилися зі шматків кулі, яка спочатку колихалася в повітрі, а потім розірвалася. Землю від падіння в безодню утримав своїм хвостом велетенський кит. А коли він рухає тим хвостом — земля починає ворушитися.
У Біблії також йдеться про те, як Бог створив Усесвіт.

Сьогодні існує декілька гіпотез щодо походження Землі. Зауважимо, що гіпотеза — це не дійсний факт, а припущення, яке може бути доведене експериментально, а може бути й спростоване. Так, наприклад, Джеймс Джинс спростував гіпотезу Канта-Лапласа, а згодом і його гіпотеза була спростована.
Чи існують докази того, що Земля утворилася мільярди років тому?
y Яке місце в Сонячній системі займає Земля?
y Що таке гіпотеза?
y Які є гіпотези походження життя на землі?
y Що таке «молодик» та «повня»?
Мал. 31.1. Гея

Земля? Наукові гіпотези
Мал.
2. Досліджуємо Землю та життя на Землі

Сучасна наукова спільнота схиляється до
думки, що виникнення Землі пов’язане з формуванням Сонячної системи. У центрі газопилової хмари, з якої виникла Сонячна система, відбувалося ущільнення речовини та підвищення
її температури. Із цієї сконцентрованої речовини сформувалося Сонце.
Оскільки хмара речовини швидко оберталася, частинки пилу спочатку розсіювалися, а потім злипалися і стискалися під дією гравітаційних сил. Так 4,5–4,8 мільярдів років тому виникла Земля й інші планети (мал. 31.2).
1. Коли з’явилися перші гіпотези утворення Землі?
2. Чим гіпотези про утворення Землі відрізняються від легенд і міфів?
3. У чому схожість чи відмінність перших гіпотез утворення
Землі з припущеннями, що поширені в сучасній науці?
4. Поміркуйте, яким було б життя на Землі без Місяця.
5. За допомогою техніки малювання «дудлинг» візуалізуйте тему уроку. Посередині аркуша напишіть слово «Земля» та інтуїтивно створіть візерунок, використавши слова-поняття: Сонце, Місяць, планети, газ, пил тощо. Поділіться малюнками та враженнями від роботи.
Видавництво «Ранок»
Місяць — «молодший брат» Землі
Коли Сонячна система формувалася, навколо неї літали різноманітні космічні уламки. Є припущення, що Місяць утворився під час гігантського
зіткнення Землі з одним із таких уламків — протопланетою Тея. Коли планети зіткнулися, частина зовнішнього шару Землі відділилася, утворивши Місяць, який став її супутником. Алессандра Мастробуоно-Баттісті разом із колегами Ізраїльського технологічного інституту змоделювали процес зіткнення об’єктів у молодій Сонячній системі та дійшли висновку, що ця гіпотеза щодо утворення Місяця є найбільш імовірною.
Ключова ідея
Існує декілька гіпотез щодо утворення Землі: з уламка Сонця, газової хмари тощо. Сьогодні найбільш ймовірною є думка, що Земля, як і вся Сонячна система, сформувалася з газопилової хмари 4,5–4,8 мільярдів років тому.
Дізнайтеся більше
у звичайному розумінні цього слова. Від самого моменту народження Всесвіт був і залишається однорідним і безмежним. Просто він розширюється у всіх напрямках.
Пригадайте, як узимку ви ліпите сніжки з пухкого снігу, стискаючи його долонями. Так само майже п’ять мільярдів років тому частинки газо-пилової хмари стискалися, щоб згодом утворилася Земля. Але була вона не холодною, а розжареною. За кулястою формою нашу планету також можна порівняти зі сніжкою. Але через добове обертання навколо своєї осі вона не ідеально кругла, а дещо сплюснута біля полюсів і нагадує еліпсоїд (мал. 32.1).
У науці форму Землі характеризують як геоїд. Це форма Землі, визначена з використанням рівня моря та уявним його продовженням під земною поверхнею (мал. 32.2).
Після утворення Земля була розпеченою, але поступово охолоджувалася. Сьогодні ми можемо спокійно ходити її поверхнею, хоча всередині все ще зберігаються дуже високі температури. Під верхнім шаром Землі — земною корою — розташована мантія. На неї припадає понад 80 % об’єму Землі та майже 70 % її маси (мал. 33.3 на с. 90). Верхній шар мантії — це астеносфера, речовина якої частково нагріта до 1000 °С і пластична.
Під твердою речовиною мантії перебуває розплавлене зовнішнє ядро. А в ньому ніби «плаває» тверде внутрішнє ядро, температура якого близько 5000 °С. Склад та особливості внутрішнього ядра ще до кінця не вивчені. Тому інформація щодо температури ядра є висновком, отриманим за результатами різноманітних досліджень, а не вимірювання.
Типи земної кори Земна кора також не є однорідною. Тому геологічна спільнота виокремила два основні та один
Чи існує зв’язок між внутрішньою будовою Землі та утворенням материків?
y У якому стані перебувала Земля одразу після утворення?
y Яку форму має Земля?


y З яких оболонок (геосфер) складається наша планета?
y У якому стані перебувають внутрішні оболонки Землі?



Мал.
Мал.
перехідний типи земної кори. Розгляньте малюнок 32.4 та з’ясуйте відмінності між океанічним і материковим типами земної кори.
Перехідний тип земної кори перебуває на межі між ділянками океанічної та материкової кори. Він складається з базальтового шару та дуже потужного шару осадових порід над ним.
Уважають, що спочатку вся земна кора була океанічного типу. Але вона поступово потовщувалася та зазнавала змін, поки не набула сучасного вигляду.
Мал. 32.5. Літосферні плити
»
1. Назвіть внутрішні шари Землі, починаючи від поверхні. Чим вони відрізняються?
32.6.
Літосфера та її рухи
Поверхня Землі не є суцільною. Вона, як пазл, складається з взаємопов’язаних частин — літосферних плит (мал. 32.5). Їхня товщина може сягати 60–100 км, вони складаються як з океанічної, так і з материкової кори. А межі між ними проходять уздовж глибоких розломів у земній корі. Оскільки земна кора легша від мантії, літосферні плити повільно, але безперервно переміщуються в горизонтальному напрямку, наче «плавають» на астеносфері зі швидкістю до 5 см на рік. Там, де плити стикаються, одна з них починає занурюватися під іншу (мал. 32.6). При зіткненні материкових плит на суходолі виникають гори. А в зоні їх розходження формуються серединно-океанічні хребти й нова океанічна кора.
Цей процес можна легко уявити, якщо згадати, як навесні річкою плавають крижини.
Ключова ідея
Земля має форму геоїда. Її середній радіус — 6371 км. У внутрішній будові Землі виділяють земну кору, мантію, зовнішнє та внутрішнє ядро. Земна кора може бути океанічною або материковою. Літосфера складається з літосферних плит, які повільно рухаються.
більше
2. Поясніть, чому екваторіальний радіус Землі дорівнює 6378,14 км, а полярний радіус — 6356,78 км
3. Чим яйце подібне до Землі?
4. На карті (мал. 32.5) знайдіть найбільші плити: Євразійську, Африканську, Північноамериканську, Південноамериканську, Індо-Австралійську, Антарктичну, Тихоокеанську, Аравійську. Позначте на контурній карті межі літосферних плит і підпишіть їхні назви. 5. За допомогою карти літосферних плит і фізичної карти півкуль (Додаток 1) з’ясуйте, який географічний об’єкт розташований вздовж східної межі Африканської та Євразійської літосферних плит. Поясніть причину його утворення.
6. Спробуйте змоделювати рух літосферних плит. Для цього налийте в пласку посудину воду та заморозте. У другу, трохи більшу, посудину налийте воду та покладіть у неї попередньо розколотий на декілька шматків лід із першої посудини. Потроху починайте рухати посудину та стежте, що буде відбуватися з крижинами.

Розлом Сільфра в Національному парку Тінгвеллір в Ісландії — це тріщина між Північно-Американською та Євразійською плитами. Він виник 1789 року через землетруси, що супроводжують розходження двох тектонічних (літосферних) плит. Це місце, де зустрічаються і дрейфують два континенти, віддаляючись один від одного на 2–7 см на рік.

Дізнайтеся

Чому на Землі існує декілька континентів, а не один?
y Скільки років нашій планеті?
y Скільки материків та океанів є на земній кулі? Назвіть їх.
y Що таке літосферна плита?
y Чи є земна кора під океанами?
y Коли виникло життя на Землі?
загадка
Ще донедавна багато хто з наукової спільноти вважав, що материки не рухаються.
Сьогодні переважає думка, що кожні декілька сотень
мільйонів років утворюється
новий суперконтинент. Що
дало змогу зробити таке припущення?

Площа поверхні нашої планети становить 510 млн км2 та складається з шести материків і п’яти океанів. Материк — це величезний масив суходолу, що оточений водою. Ми звикли до їх сучасного вигляду на глобусі. На початку ХХ століття Альфред Вегенер у своїй теорії дрейфу материків припустив, що мільйони років тому на Землі існувала лише Пангея «Єдина земля» (мал. 33.1). Гігантський материк був оточений єдиним океаном. Із часом він розколовся на Лавразію і Гондвану, на яких згодом утворилися розломи. Причиною появи тріщин й розломів були горизонтальні тектонічні рухи, тобто рухи літосферних плит, які не припинилися
й нині. Це призвело до появи нових материків та океанів. На створення теорії дрейфу материків науковця наштовхнули подібності в геологічній будові континентів та їх контурів. Нещодавно науковці з Австралії та Нової Зеландії зробили сенсаційну заяву про відкриття нового континенту, який вони назвали Зеландія (Zealandia) (мал. 33.2). Але, на жаль, лише 2 % його території височіє над водами океану. Це — острови Нова Зеландія і Нова Каледонія. А решта 98 % континенту перебуває під водою.
Геологічний літопис — життєпис Землі
Наша планета має власний життєпис, що отримав назву геологічний літопис. Це геоло-
Мал. 33.1. Теорія дрейфу материків
Досліджуємо Землю та життя на Землі
гічна історія Землі, складена на основі вивчення гірських порід. Ці знання дозволяють складати
геологічні карти, знаходити родовища корисних копалин тощо.

Проміжок часу, впродовж якого відбувався розвиток Землі, називають геологічним часом. У геології його розділяють на часові проміжки тривалістю в кілька десятків або сотень мільйонів років. Кожен такий проміжок — геологічна ера — характеризується певним етапом формування земної кори й органічного світу. Також була створена геохронологічна таблиця — шкала, що відображає послідовність основних етапів геологічної історії Землі та розвитку життя на ній (мал. 33.3).
В історії Землі виділяють п’ять ер, різних за тривалістю. Архейська ера — це ера найдавнішого життя. А ми живемо в Кайнозойську
еру — еру нового життя. Кожну еру поділяють
на періоди, також різні за тривалістю: від 20 млн до 100 млн років. Свої назви вони отримали від назв гірських порід, характерних для цього часу, або від місцевостей, де проводилися дослідження.
Мал. 33.2. Зеландія
1. Який із п’яти океанів з’явився на наших картах недавно?
2. Чим можна пояснити, що контури материків та океанів постійно змінювалися?
3. За допомогою геохронологічної таблиці з’ясуйте, скільки мільйонів років тому утворилося кам’яне вугілля та крейда?
4. Чи може наука в подальшому вплинути на утворення нового суперконтиненту?

5. Назви двох періодів у геохронологічній таблиці походять від назв давніх племен, що жили на території сучасної Великої Британії за часів Римської імперії. За допомогою додаткових джерел інформації з’ясуйте, що це за племена та які періоди назвали на їх честь. 6. Квадрат розміром 10×10 см або іншу фігуру розріжте на частини, як на малюнку.
Мал. 33.3. Геологічна шкала Землі

Ключова ідея
У результаті тектонічних рухів на Землі утворилося шість материків і п’ять океанів. Проміжок часу, впродовж якого відбувався розвиток Землі, називають геологічним часом.
За допомогою цього паперового танграму спробуйте скласти материки земної кулі. Придумайте свій суперконтинент, який можливо з’явиться на Землі за сотні мільйонів років.

y Чому вулкани називають «вікнами» в надра Землі?
y Як вулкани можуть «пробудити» зиму?

y Що таке рельєф?
y Назвіть найбільші форми рельєфу земної поверхні.
y Що відбувається в результаті руху літосферних плит?
загадка
Один із найвідоміших вулканів на Землі — Везувій, що
в Італії. У стародавні часи з його кратера вдарив вогняний фонтан, небосхил закрили хмари попелу, а місто Помпеї повністю «потонуло» у магмі та попелі.
Чому люди й досі живуть на схилах вулканів попри небезпеку їх виверження? А на
Везувії навіть працює найстаріша вулканологічна станція.
У попередньому параграфі ми розглянули утворення материків і западин океанів, що є найбільшими планетарними формами рельєфу. Над їхнім створенням «попрацювали» потужні внутрішні сили Землі: внутрішня енергія планети, сила тяжіння і сили, які виникають під час обертання Землі.
Геологічні процеси, зумовлені енергією, яка виникає у надрах Землі, називають ендогенними, або внутрішніми. Із ними пов’язане не лише формування рельєфу, а й утворення багатьох корисних копалин.
На межі, де земна кора переходить у мантію, розташована пластична розплавлена речовина — магма. Оскільки літосферні плити перебувають у безперервному русі, вони можуть стикатися і розходитися. А магма прагне заповнити місця в утворених розломах. Підняття магми супроводжується
Досліджуємо Землю та життя на Землі
виділенням газів під високим тиском. Вони пробивають канали в земній корі, через які магма виходить на поверхню Землі. Цей процес називають вулканізмом. А магму, яка виливається на поверхню Землі під час виверження вулканів, називають лавою. Так утворюються вулкани (мал. 34.1).
Канал, через який вулканічні породи виходять
на земну поверхню, називають жерлом вулкану, а його витік — кратером.
Поступово діяльність вулкана припиняється.
Такі вулкани називають згаслими. До прикладу, вони є в Карпатах і Криму (вулкан Карадаґ).
Вулкани поширені на земній поверхні нерівномірно. Найбільше їх у Тихому океані, де вони утворюють Тихоокеанське вулканічне кільце.
Проєктна діяльність: виготовлення моделі вулкана
Вам знадобиться: пластилін, 5 чайних ложок оцту, 2 чайні ложки питної соди, 1 чайна ложка рідини для миття посуду, червоний барвник (якщо є), фарби, невеличка вузька посудина, пластиковий лоток.
1. Зліпіть із пластиліну вулкан та поставте його в пластиковий лоток. За бажанням розфарбуйте.
2. У середину вулкана встроміть вузьку посудину.
3 Насипте в посудину соду, додайте рідину для миття посуду та барвник. Перемішайте.
4. Налийте у посудину оцет (обережно, буде брудно!) і спостерігайте за виверженням вулкана.

В областях сучасної вулканічної діяльності іноді можна спостерігати, як періодично з-під землі під тиском виплескує фонтан гарячої води і пари.
Це — гейзери, які іноді ще називають водяними вулканами (мал. 34.2).


Гейзери — досить рідке природне явище. Їх утворення пов’язане з особливими умовами, які є лише в кількох місцях на Землі. Коли до тріщини в земній корі, заповненій ґрунтовою водою, надходять гарячі гази й водяна пара, вода закипає
Мал. 34.2. Гейзер Стрімбоут є найбільшим гейзером у світі. Під час виверження гейзер викидає воду на висоту до 90 м
Ранок»
Розділ 2. Досліджуємо Землю та життя на Землі
і викидає стовп води, що перебувала зверху над нею. Згодом тріщина знову заповнюється холодною водою, і цикл повторюється. Уважають, що майже половина гейзерів світу зосереджена в Єллоустоунському національному парку, що у США.
Мал.
Землетрус

1. Назвіть внутрішні сили Землі. Які процеси з ними пов’язані?
2. У чому схожість (відмінність)

вулканізму та землетрусів?
3. Як можна відрізнити звичайні гори від вулканів?
4. На заході України здійснюються сейсмічні дослідження.
З якою метою їх проводять саме в цьому регіоні? Хто може використовувати ці знання?
5. Позначте на контурній карті межі сейсмічних поясів і вулканів, про які йшлося в тексті підручника.
6. Поміркуйте, для чого можна використовувати гарячу воду гейзерів.
У результаті зміщень і розривів земної кори та верхньої частини мантії утворюються землетруси — підземні поштовхи та раптові струси земної поверхні (мал. 34.3). Місце в товщині земної кори або мантії, де виникають поштовхи, називають вогнищем (гіпоцентром) землетрусу. А ділянку земної поверхні, розміщену над джерелом, називають епіцентром землетрусу. Землетруси можуть бути дуже руйнівними. Це залежить від сили поштовхів. За спостереженнями й дослідженнями землетрусів було розроблено спеціальну шкалу для їхньої оцінки. Прилад, за допомогою якого ведуть спостереження, називається сейсмографом.
Найсильніші землетруси спостерігають у Середземноморському, Тихоокеанському й Атлантичному сейсмічних поясах, Альпах, Гімалаях, Тянь-Шані, Кордильєрах.
Ключова ідея
Геологічні процеси, пов’язані з енергією, яка виникає в надрах Землі, називають ендогенними. До них належать тектонічні рухи земної кори, вулканізм і землетруси. У районах вулканічної діяльності іноді утворюються водяні вулкани — гейзери. Під час землетрусів відбуваються підземні поштовхи різної сили.
Дізнайтеся більше У с. Старуня Богородчанського району Івано-Франківської області є унікальний Старунський грязьовий вулкан. Після землетрусу 1977 року з’явилися перші кратери, з яких на висоту 3 м вихлюпувалася рідина, що складалася з газу, води, глинистої пульпи, а часом нафти. Ця рідина має високу мінералізацію та цінні лікувальні властивості. Сьогодні вулкан складається з 8 великих і 12 малих кратерів, його висота становить 3 м, а довжина глинистих потоків — 10-60 м.
Видавництво «Ранок»

Над рельєфом нашої планети активно «працюють» енергія Сонця, сила земного тяжіння і навіть живі організми. Усі ці чинники спричиняють зовнішні, або екзогенні процеси, які відбуваються безпосередньо на поверхні Землі або у верхній частині земної кори.
І якщо в результаті ендогенних процесів утворюються великі форми рельєфу, то під час екзогенних відбувається їх поступова руйнація та перетворення на інші, менші форми.
У дитинстві ми всі бавилися з піском (мал. 35.1). Але важко уявити, що колись він був частиною гігантських скель, які в результаті вивітрювання перетворилися майже на пил.
Вивітрювання — це процес руйнування та хімічної зміни гірських порід і мінералів земної поверхні та приповерхневих шарів літосфери під впливом різних зовнішніх чинників.
Повітря та вода з розчиненими в ній речовинами здатні руйнувати гірські породи. Наприклад, у процесі такого хімічного вивітрювання польовий шпат (який в Україні називають польовиком) перетворюється на глину (мал. 35.1). Саме з глини в давнину почали виробляти перший штучний матеріал — кераміку.
У пустелях і горах, де характерні значні добові зміни температури, відбувається фізичне вивітрювання (мал. 35.2).
y Як може змінюватися поверхня Землі під дією вітру чи води?
y Чи може діяльність людини впливати на стан і вигляд земної поверхні?
y Які процеси належать до ендогенних?
y Яке значення для формування літосфери мають ендогенні процеси?
y Що таке температурне розширення?


загадка
Є такий латинський вислів: «Gutta cavan lapidem», що в перекладі означає «крапля камінь точить». Йдеться про наполегливість: якщо щось робити довго і завзято, то отримаєте необхідний результат. Але постає питання: чи дійсно падіння краплин може пошкодити чи навіть зруйнувати камінь або цілу скелю? Мал.
Мал. 35.2. Фізичне вивітрювання: під дією коливань температури гірські породи руйнуються
За умов, коли добова температура повітря коливається близько 0 °С, відбувається один із видів фізичного вивітрювання — морозне. Відомо, що вода в процесі замерзання збільшується в об’ємі. Тому коли вона потрапляє в дрібні тріщини в гірських породах і замерзає, то поволі їх руйнує, розриваючи зсередини.
Органічне вивітрювання — це руйнування гірських порід живими організмами (бактеріями, мохами, лишайниками, корінням дерев, землерийними тваринами тощо), які оселяються на породах (мал. 35.3).

Мал. 35.3. Органічне вивітрювання живими організмами
Робота морських вод може бути як руйнівною, так і твірною, коли з наносного матеріалу утворюються коси, стрілки та пляжі.
Так само «працюють» і льодовики. Коли вони сповзають гірськими схилами, то «шліфують» їхню поверхню як наждачний папір, а також тягнуть за собою уламки. Скупчення цих уламків, які переносяться та відкладаються льодовиками, називають мореною.
У пантеоні богів Стародавньої Греції почесне місце посідав Еол — бог вітрів. Саме на його честь утворені в результаті роботи вітру форми поверхні називають еоловими.
Робота вод

Дослідження

У неглибоку посудину насипте невелику кількість будь-якого ґрунту у формі гірки. Візьміть склянку води та потрохи лийте її на вершину. Водний

розмиваючи ґрунт. Цей процес називають ерозією (з латини — «роз’їдання»).

У природі такі вимоїни поступово збільшуються і перетворюються на яри (мал. 35.4). Якщо цьому не запобігти, то із часом яри можуть зруйнувати дороги, сільськогосподарські угіддя тощо.
Річки також розмивають береги й утворюють річкові долини. А зруйнований матеріал відкладається у руслі та гирлі річки (мал. 35.4).
Підземні води у товщі земної кори можуть розчиняти такі м’які гірські породи, як сіль, крейда, вапняк тощо та вимивати їх. У таких місцях поверхня просідає, утворюються неглибокі западини, схожі на блюдця. Цей процес називають суфозією (мал. 35.5). У результаті розчинення гірських порід утворюються підземні порожнини — карстові печери, шахти (мал. 35.6). Ключова ідея
Екзогенні процеси відбуваються на поверхні Землі або у верхній частині земної кори внаслідок дії енергії Сонця, сили земного тяжіння та життєдіяльності організмів. До них належать вивітрювання, робота води, вітру, моря і льодовиків. У результаті земна поверхня частково руйнується, але утворюються й нові форми поверхні.
Дізнайтеся більше

Найдовша печера Європи — Оптимістична.
Вона розташована в Україні поблизу с. Королівка (Тернопільська обл.). Загальна протяжність
1. Назвіть види вивітрювання та поясніть причини, що його зумовлюють.
2. Чим ендогенні процеси відрізняються від екзогенних?
3. Яку роботу з формування поверхні Землі виконують зовнішні сили?
4. На фізичній карті України знайдіть і назвіть коси та стрілки, що утворилися в результаті роботи морських вод у Чорному й Азовському морях.
5. Запропонуйте дії, які допоможуть запобігти утворенню ярів або вповільнити їх збільшення.
6. Чи згодні ви, що екзогенні процеси нагадують роботу скульптора? Відповідь поясніть.
її ходів, нанесених на карту, сягає понад 260 км. Також це найбільша гіпсова печера світу.
Запитання і завданняМал. 35.5. Западина, що виникла в результаті суфозії
Видавництво
Про що йдеться у прислів’ї «Блискавка блисне — й камінь трісне»?
y Із чого складається літосфера?
y Назвіть агрегатні стани речовини.
y Чи однакові всі гірські породи? Що в них спільного та відмінного?
y Як класифікують гірські породи за походженням?
y Що таке цикл?
і гірських порід Земна кора дуже неоднорідна. Вона складається з великої кількості різноманітних гірських порід і мінералів. Мінерали — це тверді неорганічні речовини, що характеризуються однорідною структурою та певним хімічним складом. Вони сформувалися в результаті геологічних процесів і є складовими гірських порід. Сьогодні відомо понад 5,5 тис. мінералів (вода — найпоширеніший мінерал на Землі, слюда, алмаз, золото тощо).
У XIX столітті німецький мінералог Фрідріх Моос створив шкалу твердості мінералів. Це 10 мінералів, розташованих у послідовності
від найм’якішого до найтвердішого. Для того, щоб визначити твердість мінералу за шкалою, необхідно подряпати його нігтем, монетою, ножем тощо (згідно з правою колонкою шкали).
Шкала твердості мінералів
за Моосом Мінерал Абсолютна твердість Чим можна подряпати
Твердість
1 Тальк 1 Дряпається нігтем
2 Гіпс 3 Дряпається нігтем
3 Кальцит 9 Дряпається мідною монетою
4 Флюорит 21 Легко дряпається ножем
5 Апатит 48 Із зусиллям дряпається ножем
6 Ортоклаз 72 Дряпається напилком
7 Кварц 100 Піддається обробці алмазом, дряпає шибку
8 Топаз 200 Піддається обробці алмазом,
Уявіть себе мінералогом/мінералогинею та розгляньте мінерали (попарно), які наведені в таблиці. Хоча у своєму складі ці пари мінералів мають однакові атоми, але за хімічною будовою і властивостями, зокрема твердістю, вони відрізняються. За допомогою шкали Мооса (с. 100) визначте твердість цих мінералів.
Гірські породи — це природні тіла, які перебувають у земній корі та складаються з одного чи декількох мінералів.
Гірські породи мають різне походження. Коли магма з вулкана потрапляє на земну поверхню, вона охолоджується й утворює магматичну породу. Згодом під дією погодних умов чи, до прикладу, річкового потоку ця порода розпадається на невеликі шматочки осаду. У міру його накопичення й затвердіння утворюється вже осадова порода. Із часом вона знову опиниться глибоко в земній корі, де під дією високого тиску
і високої температури змінить свої властивості
та перетвориться на метаморфічну породу. Цей процес, що триває безперервно впродовж усієї геологічної історії нашої планети, отримав назву гірського циклу (мал. 36.1 на с. 102).
Назва
мінералу
Корунд
Вигляд мінералу
Які
атоми

є у складі мінералу
Алюміній
Топаз Алюміній
Аметист
Силіцій
Кварц

Силіцій
Флюорит
Кальцій
Кальцит
Кальцій
Мал. 36.1. Гірський цикл
1. Наведіть приклади гірських порід і мінералів.
2. Як можуть утворюватися гірські породи?

3. За якими ознаками можна класифікувати мінерали?
4. До якого типу за походженням належать: пісок, граніт, базальт, кам’яне вугілля, торф, мармур, крейда?
5. Порівняйте гірський цикл і життєвий цикл рослин. Що в них спільного, а чим вони відрізняються?
6. Із додаткових джерел інформації дізнайтеся, які корисні копалини є у вашій області. Підготуйте повідомлення про значення цих корисних копалин у діяльності людини.
Людство здавна використовує гірські породи та мінерали для своїх потреб. Їх називають корисними копалинами й умовно розподіляють на три групи, залежно від мети використання.
Паливні корисні копалини використовують як паливо: кам'яне та буре вугілля, нафта, газ, торф. Рудні копалини є сировиною для виплавки металів: руди чорних металів (залізні й марганцеві руди) та руди кольорових металів (мідні, олов’яні, поліметалічні руди тощо). Як сировину для хімічної промисловості використовують нерудні копалини (сірку, кам’яну та калійну солі тощо), а пісок, граніт, мармур, вапняк тощо — це будівельні матеріали.

Літосфера нашої планети складається з різноманітних за своїм складом і походженням гірських порід і мінералів. Завдяки гірському циклу магматичні й осадові породи перетворюються на метаморфічні. Гірські породи та мінерали, які людство використовує у своїй діяльності, називають корисними копалинами.
Дізнайтеся більше Тустань — середньовічна наскельна фортеця-град і митниця XII–XVI століть, давньоруський наскельний оборонний комплекс, залишки якого розташовані в Українських Карпатах (у Стрийському районі Львівської області, поблизу с. Урич). Скельний комплекс Тустані — це залягаючі шари пісковику. Форма і характер скель сформувалися внаслідок вивітрювання.
В одних місцях пісковики мають форму великих монолітів, у інших — безладно нагромаджених брил. У них є багато тріщин, ніш, невеликих печер, зокрема рукотворних. Форма і характер скель сформувалися внаслідок вивітрювання. В одних місцях пісковики мають форму великих монолітів, у інших — безладно нагромаджених брил. У них є багато тріщин, ніш, невеликих печер, зокрема рукотворних.

Сукупність усіх нерівностей земної поверхні утворює її рельєф. Він є важливим компонентом географічної оболонки Землі. Форми рельєфу відрізняються за походженням, віком, історією, формами, розмірами. Вони утворилися та продовжують утворюватися в результаті дії внутрішніх і зовнішніх сил Землі. За розміром виокремлюють
планетарні форми, найбільші, великі, середні, дрібні та найдрібніші.
Планетарні — це найбільші форми рельєфу, до яких належать материки та западини океанів (ложа океанів). Знайдіть їх на карті півкуль (Додаток 1).
Материки складаються з кори материкового типу. Їх середня висота становить 970 м, а найвищою точкою є гора Джомолунгма (8844,43 м). Ложа океанів — це основна частина дна Світового океану, складена з кори океанічного типу. Середня глибина дорівнює 3704 м, а найнижча відмітка — Маріанська западина у Тихому океані (11 022 м).
Найбільші форми рельєфу — це рівнини та гори Дрібними формами рельєфу є карстові блюдця, печери, яри, балки, річкові долини, дюни тощо.
А от кротовина, яку залишив після себе кріт, або горбик на луках, порослий травою (який ще називають купиною), — це найдрібніші форми рельєфу (мал. 37.1).
До утворення певних форм рельєфу причетна людина. Це — антропогенні, або техногенні, форми рельєфу. Наприклад, під час видобутку вугілля шахтним способом на поверхні Землі утворюються штучні насипи — терикони (мал. 37.2). Їх можна побачити
цькій областях України. До техногенних форм належать також канали, залізничні насипи, кар’єри тощо.
Чи може змінитися кількість материків і океанів на нашій планеті в майбутньому?
y Назвіть складові географічної оболонки.
y Що таке рельєф?
y Як утворилися материки й океанічні западини?
y Які процеси впливають на формування поверхні Землі?
y Як називають лінії на плані та карті, що поєднують точки з однаковими абсолютними висотами?

2. Досліджуємо Землю та життя на Землі



Мал. 37.3. Основні форми рельєфу та їх зображення на карті
Рельєф, його зовнішній вигляд, походження тощо досліджує наука геоморфологія.
Зображення рельєфу на фізичній карті
У попередніх параграфах ми ознайомилися з умовними знаками для зображення рельєфу на плані, зокрема горизонталями. На фізичних картах також проводять горизонталі, але через 50, 100, 200, 500, 1000 м. Щоб таке зображення рельєфу було більш наочним, проміжки між горизонталями зафарбовують у різні кольори (мал. 37.3).
Мал. 37.4. Шкала висот і глибин
1. Назвіть найбільші позитивні та негативні форми рельєфу.
2. На карті півкуль покажіть материки й океани.
3. Як можна визначити форми рельєфу на картах?
4. Порівняйте способи зображення рельєфу на плані та карті. У чому відмінність?
5. Які форми рельєфу притаманні вашій місцевості?
6. Чи може людина змінювати рельєф нашої планети? Аргументуйте свою думку.
Для визначення висоти певної точки використовують шкалу висот і глибин, розміщену на карті (мал. 38.4). На ній зображені горизонталі та ті самі кольори, що й на карті: від зеленого кольору, яким позначають низькі ділянки суходолу, до коричневого, яким позначають гори. Чим гори вищі, тим колір темніший.
Для зображення рельєфу дна океану проводять ізобати — лінії, що поєднують точки з однаковою глибиною. Проміжки між ними зафарбовують у різні відтінки синього кольору: чим більші глибини, тим колір темніший.
Ключова ідея
Рельєф — це сукупність усіх форм земної поверхні. За розміром виокремлюють такі форми рельєфу: планетарні, найбільші, великі, середні, дрібні та найдрібніші. Материки та западини океанів є планетарними формами рельєфу. На фізичних картах рельєф зображують за допомогою горизонталей, проміжки між якими зафарбовують у відповідні кольори. Для визначення висоти використовують шкалу висот і глибин.
Видавництво
Основними найбільшими формами рельєфу, які утворюються на материках, є рівнини та гори. Рівнини — це великі ділянки земної поверхні з невеликими (не більше 200 м) коливаннями висот та ухилом до 5° (мал. 38.1). Їх основою
є платформи — стійкі пласкі ділянки земної кори в межах літосферних плит, на яких майже не відбуваються магматичні прояви. Рівнини
займають близько 2/3 площі суходолу та найбільше пристосовані для життя.
Рівнини класифікують за певними ознаками, зокрема за характером поверхні, утворенням, абсолютною висотою тощо.
Із попередніх параграфів ви дізналися, що земна кора постійно рухається, зокрема піднімається. І ті її ділянки, де колись було дно моря, із часом перетворюються на суходіл. Так утворюються первинні рівнини, як-от Причорноморська низовина (мал. 38.1).
У процесі руйнації гір утворюються вторинні рівнини. До цього типу рівнин належать також
низовини, утворені річковими наносами, наприклад Індо-Гангська низовина (мал. 38.2).
На Землі ідеально пласких рівнин майже не трапляється. Їхня поверхня певною мірою вирівняна. А на горбистих рівнинах є окремі височини та низовини, пагорби й пасма. Також на рівнинах часто трапляються яри і балки.
y Чим рівнини відрізняються від гір?
y Чи можуть рівнини бути розташовані нижче рівня моря?

y Чи можуть рівнини бути абсолютно рівними?
y Назвіть позитивні та негативні планетарні форми рельєфу.
y Як класифікують форми рельєфу за розміром?

y У результаті дії яких сил утворюються найбільші форми рельєфу?
y Що таке літосферні плити?
Мал. 38.1. Причорноморська низовина
Мал. 38.2. Індо-Гангська низовина
1. Знайдіть на фізичній карті півкуль і позначте на контурній карті найбільші рівнини світу: Амазонську низовину, плоскогір’я Гобі, Східноєвропейську рівнину, Аравійське нагір’я, Ла-Платську низовину, Великі рівнини, Велику Китайську рівнину, Бразильське плоскогір’я, Індо-Гангську низовину.
2. За допомогою шкали висот визначте їхні абсолютні висоти.
Мал. 38.3. Волинська височина
1. Яким кольором на карті позначають рівнини?
2. За якими ознаками класифікують рівнини?
3. Яку інформацію про рельєф України можна отримати з фізичної карти України?
4. За фізичною картою України визначте, у межах якої форми рельєфу розташований ваш населений пункт, область.

5. Використовуючи пластилін, пап’є маше або вологий пісок, змоделюйте форми рельєфу, характерні для вашої місцевості.
6. За допомогою додаткових джерел інформації створіть
фотоколаж про найбільші рівнини світу та їх рослинний і тваринний світ.

Майже вся територія нашої країни розташована в межах рівнинних ділянок Східноєвропейської рівнини. І лише 5 % її території припадає на гори. Здійснімо умовну подорож із півночі України на південь, почавши від заболоченої Поліської низовини. На сході України вона переходить у горбисту Придніпровську низовину. Тут трапляється велика кількість ярів і балок. А на самому півдні України розташована Причорноморська низовина. Якщо рухатися з північного заходу на південний схід України, ми перетнемо Волинську, Подільську, Придніпровську, Приазовську й Донецьку височини, абсолютні висоти яких подекуди сягають майже 500 м (мал. 38.3). Поверхня рівнин і височин України ускладнюється меншими формами: кряжами, останцями, пагорбами, пасмами, річковими долинами, ярами, балками, карстовими печерами та шахтами. До змін рельєфу долучилися і люди, залишивши після себе в місцях видобутку корисних копалин кар’єри та терикони.
Ключова ідея
Рівнини розрізняють за висотою (низовини, височини, плоскогір’я), характером поверхні (пласкі й горбисті) та утворенням (первинні і вторинні). Більша частина території України розташована в межах рівнинного рельєфу.
Видавництво

Тектонічні платформи відокремлені одна від одної поясами складчастості — рухливими тектонічними структурами. Для них характерна постійна тектонічна активність, зокрема вулканічна діяльність і землетруси. І саме в межах поясів складчастості формуються гори.
Гори — це великі ділянки земної поверхні, які високо піднімаються над рівнем моря та характеризуються різким коливанням висот. Гори утворюють гірські системи, що складаються з гірських хребтів, міжгірських западин і долин.
Процес формування гірських систем під впливом внутрішніх сил Землі, який триває і сьогодні, називають горотворенням. Уявіть, скільки часу потрібно, щоб гори «виросли» заввишки декілька кілометрів, якщо за рік їхня висота збільшується на 1–10 мм.
Гори класифікують за декількома показниками: утворенням, абсолютною висотою та характером рельєфу.
1. Знайдіть на фізичній карті півкуль і позначте на контурній карті гори: Кримські гори, Карпати, Альпи, Скандинавські гори, Гімалаї,
Чи «ростуть» гори в наш час?
• Як внутрішні сили Землі змінюють рельєф планети?
• Як утворюються вулкани?
• Які основні форми рельєфу притаманні материкам?
• Як визначають абсолютну висоту місцевості?
загадка
Назва гірської системи Гімалаї в перекладі з санскриту означає «Серце снігів». А найбільшу їх вершину Еверест (інша назва — Джомолунгма) у Тибеті називають «Матір Усесвіту». Як ви вважаєте, чому вони отримали такі назви?
Видавництво
«Ранок»
Розділ 2. Досліджуємо Землю та життя на Землі
Тянь-Шань, Анди, Кордильєри, Великий Вододільний хребет, Атлаські гори.

2. За допомогою шкали висот визначте їхні середні висоти та найвищі точки (вершини).


Дослідження Декілька шарів пластиліну різного кольору розташуйте один поверх іншого (як багатошаровий пиріг). Розріжте заготовку на дві частини. Уявіть, що кожна із цих частин — літосферна плита. Повільно рухайте частини у напрямку одна до одної та починайте притискати. Повільно зближаючись, плити зіштовхуються та зминаються у складки. Так утворюються складчасті гори. Брилові гори утворюються в результаті руху окремих ділянок земної кори, розламаної на окремі брили. Складчасто-брилові гори є результатом деформації вже зім’ятих у складки порід, які втратили пластичність (мал. 39.1).
Як утворюються вулкани, ви знаєте з попередніх параграфів. Коли декілька вулканів, розташованих неподалік один від одного, поступово зливаються застиглою лавою, утворюються вулканічні хребти.
Мал. 39.1. Типи гір
Мал. 39.2. Українські Карпати. Буковель
Окрасою південно-західної частини нашої країни є Українські Карпати. (мал. 39.2). Найвищою їх точкою є гора Говерла (2061 м). Середня висота хребтів Карпат — від 700 до 1500 м. Тому за висотою їх відносять до середніх гір, що сформувалися наприкінці мезозойської та впродовж кайнозойської ери. Цей період гороутворення отримав назву Альпійської складчастості, оскільки саме тоді почали формуватися Альпи. Гірський рельєф Українських Карпат — це поєднання скельних виступів гірських порід, урвищ зі стрімкими схилами та глибоких річкових долин. Північно-східні схили гір круті, а південно-західні — пологі.

Українські Карпати
На самому півдні нашої країни на Кримському півострові розташовані складчасто-брилові Кримські гори, які почали формуватися також під час Альпійської складчастості (мал. 39.3). Ці гори займають лише 1 % площі України. Найвищою їх точкою є гора Роман-Кош (1545 м). Гірська система Кримських гір утворена трьома паралельними пасмами: Зовнішнім, Внутрішнім і Головним. Вони простягаються на 180 км уздовж узбережжя Чорного моря смугою завширшки 50–60 км, а середні їхні висоти становлять 600–1000 м. Невисокі гори мають пологі північні схили та круті обривисті південні.
Землетруси, які іноді трапляються в Кримських горах, свідчать про те, що тектонічні процеси на їхній території тривають досі.
Мал. 39.3. Кримські гори
1. Якими кольорами на карті позначають низькі, середні та високі гори?
2. Складіть рейтинг із десяти найвищих гір світу та їхніх найвищих вершин.
3. Чим тектонічні платформи відрізняються від поясів складчастості?
4. Поясніть, як відбуваються процеси горотворення та наведіть приклади того, що вони тривають і сьогодні.
Ключова ідея
Гори — це високо підняті над рівнем моря великі ділянки земної поверхні з різким коливанням висот. Вони утворюються в поясах складчастості та формують гірські системи. За висотою розрізняють низькі, середні та високі гори. В Україні розташовані Українські Карпати (г. Говерла, 2061 м) та Кримські гори (г. Роман-Кош, 1545 м).
Тисо-Дунайську низовину наче кільцем оточує так звана Вулканічна Корона — гірські хребти Вулканічних Карпат. Їх середня висота становить 900 м, а найвищою точкою є гора Бужора (1081 м). Хребет складається з масивів згаслих вулканів: Анталовецька Поляна, Маковиця, Борилів тощо. Вони мають правильну конічну форму та слабко розчленовані. На вулкані Анталовецька Поляна чітко виділяється кратер.
5. Порівняйте за висотою Кримські гори й Українські Карпати. Із чим, на вашу думку, пов’язана різниця?

6. За додатковими джерелами інформації підготуйте фотопрезентацію туристичного маршруту Кримськими горами або Карпатами (на вибір). Презентуйте її в класі.
Вулкан Маковиця

y Чи можливе життя на планеті з іншим складом повітря?
y Як склад повітря впливає на життя на Землі?
y Що таке атмосфера та з яких газів вона складається?
y Які процеси та явища відбуваються в атмосфері?
y Що таке температура та якими приладами її вимірюють?
загадка
Якщо взяти куб зі стороною
1 м, заповнити його повітрям, узятим біля земної поверхні, та зважити, то маса повітря
буде 1 кг 293 г.

Один кубічний метр повітря, узятого на висоті 10 км, буде важити лише 400 г, а на 40-кілометровій висоті маса такої самої кількості повітря становитиме 4 г.
Чому так відбувається?
У 5 класі ви дізналися, що Земля оточена повітряною оболонкою — атмосферою. Вона простягається від поверхні Землі на висоту в декілька сотень кілометрів та утримується навколо Землі силою тяжіння.
Атмосфера складається із суміші газів, водяної пари та різних домішок (пил, сажа, попіл, кристали льоду й морської солі, мікроорганізми, пилок рослин тощо). Загальна маса атмосфери сягає близько 5 300 000 000 млн тонн. Склад повітря в атмосфері до висоти 90–100 км майже сталий (мал. 40.1). А от вище переважають більш легкі гази. Кількість водяної пари в атмосфері з віддаленням від поверхні швидко зменшується. Так, на висоті 2 км її вже вдвічі менше, ніж біля поверхні, а вище 70–80 км вона взагалі відсутня. Атмосфера Землі складається з декількох шарів, що відрізняються за товщиною, складом повітря, температурою тощо. 1962 року Всесвітньою метеорологічною організацією прийнято такі назви шарів атмосфери: тропосфера, стратосфера, мезосфера, термосфера, екзосфера. Розгляньмо їх на малюнку 40.2.
Найближчий до Землі шар — тропосфера. Саме в ній відбуваються всі погодні явища, тобто формується погода. Про це ми поговоримо в наступних параграфах.


У стратосфері розташований «захисний екран» нашої планети — озоновий шар. Він складається з озону (О3) та захищає Землю від згубної дії сонячної радіації. Сьогодні, на жаль, через використання людством озоноруйнівних речовин, кожну хвилину руйнуються мільйони молекул озону. А це призводить до збільшення кількості ультрафіолетового випромінювання, яке досягає поверхні Землі.

Атмосфера не лише захищає Землю від космічного випромінювання, а й забезпечує сприятливі температурні умови для всього живого на нашій планеті. Повітря, наче ковдра, зберігає тепло сонячних променів, які нагрівають Землю. А от астронавтам і астронавткам, які перебувають на космічній станції та виходять у відкритий космос, потрібні джерело повітря для дихання та захисний костюм для збереження тепла (скафандр) (мал. 40.3).
Чому температура повітря змінюється з висотою? Повітря
Розділ 2. Досліджуємо Землю та життя на Землі
1. Назвіть складові атмосфери.
2. Чому стратопаузу називають
зоною постійної температури?
3. Доведіть, що атмосферу
недарма називають захисною оболонкою Землі.
4. Доктор Самуель Фергюсон
із відомого роману Жуля
Верна «П’ять тижнів на пові-
тряній кулі» говорив про
свою подорож: «Мені занадто жарко — я піднімаюся вище; мені холодно — я спускаюся; гора на моєму шляху — я її перелітаю; ...вибухне гроза —
я піду вище неї; зустрінеться
потік — промчусь над ним, немов птах». У якій частині атмосфери проходив його
політ? Аргументуйте свою
думку.
5. Найдовший, але найлегший маршрут на Говерлу починається
від с. Лазещина, що розташоване на висоті 711 м. Обчисліть температуру на горі Говерла, якщо в селі в цей час +8 °С.
6. За допомогою вуличного термометра вимірюйте температуру повітря впродовж дня від 8 до 18 години через кожні 2 години. Чи змінюється температура? Від чого, на вашу думку, це залежить?
теплопередачі. Завдяки випромінюванню сонячне тепло потрапляє на поверхню Землі та нагріває
її, а потім від неї через теплопровідність нагрівається й саме повітря.
Нагріте повітря піднімається вгору й поступово остигає. Тому його температура зменшується з висотою: у середньому на 6 °С на 1 км (мал. 40.4 на с. 111).
Якщо ми будемо підніматися від підніжжя Гімалаїв до гірських вершин, то поступово перейдемо від теплих тропічних лісів до холодних гірських пустель.
У стратосфері температура повітря спочатку залишається сталою, а потім поступово підвищується приблизно до 0 °С на висоті 40 км. Цю область називають областю постійної температури, або стратопаузою. Вона простягається вгору до 55 км. Вище, у мезосфері, температура знову знижується, а в термосфері, яку ще називають іоносферою, швидко зростає до понад 1000 °С. Із переходом у міжпланетний простір температура знову стрімко знижується. Тож там панує космічний холод.
Ключова ідея Атмосфера — повітряна оболонка нашої планети. Вона складається з декількох шарів, які різняться між собою температурою, складом повітря тощо. Це — тропосфера, стратосфера, мезосфера, термосфера й екзосфера. У тропосфері відбувається формування погодних явищ. Температура в ній із висотою зменшується на 6 °С на кожен 1 км підйому.
Засновник Харківського університету. 1809 року розпочав перші регулярні метеоспостереження на території України. У с. Кручик Харківської області заснував метеостанцію, де щодня о 8 та 11 годині спостерігали та реєстрували показники повітря: тиск, температуру, напрям і швидкість вітру тощо.
Василь Назарович Каразін (1773–1842)

Якщо гумовий м’яч занурити у воду кімнатної
температури, можна відчути, що він дещо стискається. Це відбувається через те, що на воду, як і на будь-яку іншу рідину, діє сила тяжіння та створює тиск.

Чи має вагу атмосфера Землі?
y Який склад повітря?
Уявіть, що ми живемо на дні величезного океану,
сотень кілометрів. І, як у досліді з м’ячем, повітряний океан тисне на дно, тобто на земну поверхню, та на всі тіла на ній. Цей тиск називають атмосферним тиском. Він виникає через те, що атмосфера має вагу.
Торрічеллі отримав від учителя завдання: з’ясувати, чому не можна підняти насосом воду на висоту понад 10 м. Під час досліджень Торрічеллі вирішив замінити воду ртуттю. Він наповнив ртуттю трубку завдовжки 1 м та запаяну з одного боку. Потім він перекинув трубку отвором униз у посудину, також заповнену ртуттю. Частина рідини з трубки вилилася в посудину. А та, що залишилася, утримувалася на висоті 760 мм силою атмосферного тиску (мал. 41.1). Тобто атмосфера створює такий самий тиск, що й стовпчик ртуті заввишки 760 мм. Так Торічеллі винайшов прилад для вимірювання атмосферного тиску — барометр, який вимірював тиск у міліметрах ртутного стовпчика (мм рт. ст.).
Згодом були сконструйовані інші, більш безпечні барометри-анероїди, які не використовували ртуть і вимірювали атмосферний тиск в інший спосіб (мал. 41.2 на с. 114). Про них ви дізнаєтесь у 7 класі.
y Що утримує атмосферу біля поверхні Землі?
y Повітря не можна побачитиабо помацати. Як довести, що в нього є маса?
загадка
Підкорення гірських вершин пов’язане зі значними труднощами: низька температура, ураганні вітри, коли швидкість вітру сягає 160 км/год, різка зміна погоди, і головне — неможливість повноцінно дихати на висоті. Чому навіть треновані альпіністи під час сходження на високі гірські вершини використовують дихальні апарати?
Мал. 41.1. Рідинний барометр Торрічеллі
атмосферний тиск
У XVII столітті талановитий учень Ґалілео
Ґалілея Еванджеліста
Видавництво
«
Ранок»
Мал. 41.2. Барометр-анероїд
1. Дайте визначення тиску та атмосферного тиску.

2. Якими приладами вимірюють атмосферний тиск?
3. Чому в горах важко дихати?

4. Цікавий дослід виконав Отто фон Ґеріке — бургомістр німецького міста Магдебург.
Він узяв дві металеві півкулі, склав їх разом, відкачав ізсередини повітря та спробував їх роз’єднати. Для цього йому знадобилося вісім пар коней, що тягнули півкулі в різні боки. Що довів цей дослід?
5. У Києві є житловий будинок
заввишки 168 метрів. Який атмосферний тиск на даху цього хмарочоса, якщо біля поверхні барометр показує 760 мм рт. ст.?
6. Ртутні барометри, як і ртутні термометри, становлять певну небезпеку. За допомогою додаткових джерел інформації з’ясуйте причину небезпеки. Складіть пам’ятку, як поводитися, якщо ви розбили ртутний термометр.
Мал. 41.3. У горах тиск повітря менший, ніж у долинах
Як залежить атмосферний тиск від висоти над поверхнею Землі
Ми вже з’ясували причину виникнення атмосферного тиску. Це — вага повітря. Тому з підняттям угору атмосферний тиск знижується. Якщо ми перебуваємо на гірській вершині, то над нами менший шар повітря, ніж коли ми біля підніжжя (мал. 41.3). За умови меншого тиску повітря стає більш розрідженим, і дихати в ньому стає складніше.
У разі підйому вгору на висоту до декілька сотень метрів атмосферний тиск зменшується на 1 мм рт. ст. на кожні 10,5 м.
Ключова ідея
Тиск — це фізична величина, яка чисельно дорівнює силі, що діє на одиницю площі поверхні тіла. Оскільки атмосфера має вагу, вона тисне на поверхню Землі та на всі тіла, що на ній перебувають. Цей тиск називають атмосферним. Його вимірюють у мм рт. ст. за допомогою барометра. Нормальним вважають тиск 760 мм рт. ст. Під час підйому вгору на кожні 10,5 м атмосферний тиск зменшується на 1 мм рт. ст.
Ми не відчуваємо атмосферний тиск тому, що кров і повітря всередині нас також перебувають під тиском. Тиск усередині нашого тіла приблизно такий самий, як атмосферний.
Деякі глибоководні риби можуть «вибухнути», якщо їх витягнути з води. Вони пристосувалися до життя в глибині, і тиск усередині них вищий, ніж атмосферний тиск на поверхні.
Дізнайтеся більше

У 5 класі ми говорили про те, що з підвищенням температури збільшується швидкість руху молекул речовин. Це призводить до того, що повітря розширюється, а його густина зменшується. Повітря з меншою густиною починає підійматися вгору (як дерев’яне або пінопластове тіло у воді). Там, де тепле повітря підіймається вгору, атмосферний тиск знижується. Якщо повітря холодне, то відбувається зворотний процес: густина повітря збільшуються, холодне повітря опускається вниз. Рух холодного повітря вниз призводить до підвищення атмосферного тиску.
Такі рухи повітря, пов’язані зі зміною його температури, відбуваються в природі в межах окремого регіону, континенту та Землі в цілому.
Якщо атмосферу можна порівняти з повітряним океаном, то вітер — це невидима річка, де замість води — повітря. У початковій школі ви дізналися, що вітер — це горизонтальний рух повітря. Але звідки й куди воно рухається?
Рух потоку повітря здійснюється внаслідок різниці атмосферного тиску в різних ділянках атмосфери. Отже, вітер — це рух повітря iз зони високого атмосферного тиску в зону низького тиску в горизонтальному або близькому до нього напрямку (мал. 42.1).


Як вітер може бути пов’язаний з атмосферним тиском?
y Чи змінюються температура повітря й атмосферний тиск із висотою?
y Як повітря може тиснути на поверхню Землі?
y Що таке вітер?
y Як людство використовує силу вітру?
загадка
В одному зі своїх творів Леся Українка написала такі рядки: Рудий Хамсін в пустині розгулявся, Жагою палений, мчить у повітрі, Черкаючи пісок сухими крильми, І дише густим полум’ям пекучим. Яке природне явище описала видатна українська поетеса й письменниця?
Розділ 2. Досліджуємо Землю та життя на Землі

Для визначення напряму вітру люди здавна використовують флюгер (мал. 42.2 на с. 115).
Оскільки вітри характеризують за швидкістю, силою, рідше тривалістю, необхідно в певний спосіб їх виміряти. Для цього використовують анемометр — прилад для вимірювання швидкості й напряму вітру (мал. 42.3 на с. 115).
Силу вітру вимірюють у балах, а швидкість — у метрах за секунду або кілометрах за годину. 1 бал приблизно дорівнює 2 м/с.
Сила вітру залежить від різниці атмосферного тиску між областями: чим різниця більша, тим більша сила вітру.
Від 1874 року для візуальної оцінки сили вітру використовують 12-бальну шкалу Бофорта. Найчастіше її використовують у морській і повітряній навігації.
Шкала Бофорта


Море Співдружності, що розташоване біля берега Георга V в Антарктиді, уважають найбільш вітряним місцем на планеті. Швидкість вітру тут сягає 320 км/год.


Дослідження
Для визначення сили вітру без спеціальних приладів скористайтеся шкалою Бофорта. Проаналізуйте дію вітру, яка відбувається у природі в момент дослідження, та знайдіть найбільш схожий опис цієї дії в таблиці. З’ясуйте, яка сила вітру йому відповідає.
На планеті утворюються постійні та місцеві вітри. Постійні потоки круглий рік дмуть в одному напрямку. До прикладу, постiйнi вiтри, що дмуть у помiрних широтах, отримали назву Захiднi вiтри. До постійних вітрів також відносять пассати. Вони переважають у тропічних широтах і дмуть від тропіків до екватора.

У природі є місця, де формуються так звані місцеві вітри. До них належать, зокрема, бризи. Бриз — це вітер, що утворюється на узбережжі морів і двічі на добу змінює свій напрям. Він є результатом того, що берег і вода в морі нагріваються по-різному. Вода нагрівається дуже повільно, тому в один і той самий час доби повітря над берегом виявляється теплішим, ніж над морем. Як наслідок, над морем формується область більш високого тиску. Повітря починає рухатися в бік суходолу, де тиск нижчий. Так утворюється денний бриз, який приносить на узбережжя прохолоду з моря. Уночі все відбувається навпаки, оскільки остигає вода також повільніше, ніж суходіл. Тому повітря над морем уночі тепліше, ніж над берегом. Так утворюється нічний бриз, що дме із суходолу в море (мал. 42.4).
Напрям вітру в горах також змінюється відповідно до часу доби: удень вітер дме з долин у бік гір, а вночі — з гір у долини. Такі вітри називають гірськодолинними (мал. 42.5).
Ключова ідея
В атмосфері відбувається постійний рух повітря. Рух потоку
повітря від області високого тиску до області низького тиску називають вітром.Силу вітру визначають за шкалою Бофорта.
1. Завдяки чому відбувається рух повітря в атмосфері?
2. Чи завжди вітер однаковий? Від чого це залежить?
3. Поясніть, як використовують шкалу Бофорта для визначення сили вітру.
4. Чи можна механізм дихання людини порівняти з механізмом утворення вітру?
5. Існує велика кількість прислів’їв і приказок про вітер. Проілюструйте одну з них у будь-який спосіб (малюнок, графіка, комікс, аніме, комп’ютерна графіка тощо). Для натхнення перегляньте в інтернеті картини японського художника Кацусіко Хокусая.
Дізнайтеся більше
Іноді пасажири літаків можуть почути попередження: «Обережно, літак потрапив у зону турбулентності. Просимо пристебнути ремені безпеки». Турбулентність — це хаотичний рух
6. Як можна зорієнтуватися в пустелі Наміб, де переважають південні вітри, та знайти шлях у бік Атлантичного океану, якщо у вас немає компаса?
невеликих мас повітря, які мають різну швидкість, у загальному потоці вітру. Через невпорядковані вихрові рухи виникає так звана «бовтанка».
Видавництво
«Ранок»

Чи існувало б життя на Землі, якби в повітрі не було води?
y Які є агрегатні стани речовини?
y З яких атомів складається молекула води?
y У яких оболонках Землі міститься вода?
загадка
Ця речовина аномальна, адже
вона — єдина речовина на
планеті, що в природних
умовах може існувати в трьох
агрегатних станах одночасно.
Що це за речовина?
Вода — це найпоширеніша речовина на нашій планеті. Її молекула складається з одного атома
кисню і двох атомів водню, а хімічна формула молекули води — H2O.
Деякі фізичні властивості води вам уже відомі. Пригадаймо їх за схемою.
Вода, як і інші речовини, здатна поглинати теплоту. Вона може її як утримувати, так і віддавати в навколишній простір. Властивість речовини поглинати певну кількість теплоти називають теплоємністю.
Вода має високу теплоємність. Для підвищення її температури на 1 °С потрібно набагато більше теплоти, ніж для будь-якої іншої рідини або твердої речовини. Саме через це водойми нагріваються й остигають повільніше, ніж суходіл.
Хімічні властивості води
Ви вже знаєте, що вода розчиняє велику кількість речовин.
В природі вона сполучається з деякими газоподібними речовинами, що викидаються в атмосферу як із природних джерел (приміром, вулкани), так і від спалювання викопного палива. Речовини переносяться вітром і повітряними масами. Згодом ці речовини вступають у хімічні реак-
Видавництво
ції з водою та іншими хімічними речовинами з утворенням кислот. Коли така кислота змішується з водою в атмосфері, можуть утворюються кислотні дощі.
Докладно про хімічні властивості води ми говоритимемо у старших класах.


В атмосфері Землі завжди міститься вода у вигляді водяної пари. Вона потрапляє туди внаслідок випаровування з поверхні Землі, водойм, листя рослин і шкіри тварин (мал. 43.1).
Отже, в атмосферному повітрі завжди є вода, хоча порівняно з іншими складниками атмосфери її небагато. Але саме завдяки цій воді утворюються хмари й відбуваються різні опади. Про це ми поговоримо в наступних параграфах.
Щодня у прогнозі погоди можна почути про вологість повітря, тобто про вміст водяної пари в атмосфері. Для чого чи для кого ця інформація?
Це важливо насамперед для тих, хто займається сільським господарством, а також для всіх, хто турбується про своє здоров’я. Адже перебування у вологому і теплому повітрі може порушити тепловий баланс організму, що може призвести до перегрівання — теплового удару.
Вологість — це величина, що визначає насиченість повітряних мас вологою. Отже, вологість повітря — це вміст водяної пари в повітрі. Одиницею вологості є г/м3. Можливий уміст водяної пари в повітрі залежить від температури (мал. 43.2).
Існує два критерії кількісної оцінки вологості: абсолютна вологість — маса водяної пари в 1 м3
Мал. 43.1. За рік у повітря випаровується понад 1014 тонн води
Мал. 43.2.
максимально можливої маси водяної пари в повітрі від температури (для повітря об’ємом 1 м3)
Розділ 2. Досліджуємо Землю та життя на Землі
повітря, та відносна вологість — відношення абсолютної вологості до максимально можливої маси водяної пари в 1 м3 повітря за певної температури.
Згідно санітарно-гігієнічних норм допустимі межі відносної вологості в житлових приміщеннях становлять від 25 до 70 %. Але найбільш комфортними умови будуть за показників від 30 до 50 %.
Мал. 43.3. Гігрометр
За 100% відносної вологості в повітрі може конденсуватися водяна пара з утворенням туману або випаданням краплин води. Температуру, за якої це відбувається, називають точкою роси. Для вимірювання відносної вологості використовують гігрометри (мал. 43.3).
1. Як називають процес переходу води з рідкого стану в газоподібний?
2. Що таке абсолютна вологість?
Що таке відносна вологість? Як визначають відносну вологість?
Яким приладом її вимірюють?
3. Є загадка про росу: увечері

на землю лягає, уночі на землі спочиває, а вранці в небо злітає. Про які фізичні процеси
йдеться в цій загадці?
4. Як теплоємність води впливає на утворення бризів?
5. Чи корисно, на вашу думку, використовувати в житлових приміщеннях зволожувач повітря?
Дослідження. Вимірювання вологості повітря за допомогою склянки з водою Налийте у склянку воду до країв і поставте в холодильник на 30 хвилин. Температура води має бути близько +5 °С. Помістіть склянку з водою в кімнаті подалі від батареї чи кондиціонера. На стінках склянки утвориться конденсат у вигляді краплин води. Якщо краплини зникнуть за 10–15 хвилин —
у кімнаті сухе повітря, якщо на це потрібно більше часу — у кімнаті занадто сиро.
Ключова ідея В атмосфері завжди є водяна пара. Вона потрапляє туди внаслідок випаровування з поверхні Землі. Вологість показує вміст водяної пари в повітрі й залежить від його температури. Для кількісної оцінки вологості використовують показники абсолютної та відносної вологості.
Дізнайтеся більше Завдяки українському інноваційному проєкту в Al Mamzar Smart Park (м. Дубай, ОАЕ) було встановлено споруду Smart Oasis, що видобуває питну воду з повітря. Вона працює на сонячних батареях і здатна утворювати до 200 л рідини щодня. Це автономні атмосферні генератори. Автор проєкту — Олексій Приходько та конструкторське бюро IDA.

Видавництво
Дослід

Візьміть пластикову пляшку від питної води. Зробіть у бічній стінці три отвори на різній висоті. Налийте в пляшку воду. Завдяки плинності вода почне виливатися з отворів.
Якщо спостерігати уважно, то можна побачити, що з нижнього отвору вода витікає з більшою швидкістю, ніж з інших.
Це відбувається тому, що біля нижнього отвору тиск води вищий, ніж біля верхнього.
Вода має вагу й тисне на дно та стінки посудини. У міру заглиблення цей тиск, що отримав назву гідростатичний тиск, зростає. Якщо замінити воду іншою рідиною, ми отримаємо той самий результат. Отже, гідростатичний тиск — це тиск рідини на дно та стінки посудини, зумовлений тим, що рідина має вагу.
Ураховувати дію гідростатичного тиску дуже важливо під час підводних досліджень. Під час занурення на кожні 10 м тиск, що діє на людину або підводні човни, зростає на значення тиску, який чинить атмосфера Землі на всі тіла на її поверхні. Уявіть, який тиск «відчуває» підводний апарат на глибині 100 м, 1 км, 10 км!
Коли будують греблі на річках, тим самим піднімають рівень води у водосховищах. Це збільшує гідростатичний тиск і силу, з якою вода тисне на греблю. Завдяки дії цієї сили на гідроелектростанціях отримують електроенергію (мал. 44.1).
Дослід Зануримо м’яч у посудину з водою (мал. 44.3 на с. 122).
Із власного досвіду ви знаєте, що для цього потрібно прикласти певні зусилля. Чому?
На будь-яке тіло, занурене в рідину, діє виштовхувальна сила. Саме вона створює опір

y Для чого на річках будують греблі?
y Чому цеглина у воді тоне, а дерев’яна дошка плаває?
y Що таке тиск? Що він характеризує?
y Що таке густина?
Нижній струмінь води витікає з більшою швидкістю тому, що внизу вода перебуває під більшим тиском
Мал. 44.1. Гребля гідроелектростанції
Розділ 2. Досліджуємо Землю та життя на Землі
вашим зусиллям занурити м’яч. Цю силу відкрив давньогрецький природознавець і математик Архімед. Тому виштовхувальну силу називають також архімедовою силою, або силою Архімеда. Причиною виникнення сили Архімеда є те, що рідина діє з більшою силою на нижню поверхню зануреного тіла, ніж на верхню, унаслідок наявності гідростатичного тиску. Різниця цих сил і є силою Архімеда.
Мал. 44.2. Дерев’яне тіло плаває у воді, а металеве тоне
загадка
Як пояснити, що у водоймах плавають судна, корпус яких виготовлений зі сталі? Адже сталевий цвях тоне, а не плаває на поверхні.
1. Що таке гідростатичний тиск?
2. Поясніть причину виникнення гідростатичного тиску.
3. Чому на тіла в рідині діє віштовхувальна сила?
4. Сформулюйте умову плавання тіл.

5. Чому під час будування морських суден обов’язково враховують їхню середню густину?
6. Наповніть водою велику посудину та опустіть на поверхню води невелику металеву миску так, щоб вона плавала. Почніть потроху наливати в миску воду. Спостерігайте, як
змінюється глибина занурення миски в міру додавання до неї води. Що трапиться з мискою, якщо продовжувати додавати воду? Зробіть висновки.

Прояв дії виштовхувальної сили можна спостерігати, підіймаючи під водою важкий камінь. У воді це зробити значно легше, ніж на березі.
Плавання тіл
Якщо кинути в посудину з водою дерев’яний і металевий бруски, то ми побачимо, що дерев’яний брусок плаватиме на поверхні, а металевий потоне (мал. 44.2).
Чому деревина плаває, а метал тоне? Густина
деревини менша за густину води, а густина металу — більша. Отже, ми визначили умову плавання тіл у рідинах: тіло плаває на поверхні рідини, якщо його густина менша за густину рідини.
Під час визначення густини будь-якого неоднорідного тіла, наприклад корабля, необхідно обчислити її середнє значення. Оскільки всередині судна є трюми й інші приміщення, що містять багато повітря, середня густина судна буде меншою за густину води. Якщо судно отримує пробоїну, то внутрішні приміщення наповнюються водою. Середня густина судна стане більшою за густину води, і воно потоне.
Ключова ідея
Через те, що рідини притягуються силою земного тяжіння і мають вагу, вони створюють гідростатичний тиск. Сила, з якою рідина тисне на нижню поверхню тіла, більша за силу, що діє на його верхню поверхню. Це зумовлює появу виштовхувальної сили, або сили Архімеда. Якщо густина тіла менша за густину рідини, то тіло плаває на поверхні. Якщо густина тіла більша за густину рідини — тіло тоне.

Прикладом одночасного існування рідкого і твердого стану води в атмосфері є хмари (мал. 45.1). Вони складаються з дрібних краплин води, кристаликів льоду або їхньої суміші. Необхідними умовами утворення хмар є насичення водяної пари до стану конденсації (перетворення пари на воду) або десублімації (перетворення пари на крижані кристали, минаючи рідку фазу) і зниження температури повітря до певного рівня.
Під час підняття вгору повітря починає охолоджуватись, а водяна пара поступово перетворюється на краплини води. Коли краплин утвориться близько 200–500 в 1 см3 — вони стають видимими людським оком: ми бачимо, як у небі з’являється хмара.
Залежно від того, чи є хмари в небі, говорять про хмарність у певний момент часу. Хмарність — ступінь укриття неба хмарами в балах від 0 (ясно) до 10 (похмуро).
Визначити хмарність на відкритій місцевості можна візуально за 10-бальною шкалою. Хмарність належить до
найважливіших елементів погоди.
Види хмар
В атмосфері утворюються різні види хмар. Розгляньмо їх на малюнку 45.1 на с. 124.
1896 року Міжнародна метеорологічна організація видала перший всесвітній довідник
із класифікації хмар та інших атмосферних явищ — Міжнародний атлас хмар (мал. 45.2, с. 124). За ним основою для поділу хмар на три яруси є висота. Тому хмари поділяють на високі, середні та низькі.
Атмосферні опади
Коли води або кристаликів льоду у хмарі стає дуже багато, вони вже не можуть втриматися на висоті, тому починаються опади. Зокрема шару-
y Як можна пояснити прислів’я «Не кожна хмара приносить дощ»?
y Чому на Землі існують
пустелі?
y Із чого складаються хмари?
y Що таке опади?
y Чому сніг на території
України влітку є аномалією?
загадка
Чому в горах, наприклад
у Карпатах, іноді «зникають»
хмари?
Видавництво «Ранок»
Мал. 45.2. Сторінки Міжнародного атласу хмар
вато-купчасті та шарувато-дощові хмари несуть опади у вигляді снігу та дощу. Атмосферні опади — явища, коли вода в рідкому чи твердому стані випадає з хмар чи з повітря на земну поверхню і тіла на ній. Із хмар випадають дощ, мряка, сніг, мокрий сніг, крупа, град, льодяний дощ. Із повітря виділяються роса, паморозь, іній. Для вимірювання кількості опадів використовують опадомір, або плювіометр. Її вимірюють у міліметрах шару води. Для вимірювання кількості снігу використовують снігомірну рейку. Різні ділянки нашої планети отримують неоднакову кількість опадів, що залежить від багатьох факторів. Це — температура повітря, висота місцевості над рівнем моря, морські течії, атмосферна циркуляція. Найбільша кількість опадів випадає в екваторіальних (понад 2000 мм) і помірних (понад 800 мм) широтах. Мало опадів (200 мм) випадає у тропічних і полярних широтах. Разом з тим над океанами опадів випадає значно більше, ніж над суходолом.
1. За якими ознаками класифікують хмари?
2. Які опади випадають на земну поверхню з хмар у рідкому та твердому вигляді?
3. Як утворюються роса та іній?
Мал. 45.1. Види хмар Ключова ідея
4. Чому опади на земній кулі утворюються нерівномірно?
5. Чи можна за хмарами передбачити погоду? Чому?


6. Створіть свій власний «Атлас опадів». Він може бути як у вигляді комп’ютерної презентації, так і у вигляді малюнків.

У горах більшу частину опадів «приймають» схили, звернені до переважаючих вітрів. В Україні навітряні схили Карпат отримують 1500 мм опадів на рік, а підвітряні — 750 мм на рік.
Ступінь вкриття неба хмарами називають хмарністю. Хмари перебувають на різній висоті, мають різний вигляд і можуть мати різні наслідки для погоди. Необхідною умовою для їх утворення є насичення водяної пари до стану конденсації або сублімації. Кількість опадів на нашій планеті нерівномірна та залежить від багатьох чинників.
майбутньогопідручникаВидавництво

Формування хмар і опадів залежить від температури повітря, тому їх можна вважати тепловими явищами, що формуються в атмосфері.
Ще одне цікаве атмосферне явище отримало гарну українську назву серпанок. Це легкий прозорий туман, не такий густий, як звичайний. Помутніння повітря в серпанку теж спричинене
наявністю в ньому дрібних краплин чи кристалів води. Вони розсіюють сонячні промені, тому всі предмети здаються білувато-сірими та нечіткими (мал. 46.1).

Яку небезпеку можуть становити природні явища в атмосфері для людства?
y Що таке випаровування води та конденсація водяної пари? y Як відбувається відбивання, заломлення та дисперсія світла?
y Як взаємодіють між собою електричні заряди?
Нагріта поверхня Землі не лише нагріває повітря, але ще виділяє невидиме теплове випромінення в космос. Особливістю земної
є те, що вона затримує ці теплові промені. Але якщо атмосфера починає занадто сильно затримувати тепло, її температура починає підвищуватися і може перейти межу та стати небезпечною. Гази, що сприяють затримці тепла атмосферою, — це вуглекислий газ, метан і водяна пара. Ці гази отримали назву парникові, а сам ефект затримки тепла атмосферою називають парниковим ефектом (мал. 46.2 на с. 126).
Сьогодні наукова спільнота спостерігає підвищений рівень парникових газів в атмосфері, що призводить до надмірного нагрівання Землі. Тому країни світу об’єдналися для спільної роботи зі зменшення кількості парникових газів в атмосфері. Одним зі шляхів має бути використання відновлювальних джерел енергії.
Оптичні явища
У земній атмосфері також поширені різноманітні оптичні явища.
У 5 класі ми вже згадували про веселку — видовищне оптичне явище, яке можна спостерігати, коли сонячні промені потрапляють у краплини води, що залишилися в повітрі після дощу.
загадка
З якою метою під час вирощування городини її часто накривають поліетиленовою плівкою або навіть будують спеціальні конструкції?
Мал. 46.1. Серпанок
Проєкт
Мал. 46.2. Затримуючи тепло, атмосфера не дає Землі остигнути

1. Наведіть приклади атмосферних явищ.
Розділ 2. Досліджуємо Землю та життя на Землі Атмосфера захищає поверхню Землі від падіння космічних тіл. Коли космічне тіло на великій швидкості потрапляє у верхні шари атмосфери Землі, яка захищає її поверхню від падіння космічних тіл, воно внаслідок тертя об повітря нагрівається, починає горіти. Невеликі камінці повністю згорають на висоті близько 100 км. У цей час спостерігається видовищне оптичне явище — метеори. Коли ж Земля під час обертання навколо Сонця потрапляє у пиловий хвіст комети, можна спостерігати одночасно багато метеорів — метеорні потоки. Також Земля зазнає впливу потоків заряджених частинок із космосу. Магнітне поле Землі спрямовує їх до полюсів, де вони потрапляють у верхні шари атмосфери та змушують молекули газів, що містяться у складі повітря, випромінювати світло. Тоді в полярних областях спостерігають видовищне оптичне явище — полярне сяйво.
2. У чому, на ваш погляд, користь і небезпека парникового ефекту?
3. У якому порядку розташовані кольорові смужки веселки?
Знайдіть в інтернеті приклади віршиків для скорішого запам’ятовування кольорів веселки або складіть власний.
4. Порівняйте блискавку та блискавицю. У чому вони схожі та чим відрізняються?
5. Які явища з описаних у параграфі ви можете спостерігати або вже спостерігали у вашій місцевості? Які з них небезпечні та несуть загрозу здоров’ю?
6. Деякі явища, описані в параграфі, формуються не лише в атмосфері. Із деякими з них ми стикаємося в побуті. Які це явища? Чому вони виникають?
В атмосфері можна спостерігати й електричні явища. Найчастіші з них — це блискавки та блискавиці.
Коли гроза далеко, то через велику відстань гуркоту грому нечутно, але за сприятливих умов на горизонті можна побачити спалахи. Це відбиття далеких блискавок у дощових хмарах. Ці спалахи називають блискавицями.
Ключова ідея
У земній атмосфері утворюється безліч теплових, оптичних та електричних явищ: парниковий ефект, веселка, метеори, полярні сяйва, блискавки, блискавиці тощо.
пояснив роботу блискавковідводів американський науковець Бенджамін Франклін 1752 року. Сучасні громовідводи встановлюють над високими спорудами. Це металеве вістря, що дротом з’єднане із землею.
«Ранок»
Мабуть, ви стикалися з тим, що, наприклад, температура повітря, яку ви вимірювали вдома, відрізняється від температури, яка була за вікном у ваших друзів. Річ у тім, що погода — це стан нижнього шару атмосфери в певній місцевості в певний момент (або проміжок) часу. Тобто погода буде різною в різних місцях і в різний час. Недарма
про неї говорять, що вона мінлива і залежить від зміни кута падіння сонячних променів протягом доби, місяця, року; неоднорідністі рельєфу (підстильної поверхні); утворення та руху повітряних
мас із низьким атмосферним тиском (циклонів) та високим атмосферним тиском (антициклонів).
Зміни погоди можуть відбуватися як періодично, так і не періодично. Періодичні пов’язані з рухом Землі навколо Сонця та своєї осі (сезонні та добові зміни температури, вологості, напряму вітру).
Неперіодичні зміни погоди залежать від руху повітряних мас і формування над певними територіями циклонів та антициклонів.
Повітряні маси — це значні об’єми повітря, що мають порівняно однорідні властивості в горизонтальних напрямах і простягаються на відстань від сотень до тисяч кілометрів. Вони виникають в атмосфері через нерівноміриний розподіл теплоти й вологи. Повітряні маси поділяють за температурою на теплi та холодні, а за вологістю — на сухі (континентальні) та вологi (морські).
Основними характеристиками погоди є температура повітря, атмосферний тиск, вітер, вологість, хмари і хмарність, опади тощо.
Сьогодні метеорологічна спільнота веде постійні спостереження за станом погоди. Для цього створена мережа метеостанцій по всьому світу. За допомогою різноманітних приладівта за
Чому погода може бути різною навіть у містах, що розташовані на невеликій відстані?
y Що таке погода?
y Які явища та процеси відбуваються в атмосфері?

y Які з них можуть нести небезпеку?
y Якими приладами вимірюють температуру повітря, атмосферний тиск, силу вітру, вологість, кількість опадів?
загадка
Метеорологія — це наука про земну атмосферу, явища та процеси, які в ній відбуваються. Але все частіше її називають фізикою атмосфери. Як ви вважаєте, чому?
Мал. 47.1. Фрагмент синоптичної карти
Розділ 2. Досліджуємо Землю та життя на Землі

Мал. 48.2. Позначення погодних явищ
допомогою даних із метеосупутників, складають синоптичні карти та формують прогноз погоди. Синоптичні карти — це спеціальні карти, на яких цифрами та символами наносять результати метеорологічних спостережень у певний момент часу (мал. 47.1). Їх складають для прогнозування погоди. Прогноз погоди — це інформація про стан погоди в майбутньому.
Сьогодні будь-хто, маючи доступ до мережі інтернет, може подивитися цифрову карту погоди для свого міста в режимі реального часу.
1. Складіть перелік приладів, які встановлюють на метеостанціях.
2. Як ви розумієте вислів «Трапляється такий год, що на день по сім погод»?
3. Чи можна, на вашу думку, вірити народним прикметам про погоду? Наведіть прикмети, що передбачають ясну, похмуру й дощову погоду.
4. Зберіть у мережі інтернет інформацію про сайти, де можна відслідковувати погоду в реальному часі (за потреби разом із дорослими)
5. Які несприятливі погодні явища ви спостерігали у своїй місцевості? Розробіть пам’ятку безпечної поведінки під час несприятливих погодних умов у вигляді буклета або плаката. Презентуйте її в класі.
Дослідження Проведіть спостереження за погодою «в польових умовах», тобто на вулиці. Визначте основні характеристики погоди. Скористайтеся наявними у школі приладами та виміряйте температуру повітря, атмосферний тиск тощо. Запишіть погодні явища, використовуючи запропоновані умовні позначки (мал. 47.2). Порівняйте свої результати з прогнозом погоди на цей день. Для цього скористайтеся радіо, телебаченням, інтернетом, газетами тощо.
Іноді несподівано виникають погодні явища, що можуть негативно впливати, наприклад, на роботу транспорту, як-от туман чи ожеледь. Грози та град можуть зашкодити сільському господарству, ураган — порушити електромережі, а повені — пошкодити житлові будинки.
На території України також трапляються несприятливі погодно-кліматичні явища, зокрема заморозки, хуртовини, ожеледь, зливи, грози, тумани, посухи, буревії, смерчі. Останнім часом
спостерігають нехарактерні для нашої території торнадо, зокрема в Херсонській області (мал. 47.5).
Ключова ідея
Погода — це стан нижнього шару тропосфери в різних міс-
цях і в різний час. Вона змінюється і залежить від багатьох
чинників. Спостереження за погодою відбуваються на спе -
ціальних метеостанціях.
Видавництво
«Ранок»
Клімат
Пригадайте, чи було тепло влітку минулого року? А позаминулого? І чи була холодною наша зима? Ми говоримо про клімат, тобто про показники погоди впродовж тривалого періоду, які повторюються. Отже, клімат — це багаторічний режим погоди, характерний для певної місцевості.
Основні кліматотвірні чинники — це енергія Сонця, що потрапляє на поверхню Землі, підстильна поверхня та циркуляція атмосфери.
Залежно від кількості отримуваного Землею тепла, що зменшується від екватора до полюсів, виділяють жаркий, два помірних і два холодних теплових пояси Землі.
Повітря в атмосфері постійно
в горизонтальному та вертикальному напрямах. Цей рух отримав назву циркуляція атмосфери.
І саме через неї відбувається переміщення повітряних мас, від яких залежать погода та клімат.
Різні поверхні нагріваються й охолоджуються по-різному, тому клімат залежить від характеру підстильної поверхні, зокрема наближеності до океанів і морів.
І хоча клімат на нашій планеті дуже різний, на земній поверхні виділяють широтні смуги, у межах яких клімат є певною мірою однорідним. Це кліматичні пояси, які розміщуються зонально й повторюються від екватора до полюсів. Розрізняють основні та перехідні кліматичні пояси (мал. 48.1). Перехідні пояси мають у своїй назві префікс суб-. Вони відрізняються від основних тим, що повітряні маси змінюються в них за сезонами, надходячи із сусідніх основних поясів. Тоді як в основних кліматичних поясах один тип повітряних мас переважає впродовж року. Усередині кліматичних поясів виділяють кліматичні області — території з певним типом клімату.

y Чим погода відрізняється від клімату?
y Чи може погода повторюватися щороку?
y Чому на нашій планеті існують пустелі й місця, де щодня йде дощ?
y Які чинники впливають на формування погоди?
y На які теплові пояси розділена поверхня Землі?
y Що таке повітряні маси?
2. Досліджуємо Землю та життя на Землі
Тип клімату — це стала сукупність кліматичних показників, характерних для певного періоду часу та певної території.

1. Назвіть кліматотвірні чинники.
2. Чому екваторіальний кліматичний пояс один, а інших поясів по два?
3. Назвіть кількість типів клімату в кожному кліматичному поясі та поясніть причину їх виникнення.
4. За допомогою карти-схеми (мал. 49.1) з’ясуйте, у якому кліматичному поясі розташована територія України.
5. Виступіть у ролі дослідників і дослідниць та з’ясуйте, як виявляються кліматичні зміни у вашій місцевості. Для цього за можливості проведіть опитування людей похилого віку, щоб дізнатися, яким був клімат у вашому місті чи селі 30, 40 або 50 років тому. Зробіть висновки та поділіться результатами.
6. Чи згодні ви, що клімат Землі змінюється через людську діяльність? Поясніть свою думку.
Можливо, ви іноді помічали, що в населеному пункті взимку дещо тепліше, ніж на його околицях чи в полі. А влітку біля річки чи в лісі не так спекотно, як серед міста. Так виявляється місцевий клімат. Він визначається особливостями земної поверхні конкретно в певній місцевості.
У межах місцевого клімату розрізняють мікроклімат. Наприклад, у населеному пункті клімат на площі відрізнятиметься від клімату в парку. Навіть у приватній оселі може бути мікроклімат саду чи городу. А в місцевому кліматі лісу є мікроклімат галявини чи узлісся. На їх формування впливають характер ґрунту, рослинний покрив тощо. Сьогодні часто можна почути по телебаченню чи в інтернеті, що температура на Землі підвищується, і клімат змінюється. На жаль, людство також причетне до цих змін. Як це відбувається і як цьому можна зарадити, ви дізнаєтеся в наступних параграфах.
Ключова ідея
Багаторічний режим погоди, характерний для певної місцевості, називають кліматом. На його формування впливають енергія Сонця, підстильна поверхня та циркуляція атмосфери. На Землі виділяють кліматичні пояси, у межах яких розрізняють різні типи клімату.
Дізнайтеся більше
Світлана Краковська українська кліматологиня. 1997 року вона була однією з чотирьох українських жінок, які вперше побували на станції «Академік Вернадський» в Антарктиді. Від 2013 року є представницею від України на засіданнях Міжурядової групи експертів зі змін клімату.
Якщо подивитися на нашу планету з близького космосу, вона здається блакитною.
Такого кольору їй надає не лише атмосфера. Дві третини поверхні Землі займають океани. Але вода є не лише на поверхні. Певна її частина перебуває і в атмосфері, і у верхньому шарі літосфери. Саме тому вода — найпоширеніша речовина, з якої складається гідросфера — водна оболонка Землі. Вивченням гідросфери займається наука гідрологія.
У складі гідросфери переважає солона вода Світового океану (мал. 49.1).
Прісна вода у природі наявна лише в льодовиках, поверхневих водах суходолу, підземних водах та атмосфері. Але, на жаль, через забруднення, зокрема в результаті людської діяльності, не вся прісна вода придатна до споживання. Тому однією з глобальних проблем сучасності є проблема нестачі питної води.
Усі частині гідросфери пов’язані між собою.
А колообіг води є однією зі складових обміну речовин у природі.
У 5 класі ви дізналися, як відбувається великий колообіг води (мал. 49.2 на с. 132).
Проте у природі є ще й малий колообіг води. Він також відбувається під впливом енер-
y Чи можливе життя на Землі без води?
y Чому Землю називають блакитною планетою?
y Завдяки яким властивостям воду вважають унікальною рідиною?
y Назвіть умови переходу води в різні агрегатні стани.
y Як нестача води може вплинути на живий організм?
y Назвіть оболонки Землі.
загадка
Деякі водорості та медузи майже на 99 % складаються з води. А тіло дорослої
людини — на 65 %. Чи можна вважати воду, яка є в живих організмах, складовою гідросфери?

Колообіг
1. Назвіть складові гідросфери.
2. Автор казки «Маленький принц» французький письменник Антуан де Сент-Екзюпері назвав воду «самим життям» та найбільшим багатством у світі. Як ви вважаєте, чому?
3. У чому відмінність малого та великого колообігів води у природі?
4. Загальний об’єм води на Землі становить близько 1,4 млрд км³. Обчисліть, скільки прісної води є на нашій планеті, використовуючи інформацію
з мал. 50.2.
5. У давні часи люди мили голову дощовою водою. Поміркуйте, чому сьогодні екологи не радять це робити, особливо в містах.
6. Кількість води на Землі майже не змінюється. Тоді чому існує проблема нестачі питної води? Відповідь аргументуйте.
гії Сонця, але лише над окремими океанами чи ділянками суходолу. Малий колообіг на суходолі іноді називають внутрішньоматериковим, адже він відбувається за схемою: суходіл — повітря — суходіл. Але іноді водяну пару, яка потрапляє в повітря з поверхні суходолу, повітряні маси переносять за межі материків. Тому чітких меж між малим і великим колообігами води у природі не існує. У колообігу води задіяні всі складові гідросфери. Також він пов’язує між собою всі оболонки Землі. Цей процес має планетарне значення, адже саме завдяки йому відбувається перенесення тепла й вологи на Землі.
Ключова ідея

Гідросфера — це водна оболонка Землі, що складається з вод Світового океану, вод суходолу та води в атмосфері. Основна частина води в гідросфері солона. У природі відбувається безперервний процес переміщення води, у якому задіяні всі оболонки Землі.
Дізнайтеся більше Серед основних забруднювачів води в Україні перше місце посідає житлово-комунальне господарство, друге — промисловість, а третє — сільське господарство. І хоча вважають, що гідросфера нашої планети може поступово оновлюватися, для цього потрібно дуже багато часу. Так, щоб в океані зникло забруднення, усе в ньому прийшло в норму і він очистився, необхідно понад 3 тис. років. А для очищення підземних вод потрібні тисячоліття.

§ 50. Світовий океан і його
Світовий океан займає майже 71 % поверхні земної кулі, складається з океанів, морів, заток і проток та омиває всі материки. До середини XVII століття поняття «Світовий океан» не існувало. Уперше його запропонував нідерландський географ Бернхард Варен, щоб позначити спільність усіх морів і океанів Землі.
Якщо покрутити глобус, можна побачити, що Світовий океан покриває нашу планету нерівномірно. Одна півкуля майже вся вкрита водою, за що й отримала назву «океанічна». А більшу частину «материкової» півкулі займають материки.
Найбільші частини Світового океану, обмежені материками, називають океанами. Сьогодні виокремлюють Тихий, Атлантичний, Індійський, Південний і Північний Льодовитий океани (мал. 50.1).
Дослідження
Побудуйте схему, на якій позначте найглибші океанічні западини океанів світу (у порядку зменшення глибини). Роботу можна виконати як у зошиті, так і за допомогою комп’ютера.
y За якими критеріями Світовий океан розділили на
п’ять окремих океанів?
y Чому моря, які розташовані на материках, також відносять до складу Світового океану?
y З яких частин складається гідросфера? Яка з них найбільша?
y Назвіть океани Землі.
загадка
Кожен з океанів має свої моря. Якщо на карті порахувати всі назви великих водних об’єктів, які мають у своєму складі слово «море», їх буде досить багато, хоча насправді морів лише 63. Які ще моря, що не є складовими Світового океану, є на карті?

1. Розгляньте інформацію про океани на схемі.



2. З’ясуйте, в якому океані найглибша западина, а в якому — найменш глибока.
3. Оберіть масштаб для схеми.
4. Намалюйте згідно з масштабом шкалу глибин, розташувавши її вертикально. Проведіть горизонтальну лінію, що позначатиме поверхню океану, тобто 0 м. Вона має бути зверху.
5. Униз від цієї лінії проведіть лінії відповідної довжини (згідно з масштабом), що позначатимуть глибину найглибшої западини кожного з п’яти океанів (як зображено на малюнку).
6. Зробіть підписи западин та океанів.
7. За значенням середньої глибини зробіть висновок: який океан найглибший, а який має найменшу глибину.
Моря
Мал. 50.2. Чорне й Азовське моря
Море — це частина океану, частково відокремлена від нього суходолом, островами або підвищеннями океанічного рельєфу, та відрізняється від нього властивостями й складом води. Кожне море належить до басейну певного океану, а саме того, з яким воно сполучається. Наприклад, Чорне море є складовою басейну Атлантичного океану. Залежно від того, де розташовані моря, їх розділяють на окраїнні, міжострівні та внутрішні. До внутрішніх морів, які глибоко врізаються в суходіл та сполучаються з океаном лише протоками, відносять, зокрема, Середземне, Чорне й Азовське моря (мал. 50.2).
Цікаво, що свого часу назву «море» помилково отримали деякі великі озера, як-от Мертве море.
На відміну від моря, затока — це частина океану або моря, що врізається в суходіл, але має з основною частиною водойми вільний водообмін, як-от Біскайська, Бенгальська, Мексиканська, Гвінейська.
Іноді затоки називають бухтами. Проте зазвичай бухта — це невелика частина моря, затоки, озера чи водосховища, що відокремлена від них частинами суходолу з трьох боків. Оскільки завдяки ним бухти мають додатковий захист від хвиль і вітру, там зазвичай будують порти або стоянки для суден, наприклад Севастопольська бухта в Чорному морі.
Протоки — це природні звужені ділянки водного простору між двома континентами або їхніми частинами чи островами, які поєднують суміжні водні об’єкти або їхні частини. Саме протоки з’єднують океани з внутрішніми морями. Наприклад, Гібралтарська протока між Африкою та Європою, яку використовують у навігаційних цілях, поєднує Середземне море з Атлантичним океаном.
Світовий океан включає в себе п’ять океанів. Середня глибина Світового океану 3,7 км, а максимальна — 11 022 м.
До нього належать 63 моря, серед яких розрізняють внутрішні, окраїнні й міжострівні, затоки і протоки.
1. Назвіть частини Світового океану.
2. Чим затока відрізняється від протоки?
3. Підпишіть на контурній карті частини Світового океану, які згадувалися в параграфі.
4. Морська тематика присутня у творах багатьох художниківмариністів. Знайдіть в інтернеті картини із зображенням моря. Зробіть презентацію та поділіться цією інформацією з однокласниками й однокласницями. 5. Порекомендуйте мореплавцям найкоротший морський шлях з України до Австралії. Відповідь сформуйте у вигляді переліку частин Світового океану, через які буде проходити маршрут: «Свій шлях починаємо з Чорного моря, через… протоку…».
Уперше назву Південний океан почали використовувати в XVII столітті. Мандрівники припускали, що існує південний материк, тому на карті такою назвою позначали ділянку океану поблизу ще не відкритого уявного материка. 1937 року Міжнародна гідрографічна організація затвердила Південний океан як п’ятий. Проте багато науковців наголошували на недо -
цільності такого рішення, і Південний океан знову зник із карт світу. Новітні гідрологічні дослідження наприкінці XX століття довели, що природні умови в цій частині Світового океану дуже різняться від його інших частин. Тому 2000 рік став черговим «роком народження» Південного океану.
Дізнайтеся більше
y Під дією яких чинників формується рельєф дна Світового океану?
y Чим острів відрізняється від материка?
y Чим океанічна земна кора відрізняється від материкової?
y Назвіть планетарні форми рельєфу.
y Назвіть внутрішні та зовнішні сили Землі, які впливають
на формування рельєфу материків.
y Назвіть найглибшу западину. У якому океані вона розташована?
Уперше опис морського дна, який дійшов до наших часів, зробив 450 року до н. е. Геродот. Він описав Середземне море біля узбережжя Єгипту. Сьогодні, щоб побачити, як виглядає рельєф дна Світового океану, ми використовуємо цифрові карти, наприклад карти Національного управління океанічних і атмосферних досліджень (мал. 51.1).

Рельєф дна Світового океану формується під дією тих самих внутрішніх сил Землі, що і рельєф материків (мал. 51.2). Умовно його поділяють на шельф, материковий схил та ложе. Шельф — це прибережні частини материків із глибиною до 200 м. Шельф оточує материк з усіх боків і являє собою рівнину з невеликим схилом. Після шельфової зони на глибині від 200 до 2000 м розташований материковий схил. Він стрімко обривається та переходить безпосередньо в ложе океану — глибинну частину дна. Майже до середини XIX століття океанічне дно вважали ідеально рівним. Але насправді там є рівнини й гори, як і на материках. Підводні гори, що лежать на межах літосферних плит, називають серединно-океанічними хребтами. Приміром, Серединно-Атлантичний хребет, який простягається на 18 тис. км.
Магма, що піднімається тріщинами літосфери, постійно добудовує підводні гори та не допускає їх руйнування. А вершини хребтів, що піднімаються над водою, утворюють острови.
Мал. 51.1. Фрагмент карти Національного управління океанічних і атмосферних досліджень, що показує підводний рельєф дна океану
В океані можна спостерігати й вулканічну діяльність. Виверження підводних вулканів призводять до появи вулканічних островів. І якщо вулкан діючий, розміри таких островів можуть збільшуватися. Найглибші ділянки океану припадають на глибоководні жолоби — довгі вузькі зниження дна з найбільшими глибинами.
Видавництво
Якщо здійснити умовну подорож уздовж берегів океанів або морів, на своєму шляху ми побачимо частини материка, що далеко врізаються в море і з трьох боків оточені водою. Це — півострови, як-от Аравійський півострів, Кримський півострів тощо. У геологічному відношенні в більшості випадків півострів складає одне ціле з материком (мал. 51.3).
Із «великою землею» півострів можуть з’єднувати вузькі невеликі видовжені ділянки суходолу — перешийки.
Мис, або ріг, — частина суходолу, що врізається в море у вигляді гострого кута, наприклад мис Сарич у Криму. Одним із найнебезпечніших для мореплавців є мис Горн. Тут майже 300 днів на рік іде дощ, дме дуже сильний вітер. «Паща диявола», «Цвинтар кораблів», «Старий людожер» — так мис Горн із давніх-давен
називали моряки та мандрівники.


Деякі ділянки суходолу можуть бути оточені водою з усіх боків — це острови. Вони височіють над морськими водами, але відрізняються від материків порівняно невеликими розмірами. Залежно від походження острови поділяють на материкові (Гренландія, Калімантан, Мадагаскар), вулканічні (Ісландія, Гавайські острови, Канарські острови) та коралові, які ще називають атолами. Острови, що лежать на невеликій відстані один від одного й об’єднуються в одне ціле, називають архіпелагом.
Ключова ідея
Рельєф дна Світового океану складається з шельфу, материкового схилу та ложа океану з підводними хребтами, рівнинами й океанічними жолобами. Вершини хребтів, які піднімаються над водою, утворюють острови. Виверження підводних вулканів призводять до появи вулканічних островів. В океанах і морях тропічного поясу розташована велика кількість островів, утворених у результаті життєдіяльності коралів.
Мал. 51.3. Півострів Пелопоннес, Греція
Запитання і завдання
1. Назвіть форми рельєфу дна Світового океану. Наведіть приклади.
2. Поясніть, як утворюються різні типи островів.
3. Представникам яких професій потрібна інформація про рельєф дна моря чи океану?
4. Підпишіть на контурній карті острови: Велика Британія, Гренландія, Мадагаскар, Нова Гвінея; півострови: Скандинавський, Кримський, Аравійський, Індостан, Сомалі, Лабрадор.
5. У якому місці Світового океану можна «сховати» найвищу вершину світу? Відповідь поясніть за допомогою шкали висот і глибин.
6. Обґрунтуйте висновок, що рельєф дна Світового океану постійно змінюється.
Чому вода в морі солона?
y Назвіть відомі вам властивості води.
y За якої температури вода замерзає?

y Як знайти середнє арифметичне числа?
загадка
Під час Другої світової війни
військові хірурги через брак крові для переливання
успішно використовували
замість неї розведену мор -
ську воду. Цей розчин навіть
отримав свою назву — розчин
Квінтона. Завдяки чому він став замінником крові?
Солоність
Солоність води — це кількість солі в грамах, яка розчинена в 1 л океанської води. Вона визначається в проміле (одна тисячна частина) та позначається ‰. Середня солоність океану — 35 ‰, тобто якщо випарити 1 л океанської води, ми отримаємо 35 г солі. Із речовин, що утворяться після випарювання, найбільше буде звичайної кухонної солі (натрій хлорид NaCl) — 27 г. Саме вона надає морській воді солоного присмаку (мал. 52.1). А гіркоти їй надають солі Магнію. Також у морській воді наявні сполуки інших хімічних елементів. Прісна вода має солоність менше 1 ‰.
Солоність води в деяких морях, наприклад у Червоному морі (42 ‰), більша, ніж середня солоність в океані. А деякі моря, як-от Чорне море, мають солоність меншу, ніж навколишній океан — 18 ‰.
Солоність води змінюється від екватора до полюсів (мал. 52.2). У посушливих регіонах, де випаровування значно більше за кількість атмосферних опадів, а річок із прісною водою, що впадають в океан, мало, солоність води буде більшою. І навпаки, якщо приплив прісної води зі стоком річок та опадами переважає над випаровуванням, вода буде менш солоною. Води від танення льодовиків та снігу, які стікають в океан, також зменшують його солоність.
Температура
Мал. 52.1. Морська сіль
Світовий океан упродовж року отримує від Сонця багато тепла. Проте прогрівається лише його поверхня. Оскільки кількість тепла зменшується від екватора до полюсів, температура поверхневого шару води також знижується відповідно (мал. 52.3).
Видавництво
Досліджуємо Землю та життя на Землі
Найвища температура води в районі екватора та тропіків — від +25 до +27 °С. У полярних районах із холодним кліматом температура води може знизитися до –1,8 °С. І навіть за такої низької температури вода не замерзає, оскільки температура замерзання солоної води становить –2 °С. Отже, льодовий покрив може виникати лише в полярних районах — у Північному Льодовитому та Південному океанах (мал. 52.4).
Коли ми заходимо влітку в море, то відчуваємо, що вода на поверхні тепліша, ніж у глибині. Дійсно, температура води у Світовому океані змінюється із глибиною. Сонячне тепло та світло проникають у води океану на глибину до 100 м, тому саме в цьому шарі зосереджені теплі води.
А на глибині понад 1000 м вода не прогрівається вище +2…+3 °С. Якщо була б можливість перемішати всю воду у Світовому океані та виміряти її температуру, вона б становила лише +4 °С.
Ключова ідея
Солоність води в різних частинах океанів неоднакова. Температура води Світового океану зменшується від екватора до полюсів. Також вона зменшується з глибиною.
1. Від чого залежить солоність води в океані?
2. Чому людина може загинути від зневоднення посеред моря?

3. Скільки грамів солі можна випарити з 3 л морської води Червоного моря, якщо її солоність 42 ‰? Скільки грамів із цієї кількості припаде на кухонну сіль?
4. Які причини зміни температури води в океані з широтою та глибиною?
5. Поміркуйте, для чого можна використовувати морську воду.


Звук у воді може поширюватися зі швидкістю до 1570 м/с. Швидкість залежить від температури
води, її солоності та тиску: за їх підвищення
швидкість зростає. За допомогою гідроакустич-
них приладів досліджують глибини морів і океанів для судноплавства. Також гідроакустичні
прилади дозволяють виявити цунамі лише
кілька годин.
Дізнайтеся більше
y Чому море може «рухатися»?
y Чи може вода в океані рухатися та «перемішуватися» від його дна до поверхні?
y Властивості води Світового океану.
y Як змінюється температура
поверхневих вод від екватора до полюсів?
y Як Місяць впливає на Землю?
y Чому утворюється вітер?
y Що таке рух тіла?
загадка
Коли від льодовиків Антарктиди відколюється величезний
уламок — айсберг — він починає дрейфувати океаном
у бік екватора. Вчені дослідили, що рух відбувається
певними шляхами й назвали цей напрям «алеєю айсбергів».
Що це за шляхи, якими подорожують айсберги?
Водні маси
Великі об’єми води, що відрізняються температурою й солоністю, називають водними масами. Як і повітряні маси, вони отримали назви відповідно до місця їх формування — екваторіальні, тропічні, помірні й полярні водні маси. Вони перебувають у постійному русі, який залежить від декількох чинників.
Рух води може бути коливальним (хвилі) чи поступальним (течії).
Океанічні течії
Океанічні течії виникають через дію вітрів і велику різницю в густині води. Відповідно до цього їх поділяють на приповерхневі, що спричинені впливом потужних постійних вітрів, та глибинні. За температурою води розрізняють теплі течії, води яких тепліші за навколишні (Гольфстрим), та холодні течії, води яких холодніші за навколишні (течія Західних Вітрів). У тропічних широтах уздовж східного узбережжя материків прямують теплі, а вздовж західного — холодні течії. А в помірних широтах східне узбережжя омивають холодні, а західне — теплі течії (мал. 53.1).
Отже, поверхневі води Світового океану перебувають у стані циркуляції. Але маси води рухаються також і вертикально, утворюючи глибинну циркуляцію, яка виникає через різну солоність, та відповідно різну густину води.
Морські хвилі
Причини утворення хвиль також можуть бути різними: вітер, землетруси, сила тяжіння тощо.
Причиною утворення вітрових хвиль є вітер, який зумовлює вертикальний коливальний рух водної поверхні, висота хвиль залежить від його
Видавництво

Мал. 53.1. Океанічні течії
сили і тривалості. Іноді хвилі можуть «зароджуватися» за тисячі кілометрів від берега. Середня
висота хвилі під час шторму в океані може бути 7–8 м, але іноді вони сягають 18–20 м (мал. 53.2).
Гігантські хвилі, що утворюються в результаті сейсмічної чи вулканічної діяльності на дні океану, називають цунамі (мал. 53.3).
Цунамі — хвилі величезної руйнівної сили, які можуть перетинати океан зі швидкістю до 800–1000 км/год, тобто швидше за реактивний літак. Цікаво, що у відкритому океані їхня висота незначна, і вони не становлять небезпеку. А ближче до берега висота цунамі зростає до 20–30 м. Тому хвиля «обрушується» на узбережжя та завдає великих руйнувань.
Мал. 53.2. Структура хвилі

Мал. 54.3. Утворення цунамі

2. Досліджуємо Землю та життя на Землі
На Землі не існує чіткої межі гідросфери, адже вода є і в літосфері, і в атмосфері. Так само й повітря є не лише в атмосфері.
Дослідження: виявлення повітря у воді
1. Що спільного між повітряними та водними масами?
2. Наведіть приклади теплих і холодних течій. Покажіть їх на карті.
3. Назвіть типи хвиль залежно від причини їх утворення.
4. Підготуйте пам’ятку для населення щодо безпечної поведінки на березі під час шторму.
5. Однією з головних ознак появи цунамі є раптовий швидкий відхід води від берега на значну відстань та осушення дна. Поясніть, чому це відбувається.
6. Художників, які пишуть картини із зображенням моря, називають мариністами. За допомогою додаткових джерел інформації створіть віртуальну виставку картин мариністів у вигляді презентації. Обов’язково зазначайте джерело інформації.
1. Налийте в прозору склянку воду та залиште на декілька годин. Що можна побачити на стінках?
2. Поставте каструлю з водою на вогонь та доведіть до кипіння. Що доводять бульбашки повітря, які з’являються в процесі кипіння?
Дослідження доводить, що повітря є не лише в атмосфері, але й у воді. А вода є і в літосфері, і в атмосфері. Таким чином оболонки Землі перебувають у постійній взаємодії через обмін речовинами та енергією Також завдяки океанам в атмосфері відбуваються циркуляція повітряних мас і перенесення тепла.
Наслідками такої взаємодії між океаном та атмосферою є перерозподіл тепла, вологи та речовин.
Ключова ідея
Води Світового океану перебувають у стані постійного руху, спричиненого дією вітрів, сейсмічною та вулканічною діяльністю на дні океану, силою тяжіння Місяця та Сонця. Відповідно утворюються поступальні рухи — океанічні течії, та коливальні рухи —хвилі (вітрові, цунамі, припливно-відпливні).
Дізнайтеся більше
«Ревучі сорокові» (англ. Roaring Forties) — таку назву дали моряки ділянці океану між 40° і 50° південної широти. Тут завжди дмуть сильні та стійкі західні вітри, що спричиняють часті шторми й величезні хвилі. У ті часи, коли морські подорожі відбувалися на вітрильних кораблях, що залежали саме від вітру, через ці широти попри небезпеку прокладали «найшвидші» маршрути. У наш час яхтсмени також віддають перевагу цим маршрутам під час навколосвітніх подорожей та змагань.

до життя у воді

На пристосування організмів до водного середовища існування впливають певні фактори неживої
природи: солоність і густина води, освітленість, низький уміст кисню і стабільний температурний режим (порівняно з атмосферою) тощо. Рослини й тварини водного середовища мають характерну будову, зумовлену особливостями життя у воді (мал. 54.1).
Зокрема, у тварин обтічна форма тіла, вкритого слизом. А в деяких савців і птахів пера вкриті спеціальною рідиною, що захищає їх від намокання. Більшість морських тварин мають плавці, ласти чи плавальні перетинки. Рослини мають гнучке стебло, коренями кріпляться до дна водойми. А листочки часто нагадують стрічки, щоб збільшити площу вбирання кисню з води.
Рослинний світ Тихого, Атлантичного й Індійського океанів представлений зеленими, червоними та бурими водоростями (мал. 54.2). А ось у Північному Льодовитому океані та частково
Ернест Хемінгуей — американський письменник і журналіст, лауреат Нобелівської премії з літератури — свого часу говорив: «Людина в морі ніколи не буває самотньою».
Що мав на увазі Хемінгуей? Чи
поділяєте ви його думку?
Що таке «біорізноманіття»?
загадка
«Оксана раділа подарунку. Не кожна красуня в селі може похизуватися такими красивими червоними коралами. Їх
привіз їй тато із Криму, куди їздив із чумаками по сіль. Цей подарунок обійшовся
татові у 10 дукатів. Оксані було цікаво, де добувають такі красиві камені. Якими ж було її здивування, коли вона дізналася, що корали — дарунок моря».
З’ясуйте, яку тварину морів і океанів описано в уривку з оповідання Г. КвіткиОснов’яненка «Сердешна Оксана».
Мал. 54.1. На різних глибинах мешкають різні види організмів, які пристосувалися до певних умов водного середовища
Розділ 2. Досліджуємо Землю та життя на Землі
Мал. 54.2. Водорості в Атлантичному океані
в Південному океані рослинний світ дуже бідний через кліматичні умови. Тваринний світ океанів, на відміну від рослинного, дуже різноманітний. Видовий склад залежить, зокрема, від температури води, до якої пристосувалися як теплокровні, так і холоднокровні тварини. Наприклад, дельфінів можна зустріти в теплих водах Тихого, Індійського й Атлантичного океанів, а от моржів можна побачити лише в Північному Льодовитому океані (мал. 54.3).
Сьогодні в інтернеті є багато фільмів, присвячених тваринному світу океанів. Зокрема, це фільми Жака-Іва Кусто, Жака Перрена та інших дослідників і дослідниць. Пропонуємо переглянути деякі з них.
Мал. 54.3. Моржі — великі морські ссавці, які поширені по всьому узбережжю Північного Льодовитого океану





Мешканці Чорного й Азовського морів У Чорному морі більшість організмів зосереджена на мілководді та в приповерхневому шарі, а глибше (150–200 м) мешкають прокаріотичні організми. Рослинність Чорного й Азовського морів представлена великою кількістю видів водоростей, зокрема червоних (філофора), зелених (ульва), бурих (цистозіра) та фітопланктону — рослинних організмів, які рухаються в товщі води під дією течії, хвиль, вітру тощо. Трапляються представники трав’янистих рослин, наприклад зостера — багаторічна рослина з повзучим кореневищем. Її часто використовують для виготовлення будівельних матеріалів або як добриво. Серед безхребетних тварин у наших морях переважають ракоподібні (креветки, раки-саміт-



Скат морський кіт Тюлень-монах
ники й краби) та молюски (мідії, рапани, морські гребінці, устриці). Зустрічаються також представники медуз — коренерот і аурелія. Улітку відбувається масове розмноження цих жалких тварин, що спричиняє проблеми для відпочиваючих.
Хребетні тварини Чорного й Азовського морів представлені рибами (понад 150 видів): акула катран, скат морський кіт, камбала, кефаль, скумбрія, оселедець, шпрот тощо. Тут можна зустріти й водних ссавців: це Тюлень-монах звичайний і три види дельфінів: афаліна, білобочка та морська свиня. А на узбережжі морів мешкає чимала кількість птахів, зокрема пелікани, чайки, баклани, степова дрохва, залітають чорний лелека, казарка, гірський гриф тощо.
1. Які особливості пристосування організмів у/на воді? Кого називають гідробіонтами?
2. Прочитайте назви організмів. Визначте правильний наголос у словах, використавши словник наголосів. За допомогою мережі інтернет дізнайтеся, у яких океанах мешкають ці організми.
Сардинела, скумбрія, кайри, філофора, калан, камбала, нототенія, коренерот, палтус, аурелія, навага, цистозіра, рапана.
3. Схарактеризуйте фактори, що впливають на різноманіття організмів у морях України.



Водне середовище існування має низку факторів, що впливають на пристосування організмів: густина, температурний режим, розріджений кисень, освітленість і певний сольовий баланс. У Чорному й Азовському морях мешкає чимало різних організмів: представники одноклітинних, ракоподібних, молюсків, жалких, риб, ссавців і птахів.
Афаліна Дізнайтеся більше Борис Александров — видатний український гідробіолог. Запропонував методологію збереження біологічного різноманіття Чорного моря. Його ім’ям названо судно, яке Україна отримала в подарунок від уряду Бельгії. Судно використовують для моніторингу Чорного моря, зокрема, дослідження морського дна і збирання екологічних даних.
4. Ще донедавна в Азовському морі виловлювали риби в 35 разів більше, ніж у Чорному, та у 12 разів більше, ніж у Балтійському. В Азовському морі мешкало понад 114 видів риб. Чому сьогодні води Азовського моря перебувають на межі екологічної катастрофи? Що варто зробити, аби уникнути незворотних екологічних наслідків? 5. За додатковими джерелами інформації створіть трейлер на тему «Глибоководні тваринихимери, що могли б виконати головну роль у фільмах жахів». Зверніть увагу на те, як ці тварини пристосувалися до життя у водному середовищі.

y Куди течуть річки? Як на це впливає рельєф?
y Чому рівень води в річці може змінюватись?
y Яку роль у житті людства відіграють річки?
y Які води суходолу є складовою гідросфери?

y Як відбувається колообіг води в природі?

загадка
На нашій планеті величезна кількість річок. Вони утворюють річкову систему, яку часто порівнюють із кровоносною системою тварин. Поясніть, чому річки називають кровоносною системою Землі.
Річка та її частини
Річка — це природний водний потік, що тече в зниженні рельєфу, яке називається руслом, або річищем (мал. 55.1).
Кожна річка має свій початок — витік. Це може бути джерело, озеро, болото або льодовик. Від витоку річковий потік несе свої води вниз за течією до гирла, де впадає в іншу річку, озеро або море. Відстань від витоку до гирла називають довжиною річки. Це приблизна величина, адже іноді буває важко визначити точне місце гирла. Тому за перше місце серед найдовших річок світу змагаються Ніл та Амазонка. Потім ідуть Янцзи, Міссісіпі, Єнісей. Дніпро має довжину 2287 км та посідає 48 місце.
1. За допомогою додаткових джерел інформації з’ясуйте, яку довжину мають п’ять найдовших річок світу.
2. Доберіть відповідний масштаб і намалюйте схему, на якій відобразіть довжину кожної річки.
3. За допомогою карти півкуль (Додаток 1) з’ясуйте, на яких материках протікають ці річки. Зробіть відповідні підписи на схемі (див. зразок).
Зазвичай річка — це постійний потік води. Деякі річки залишаються повноводними впродовж усього року. В інших рівень води змінюється відповідно до сезону.
Досліджуємо Землю та життя на Землі
влітку повністю пересихають, відкриваючи русло. Такі річки в Австралії називаються кріками, а в Азії та Африці — ваді (мал. 55.2).

У річку можуть впадати інші річки, які називають притоками. Розрізняють праві та ліві притоки (залежно від того, з якого боку вздовж течії головної річки вони впадають).

Головна річка та її притоки утворюють річкову систему.
Річкова система може бути дуже розгалуженою та нагадувати кореневу систему дерева. Найбільшою річковою системою світу є Амазонка з притоками. Територію, з якої річка разом із притоками збирає воду, називають басейном річки (мал. 55.3).

течії річки
Річки поділяють на рівнинні та гірські. Від рельєфу залежать особливості їхньої течії: рівнинні річки повільні, з широкими долинами, а гірські, навпаки, мають швидку течію, вузькі
Розділ 2. Досліджуємо Землю та життя на Землі

1. Назвіть води суходолу.
2. Як за допомогою карти можна визначити, де в річки
витік, а де — гирло; які притоки праві, а які — ліві?
3. Для представників яких професій буде корисною інформація, отримана в ході гідрологічних досліджень?
4. На контурній карті позначте річки Дніпро, Дністер, Дунай, Янцзи, Ніл, Амазонку, Міссісіпі.
5. За допомогою карти України з’ясуйте, які річки протікають територією вашої області. Яка з них найближча до вашого населеного пункту?
6. Річку Дніпро вважають головною річкою нашої країни, хоча її довжина менша за довжину річки Дунай, яка також протікає територією України. Як ви вважаєте, чому?
й глибокі долини. Іноді, коли потік води падає
з високого скелястого уступу, утворюються водоспади (мал. 55.4).
Найбільшим водоспадом є Ніагарський водоспад, а найвищим — водоспад Анхель.
А коли на шляху річки трапляються тверді гірські породи, які вона не в змозі розмити, утворюються пороги. Велику кількість порогів мав Дніпро. На початку тисячоліття, щоб проплисти від Києва вниз за течією, доводилося частину шляху тягнути човни берегом, щоб оминути ці величезні брили, що здіймалися серед Дніпра. Сьогодні ці пороги перебувають під водою через побудовану Дніпровську ГЕС (мал. 55.5). А низка шлюзів дозволяє річковим суднам курсувати Дніпром без перешкод.
Гідрологічні дослідження Природні води в межах гідросфери Землі, а також явища й процеси, які в них відбуваються, вивчає наука гідрологія. Гідрологічні дослідження — це спостереження за такими характеристиками водних об’єктів, як рівень води, її температура та гідрохімічні показники, швидкість течії, глибина тощо.

Ключова ідея
Річка — це водний потік, що тече у виробленому ним заглибленні, який називається річищем (руслом). Основними частинами річки є витік, гирло та притоки. Річка зі своїми притоками утворює річкову систему. Річки поділяють на рівнинні та гірські.
Дізнайтеся більше Упродовж певного періоду часу річку Ніл вважали найдовшою на планеті. Річка Амазонка посідала друге місце. Однак кілька років тому наукова група з Бразилії довела, що Ніл таки поступається Амазонці. Дослідження виконували з використанням супутникових даних.
Озера на нашій планеті займають близько 2,1 млн км2, або понад 1,4 % площі суходолу. Озеро — це природне замкнене заглиблення суходолу, заповнене водою. Озера не мають зв’язку з океаном, а живляться річковим або підземним стоком та атмосферними опадами.
Відповідно до походження западини (улоговини), у якій згодом утворилося озеро, розрізняють різні типи озер. Тектонічні озера найбільші й найглибші. Другим за глибиною (після Байкалу) озером є Танганьїка. Воно простяглося з півночі на південь на 676 км (що майже дорівнює відстані від Києва до західного кордону України).
У багатьох озерах беруть початок річки. Такі озера називають стічними. Із проточних озер річки не лише витікають, а й упадають до них. А безстічні озера не мають стоку. Вони розташовані переважно в напівпустелях і пустелях та залежать від кількості опадів у регіоні.
Іноді озера можуть різко змінювати свої межі. Наприклад, озеро Чад — одне з найбільших озер світу — не має сталої площі. Так, у суху пору року воно займає 11 тис. км2, а в період дощів збільшується майже вдвічі. Через те, що площа випаровування озера дуже велика, а глибина ледь сягає 7 м, межі озера змінюються залежно від кількості опадів у верхів’ях річок, що його живлять (мал. 56.1).
Властивості озерної води


Озера є природними резервуарами прісної води. Зазвичай стічні та проточні озера є прісними, оскільки вода в них постійно оновлюється. Якщо в озерній воді розчинена певна кількість мінеральних речовин, зокрема солі, озера вважають солоними або солонуватими.
y Чим внутрішнє море відрізняється від озера?
y Як кратер вулкана може заповнитися водою?
y Де може бути витік річки?
y Що таке русло річки?
y Який процес називають випаровуванням?
загадка
Мертве море, якому понад
3 млн років, — одна з дивовижних водойм нашої планети. У його назві є і правда, і неправда. Поміркуйте, що саме.
Розділ 2. Досліджуємо Землю та життя на Землі
Мал. 56.2. Озеро Сасик (Кундук)

1. Назвіть типи озер.
2. Складіть перелік озер України, про які йшлося в параграфі, та знайдіть їх на фізичній карті України.
3. Поясніть, у чому полягає різниця між стічними та безстічними озерами.
4. Чому іноді на запитання: «Яка площа цього озера?» не можна отримати чіткої відповіді?
5. Уміст солі в Мертвому морі з часом збільшується. Багато
в чому це відбувається внаслідок діяльності людини. Поясніть, як людина може впливати на солоність води в озері.
6. Уявіть, що ви працюєте в туристичній фірмі. Порекомендуйте декілька варіантів відпочинку на озері з метою лікування та проведення косметологічних процедур.
Безстічні озера є переважно солоними. Мертве море — одна з найсолоніших водойм світу, оскільки його середня солоність становить 310 ‰. А в окремі роки вона може сягати 350 ‰. Солона вода Мертвого моря насичена цілющими речовинами, тому її використовують для лікування й оздоровлення. Також у Мертвому морі видобувають калійні та інші солі.

Хімічний склад озерних вод, на відміну від річок, є відносно сталим. Проте іноді людина вирішує втрутитися у природу, що часто призводить до екологічних проблем. Так сталося з найбільшим озером України — озером Сасик (Кундук), яке розташоване на узбережжі Чорного моря. Площа озера становить 210 км2. До 1978 року воно складалося із солонуватої та солоної частин. Потім озеро вирішили опріснити, відокремивши від Чорного моря та вливаючи в нього воду з річки Дунай. Це призвело до певних екологічних проблем. І хоча процес опріснення було зупинено, для поліпшення екологічного стану озера необхідно відновити його зв’язок із Чорним морем (мал. 56.2).
Ключова ідея
Озера — природні заглиблення суходолу, заповнені водою. Вони не мають безпосереднього зв’язку зі Світовим океаном. За типами озерних улоговин розрізняють тектонічні, вулканічні, загатні, льодовикові, річкові, морські, карстові та залишкові озера. Вода в озерах може бути як прісною, так і солоною.
Дізнайтеся більше Окрасою Шацьких озер на Волині є найглибше озеро в Україні — Світязь. Подекуди його глибина перевищує 58 м. Озеро живиться лише підземними водами: у нього не впадає жодна річка. Вода в озері має лікувальні властивості, адже містить срібло та гліцерин. Вона сприяє загоєнню ран і добре впливає на шкіру. На базі відпочинку, що розташована на березі Світязя, проходили відновлення космонавти після повернення з космічної орбіти.
У прісних водоймах, як і в солоних, організми мають усі необхідні для життя умови: світло, тепло, повітря та поживні речовини.
Прісноводне середовище існування за своїми умовами значно відрізняється від наземно-повітряного. Наприклад, у ньому менші коливання температури впродовж доби та року, уміст кисню також значно менший, адже він розчинений у воді.
Як кісткові риби в річках та озерах змінюють глибину занурення? Для цього їм стає в пригоді плавальний міхур. Змінюючи його об’єм, риби змінюють середню густину тіла, і тому можуть спливати до поверхні води або занурюватися на дно водойми.
Це добре ілюструє дослід, що увійшов до історії науки під назвою «картезіанський водолаз», на основі якого пізніше створили іграшку з такою самою назвою. Уважають, що дослід запропонував французький фізик і математик Рене Декарт (французським правописом правильно писати Рене де Карт ). Спробуйте відтворити цей дослід удома.
Для цього вам знадобляться велика пластикова пляшка та піпетка.
1. Налийте в пластикову пляшку теплу воду.
2. Наберіть трохи води в піпетку та опустіть всередину пляшки. Піпетка має плавати, трохи виступаючи над рівнем води.
3. Закрийте пляшку кришкою і щільно закрутіть.
4. Натисніть на пляшку.
5. Що відбувається з піпеткою? Чому це відбувається?
y Які особливості пристосування організмів до життя у / на воді?
y Що станеться з рибами, якщо у прісне озеро потрапить солона вода?
y Яке значення води у природі?
y Які водойми належать до прісних?
y Кого називають гідробіонтами?
y Як пристосовуються рослини до життя у солоних водоймах?

Дослід «картезіанський водолаз»

«Ранок»

загадка

«Водяні лілії» — цикл із близько 250 картин французького художника-імпресіоніста Клода Моне. Розгляньте картину. Чи правильне твердження: «Водяні рослини, які мають білий і рожевий
кольори — лілії, а от круглі жовті квітки — латаття?»
Флора прісноводних водойм має значно кращі умови для існування, аніж у солоних. Тому можемо спостерігати багате рослинне різноманіття. В Україні на заплавах переважно ростуть берест, вільха, верба, аїр звичайний, червона й чорна бузина та навіть калина. На мілководді ростуть калюжниця, цикута, очерет, рогіз, осока та стрілолист. На поверхні води вільно плавають біле латаття, глечики жовті, ряска тощо (мал. 57.1).





Мал. 57.2. Сальвінія плавуча та водяний горіх
Також у прісних водоймах є рослини, які все життя проводять під водою. Так, елодея фіксує своє коріння на дні водойми, а от кушир цього зробити не може через відсутність кореневої систем. Ці глибоководні рослини є найкращим захистом для риб під час розмноження та стають корисною окрасою прісноводних акваріумів. Сальвінія плавуча — водяна папороть, що прикрашає поверхню деяких ставків, як і рідкісний водяний горіх, занесений до Червоної книги України (мал. 57.2).

»
Мал. 57.5. Рак вузькопалий, водяний ослик зрячий

Справжніми «господарями» прісноводного
світу серед тварин є кісткові риби. В українських водоймах це плотва, краснопірка звичайна, амур білий, лящ, карась, короп, товстолоб, сом, судак, окунь тощо (мал. 57.3).
Можна побачити й інших тварин — ропуху зелену, бобра, видру річкову, нічницю ставкову. На узбережжях прісноводних водойм живе багато птахів — лелека чорний, журавель сірий, скопа, рибалочка блакитний, курочка водяна, змієїд тощо (мал. 57.4).
У річках та озерах можна зустріти п’явку медичну, гідру, губку бодягу, безхребетних членистоногих тварин (рак вузькопалий, водяний ослик зрячий тощо), різноманіття комах, молюсків та інших видів (мал. 57.5).
1. Чим прісноводне середовище існування за своїми умовами відрізняється від наземно-повітряного?
2. Як водяні лілії пристосувалися до водного середовища існування? Які легенди пов’язані з цією рослиною? Відшукайте народні назви цієї рослини.
3. Уявіть, що ви ландшафтний дизайнер / дизайнерка. Вам необхідно зробити проєкт штучного озера для присадибної ділянки. Яких тварин і рослини ви туди розмістили б? Обґрунтуйте свій вибір.
4. Які наслідки для біорізноманіття матиме зміна складу води у водоймі в результаті хімічного забруднення?
Ключова ідея

У прісних водоймах організми мають усі необхідні для життя умови: світло, тепло, повітря та поживні речовини. Тому рослинний і тваринний світ прісних водойм дуже різноманітний.
Дізнайтеся більше
5. Виготовіть лепбук «Тварини та рослини прісноводних водойм».
6. Висловіть власне ставлення до неконтрольованого вилову риби у водоймах. Чим це може загрожувати екосистемі водойми?
Вадим Владиков — засновник наукової іхтіології (науки про риб) Закарпаття. Також його вважають основоположником сучасної іхтіології колишньої Чехословаччини та Канади. Розпочав досліджувати рибний світ річок та озер Закарпаття 1923 року, а результати досліджень описував, зокрема німецькою, французькою та чеською мовами. У своїх роботах дав не лише систематику риб Закарпаття, а також їх місцеві назви та цікаві матеріали про риболовлю. За ці дослідження отримав Золоту медаль у Парижі. На честь науковця було названо один із видів міног — Eudontomyzon vladykovi , або мінога Владикова.

Видавництво
«Ранок»

y Як бобри можуть сприяти утворенню боліт?
y За яких умов озеро може перетворитися на болото?
y Чому з болотом пов’язані народні повір’я про «нечисть»?
y Як утворюються річкові озера?
y Що таке торф?
загадка
Ми звикли називати ліси «легенями планети». Проте також це можна застосувати й до боліт. А ще болота називають природним «пилососом». Як ви вважаєте, чому?
Болота — це надмірно зволожені ділянки земної поверхні з шаром торфу не менше 0,3 м. Вони займають 2 % усієї території суходолу нашої планети, або близько 5 млн км2.
Болота зосереджені переважно в Північній півкулі, насамперед на рівнинних територіях. Найбільше їх у тундрі й тайзі, а також у сельві Бразилії — у районах із надлишковим зволоженням.
В Україні більшість боліт розташовані в межах Полісся.
Болота містять до 10 % торфу. Відповідно до його товщини іноді болота поділяють на безпосередньо болота (товщина торфу понад 30 см) та заболочені землі (товщина торфу менша за 30 см). Цей поділ умовний, а більшість людей називають болотом будь-яку заболочену ділянку (мал. 58.1). Болота можуть утворюватися двома шляхами. Перший — це заростання озер, коли озеро поступово перетворюється на болото впродовж століть і тисячоліть. Цей природний процес відбувається тому, що всі рослини і тварини, які мешкають в озері, після загибелі опускаються на дно. Там мікроорганізми перетворюють ці рештки на донний мул. Із часом товщина мулу збільшується, а глибина озера відповідно зменшується. Вода краще прогрівається, що сприяє активному розвитку рослин і тварин. Отже, товщина торфових відкладень поступово збільшується (мал. 58.2).
Другий шлях — це коли болото утворюється на суходолі в пониженнях рельєфу із щільним ґрунтовим покриттям. У цих умовах життєдіяльність дерев та іншої рослинності поступово пригнічується, а мохи, які менш вибагливі до умов існування, активно розвиваються. Мохи вбирають воду та перекривають доступ кисню в ґрунт. Це призводить до загибелі дерев, які відігравали

Мал. 58.2. Перетворення озера на болото
роль насоса й перекачували воду з ґрунту в повітря. У результаті відбувається активне заболочування території та формування болота.


Часто діяльність людини, наприклад будівництво греблі, сприяє утворенню боліт. Також це відбувається через греблі, зведені бобрами (мал. 58.3).
Типи боліт

Болота поділяють на низинні, верхові та перехідні.
Низинні болота розташовані в долинах річок, на берегах озер, тобто переважно у зниженнях рельєфу. Вони живляться підземними водами (мал. 58.4а).
Утім, не завжди болота — це низовини, заповнені водою. Коли болото, розташоване на вододілі чи піщаній терасі річки, розвивається, залишки рослин поступово відкладаються на його дні та формують «купол» верхового болота (мал. 58.4б ). Висота такого купола щодо нижньої частини болота може сягати 6–8 м. Верхові болота живляться переважно атмосферними опадами.
Перехідні, або змішані, болота поєднують ознаки низинних і верхових боліт. Вони утворюються в процесі перетворення низинного болота на верхове. Перехідні болота живляться ґрунтовими водами.
Мал. 58.3. Гребля на озері, збудована бобрами
Мал. 58.4. Верхові та низинні болота
Болота підтримують склад атмосферного повітря, збільшують його вологість і змінюють температуру. Болота поглинають велику кількість
Значення боліт. Використання торфу
2. Досліджуємо Землю та життя на Землі
вуглекислого газу. А кисню за рік болота виділяють більше, ніж така сама площа лісу. У районі боліт температура повітря завжди холодніша, ніж навколо. Пил має властивість у безвітряну погоду рухатися до областей
Мал. 58.5. Подрібнений торф на острові Айлей, Шотландія
і
1. Де і як утворюються болота?
2. Поясніть, чим верхові болота відрізняються від низинних.
3. Уважають, що за рік 1 га болота поглинає з повітря
550–1800 кг вуглекислого газу та виділяє 260–700 кг кисню. Площа

боліт Біле озеро і Коза-Березина, розташованих у Рівненській
області, становить 8036,5 га.
Обчисліть, скільки вуглекислого
газу поглинають, а скільки кисню
виділяють за рік ці болота.
4. Які наслідки накопичення
недорозкладених рослинних
залишків трав, мохів і дерев у болотах?
5. Як ви вважаєте, які наслідки може мати осушення боліт?
Відповідь аргументуйте.
6. Чи ефективно, на ваш погляд, видобувати торф на Поліссі?
нижчою температурою. Отже, він рухається в напрямку до боліт, де й поглинається ними. За рік 1 га болота поглинає 3 т пилу! Крім пилу, торф’яні родовища поглинають різні токсичні речовини.
Багато річок починаються у верхових болотах. У разі осушення боліт ці річки позбудуться живлення. Також у болотах відбувається процес відстоювання й очищення води.
Люди з давніх-давен використовують торф, який видобувають у болотах. Торф — цінна корисна копалина, утворена впродовж тисяч років з решток відмерлих рослин (трав, мохів, дерев), яку використовують як паливо, добрива, сировину для хімічної промисловості (мал. 58.5).
Ключова ідея

Болото — це надмірно зволожена ділянка земної поверхні. Болота відіграють важливу роль в гідрологічному балансі планети, підтримують склад атмосферного повітря, поглинають тонни пилу. Торф’яні болота є джерелом видобутку торфу.
Дізнайтеся більше
Тетяна Андрієнко — українська вчена в галузі ботаніки, фахівчиня з охорони рослинного світу, зокрема боліт. Рідкісні гірські болота Українських Карпат, які описала Тетяна Леонідівна, були взяті під державну охорону в межах міжнародної програми «Телма».
На території національного парку «Зачарований край» розташоване Чорне Багно — найбільше збережене болото у Вулканічних Карпатах України. Площа болота становить 15 га, а товщина торфових покладів — до 6 м.




Територія боліт характеризується підвищеною вологістю. Це створює привабливі умови для життя прісноводних рослин і тварин, зокрема амфібій і плазунів.
На торф’яних болотах сфагновий мох щорічно наростає на кілька міліметрів, тому рівень усього болота поступово підвищується (мал. 59.1).
Рослини змушені до цього пристосовуватися. Так, у чагарників вище по стовбуру відростає додаткове коріння, а насіння трав потрапляє на поверхню мохової подушки за рахунок активного росту рослини в цей період.
Ґрунтова
перебуває під шаром торфу. А оскільки мохи, як губки, всмоктують атмосферну вологу, рослини змушені поглинати воду з мохової подушки. Саме тому ці болота вологі лише в дощову погоду, а в посуху — висихають.
Основою однієї з класифікацій боліт є рослинний покрив.
Для лісових і трав’яних боліт типовими рослинами є вільха, осика, ряска, біле латаття і глечики жовті, очерети, аїр болотний (лепеха), рогіз, осока звичайна, пухівки, жовтець, півники, шабельник, водяний перець тощо (мал. 59.2).
Чому змінюється рослинність у процесі перетворення озера на болото?
y Що таке болото?
y Як утворюються болота?
y Яку роль в утворенні боліт відіграють рослини?
y Як утворюється торф?
загадка
Мох сфагнум — дивовижна рослина з унікальними властивостями. Під час війни його застосовували як перев’язувальний матеріал замість вати. Які саме властивості сфагнуму при цьому використовувалися?
вода часто недоступна рослинам, адже
КласифікаціяМал. 59.2. Лепеха звичайна Мал. 59.1. Збирання сфагнуму
Мал. 59.4. Трясовина здатна засмоктувати живих істот


Мал. 59.5. Водне середовище існування


У трав’яно-мохових болотах наявний шар торфу, а в рослинному покриві переважають звичайні види болотного різнотрав’я. Крім моху, як основної рослини, на їх території можна побачити чорницю, брусницю, журавлину (мал. 59.3 на с. 157).
Уся ця рослинність поступово насувається на водойму і зменшує або зовсім закриває водну поверхню. Коли болота дуже заростають, коло берегів утворюється такий собі «плавучий килим», а в центрі — плавучі острівці, які поступово зростаються. У цьому килимі переплітаються кореневища й дернини водних рослин. Із часом його потужність збільшується. Так утворюються небезпечні хиткі болота — трясовини (мал. 59.4).
Тваринний світ боліт дуже різноманітний — від одноклітинних до багатоклітинних організмів. І всі вони взаємодіють між собою (мал. 59.5).
Мал. 59.6. Тварини боліт: а — водяна курочка; б — куріпка біла; в — ондатра
Земноводні, для яких тут справжній «обітований край», улітку ховаються в затінку і полюють на дрібних комах — основою їхнього живлення. Разом із цим вони мають бути насторожі, адже самі можуть стати здобиччю птахів та плазунів, які мешкають поруч. Тому земноводні мають захисне забарвлення, що зливається з рослинністю болота.

Досліджуємо Землю та життя на Землі
а б в г
Мал. 59.7. Тварини боліт: а — ласка; б — в’юн; в — гадюка звичайна; г — болотна європейська черепаха
Між очеретом і сушею зводять гнізда різноманітні птахи: водяна курочка, очеретянка, куріпка біла, глухарі, гуси, качки, чаплі, журавлі тощо (мал. 59.6).
У густих заростях болота шукають їжу й укриття, піклуються про своїх дитинчат ссавці: ондатри, видри, ласки тощо. Серед риб переважають карасі, соми, щуки, в’юни.
У болотних кущах можна зустріти й небезпечну тварину — гадюку звичайну (ґалицю).
Є також інші плазуни, зокрема болотна європейська черепаха, яка є санітаркою болота — вона знищує личинок комарів і хворих риб.
Ключова ідея




Підвищена вологість на болотах забезпечує привабливі
умови для життя прісноводних тварин, амфібій і плазунів. Відповідно до переважаючого типу рослинності болота поділяють на лісові, трав’яні та трав’яно-мохові.
1. Для болота характерне невелике видове різноманіття рослин. Із чим це пов’язано?
2. Опишіть рослинний світ лісових, трав’яних і трав’яномохових боліт. Чим він відрізняється?
3. За допомогою додаткових джерел інформації підготуйте повідомлення про лікарські рослини та ягоди, які ростуть на болотах.
4. Трясовина — небезпечна ділянка болота, тому важливо дотримуватися певних правил поводження на болоті. Підготуйте відповідну пам’ятку для туристів.
5. Як осушення боліт збільшує небезпеку пожеж, що можуть тривати роками?
6. Створіть лепбук «Життя болота влітку і взимку».

Сьогодні болота — це найбільш змінені людиною ділянки природи, зокрема і в Україні. Тому велике значення приділяють їх збереженню та відновленню. Так, у Поліському природному заповіднику площа боліт і заболочених лісів становить близько 5 тис. га. А між Києвом та Ірпінем у долині
річки Любка є ботанічна пам’ятка природи державного значення — Романівське болото, одне з небагатьох боліт Київської області.
Рододендрон жовтий (азалія) у Поліському природному
заповіднику
Дізнайтеся більше
y Чому лід утворюється лише на поверхні морів та океанів, а вони не промерзають до самого дна?
y Чи може весь лід на Землі розтанути?
y Яка особливість води забезпечує її колообіг у природі?
y Чому полярні райони й екватор отримують неоднакову кількість тепла?
y Як змінюється температура повітря з підняттям угору?
загадка
2014 року канадський альпініст Вілл Гедд піднявся на найвищу точку Африки — гору Кіліманджаро. Згодом він згадував, що для нього словосполучення «лід в Африці» раніше звучало так само неймовірно, як «пальми на Північному полюсі». Усе змінилося, коли він побачив африканський лід. Чому в жаркій Африці в горах утворилися льодовики?

Сніги та лід покривають великі площі суходолу і моря. У найвищих шарах атмосфери хмари складаються з льоду. Сніг також складається з кристаликів льоду — сніжинок.
Лід — це твердий агрегатний стан води. У полярних районах і високо в горах сніг і лід покривають поверхню впродовж усього року, а в інших регіонах нашої планети процеси замерзання і танення льоду чергуються залежно від пори року. Особливості рельєфу місцевості та кліматичних умов спричиняють різні форми утворення льоду. Наприклад, якщо вода в річці дуже переохолоджена, процес її замерзання йде швидко, і річка може промерзнути до самого дна (мал. 60.1).
Як і в прісних водоймах, у морях кристалізація льоду відбувається на поверхні води. Товщина «молодого» морського льоду може сягати 2 м, а в полярних районах, де влітку лід не встигає розтанути, його потужність рік у рік зростає. Північний Льодовитий океан покритий шаром льоду завтовшки в декілька метрів, який постійно дрейфує. Цей процес залежить від морських течій і вітрів (мал. 60.2).
Трапляється лід і під землею: у деяких регіонах планети утворилися величезні масиви багаторічної мерзлоти. У полярних районах земля
Видавництво «Ранок»
Досліджуємо Землю та життя на Землі
Мал. 60.2. На Землі морський лід займає площу 25 млн км2

промерзає настільки глибоко, що влітку встигають розтанути лише верхні шари ґрунту. Потужні шари багаторічної мерзлоти можуть сягати понад 1000 м (мал. 60.3).



Основна маса льоду на землі зосереджена
в льодовиках. Вони покривають 16,2 млн км2 поверхні Землі. У льодовиках зберігається 80 % усієї прісної води.
Льодовик — це природне скупчення льоду на земній поверхні, що утворюється в результаті нагромадження й ущільнення снігу вище від снігової лінії. Снігова лінія — це межа, вище від якої сніг зберігається впродовж року. Висота снігової лінії залежить від географічної широти місцевості. Зі збільшенням географічної широти висота снігової лінії зменшується (мал. 60.4).
Снігова лінія в районі екватора проходить на висоті близько 4500 м, у горах помірних широт — на висоті 3000 м, а в полярних широтах — на рівні моря. Тому на пласких рівнинах полярних областей виникають покривні льодовики, а гірські льодовики утворилися на найвищих гірських вершинах у низьких широтах.
Близько 98,5 % усіх льодовиків Землі становлять саме покривні льодовики. Вони утворилися
в Антарктиді (85,6 % загальної площі зледеніння)
та на острові Гренландія (11,0 %). Їхня товщина
подекуди перевищує 2000 м. Покривний льодовик сповзає з материка чи острова в прибережну частину океану й утворює айсберги плавучі крижані гори. Більша частина айсбергів перебуває під водою (мал. 60.5).
Мал. 60.3. Багаторічна мерзлота
Мал. 60.4. Снігова лінія на горі Кіліманджаро проходить на висоті 3170 м
Мал. 60.5. Висота айсберга
водою може сягати 100 м,
— сотень кілометрів

1. Де можна зустріти природний лід?
2. Поясніть, як утворюється багаторічна мерзлота.
3. На якій висоті в горах проходить снігова лінія, якщо біля підніжжя гори температура повітря становить +18 °С?
4. Чому площа льоду на нашій планеті майже в 30 разів більша, ніж площа всіх поверхневих вод суходолу?
5. Гірські льодовики Кавказу та Альп просуваються зі швидкістю від 10 до 150 м за рік. На Памірі швидкість руху доходить
до 1500 м за рік. Обчисліть, на яку відстань просувається
льодовик у Памірі за день.
6. Чи згодні ви, що танення

льодовиків становить загрозу для Землі? Поясніть чому.
Мал. 60.6. Морена — льодовикові відклади (валуни, щебінь)
Джерелом живлення гірських льодовиків є тверді атмосферні опади, що нагромаджуються та ущільнюються, перетворюючись на лід вище снігової лінії. Завдяки пластичності льоду та під дією своєї маси гірський льодовик сповзає вниз долиною. Рухаючись, він руйнує та поглиблює долину, а продукти руйнування несе вниз (мал. 60.6).
Найдовший льодовик на нашій планеті — це льодовик
становить майже 400 км. А льодовик Федченка в горах Паміру — найдовший у Євразії. Його довжина дорівнює 77 км, причому початок перебуває на висоті 6280 м, а нижній край — на висоті 2900 м.
Ключова ідея
Лід у природі трапляється не лише на поверхні Землі, а й в атмосфері та земній корі. У результаті нагромадження й ущільнення снігу вище від снігової лінії утворюються льодовики, у яких зосереджена величезна кількість прісної води. Розрізняють гірські й покривні льодовики. Для північних районів Землі характерна багаторічна мерзлота.
Дізнайтеся більше «Льодовиковим питанням» займаються науковці-гляціологи. Вони вивчають особливості льодовиків і процеси, які в них відбуваються.
Микола Дмитрієв — український геолог і гляціолог. Докладно описав льодовикові та водно-льодовикові форми рельєфу України.
Ламберта в Антарктиді. Його довжина
Підземними називають води, що перебувають у верхній частині земної кори в порах, порожнинах і тріщинах. На підземні води припадає близько 2 % обсягу води на планеті. Проте, за припущеннями гідрогеологів, у глибинних шарах Землі можуть бути колосальні запаси підземних вод, родовища яких ще належить відкрити.
Невелика частка підземних вод утворюється
в порах гірських порід шляхом конденсації з повітря за зниження його температури. Також поповнення підземних вод може відбуватися завдяки
водяній парі з глибинних шарів Землі, наприклад
під час виверження вулканів. Проте більшість підземних вод утворюється шляхом просочування
y Звідки до наших осель потрапляє питна вода?

y Чому вода в деяких джерелах має лікувальні властивості?
y Який відсоток становить прісна вода в гідросфері Землі?
y Пригадайте, як відбувається живлення річок, озер і боліт.
в землю атмосферних опадів і талих вод. Такі гірські породи, як вапняк, пісок, галька, гравій, добре пропускають воду. Їх називають водопроникними. А такі гірські породи, як граніт, глина, мергель тощо, воду затримують. Їх
водотривкими. Коли вода потрапляє на водотривкий шар, вона затримується над ним і нагромаджується у водопроникному шарі (мал. 61.1). Шар водопроникних гірських порід, що вміщує воду та залягає над водотривким шаром, називають водоносним горизонтом.
Класифікація підземних вод
Класифікація підземних вод залежить від ґрунтів, що складають земну кору, їхньої вологоємності та глибини залягання. Верховодка залягає найближче до земної поверхні. Ґрунтові води залягають у першому від поверхні водоносному шарі, живляться атмосферними опадами. Міжпластові води залягають у водоносному шарі між двома водотривкими шарами. Живляться водами, що потрапляють в цей шар у місці, де він виходить на поверхню.
Мал. 61.1. Утворення підземних вод
«Ранок»
Розділ 2. Досліджуємо Землю та життя на Землі
Міжпластові підземні води, що перебувають
під напором, називають артезіанськими водами.
Цей напір проявляє себе в підйомі рівня води під час буріння свердловини. За сприятливих умов такі свердловини можуть фонтанувати.
Мал. 61.2. Геотермальна електростанція на півострові
Рейк’янес в Ісландії
Вода активно поглинає речовини, що містяться у складі гірських порід, і насичується солями та мінералами. Залежно від кількості розчинених у воді речовин розрізняють прісну, солонувату, солону воду та розсоли. Водоносні горизонти з прісною водою вважають одним із найважливіших ресурсів на Землі.
За температурою підземні води поділяють на чотири типи: холодні (нижче 20 °С), теплі (20–37 °С), гарячі (37–42 °С), дуже гарячі (терми) (понад 42 °C). Гарячу воду можна використовувати для обігріву приміщень. Для промислового отримання електроенергії з гарячих термальних підземних вод будують геотермальні електростанції (мал. 61.2).
Підземні води з розчиненими в них солями називають мінеральними.
Мал. 61.3. Використання води для лікування
1. Назвіть види підземних вод.
2. Поясніть, як утворюються артезіанські води.


3. Кому, на ваш погляд, будуть важливі знання про хімічний склад мінеральних вод?
4. Від чого залежить рівень верховодки та ґрунтових вод?
5. Чому глибина колодязів у різних місцях різна?
6. Проведіть опитування серед своїх знайомих та з’ясуйте, які мінеральні води вони знають або вживають. Складіть перелік названих мінеральних вод за популярністю.
На території України виявлено близько 500 джерел різних мінеральних вод.
Підземні води, які мають певні лікувальні властивості, називають бальнеологічними. В Україні найвідомішими бальнеологічними курортами є Трускавець, Східниця, Моршин, Хмільник, Миргород, Куяльник, Поляна, Берегове тощо. З лікувальною метою на цих курортах води використовують не тільки внутрішньо, а також і зовнішньо (мал. 61.3).
Ключова ідея
Підземні води, які перебувають у верхній частині земної кори, утворюються переважно внаслідок просочування крізь гірські породи атмосферних опадів. Вода — універсальний розчинник, тому підземні води розчиняють гірські породи та насичуються різними солями. Такі води називають мінеральними.
Лікувальні джерела
До складу гідросфери, окрім природних водних об’єктів, належать також і штучні водойми. Штучні водойми — це водойми, створені людиною.

Основні види штучних водойм — це канали, водосховища, ставки та штучні озера.
Перші штучні водойми почали будувати ще у Стародавньому Єгипті. У долині річки Ніл споруджували водосховища для освоєння родючих земель. А канал фараонів, побудований ще до нашої ери, з’єднав Ніл і Червоне море.
Канал — це лінійно видовжений штучний водотік, що з’єднує між собою річки, озера, моря тощо. Люди створюють канали для судноплавства, зрошування або осушування земель. Найвідомішими є Суецький канал, який від 1869 року з’єднує Середземне та Червоне моря, і Панамський канал, який 1920 року з’єднав Тихий та Атлантичний океани. Канали суттєво скорочують шлях, що дозволяє суднам швидко переходити з однієї водойми до іншої (мал. 62.1).
Прикладом зрошувального каналу є Каховський 130-кілометровий канал. Він споруджений для зрошування сільськогосподарських земель і забезпечення водою населених пунктів Запорізької та Херсонської областей України. Він починається в Каховському водосховищі, яке ще називають Каховським морем.
Водосховище — штучна водойма, створена в долинах річок для накопичення й зберігання води, регулювання річкового стоку тощо.
Іноді на річці зводять не одну греблю, а декілька, зокрема для ГЕС. І тоді утворюється каскад водосховищ, як, наприклад, на Дніпрі: Київське, Канівське, Кременчуцьке, Кам’янське, Дніпровське, Каховське (мал. 62.2 на с. 166).
Ставок відносно невелика штучна водойма. Їх створюють у руслах струмків, ярах або
y Для чого люди будують канали?
y Чим ставок відрізняється від озера, а канал — від річки?
y Назвіть складові гідросфери. y Що таке річка?
y Що таке озеро?
y До яких наслідків може призвести будівництво
дамби чи загати на річці?
загадка
Людина намагається підкорити та вдосконалити природу. Вона створює не лише автомобілі, морські кораблі та літаки, а навіть моря. Чи є такі моря в Україні?
Мал. 62.1. Панамський канал, створений для покращення судноплавства між океанами
майбутньогопідручникаВидавництво
Ранок
Мал. 62.2. Гребля Дніпровської ГЕС
Мал. 62.3. Ставки в рибному господарстві
1. Назвіть основні види штучних водойм.
2. Поясніть, з якою метою будують водосховища на річках.

3. Довжина Панамського каналу
81,6 км. Завдяки йому морський шлях із Нью-Йорка до СанФранциско суттєво скоротився. За допомогою будь-якої карти (Додаток 1, карти Google тощо) обчисліть, на скільки кілометрів скоротився цей шлях.
4. У чому схожість та в чому полягають відмінності між водосховищем та озером?
5. Сформулюйте правила безпечного перебування на березі водойми у вигляді буклета для відпочиваючих.
6. Проведіть візуальне спостереження найближчого до вас об’єкта: моря, річки, озера, штучної водойми, болота, джерела, та зазначте можливі джерела його забруднення.
викопаних заглибленнях для зберігання води з метою водопостачання, зрошення, розведення риби й водоплавних птахів тощо (мал. 62.3). Ставки створювали в Україні з давніх-давен. Ось як описує ставок видатний український письменник Іван Нечуй-Левицький: «Там десь на широкій долині розлився довгий став; кругом ставка над самим берегом біліє смуга з вишневих та черешневих садків. Ставок блищить на сонці, неначе дзеркало, вправлене в срібні рами, закутані дорогою білою, прозорою тканиною». У зонах відпочинку створюють штучні озера. Вони є місцями купання та проведення спортивних заходів. Також невеликі штучні озера будують на присадибних ділянках (мал. 63.4).

стану водних

Будь-які водні об’єкти потребують контролю за їх екологічним станом. Для цього проводять різноманітні дослідження. Наявність у воді забруднювачів виявляють із застосуванням хімічних, фізико-хімічних і фізичних методів Методи санітарно-бактеріологічного аналізу води використовують для визначення загальної кількості мікроорганізмів у воді, зокрема бактерій групи кишкових паличок.
Мал. 62.4. Невеличке штучне озеро Ключова ідея
До штучних водойм, створених людиною для судноплавства, зрошування, зберігання води, розведення риби тощо, належать канали, водосховища й ставки. З метою контролю за станом водних об’єктів проводять різноманітні хімічні, фізичні та медико-біологічні дослідження.
У 5 класі ми розглядали середовища існування живих організмів. Це та частина природи, яка їх оточує та взаємодіє з ними. Розрізняють наземноповітряне, ґрунтове, водне та організмове середовища існування. Усі живі об’єкти природи, що мешкають у цих чотирьох середовищах, постійно взаємодіють одне з одним (мал. 63.1).
Як наслідок, між тваринами, рослинами, грибами та бактеріями утворюються численні зв’язки та взаємовідносини. Сукупність живих об’єктів і тієї частини речовини планети, що перебуває в безперервному обміні з цими організмами, називають біосферою.
Межі
Маса біосфери становить 0,05 % маси земної кулі.
Межі біосфери визначаються умовами, необхідними для життя: наявністю води, мінеральних речовин, кисню, вуглекислого газу, сприятливого температурного режиму, ступенем солоності води у водних екосистемах, рівнем радіації. Усі ці умови перетинаються та поєднуються у місцях контакту трьох геологічних оболонок Землі — атмосфери, літосфери й гідросфери.
y Чи могла би біосфера існувати без людини?
y Яку роль може відіграти Україна в підтриманні
біорізноманіття планети?
y Які основні рівні організації живих систем?
y Що таке «біорізноманіття»?
y Які існують середовища існування?

загадка
Англійський натураліст Едвард Форбс 1841 року за результатами своїх спостережень у Середземному морі заявив, що глибше 540 м життя в океанічних водах неможливе. Чи правий був дослідник?

Видавництво
Розділ 2. Досліджуємо Землю та життя на Землі

1. Назвіть умови, необхідні для існування біологічних систем.
2. На конкретних прикладах
поясніть, як компоненти біосфери взаємодіють між собою.
3. У чому схожість / відмінність понять «біосфера» та «ноосфера»?
4. Як екологічні проблеми окремого району Землі можуть вплинути на екологічний стан всієї планети?
5. Чому, на вашу думку, найбільші тварини існують у воді, а не на суші? Чи можуть бути наземні тварини розміром із кита?
6. За допомогою додаткових джерел інформації підготуйте повідомлення про міжнародні природоохоронні організації, що займаються проблемами охорони біосфери.
Отже, біосфера охоплює нижню частину атмосфери — тропосферу (від 8 км у висоту біля полюсів до 22 км у висоту біля екватора), верхню частину літосфери (3–4 км у глибину) і всю гідросферу (до 11 км у глибину).
Більшість організмів на Землі зосереджена в межах тонкого прошарку, де взаємодіють повітря, води та гірські породи. Це так звана «плівка життя». Людина — невід’ємна частина біосфери.
Як захищають біосферу?
Сьогодні людству необхідно зберегти біорізноманіття сучасної біосфери, оскільки лише в цьому випадку можливе подальше співіснування природи і людського суспільства. Для збереження біологічних систем багато країн світу, зокрема Україна, вживають заходи зі збереження біорізноманіття нашої планети на різних рівнях (науковому, законодавчому, господарському тощо). Адже для збереження біосфери необхідна міжнародна співпраця. 1970 року була прийнята довгострокова програма «Людина і біосфера», а 1979 року заснована «Програма ООН з навколишнього середовища» (ЮНЕП). Також створені різноманітні організації, як, наприклад, Міжнародний союз охорони природи (МСОП) для збереження природних ресурсів.
Ключова ідея Біосфера — оболонка Землі, що містить усю сукупність живих організмів і ту частину речовини планети, що перебуває в безперервному обміні з цими організмами. Межі біосфери визначаються умовами, необхідними для життя.
Дізнайтеся більше Сучасне вчення про біосферу створене Володимиром Вернадським. Відповідно до нього біосфера — це не лише простір життя, а й інші структури Землі, генетично пов’язані з живою речовиною. У першій половині ХХ століття він спрогнозував, що біосфера розвинеться в ноосферу (від грец. ноос — розум). Ноосфера — це певний стан біосфери, де розумова діяльність людини є визначальним елементом її розвитку
Видавництво «Ранок»
Паразитичний спосіб життя притаманний деяким одноклітинним організмам. Ці на перший погляд безвинні істоти поширюють інфекційні захворювання, що зазвичай перебігають у тяжкій формі. Паразитичні протисти можуть мешкати
в порожнинах травної системи тварин, у м’яких тканинах, у крові або навіть усередині клітин багатоклітинного організму (хазяїна).
Наприклад, дизентерійна амеба є збудником тяжкого захворювання. Заразитися цією недугою можна через цисти (захисна оболонка). Вони можуть потрапити до організму через їжу, воду, предмети побуту, гроші тощо).
Таким чином одні організми можуть використовувати як середовище існування організми інших видів.
Такими «квартирантами» можуть бути прокаріоти, одноклітинні еукаріоти або ж багатоклітинні організми різних груп. Приклади симбіозу (взаємодія та співіснування організмів без шкоди одне одному) можуть траплятися навіть в одноклітинних організмів.
Наявністю симбіотичних водоростей зумовлене яскраве забарвлення коралів (мал. 64.1).
На тваринах також можуть оселятися водорості, приміром на шерсті лінивців (мал. 64.2).
Хто такі паразити?
Світ паразитів з’явився відтоді, коли виникло життя на Землі і коли з’явилися комфортні умови для деяких організмів жити в інших організмах. Разом зі світом паразитів у біосфері виник особливий тип взаємовідносин «паразит—хазяїн», який називають паразитизмом. Науку, що вивчає паразитичні організми, називають паразитологією. За місцем розташування на / у тілі хазяїна тварин-паразитів поділяють на чотири основні групи. Розгляньмо їх на малюнках 64.3–64.7.
y Чому треба мити руки?
y Чи є в організмі людини бактерії?
y Чому домашні улюбленці час від часу чухмаряться?


Що таке життєвий цикл?
Мал. 64.1. У разі загибелі водоростей тіло корала стає сірим, а через нестачу поживних сполук він гине
Мал. 64.2. Зеленуватий відтінок забарвлення шерсті лінивців допомагає їм маскуватися
серед рослин
Мал. 64.3. а — екзопаразити; б — шкірні паразити; в — ендопаразити
загадка Український майстер мікромініатюр Микола Сядристий
підкорив світ унікальним мистецтвом. Йому вперше вдалося підкувати паразитичну комаху. Для цього він узяв звичайну блоху, обробив її спиртом і висушив, а потім спеціальним інструментом
підкував золотими підківками
дві лапки блохи. Товщина підківок — п’ять мікрон (1 мк = = 0,001 мм = 0,0001 см = = 0,000001 м), а ширина
дорівнює діаметру людської
волосини — 60 мікрон. Майже

50 років ця блоха є музейним


експонатом. Яка органічна
речовина дозволяє якнай-

довше зберегтися паразитич-



ній комасі в такому вигляді?
Дослідження. Виготовлення мила в домашніх умовах (разом із дорослими)
Для запобігання інфекційним захворюванням
необхідно дотримуватися правил особистої гігієни, зокрема слідкувати за чистотою рук. Приготуємо мило, яке використовують для миття рук. Для дослідження вам знадобиться: брусок дитячого мила, 1 столова ложка оливкової або кокосової олії, 100 г рідини (молоко, відвари м’яти чи меліси тощо), 6–7 крапель ефірного масла, 4–5 крапель барвника (за бажанням), 50 г будь-яких добавок на 100 г мила (шоколад, цукор, мед, кава, вівсянка тощо), скляна жаротривка посудина.
Під час роботи дотримуйтеся правил безпеки з нагрівними приладами та гарячими рідинами!
1. На терці натріть брусок мила. Отриману стружку перекладіть у скляну жаротривку посудину.
Видавництво
2. Поставте посудину на водяну баню. Тепло має передаватись від киплячої води до посудини. Слідкуйте за плавленням стружки.
3. Попередньо розбавте будь-який відвар молоком і додайте в посудину зі стружкою. Помірно
помішуйте, але не доводьте до кипіння.
4. Поступово додайте будь-яку добавку.
5. Коли мило повністю розплавиться, стане тягучим і без грудочок, додайте до нього олію.


6. Зніміть посудину з водяної бані та додайте ефірні масла й барвник.
1. Хто такі паразити? Яка наука вивчає ці організми?
2. Грецькою parasites означає «дармоїд». Як це узгоджується з поняттям «паразит»?
3. За можливості розгляньте під мікроскопом мікропрепарати паразитичних найпростіших. Які захворювання можуть спричинити ці організми?
7. Ретельно розмішайте отриману суміш, розлийте будь-які формочки. Залиште мило остигати на підвіконні та відчиніть вікно, щоб випарувалася волога. Ваше мило готове!
4. До інфекційного відділення прибув хворий. Він скаржився на біль у шлунку та часту діарею. За результатами лабораторного дослідження екскрементів було виявлено форми амеб. Як називається вид амеби, що спровокувала цю недугу?
Ключова ідея Організми одних видів можуть використовують в якості середовища існування організми інших видів. Таке середовище називають організмовим середовищем існування. У ньому існують зв’язки «паразит-хазяїн», які називають паразитизмом.
Дізнайтеся
У середині організму малярійний плазмодій утворює спеціалізований комплекс органел, завдяки яким потрапляє в еритроцити людини та спричиняє серйозне захворювання — малярію. Токсини, які виділяє малярійний плазмодій, руйнують еритроцити, тому хворого починає лихоманити, підвищується температура. Людина для малярійного плазмодія є проміжним хазяї-
5. Уявіть, що ви паразитолог / паразитологиня. За допомогою додаткових джерел інформації складіть перелік профілактичних заходів, які дозволять суттєво знизити ризик захворювання інфекційними захворюваннями.
6. Створіть лепбук про взаємовигідні взаємодії організмів хазяїна та симбіонта.
ном, а от основним хазяїном паразита є переносник збудника малярії — самка комара роду Anopheles. Заразитися малярією можна й під час переливання крові. Лікування цього захворювання відбувається за допомогою спеціальних протималярійних препаратів під наглядом медичного персоналу.
Видавництво
Завдяки чому різні види організмів, які мають різні потреби, можуть існувати як одна біологічна система?
y Що означає слово «система»?
y Що таке біорізноманіття?
y Що вивчає наука екологія?
Термін «екосистема» уперше був запропонований англійським екологом Артуром Тенслі 1935 року Він уважав, що організми не можна відокремлювати від середовища існування, з яким вони утворюють єдину фізичну систему.
Екосистема (екологічна система ) — біологічна система, що складається з усіх організмів і фізичного середовища, з яким вони взаємодіють, зокрема здійснюють обмін речовинами та енергією.
Екосистеми мають різний ступінь складності, різні розміри. Так, море з його різноманіттям водоростей, риб, молюсків, ракоподібних — це велика макроекосистема. Болото з водними та навколоводними організмами є мезоекосистемою середнього розміру. А трухлявий пеньок у лісі з грибами, бактеріями, безхребетними, які його населяють, є мікроекосистемою невеликого розміру (мал. 65.1) Окрім природних екосистем є штучні екосистеми, створені людиною для задоволення своїх потреб. Це — поселення, сільські й міські двори, штучні водойми, сади, парки, городи тощо. Акваріум із рибами та водоростями або тераріум — це також штучні екосистеми (мал. 65.2).


В екосистемі організми різних видів виконують різні функції, завдяки яким здійснюється колообіг речовин. Залежно від ролі, яку організми відіграють у колообігу, їх відносять до різних функціональних блоків (груп): продуцентів, консументів та редуцентів.
Мал. 65.2.
екосистема «Ліс у банці»
Продуценти (від лат. producens — ті, що створюють) —це автотрофні організми-виробники. Вони синтезують органічну речовину з мінеральних речовин із використанням сонячної енергії або енергії хімічних реакцій. Це всі зелені рослини, водорості, лишайники, бактерії тощо.
Мал. 65.3. Ланцюг живлення
Консументи (від лат. consum — споживаю) — це гетеротрофні організми-споживачі. Вони споживають живу органічну речовину і передають енергію, що міститься в ній, через ланцюг живлення. Ланцюги живлення — це низки взаємопов’язаних видів, у яких кожний попередній є об’єктом живлення наступного (мал. 65.3).
Редуценти (від лат. reducens — ті, що повертають) — це гетеротрофні організми-руйнівники. Вони розкладають органічні речовини до мінеральних речовин. Це — гриби, ґрунтові бактерії тощо. Мінеральні речовини знову накопичуються в ґрунті й поглинаються продуцентами. Так відбувається колообіг речовин у природі.
ляються не повсюдно, а в місцях, де для їх існування є всі необхідні умови.
У природі на організм діє не один, а декілька екологічних чинників. Але критичні зміни хоча б одного з них, попри оптимальний вплив інших факторів, може призвести до загибелі організму.
Ключова ідея


Екосистема — одне з основних понять екології, яка вивчає закономірності відносин між організмами та довкіллям.
Сукупність зовнішніх факторів, що впливають
на організм людини в процесі роботи, називають виробничими факторами. До них відносять
температуру приміщення, вібрацію, шум, випромінювання, токсичні речовини, вплив мікроорганізмів, бактерій, рослин і тварин, фізичні й нервово-психічні перевантаження тощо. Під
1. Як організми реагують на зміни середовища існування?
2. Назвіть продуцентів і консументів І–ІІІ порядків, зображених на малюнку. Поясніть свій вибір.
3. За допомогою методу Fishbone поясніть, як впливає на екосистеми (позитивно й негативно) зведення малих ГЕС на невеликих річках України. На основі отриманих результатів зробіть висновки.
4. Поясніть, яка роль редуцентів у колообігу речовин у природі. Наведіть приклад.
час роботи виробничі фактори впливають на організм людини та можуть навіть спричиняти професійні захворювання. Щоб зменшити шкідливий вплив виробничих факторів на організм, розробляють спеціальні правила техніки безпеки на виробництві, а за потреби використовують засоби індивідуального захисту та спецодяг.
y Чому існує колообіг речовин у природі?
y Що буде, якщо прибрати один із компонентів колообігу?
y Назвіть складові біосфери.
y Як відбувається колообіг води у природі?
y Які речовини беруть участь у фотосинтезі?

y Для яких процесів необхідний кисень?
y Що є джерелом енергії для тварин і людей?
загадка Однією з речовин, необхідних для життя, є вода. Але тварини вомбати її майже не п’ють. Як вона потрапляє в їх організм?
Усі процеси в біосфері пов’язані між собою. До прикладу, у колообігу води важливу роль відіграють живі організми. Вода потрібна рослинам для росту, розвитку та розмноження. У процесі життєдіяльності вони не лише всмоктують воду з ґрунту, але й випаровують її в атмосферу через стебла та листки. Наприклад, маса води, що випаровується з 1 га лісу становить 20–50 т води на добу.
Є рослини, які на 80–90 % складаються з води.
Тварини також беруть активну участь у кругообігу води. Вони споживають воду для підтримки процесів життєдіяльності та виділяють її з продуктами обміну речовин. Нестачу води тварина відчуває надзвичайно гостро: у разі втрати 20 % води у хребетних тварин настає смерть. Деякі представники тваринного світу отримують потрібну кількість води, з’їдаючи плоди, листя та стебла рослин. А для мешканців пустель такі рослини є єдиним джерелом води.
Дослідження: колообіг води у біосфері Для дослідження вам знадобляться: пластикова пляшка, ножиці, 150–200 г ґрунту, жменя дрібних камінців, клейка стрічка, 2–3 рослини невеличкого розміру. Це можуть бути попередньо пророщені паростки насіння або квасолі.
1. Візьміть пластикову пляшку й акуратно розріжте її впоперек посередині.
2. На дно пляшки насипте камінці, ґрунт і висадіть рослини.
3. Зволожте ґрунт невеликою кількістю води.
4. З’єднайте обидві частини пляшки, а місце стику щільно обклейте клейкою стрічкою.
5. Поставте конструкцію на підвіконня і спостерігайте за колообігом води.
Досліджуємо Землю та життя на Землі
6. Фіксуйте зміни в щоденнику спостережень. За тиждень зробіть висновок.
Колообіг кисню й вуглекислого газу

Колообіги вуглекислого газу й кисню в біосфері тісно пов’язані (мал. 66.1). Усі процеси в біосфері, у результаті яких виділяється вуглекислий газ, потребують кисню. Це — горіння палива в котлах і двигунах, дихання, гниття рослинних і тваринних решток. Вуглекислий газ і кисень беруть участь у таких взаємно обернених процесах, як дихання та фотосинтез: рослинам для живлення потрібен вуглекислий газ, а людям і тваринам — кисень для дихання. Уважають, що саме тому кімнатні рослини добре себе почувають у місцях масових скупчень людей: офісах, лікарнях, школах тощо.
Ключова ідея

Наша планета — це єдина величезна система, у якій усе
поєднано між собою, зокрема через процеси колообігу води, кисню та вуглекислого газу. А деякі процеси обміну
речовин у біосфері є взаємно оберненими, приміром фотосинтез і дихання.
Дізнайтеся
Щоб виробити 10 кг біомаси, більшість рослин споживають близько 1000 л води. Вона проходить через коріння, і майже 991 літр згодом випаровується з поверхні листків. Це необхідно
Мал. 66.1. Колообіг вуглекислого газу
1. Які процеси не можуть відбуватися без кисню?
2. Звідки беруть воду тварини, що мешкають у пустелі?
3. Визначте, у результаті яких процесів утворюється вуглекислий газ.
4. У чому схожість / відмінність між процесами дихання та фотосинтезу?
5. Уявіть, що в поході у вас виникла проблема з питною водою. Як можна очистити дощову воду, використовуючи методи фільтрації, відстоювання тощо?
6. За допомогою циклічної діаграми поясніть, як відбувається колообіг води, вуглекислого газу та кисню в біосфері. За допомогою підручних матеріалів візуалізуйте ці процеси в техніці «аплікація».
рослині насамперед для охолодження. А 7,5 л води залишається в тканинах рослин у вигляді хімічно вільної води. І лише 1,5 л використовується рослинами в процесі фотосинтезу.
більше
Чому для вирощування різних культур підходять різні типи ґрунтів?
• Чи є вода в земній корі? • Як відбувається колообіг вуглекислого газу й кисню в біосфері? • Що таке вивітрювання?
До ХІХ століття вивченням ґрунтів займалися виключно геологічна й агрономічна спільноти. У геології ґрунт розглядали як гірську породу та поділяли його на пісок, глину, суглинок тощо. В агрономії за ґрунт вважали верхній 30–40-сантиметровий шар землі, а глибше «не заглядали». Сьогодні ґрунтознавство посідає важливе місце в системі наук про біосферу, адже ґрунт — необхідна умова існування життя на Землі й водночас її наслідок. Він сформувався в результаті тривалої взаємодії клімату, рельєфу, гірських порід і живих організмів. Ґрунт це верхній пухкий родючий шар Землі, у якому ростуть рослини, мешкають тварини й інші організми (мал. 67.1).
Мал. 67.1. За багато сотень років верхній шар гірських порід перетворився на ґрунт
У складі ґрунту є тверда, рідка і газоподібна частини, а також жива й органічна частини. Найважливішою складовою ґрунту є гумус. Гумус (перегній) — це органічна частина ґрунту, яка утворюється та накопичується в результаті розкладу рослинних і тваринних решток і продуктів життєдіяльності організмів.
Від кількості гумусу залежить здатність ґрунту забезпечувати рослини поживними речовинами та вологою, тобто його родючість.


Основою для формування ґрунту є гірські породи. Утворення ґрунту потребує надзвичайно багато часу: шар завтовшки 1 см формується від 100 до 200 років (мал. 67.2).
Мал. 67.2. Ґрунтові горизонти — шари ґрунтів, що виникають у процесі ґрунтоутворення
порід під впливом живих і мертвих організмів (рослин, тварин, мікроорганізмів), сонячного тепла, атмосферних опадів (клімату), рельєфу місцевості з урахуванням чинника часу. Також до чинників ґрунтоутворення додають дію ґрунтових вод і діяльність людини.

Якщо змінюються властивості хоча б однієї складової ґрунту, змінюється вся його структура, наприклад родючість. У результаті формуються різні типи ґрунтів із різними властивостями: родючістю, пористістю, здатністю утримувати вологу та повітря.
Зміни природних властивостей ґрунтів, зокрема родючості, певною мірою залежать від людини: тривале розорювання ґрунтів призводить
до зменшення їхньої родючості та ерозії.
Кожен тип ґрунту має свої різновиди залежно


від підґрунтя, клімату, рослинного покриву
й інших чинників ґрунтоутворення. В Україні виявлено 650 видів ґрунтів. Також Україна
володіє третиною світового запасу найродючіших
земель — чорноземів (мал. 67.3).
Чорноземи формуються у степах під трав’янистою рослинністю за достатньої кількості
тепла й вологи, а за нестачі вологи там утворюються каштанові ґрунти.
Підзолисті ґрунти формуються під хвойними лісами за умов великої кількості опадів. Опади промивають ґрунт, унаслідок чого під тонким шаром гумусу утворюється білий горизонт вимивання, який за кольором нагадує золу (мал. 67.4).
Бурі лісові ґрунти формуються під широколистими лісами з розвиненим трав’яним покривом. Під вологими екваторіальними лісами, де впродовж усього року високі температури повітря та велика кількість опадів, формуються червоні та жовті фералітні ґрунти (від лат. ferrum — залізо, aluminium — алюміній та грец. lithos — камінь) (мал. 67.5).
Тундрово-глейові ґрунти формуються за умов майже повної відсутності рослинного покриву та надлишку вологи. У пустелях і напівпустелях майже без опадів і рослинності розвиваються бурі пустельні ґрунти та сіроземи.
Мал. 67.3. Верхні шари чорнозему мають темний колір, якого надає перегній
Мал. 67.4. Підзолисті ґрунти
Мал. 67.5. Фералітні ґрунти містять багато заліза й алюмінію
2. Досліджуємо Землю та життя на Землі
Дослідження ґрунту
Вам знадобляться: дві коробочки для зразків, дві скляні банки, вода, лінійка.

1. Наберіть у дві коробочки ґрунт із різних ділянок (щоб він візуально відрізнявся).
2. Для більшої точності відокремте від нього великі частинки, як-от каміння та гравій.
3. Налийте трохи води до зразків ґрунту, щоб він став вологим, але не мокрим.
4. Зробіть кульки з ґрунту, підкиньте їх приблизно на пів метра вгору та зловіть. Якщо кулька розсипалася — ґрунт занадто піщаний, а якщо вона залишилася ціла — ґрунт містить багато глини.
1. Як утворюється ґрунт?
2. Схарактеризуйте схему
утворення гумусу. 3. Поясніть вираз «Ґрунт — екологічна система, у якій усі елементи взаємопов’язані».
4. Яка діяльність людини може вплинути на ґрунт? Чи може деградація ґрунтів через негативний вплив призвести до голоду на планеті?
5. За допомогою карти ґрунтів з’ясуйте, на якому материку ґрунти розподіляються чітко в широтному напрямку.
6. Як властивості ґрунту залежать від кожного з чинників ґрунтоутворення?
5. Насипте по жмені ґрунту в скляні банки та залийте водою. Подивіться, чи буде виходити з ґрунту повітря.
6. Добре струсіть банки. Залиште відстоюватися (глина може осідати кілька днів).
7. За певний час утворяться шари різних видів ґрунтів відповідно до їхньої маси. Виміряйте їхню товщину та обчисліть співвідношення. Послідовність шарів залежить від їхньої маси. Найважчий — пісок, він перебуватиме на дні, мул — посередині, а найлегша глина буде зверху. 8. Зробіть висновок щодо властивостей зразків ґрунту.
Ключова ідея
Ґрунт — верхній пухкий родючий шар Землі. Його родючість залежить від кількості в ньому гумусу. Розвиток ґрунту з гірських порід забезпечується мікроорганізмами та ґрунтовими тваринами під впливом клімату, рельєфу місцевості, ґрунтових вод і діяльності людини з урахування чинника часу.
Дізнайтеся більше Микола Омелянович Бекаревич (1906–1996) — видатний український ґрунтознавець. Створив наукову школу ґрунтознавців-екологів, які займалися проблемами земельних ресурсів України. Особливу увагу приділяв питанням рекультивації земель, їхнього раціонального використання та збереженню гумусового шару українських чорноземів.

Видавництво

У попередніх параграфах ви дізналися, що всі оболонки Землі постійно взаємодіють між собою. Унаслідок цієї взаємодії, а також взаємопроникнення оболонок одна в одну утворилася географічна оболонка. Географічна оболонка — це цілісна оболонка Землі, що охоплює нижні шари атмосфери, верхню частину літосфери, усю гідросферу та біосферу, і в якій зародилося та існує життя (мал. 68.1).
Визначити точну товщину географічної оболонки неможливо, адже взаємодія різних компонентів природи в різних частинах Землі неоднакова. І хоча географічна оболонка не має чітко визначених меж, науковці вважають, що вона може сягати 50–60 км.
У природі є певні закономірності розвитку географічної оболонки, зокрема зональність (широтна — у напрямку від екватора до полюсів, висотна — від підніжжя до вершини у горах).
Широтна зональність зумовлена неоднаковою кількістю тепла, яку отримує земна поверхня в напрямку від екватора до полюсів. Вона виявляється у зміні природних компонентів і природних комплексів у широтному напрямку. Висотна зональність (або висотна поясність) — зміна природних компонентів і природних комплексів із підняттям у гори, зумовлена зміною клімату з висотою.
Відмінності у співвідношенні температури повітря та кількості опадів у різних частинах Землі, неоднорідність земної поверхні визначають різноманітність рослинності, ґрунтів і тваринного світу. Відповідно до цього географічну
Чому природа нашої планети така різна?
y Назвіть складові літосфери, атмосфери, гідросфери та біосфери.
y Наведіть приклади взаємодії оболонок Землі.
y Назвіть колообіги речовин у природі.
y Що таке ритмічність?
загадка
Чому широтна зональність найбільш чітко спостерігається в Африці, а в Північній Америці природні зони змінюються із заходу на схід?
Мал. 68.1. Географічна
оболонка
поясність та
Мал. 68.2. Широтна зональність і висотна поясність
оболонку поділяють на окремі природні комплекси — відносно однорідні частини поверхні Землі. Природні комплекси — це поєднання взаємопов’язаних компонентів природи на певній ділянці земної поверхні.
Найбільші зональні комплекси географічної оболонки — географічні пояси, у межах яких розміщені менші за розмірами комплекси — природні зони.
Мал. 68.3. Каскад териконів, що утворилися в результаті видобутку вугілля
Географічні пояси збігаються з кліматичними поясами та мають такі самі назви. Назви природним зонам дають за типом рослинності, що в ній переважає: зона хвойних лісів, лісостепу та степу, пустелі тощо. Зміна природних зон зумовлена змінами співвідношення тепла та вологи на певних ділянках земної поверхні в межах географічних поясів.


У разі зміни одного компонента природного
Мал. 68.4. Вирубування Карпатських лісів
комплексу відбуваються зміни всього природного комплексу в цілому. Тому сьогодні дедалі частіше з’являються антропогенні природні комплекси — території, які суттєво змінилися під впливом людини. Це розорані степи, осушені

болота, кар’єри, що залишилися після видобутку
корисних копалин, штучні водосховища та лісосмуги тощо (мал. 68.3).

Результат втручання людини в природу може мати катастрофічні наслідки. Так, останнім часом мешканці окремих районів Карпат потерпають від повеней. Річки, що виходять із берегів, руйнують усе на своєму шляху. Місцеве населення не пригадує таких повеней у минулому. Науковці з’ясували, що їх причиною є неплановане вирубування лісів у Карпатських горах (мал. 68.4).
Через це навесні сніг тане швидко й наповнює річки водою, які перетворюються на руйнівний потік. Тому будь-яке втручання людини
в природу має бути продуманим із прогнозованими наслідками.
1. Наведіть приклади, що доводять таку закономірність географічної оболонки, як циклічність.
2. Поясніть, як відбувається взаємопроникнення оболонок, у результаті чого утворилася географічна оболонка.
3. Додайте відсутні ланки в ланцюжок подій: вирубування лісу — … — ... — .... — міліють річки.
Ключова ідея
Географічна оболонка Землі охоплює нижні шари атмосфери, верхню частину літосфери, усю гідросферу та біосферу. У ній стикаються, взаємопроникають усі геосфери, утворилося й розвивається життя. Географічну оболонку поділяють на окремі природні комплекси. Зміна одного компонента природного комплексу призводить до зміни комплексу в цілому. Території, які суттєво змінилися під впливом людини, називають антропогенними природними комплексами.
4. За допомогою карти природних зон з’ясуйте, які природні зони характерні для України.
5. Що спільного між географічною оболонкою та природною зоною?
6. Які антропогенні природні комплекси є у вашому населеному пункті або поруч із ним? Чи має їх утворення негативні наслідки? Як можна було їм запобігти?
Дізнайтеся більше Степова зона — найбільша за територією природна зона України. Вона займає площу 18,4 млн га. Це становить 46,5 % площі всіх сільськогосподарських угідь, тож степи найбільше зазнали антропогенного впливу. Видатний український науковець Володимир Круть розробив принципи обробітку чорноземних ґрунтів, які дозволили мінімізувати негативний вплив від дій людини та сприяли збереженню степової зони. Був одним з організаторів Української академії аграрних наук.
Видавництво
Ранок
y Чому існує така кількість природних зон лісів: хвойні, мішані, листяні?
y Чим відрізняються тропічні
ліси від лісів помірного кліматичного поясу?
y Чому в лісах Карпат листяні породи дерев із висотою змінюються хвойними?
y Що таке природна зона
y Які породи дерев ви знаєте?
y Чим листяні дерева відрізняються від хвойних?
Умови життя в лісі
Основною складовою рослинності лісів є дерева. Також у лісах ростуть кущі та трав’янисті рослини. Особливістю пристосування рослин до умов життя в лісі є їх ярусне розташування. Кількість ярусів лісу залежить від типу рослин, які переважають. У лісах виділяють такі яруси: ярус дерев, підлісок (ярус чагарників), трав’яний (ярус трав’янистих рослин), мохово-лишайниковий ярус.
За типами рослинності виділяють різні типи лісів. Листяні ліси складаються з осик, верб, диких яблунь, дубів, кленів, берез тощо. Характерна ознака листяного лісу — скидання листя перед настанням холодної пори року. Хвойні ліси складаються з ялин, сосен, ялиці, модрини, кедрів тощо. Майже всі вони є вічнозеленими. У змішаних лісах ростуть як листяні, так і хвойні види дерев. Тропічні ліси складаються з тисяч видів трав, чагарників і дерев.
Мал. 69.1. Тіньовитривалі рослини нижнього ярусу тропічного лісу
Різні ліси мають різну кількість ярусів, що залежить від зовнішніх умов: освітленості, зволоженості ґрунтів. Крони дерев першого ярусу краще освітлені. До низу освітленість зменшується, оскільки рослини верхніх ярусів затримують частку сонячних променів. Мохи та лишайники, що займають нижній ярус, отримують найменшу кількість світла. Тому в нижньому ярусі мешкають організми, що пристосувалися до тіні (мал. 69.1).
Тварини в лісі також селяться ярусами, де знаходять собі їжу та житло житло. Також кожен із видів рослин та тварин має свій час активного життя, розмноження та полювання. Приміром, сова полює вночі на мишей, які також виходять на пошуки поживи в цей час. А лисиця полює вдень. І хоча вона не пропустить і мишу, але жаба чи їжак також можуть стати її здобиччю (мал. 69.2).
Мал. 69.2. Лисиця звичайна


Мал. 69.3. Ліси Карпат
Тож, між усіма жителями лісу існують взаємозв’язки, зумовлені ланцюгами живлення.



Природна зона мішаних лісів в Україні становить близько 20 % її території. Ліси розташовані дуже нерівномірно і сконцентровані переважно
в Поліссі та в Українських Карпатах, через це зону мішаних лісів часто називають Українським Поліссям. Здебільшого це соснові, дубово-соснові та дубово-грабові ліси (мал. 69.3). Трапляються також великі ділянки дубово-липових, вільховоберезових і ясенево-вільхових лісів. У мішаних лісах чітко прослідковується ярусність.
Види, характерні для лісів України, зв’язки між ними

У лісах України в ярусі дерев переважають сосна звичайна, ялиця і ялина європейська (смерека), дуб звичайний, граб, береза, липа, осика, клен, вільха. Другий ярус-підлісок утворюють кущі ожини, шипшини, барбарису, ліщини, малини, брусниця й чорниця. Ярус трав’янистих рослин змінюється за сезонами. Навесні це підсніжники, проліски, ряст, анемона, конвалія, фіалки, купина, сон-трава. Улітку залишаються лише вологолюбні, тіньовитривалі рослини — папороті, мохи, копитняк. Також у мішаних лісах багато грибів (білих, підберезників, підосичників, маслюків, опеньків), а на галявинах та узліссях росте звіробій, деревій, ромашка, іван-чай тощо. Восени більшість трав’янистих рослин відмирає.

Мал. 69.4. У мішаних лісах багато грибів.
Мал. 69.5. Тваринний світ лісів: деревинник дубовий, кабани
Мал. 69.6. Тваринний світ лісів: олень, сова, зозуля, білка
1. Назвіть типи лісів.
2. Чим зумовлена велика видова різноманітність мешканців дощових тропічних лісів?
3. За допомогою статистичних даних побудуйте діаграму
розміщення лісів України, якщо
40 % лісів займають Полісся, 25 % — припадає на лісостеп, 22 % — на Карпати, 10 % — площа лісів степу й лише 3 % — Крим.
4. Загальна площа лісових



ділянок становить 10,4 млн га. Обчисліть, який відсоток від площі України займають ліси.
5. Підготуйте пам’ятку для туристів, які будуть подорожувати лісами України, із попередженням про небезпечних
тварин, які мешкають у лісах.

6. За допомогою додаткових джерел інформації опишіть широколистяний ліс за планом: ярусність, життєстійкість, зімкнутість крон, приблизний вік і висота дерев.
Тваринний світ зони мішаних лісів дуже різноманітний (мал. 69.5 і 69.6). Тут можна зустріти таких великих тварин, як зубр, лось, олень благородний. Є також хижаки — вовк, лисиця, рись, тхір чорний, куниця лісова. Багато в лісах козуль, зайців, мишей. Зустрічаються дикі свині, борсуки, білки, їжаки, а біля лісових водойм — бобри, видри, ондатри, жаби, тритони. Більшість птахів у лісах прилітають навесні: солов’ї, зозулі, шпаки, мухоловки, іволги, лелеки білі, журавлі сірі, кулики тощо. Але є птахи, що зимують у лісі. Це — сова сіра, дятел великий, рябчик, глухар, тетерук тощо. Харчуються птахи комахами, що живуть під корою дерев та в лісовій підстилці, а в теплу пору року — на рослинах. Ключова ідея
На Землі існують кілька лісових природних зон: хвойних лісів (тайга), мішаних лісів, листяних лісів, тропічних лісів. Зона мішаних лісів, де переважають соснові, дубово-соснові та дубово-грабові ліси, становить близько 20 % території України. У мішаних лісах чітко прослідковується ярусність.
Володимир Бондаренко — український педагог, зоолог і поет. Своє наукове життя пов’язав із лісовою зоологією, мисливствознавством, історією лісівництва. Є автором багатьох науково-популярних творів, у яких з наукової точки зору розповідає про мешканців лісів України, їх поведінку та спосіб життя.


Природні зони степів розташовані в помірному поясі там, де випадає проміжна між пустелями й лісами кількість опадів. Це великі ділянки переважно рівнинної місцевості, що поросли трав’янистою, переважно злаковою, рослинністю. Природна зона степів в Євразії представлена типовими степами, у Північній Америці — преріями, у Південній Америці — пампасами.
Лісостеп — це перехідна природна зона помірного поясу Північної півкулі між зонами мішаних лісів та степу. На ній чергуються лісові ділянки і степові масиви.
Луки й поля. Чи є різниця?
Луки — це ділянки землі, вкриті переважно багаторічними трав’янистими рослинами, переважно злаками й осоковими. Луки формуються за умов достатнього або надмірного зволоження.
Здавна людство використовує луки як пасовища для худоби та для сіножаті (мал. 70.1).
За розташуванням луки поділяють на материкові, заплавні та гірські.
Перші поля були створені людиною, коли на місці випаленого лісу почали висаджувати злаки. Отже, поле — це штучно створена ділянка землі для сільськогосподарських робіт (мал. 70.2).

y До яких кліматичних умов пристосувався тваринний і рослинний світ степів?
y Чому лісостепову зону називають перехідною?
y Яких тварин можна зустріти в степу
y Для чого створюють поля?
загадка
Споконвіку український степ називали «годувальником». Поясніть, чому.




Степова зона України займає 39 % її території: від зони лісостепу в південній частині України до узбережжя Чорного й Азовського морів і передгір’я Кримських гір (мал. 70.3).
Мал. 70.3 Природні зони України
У рельєфі лісостепу переважають височини. Більша частина території українського степу також рівнинна. Клімат у цих зонах помірно континентальний із теплим літом і помірно холодною зимою. В окремі роки тут бувають посухи. Славляться українські степи своїми чорноземами. Тому значну їх частину використовують як сільськогосподарські угіддя. Через низьку вологість у степах бувають суховії, посухи, які завдають значної шкоди сільському господарству.
Мал. 70.4. Злакові рослини найбільше пристосовані до життя в умовах степу
Умови життя в лісостепу та степу
У степовій зоні переважають кліматичні фактори, що негативно впливають на зростання деревної рослинності. Це — посухи й різкі зміни вологості повітря, чергування морозних днів із відлигами, ранні осінні й весняні заморозки. Тому серед рослин степу переважають різні трави, здатні витримувати посуху. В одних рослин стебла та листя рясно опушені або мають восковий наліт, а в інших рослин жорсткі стебла вкриті вузькими листками, що згортаються в суху пору року (злаки). Рослини відрізняються кореневою системою, що або глибоко йде в землю, або утворює бульби, цибулини, кореневища (мал. 70.4). Тваринний світ лісостепів і степів пристосований до існування на відкритих просторах за посушливих кліматичних умов.
Флора лісостепу та степу України
Мал. 70.5. Типові рослини степів: пирій, конюшина, стоколос
Флора перехідної зони формується видами як лісової, так і степової зон. З-поміж деревних рослин тут трапляються дуб, клен, липа, ясен, в’яз, верба тощо. Серед трав’янистих рослин переважають конюшина, тонконіг, ковила, стоколос, пирій тощо (мал. 70.5). На заплавних луках лісостепу ростуть осока, рогіз, калюжниця.

Мал. 70.6. Типові тварини степів: ховрах, орел степовий, тхір степовий, жук-гнойовик
Природна рослинність степової зони майже не зберіглася, адже 80 % земель розорані.
Фауна лісостепу та степу України

Тваринний світ лісостепів і степів різноманітний. Ссавці представлені гризунами (ховрах, бабак, тушканчик тощо), хижаками (тхори степовий і перев’язка, кам’яна куниця, лисиця-корсак тощо), плазунами (степова гадюка, жовточеревий полоз тощо). А серед птахів можна зустріти сову вухату, жайворонка, перепілку, вівсянку, сіру куріпку. Зрідка трапляються степовий орел, канюк. Багатий живий світ лісостепів і степів на безхребетних тварин, це — жук-гнойовик, жуколень, бражник мертва голова, павук-хрестовик, тарантул тощо (мал. 70.6).
Тваринний світ лісостепової зони представлений як лісовими, так і степовими видами.
Ключова ідея




Степи — це великі ділянки місцевості, що поросли переважно злаковою рослинністю. У лісостепах представлені як лісові, так і степові види рослин. Тваринний світ лісостепів і степів пристосований до існування на відкритому просторі за посушливих кліматичних умов.
Дізнайтеся більше
1. На карті природних зон світу покажіть розташування природної зони степу.
2. У чому схожість та відмінність між полями та луками?
3. Типового представника тваринного світу степів жукагнойовика в давнину в Україні називали «ґадзу ´ лею». Чим жук завдячує такій назві?
4. Які екологічні умови дозволили рослинам опанувати природну зону степів?
5. Про що свідчить наявність у степових рослин кореневої системи, що глибоко йде в землю, або утворює бульби, цибулини, кореневища?
6. За допомогою додаткових джерел інформації підготуйте фотоколаж «Тварини Українських степів», або «Тварини прерій».
Український зоолог Микола Шарлемань є автором понад 300 праць з орнітології, зоології, зоогеографії. Цікавим напрямом дослідження науковця стало «Слово о полку Ігоревім». Зокрема, він відзначив до 80 згадок диких тварин і птахів у тексті: сокола, лебедя, качки (гоголя), орла, чорного і сіродимчастого ворона, галки, сороки, дятла, вовка, тура, лисиці, горностая
тощо.
y Чому з підйомом у гори рослинність поступово змінюється?
y Чи може людина підніматися високо в гори без додаткового кисневого спорядження?
y Як змінюються температура повітря та тиск із висотою?
y Що таке зональність?
y До яких гір за абсолютною висотою належать Карпати та Кримські гори?
загадка
У Карпатах мандрівники можуть побачити багато дивовижних явищ. А той момент, коли гори «димлять», надихав поетів, композиторів і художників на створення справжніх шедеврів. Чому ж «димлять» гори?
Висотна зональність була вперше обґрунтована географом Олександром фон Гумбольдтом. 1799 року під час подорожі, яку ще називають другим відкриттям Америки, він помітив, що рослинність Південної Америки змінювалась із висотою. Коло підніжжя гір росли тропічні рослини, а високо в горах — лише мохи та лишайники. Висотна поясність (висотна зональність) — це закономірна зміна природних умов і ландшафтів у горах із висотою. Температура, вологість, склад ґрунту та сонячне випромінювання є важливими факторами, що впливають на формування висотних поясів (мал. 71.1). Чим вище в гори, тим більше змінюється клімат довкола. До прикладу, із висотою зростає інтенсивність сонячної радіації, а до висоти 2–3 км збільшується хмарність і кількість опадів. Для прикладу, на високогір’ї Карпат дощить утричі частіше, ніж біля підніжжя (1600–2000 мм опадів на рік).
Типи висотної поясності

Якщо порівняти висотну поясність, приміром, у Кримських горах і в Гімалаях, можна побачити, що вона суттєво відрізняється (мал. 71.2).
Кожній природній зоні властивий свій тип висотної поясності, що характеризується різною кількістю поясів, їх послідовністю та висотними межами. Формування типів висотної поясності залежить від певних чинників.
Умови життя в горах
Вплив висотної поясності істотно позначається на біорізноманітті гірських територій. Чим більша висота гір і чим ближче вони до екватора, тим більше видів флори та фауни в горах (мал. 71.3).
майбутньогопідручникаВидавництво «
Ранок»



Мал. 71.1. Повний спектр висотних поясів у Гімалаях
Мал. 71.2. Висотна поясність Кримських гір
Слід зважати, що з висотою скорочується вегетаційний період рослин, погіршуються інші агрокліматичні показники. Тому з підйомом у гори теплолюбні рослини змінюються холодостійкими. Також у високогір’ях умови життя ускладнені низьким тиском, нестачею кисню, зниженням точки кипіння води тощо.
У людини такі умови спричиняють несприятливі фізіологічні реакції, що отримали назву висотна (гірська) хвороба. Деякі фізіологічні зміни можна помітити вже на висоті 1500–2500 м. На висотах, більших за 5800 м, людина навіть у стані спокою відчуває погіршення самопочуття.
Пристосування організмів до перебування
в повітряному середовищі
Повітря, як середовище існування, через свої фізичні властивості малопридатне для існування в ньому живих організмів. Лише незначна їх кількість пристосувалася до життя в умовах повітряного середовища. Це насамперед мікроорганізми (бактерії (туберкульозні палички), спори пліснявих грибів тощо) (мал. 71.4 на с. 190).
Мал. 71.3. Рослини Карпат

Мал. 71.4. Кількість мікроорганізмів
в 1 м3
повітря в житлових
приміщеннях може сягати 20 тис
1. Що таке висотна поясність?
2. Префікс а- у словах іншомовного походження означає заперечення, відсутність чи недостатність ознаки, яка виражена коренем слова, тобто відповідає українському «не». Поясніть, чому висотну поясність часто називають азональною.
3. Чому жодні гори світу не мають таких контрастів ландшафтів, які можна спостерігати, піднімаючись в Гімалаях?
4. На яких висотах неможливо


перебувати без додаткового джерела кисню?
5. Чи відрізняються за будовою птахи, які мешкають у наземноповітряному середовищі, від птахів, що пристосувалися до життя у воді?
6. Побудуйте модель висотної поясності Кримських гір або Карпат. За зразок візьміть малюнок 71.1.
Мал. 71.5. Літати метеликам і комарам допомагають крила
Хоча повітря є несприятливим середовищем для їх життя, бо в ньому вони не знаходять продуктів живлення, проте мікроорганізми більшість часу перебувають у повітрі: потрапляють у нього з пилом, поширюються повітрям. Зокрема так поширюються патогенні мікроби, що спричиняють захворювання рослин, тварин і людини.
Переважна більшість організмів, здатних до польоту, використовує повітряне середовище лише для пересування. Але у повітрі значну частину життя проводять метелики, мухи, комарі тощо (мал. 71.5).
Наукова спільнота давно припускає, що деякі види птахів живляться і навіть сплять під час польоту. Але усі були приголомшені, коли дослідження довели, що серпокрилець чорний (стриж) здатний проводити в польоті до десяти місяців без жодної посадки.
Ключова ідея

Із висотою в горах відбувається закономірна зміна природних умов і ландшафтів. Висотна поясність пов’язана зі змінами температури, тиску, сонячної радіації. Як середовище існування, повітря використовують лише мікроорганізми. Для польотів у повітрі пристосувалися комахи та птахи.
Дізнайтеся більше
Людина здатна певною мірою адаптуватися до висотної хвороби. Так, спортсмени, щоб підвищити спортивні досягнення, спеціально тренують свою здатність до адаптації. Але в будь
якому випадку, на висоті понад 8000 м над рівнем моря тривале перебування людини без дихальних кисневих приладів неможливе.
1 Чому вважають, що новий етап у розвитку географії розпочався в середині XX століття?
2 Які джерела знань ви вважаєте найсучаснішими? Поясніть, чому.
3 Якими відкриттями і винаходами ми завдячуємо мандрівникам / мандрівницям, дослідникам / дослідницям Землі?
4 Складіть свій рейтинг найважливіших відкриттів у дослідженні
Землі. Презентуйте його однокласникам / однокласницям.
5 У будь-який спосіб доведіть, що зобразити кулясту форму земної поверхні на площині без спотворень неможливо.
6 Підготуйте презентацію про незвичайні глобуси, що були створені в різних країнах світу. Зверніть увагу на те, з якою метою їх створювали.
7 Яка відстань від Північного до Південного полюса через центр Землі?
8 Дослідіть, у чому полягає небезпека будування гідроелектростанцій у Карпатських горах.
9 Чи впливає вирубування дерев на пагорбі на ймовірність зсуву ґрунту? Поясніть свою думку.
10 Визначте, які професії пов’язані з вивченням (збереженням) природи.
11 Яке значення прогнозування погоди для життя й діяльності людини? Наведіть приклади з власного досвіду, коли вам став у пригоді прогноз погоди.
12 Поміркуйте, як може виглядати ваша місцевість через 50 років через втручання людини у природу. Відповідь представте у вигляді малюнка, схеми, інфографіки тощо.
13 Чи є різниця між повітрям, яким ви дихаєте в приміщенні, та повітрям, яким ви дихаєте на вулиці? Відповідь аргументуйте.
14 Уявіть себе метеорологом / метеорологинею та доповніть таблицю-
класифікатор хмар відсутньою інформацією.
Ярус
Назва хмар Вигляд хмар
Шаруватокупчасті
Нижній



Можливі зміни погоди
Опадів не дають. Взимку тримаються довго, влітку швидко розходяться
Шаруватодощові
Високошаруваті
Може бути невеликий
дощ
Опадів не дають
Сигналізують про зміну погоди
Верхній
Перистошаруваті



15 Людству загрожує багато природних явищ. Особливо небезпечними

є виверження вулканів та землетруси. Складіть пам’ятку про загрози, які виникать під час землетрусу або виверження вулкана, в якій обґрунтуйте необхідність запропонованих дій. Формат
пам’ятки оберіть самостійно (буклет, листівка, інфографіка тощо).


16 Розгляньте малюнок та з’ясуйте, які події відбувалися в той чи інший період на нашій планеті.
Ми занурюємося у світ природничих наук
y Назвіть три факти, які ви дізналися з розділу.
y Наскільки важливими є ті завдання, які ви виконали?
y Де ви зможете використати знання з вивченого розділу?
y Під час вивчення матеріалу ви досягли певних успіхів. Що
ви робили для цього?
y Де вам знадобиться новий досвід?
y Із якими перешкодами ви зіткнулися під час опанування
розділу?
y Як ви подолали труднощі?
§ 72. Походження людини


Чим саме люди відрізняються
від інших живих організмів?
Наведіть конкретні приклади.

Назвіть основні теорії виникнення життя на Землі.
Походження та еволюція людини
Як не існує єдиної доведеної теорії походження життя на Землі, так не існує і єдиної думки про місце й час появи першої людини. Сьогодні цими питаннями займається антропологія — наука, що вивчає походження і подальший розвиток (еволюцію) людини, утворення людських рас. За результатами досліджень антропологів були зроблені припущення, що прабатьківщиною людини була Східна Африка. Адже саме тут 1924 року були знайдені рештки австралопітека — істоти, яку за будовою вважають проміжною ланкою між мавпою і людиною (мал. 72.1).
А в 1959–1961 роках у Танзанії, що у Східній Африці, було знайдено не лише кістки австралопітеків, а й кам’яні знаряддя. Усе це дозволило
Мал. 72.1. Австралопітек (комп’ютерна модель)
Мал. 72.3. Неандерталець (реконструкція)
припустити, що саме Африка є «колискою» людства, звідки воно поширилося світом (мал. 72.2).
У Німеччині в долині Неандерталь 1856 року було вперше знайдено й описано рештки неандертальця — викопного виду, який імовірно населяв Європу й Західну Азію у 230 000–27 000 роках до н. е. (мал. 72.3). В Україні кістки неандертальців, знаряддя праці і сліди вогнищ були знайдені в печері Киїк-Коба (Крим) та в гроті Прийма-1 (Львівська обл.).
Сьогодні панує думка, що не неандертальці були еволюційними попередниками сучасних людей, а кроманьйонці (мал. 72.4).
Єдиний вид роду Людина (Homo), що зараз населяє Землю, — Людина розумна (Homo sapiens) (мал. 72.5).


Унікальність людства
Сьогодні на Землі Людина розумна — єдиний
вид свого роду. А чи означає це, що ми унікальні? Приміром, Аристотель ще понад 2000 років тому уважав, що ми — розумні тварини, які прагнуть знання заради самого знання, що ми живемо мистецтвом і мисленням.
Дійсно, саме в Homo sapiens почало розвиватися мистецтво (мал. 72.5). Спочатку це були прості символи, за допомогою яких люди описували навколишній світ. Проте згодом це сприяло появі складної мови.
Мова та мистецтво є визначальними характеристиками людей. Також еволюційною перевагою людини стали великий мозок, здатність обробляти інформацію та складні соціальні навички.
Утім, якою б унікальною не була людина — вона є частиною живої природи та має певні спільні риси з іншими організмами.
Ключова ідея
Походження та еволюцію людини вивчає наука антропологія. Прабатьківщиною людства була Східна Африка. Єдиний
вид роду Людина (Homo), що сьогодні населяє Землю, — Людина розумна (Homo sapiens).
Мал. 72.5. Печерне мистецтво Людини розумної
Запитання і завдання
1. Що вивчає антропологія?
2. Назвіть еволюційні переваги людства.
3. Якби ви були первісною людиною, яке б відкриття зробили першим?
4. За допомогою мал. 72.2 установіть послідовність розселення людини.
5. Що спільного між людиною та твариною?
6. Чи дійсно людство унікальне? Чому?
Чому в одних місцях нашої планети живе велика кількість людей, а в інших — дуже мало?
y Що таке людство?
y Як людина розумна
розселилася світом?
y Чому процес розселення
людей відбувався повільно?
загадка
Серед наукової спільноти переважає думка, що прабатьківщиною сучасної людини була Африка. Корінні мешканці
цього континенту мають темно-коричневий або чорний колір шкіри, карі очі, чорне кучеряве волосся, великі губи й широкий ніс. Чому ж не все населення нашої планети має такі самі зовнішні ознаки?

Пригадайте, як ви прижмурюєте очі, коли в обличчя дме сильний вітер, або як від сонця тіло вкривається засмагою. Так наш організм певним чином пристосовується до природних умов. Так само відбувалося з окремими групами людей, які оселялися на певній території. Під впливом природних умов упродовж тривалого часу змінювалася їхня зовнішність. Наприклад, вузький розріз очей запобігав потраплянню в них пилу і піску, а через надлишок сонця у шкірі виробився спеціальний фарбник (пігмент), від якого шкіра поступово набула темного кольору. Зовнішні ознаки передаються спадково з покоління в покоління, від батьків до дітей, незалежно від місця проживання. Так на Землі сформувались основні групи людей зі схожими зовнішніми ознаками — людські раси. До расових (зовнішніх) ознак належать колір шкіри, риси обличчя, колір і форма волосся. Розрізняють чотири основні раси: європеоїдну, монголоїдну, негроїдну та австралоїдну, але деякі науковці об’єднують негроїдну й австралоїдну раси в одну — екваторіальну.
Найчисленнішою сьогодні є європеоїдна раса (близько 45 % населення Землі). Представники європеоїдної раси — це корінні народи Європи, Західної Азії та арабські народи Північної Африки. Проте за останні століття багато представників цієї раси переселилися на інші материки (мал. 73.1).
Зовнішній вигляд представників європеоїдної раси не однаковий: люди, що живуть у північних регіонах, мають переважно світлішу шкіру і світле волосся, а в мешканців південних районів більш смаглява шкіра і темне волосся (мал. 73.2).
До монголоїдної раси належать народи Північної, Східної і Південно-Східної Азії, а також корінне населення Америки (мал. 73.3). Представ-
Видавництво «Ранок»
Мал. 73.1. Сучасне розселення (розміщення) представників різних рас

ники монголоїдної раси сьогодні також проживають на різних континентах.
Народи, що мешкають у приекваторіальних районах Африки, сформували негроїдну расу (мал. 73.4). І хоча вони переважно розселені в Африці, багато представників негроїдної раси сьогодні живе в Америці.
Австралоїди є найменш чисельною расою. Це — корінні мешканці Австралії та навколишніх островів. Раса не набула значного поширення на планеті, на відміну від інших рас (мал. 73.5).
У результаті розселення представників різних рас планетою та створення сімей між людьми різних рас утворилися мішані раси — креоли, самбо, мулати, метиси тощо.



Стародавні цивілізації зазвичай надавали великого значення племінній або родинній належності людини, а не зовнішнім ознакам.
Утім, у певні періоди історії траплялося, що представники однієї раси вважали себе вищими за представників інших рас. Проте розум людини, її природні здібності не залежать від належності до тієї чи іншої раси! Одним із перших довів рівність людських рас і виступив проти расизму Микола Миколайович Миклухо-Маклай, нащадок

Мал. 73.2. Українці належать до європеоїдної раси
Мал. 73.3. Індіанці — корінне населення Америки
Мал. 73.4. Корінне населення Африки
Мал. 73.5. Корінне населення Австралії — аборигени
Мал. 73.6. Усі ми різні, але всі є жителями планети Земля
славнозвісного козацького роду (його батько походив із міста Стародуба, що на Чернігівщині). Перша подорож Миклухо-Маклая до Нової Гвінеї розпочалася 1870 року. Він оселився на острові, де жили представники австралоїдної раси — папуаси. Він вивчав їхнє життя та побут. Результатом його досліджень став висновок, що представники всіх людських рас рівні за розумом і здібностями. Сьогодні багато науковців уважають, що ідея різних людських рас у біологічному сенсі застаріла. Це доводить і сучасна генетика: поняття «раса» уже не дає точного уявлення про біологічні варіації людини (мал. 73.6).
Мал. 73.7. Знадобилося понад 200 тис. років, щоб кількість населення досягла 1 млрд осіб, і лише 219 років, щоб досягти 8 млрд осіб
1. Що таке людська раса?
2. Чим зумовлені відмінності в зовнішньому вигляді представників різних рас?
3. Для чого нам потрібні знання про кількість населення? Хто їх може використовувати?
4. Чи може в людини змінитися колір шкіри? Відповідь обґрунтуйте
5. Які причини, на ваш погляд, впливають на кількість населення? Розподіліть їх на такі, що сприяють збільшенню кількості населення, та такі, що стримують зростання.

6. За графіком зміни кількості населення Землі (мал. 73.7)
спрогнозуйте, як може змінитися кількість населення в найближчі 10 і 20 років.
Населення планети Населення нашої планети є об’єктом вивчення багатьох наук, зокрема демографії (у перекладі з грецької — «опис народу»). Демографія досліджує процеси формування кількості та складу населення, особливості його розміщення. Скільки людей мешкало на Землі в прадавні часи, достеменно сказати неможливо. Адже точні дані можна отримати лише за переписами населення. А вони відомі для певних періодів історії та певних країн. Згідно з деякими припущеннями, ще 10 тис. років тому населення Землі становило близько 4 млн осіб. А 15 липня 2022 року (за оцінкою ООН) кількість населення світу досягла 8 млрд осіб (мал. 73.7).
За оцінкою ООН, в Україні зараз мешкає 40 млн осіб.

Сьогодні ми можемо слідкувати за змінами кількості населення на спеціальних сайтах в інтернеті. Наприклад, на статистичному сайті worldometers.
Ключова ідея
За зовнішніми ознаками виділяють чотири основні раси людей. Представники різних рас відрізняються за зовнішніми ознаками, але розумові здібності людини не залежать
від її расової належності. Станом на кінець 2022 року на нашій планеті живе понад 8 млрд осіб.
майбутньогопідручника
Видавництво
населення на Землі

Розселення людства земною кулею відбувалося нерівномірно, адже люди завжди обирали для життя місця зі сприятливим кліматом, на рівнинних місцевостях, біля водойм тощо.
Це підтверджується археологічними знахідками в долинах Нілу, Тигру та Євфрату, Інду, на рівнинах Китаю, узбережжі Середземного моря, де сформувалися перші осередки цивілізації (мал. 74.1).
Минали століття, але й сьогодні саме природні умови та природні ресурси впливають на розміщення населення. Тому майже 70 % населення нашої планети проживає на 7 % поверхні суходолу.
Території, які досі залишаються незаселеними (або майже незаселеними), — це острови Північного Льодовитого океану, Гренландія та Антарктида, тобто регіони з несприятливими для життя природними умовами.
Окрім природних, на розміщення населення впливають різні соціально-економічні чинники
та історичний розвиток територій. Для більш чіткого визначення розселення використовують такий показник, як густота населення — кількість жителів на 1 км2 території. Щоб визначити густоту населення, необхідно кількість населення поділити на площу території, де воно проживає.
Дослідження: розселення людей на планеті
1. Станом на листопад 2022 року кількість населення Землі становить 8 млрд осіб, а площа суходолу Землі — 149 млн км2. Обчисліть середню густоту населення нашої планети.
2. Середня густота населення України станом на 2020 рік становить 72 особи/км2. Порівняйте її із середньою густотою населення Землі та зробіть висновок.
y Чому різні частини материків заселені нерівномірно?
y Які причини розселення людства земною кулею?
y Чи відрізняються умови життя в місті та сільській місцевості?
y Де виникли перші осередки людської цивілізації?
y Які населені пункти є поруч із вашим?
загадка
1978 року на станції
«Есперанса», що належить Аргентині, поблизу вершини Антарктичного півострова з’явилася на світ перша людина Антарктиди — Еміліо Маркос Палма. Чому його вважають першою людиною цього величезного материка?
Мал. 74.1 Стародавній Єгипет у долині Нілу


3. У якій півкулі проживає більше людей: у Північній чи Південній?
4. Густота населення значно відрізняється


за материками. Так, в Азії густота населення в деяких районах сягає 2000 осіб/км2, у Європі й Північній Америці — 1500 осіб/км2. Найменша густота населення в Австралії — лише 2 особи/км2. Із чим, на вашу думку, пов’язані такі розбіжності?
Типи населених пунктів Розселення — це результат розподілу населення територією у формі мережі населених пунктів. Населений пункт — це територіально обмежене людське поселення з постійними жителями, житловою, господарською й іншою забудовою. Кожний населений пункт має адміністративно закріплену географічну назву.
Головною ознакою, за якою розрізняють міські та сільські поселення, є характер зайнятості населення. Тобто, якщо більшість людей працює в промисловості та сфері послуг — це міське поселення. А якщо населення переважно працює в сільському господарстві — це сільське поселення. Сьогодні половина населення планети мешкає в міських населених пунктах. Цікаво, що, приміром, в Ісландії містом вважають поселення, де проживає понад 200 осіб, у Сполучених Штатах Америки — понад 2,5 тис. осіб, а в Україні — понад 10 тис. осіб (мал. 74.2).

Тому для всіх країн світу спільного критерію для
міста за кількістю жителів не існує. Облік міст ведуть окремо за даними кожної держави.
Сільські населені пункти мають незначну кількість населення. Вони сформувалися переважно на базі сільськогосподарського виробництва. У селах, селищах і хуторах переважають невеликі житлові будівлі з присадибними ділянками (мал. 74.3).
Головною ознакою міста в Україні також
є характер зайнятості населення в ньому. Утім стати містом населений пункт може лише за рішенням Верховної Ради України.
Два міста в Україні мають спеціальний статус — Київ (столиця країни) і Севастополь, розташований на території Автономної Республіки Крим (мал. 74.4).
В Україні переважають малі та середні міста. Проте є і надвеликі, де проживає до 1 млн осіб: Дніпро, Запоріжжя, Львів та інші, а також міста з населенням понад 1 млн осіб — Київ, Харків та Одеса (мал. 74.5).
Більшість сільського населення в Україні проживає в середніх і великих селах (від 500 осіб) (мал. 74.6).
Ключова ідея
Розміщення населення на території та розподіл його за різними типами поселень називають розселенням. Населення
на планеті розміщене дуже нерівномірно. Це зумовлене природними, історичними, демографічними й економічними чинниками. Розрізняють два типи поселень: міські та сільські.
1. Як можна обчислити густоту населення?
2. Чи пов’язана сучасна густота населення на певних материках із давніми міграціями людей?
3. Як ви вважаєте, чому міста Прип’ять і Чорнобиль в Україні взагалі не мають постійного населення?
4. Дізнайтеся, як утворилася назва вашого населеного пункту. Чи змінювалася вона від початку його заснування?
5. Що спільного між умовами життя в сучасному селі та місті? Чи були такі самі умови в минулому? Що саме змінилося?
6. Уявіть, що вам необхідно створити буклет для туристів, які приїдуть до вашого населеного пункту. Намалюйте план міста (села), на якому позначте місця, які можна запропонувати для відвідування. У текстовій частині буклета опишіть переваги життя саме у вашому населеному пункті.
Топоніміка (від грец. тopos — місце та onoma — ім’я, назва) — наука, що вивчає місцеві назви (топоніми). Вона перебуває на межі трьох наук: географії, історії та мовознавства. Топоніміка
вивчає географічні назви, їхнє походження, змістове значення, розвиток, написання та вимову, а також соціальні й природні умови минулого, за яких ці назви виникли.
Дізнайтеся більше
Видавництво
«
Ранок»

y Який вплив більший: природи на людину чи людини на природу?
y Як ви розумієте вирази: «століття хімії», «століття синтетики»?
y Які джерела енергії ви знаєте? Як їх класифікують?
y Яка відмінність між речовиною та матеріалом?
y Які речовини є природними, а які — штучними?
загадка
Христофор Колумб описав гру
індіанців у м’яч, який був зроблений із соку дерева. Також із цього соку індіанці робили взуття: вмочали ногу в сік, який застигав, утворюючи черевики. Сік якого дерева використовували індіанці?
Із давніх-давен людина використовувала для своїх потреб усе, що її оточувало.
Ресурси — усе, що можна використати для виробництва благ із метою задоволення потреб людини. Розрізняють природні та людські ресурси. Людські ресурси — це люди, які мають певні професійні навички та знання, та можуть використовувати їх у трудовому процесі. Людські ресурси залежать від багатьох чинників: фізичного стану, інтелектуального розвитку тощо.
Різноманіття природних ресурсів також класифікують за певними ознаками.
У нашій країні є всі види природних ресурсів (за винятком енергії припливів і відпливів). Лише корисних копалин в Україні розвідано 94 види, розробляється 8000 родовищ, де видобувають сировину для промисловості.
Багата Україна і на ґрунти, зокрема чорноземи, і на рекреаційні ресурси (мал. 75.1).

в побуті
Із давніх-давен люди використовували в побуті такі природні речовини, як смола, віск, жири, ефірні масла та природні барвники. У Стародавньому Римі столи натирали м’ятою для приємного запаху, а для профілактики інфекційних захворювань спалювали кедр.
Для бальзамування тіл у Стародавньому Єгипті використовували спеціально дібрані речоМал. 75.1. Рекреаційні ресурси Карпат
майбутньогопідручникаВидавництво «
Ранок»
вини. Сечу тварин застосовували для прання. Смолою та бджолиним воском змащували човни.
З природних речовин також виготовляли мило.
Зі збільшенням потреб лише природних ресурсів людству виявилося недостатньо. Почали з’являтися

штучні матеріали. А у ХХ столітті розпочалося масове виробництво товарів побутової хімії.
Сьогодні людство використовує побутові
хімічні речовини (мийні, дезінфікуючі засоби тощо) і хімічні речовини спеціального призначення (мінеральні добрива, будівельні матеріали, засоби для боротьби зі шкідниками тощо).
Під час використання речовин, зокрема хімічних, дуже важливими є правила безпеки. Більшість речовин і матеріалів, із якими ми маємо справу щодня, є безпечними у використанні (якщо дотримуватися інструкції). А на упаковках
із небезпечними речовинами має бути спеціальне маркуванняіз рекомендаціями з використання і зберігання (мал. 75.2).
На жаль, масове використання хімічних речовин у побуті забруднює навколишнє середовище. Зі стічними водами в довкілля потрапляють хімічні сполуки, не властиві природі, або не характерні для неї в такій кількості.
Сьогодні не можна повністю відмовитися від використання побутової хімії. Проте слід спрямувати зусилля на створення таких штучних речовин, що будуть корисними для людини і не шкідливими для довкілля.
Ключова ідея
Усе, що можна використати для задоволення потреб людини, називають ресурсами. Ресурси поділяють на природні та людські. Людству недостатньо лише природних ресурсів, тому з’являються різні штучні матеріали. Використання будьяких ресурсів має бути заощадливим і безпечним.
Мал. 75.2. Маркування небезпечних речовин і матеріалів
1. Класифікуйте відомі вам природні ресурси за характером відновлення.
2. Наведіть приклади природних ресурсів, які відрізняються за походженням.
3. Складіть перелік відомих вам природних ресурсів України та розподіліть їх за призначенням.
4. Пригадайте, яке маркування небезпечних речовин вам траплялося. На упаковках яких товарів?
5. Підготуйте презентацію «Хімічні речовини в побуті: за і проти».

Чому люди почали створювати синтетичні матеріали?
Чи можуть штучні матеріали повністю замінити природні?
y Наведіть приклади природних речовин і тих, що винайдені людиною. y Для чого людина використовує різноманітні матеріали?
Мал.
Суттєвою відмінністю людини розумної (Homo sapiens) від інших видів стало використання нею природних матеріалів як знарядь полювання та праці. Тисячоліттями людина використовувала лише ті матеріали, що давала їй природа. Перші будівлі прадавніх людей були дуже прості. Їх зводили з каменю, деревини, осоки й інших природних матеріалів (мал. 76.1). Такі будівлі й сьогодні можна побачити в Африці, Австралії тощо. Новий етап у розвитку цивілізації розпочався, коли люди навчилися створювати матеріали, яких не існувало в природі, — синтетичні матеріали.Зокрема, коли виникла потреба в матеріалах для масового будівництва, були винайдені цегла, бетон, скло, пластмаса та інші будівельні матеріали, що не трапляються в природі. Ці штучні матеріали були більш міцними, вогнетривкими, пластичними, легкими, ніж природні (мал. 76.2). Із давніх-давен людина використовує бавовну, вовну, льон, шкіру, хутро для виготовлення одягу. Усе це — природні матеріали тваринного та рослинного походження. Від кінця ХІХ століття для виготовлення одягу на заміну природним волокнам були винайдені синтетичні — віскоза, капрон, нейлон, акрил тощо. Природні шкіру та хутро сьогодні поступово замінюють штучні аналоги. Вони стійкіші, простіші в догляді, а головне — дешевші у виробництві, тож доступніші. Крім того, використання синтетичних матеріалів зберігає життя тварин і вивільняє сільськогосподарські землі, які потрібні для вирощування бавовника й льону та випасу тварин для отримання вовни та шкіри. Іще одна галузь, де синтетичні матеріали замінюють природні, — меблева промисловість. Раніше меблі виготовляли переважно з деревини. Сьогодні

для масового виготовлення меблів використовують
спеціальні плити, що виготовляють із дерев’яних
ошурків — відходів деревообробної галузі. Також для виготовлення сучасних меблів широко використовують пластмаси, скло, метал, кераміку.
Проєктна діяльність. Боротьба з пластиковими відходами в рідному краї
Сьогодні актуальною є
проблема утилізації
синтетичних матеріалів. За даними праворуч розгляньте, скільки часу (орієнтовно) потрібно для розкладання речей, якими ми користуємося в побуті:
Наведені терміни розкладання різних видів відходів, зокрема пластику, є орієнтовною. Адже наука не стоїть на місці, і сьогодні, приміром, виробляють пластики, які розкладаються впродовж трьох років. Проаналізуйте кількість пластикових відходів, які впродовж тижня найчастіше потрапляють у смітник у вашій родині. Запропонуйте, як обмежити використання пластикових речей, які довго розкладаються.
Спробуйте сортувати відходи та здавати пластик на переробку, якщо у вашому населеному пункті ще не встановлені спеціальні контейнери для сортування сміття.
Ключова ідея

Багато років людство використовувало природні матеріали в різних галузях своєї діяльності. Синтетичні матеріали широко використовують у будівництві, для виготовлення одягу, меблів тощо.
Під час хірургічних операцій пацієнти можуть утрачати багато крові, тому було синтезовано штучну кров для часткової заміни донорської. Один із варіантів такої штучної крові — це речовина блакитного кольору. Вона добре переносить кисень від легень до інших орга-
1. Поясніть, чим відрізняються природні та синтетичні матеріали.
2. Наведіть приклади синтетичних матеріалів, що використовує людина в будівництві.
3. Які переваги синтетичних матеріалів?
4. Порівняйте природні та синтетичні матеріали, з яких може бути виготовлений одяг. Які переваги або недоліки має їхнє використання?
5. Запропонуйте, як можна в домогосподарстві обмежити споживання продуктів і речей, які довго розкладаються.
6. Чи згодні ви, що використання синтетичних матеріалів може зашкодити природі? Чому?
нів людини. Ще одна її перевага — ця кров сумісна з будь-якою групою крові. Також її зберігання не потребує коштовного обладнання. Однак є й недоліки — така «блакитна кров» дуже коштовна, і її не можна використовувати тривалий час.

Як пов’язаний розвиток людської цивілізації з розвитком техніки і технологій?
y Що таке енергозберігаючі технології?
y Назвіть космічні тіла, що утворюють Сонячну систему.
загадка
В одній із громад Вінницької
області із суміші піску та
вторинної сировини виготов-
ляють «вічну бруківку». Така
плитка дешевша та якісніша
від бетонної. Вона «не боїться»
соляних розчинів або перепадів температури, а термін її експлуатації значно більший.
Яку вторинну сировину, що раніше забруднювала повітря, використовують для виробництва цієї плитки?
і
еволюція людської цивілізації
Історія людської цивілізації пов’язана з розвитком техніки та технологій. Різноманітні технічні засоби дозволили отримувати більші врожаї, пересуватися швидше, перевозити великі вантажі, мати можливість спілкуватися на будьяких відстанях, здійснювати складні обчислення, досліджувати потаємні куточки планети, будову Сонячної системи і Всесвіту тощо. Розгляньмо деякі технічні надбання людства. Винайдення
Суттєвим кроком у розвитку стародавньої техніки було винайдення колеса. Обертальний рух колеса дозволив створити колісний транспорт: вози, колісниці, карети, велосипеди, автомобілі, залізничний транспорт. Створення колісного транспорту потребувало будівництва розгалуженої мережі доріг. До наших днів в Італії збереглися окремі ділянки доріг для бойових колісниць Стародавнього Риму — Аппієві дороги. Їх вимощували кам’яною бруківкою, тож на сучасний погляд ці дороги не дуже зручні для подорожі велосипедом або автомобілем (мал. 77.1). Сучасні дороги дозволяють колісним транспортним засобам розвивати під час руху значну швидкість і перевозити багатотонні вантажі. Також важливим є використання колеса в залізничному транспорті, який є лідером у наземному вантажному перевезенні.
Колесо використовують у різноманітних механізмах. Наприклад, зубчасті колеса різного діаметра є в конструкціях механічних годинників: від тих, що встановлені на ратушних вежах, до ручних моделей (мал. 77.2).
Мал. 77.1. Сьогодні в Італії можна побачити дороги часів Стародавнього Риму
Конвеєр Революційною технологічною новацією
майбутньогопідручникаВидавництво
для масового виробництва автомобілів на автомобілебудівних заводах у США. До того часу автомобілі збирали по одному: кожний від першого гвинтика до останнього. 1908 року використання конвеєрного виробництва на автомобільних заводах Генрі Форда стало одним із чинників промислової революції у світі. Конвеєрний спосіб збирання виявився в десятки разів ефективнішим, ніж поодинокий.
Сьогодні конвеєри використовують майже в усіх машинобудівних та інших виробництвах світу (мал. 77.3).

Для підтримання сучасного рівня життя людству потрібно багато енергії. Її видобуток супроводжується негативним впливом на природу. Для зменшення цього впливу останнім часом активно впроваджують енергозберігаючі технології. Про ці технології ми вже говорили в 5 класі. Це, наприклад, «зелена» енергетика (мал. 77.4).
Утеплення будинків, використання у вікнах склопакетів для зменшення втрат тепла, заміна ламп розжарювання на енергозберігаючі або світлодіодні, використання електричних та електронних пристроїв, комп’ютерів, телевізорів, планшетів, смартфонів зі зниженим електроспоживанням — усе це дієві кроки щодо впровадження енергозберігаючих технологій, які сьогодні доступні людству.

Комп’ютерні технології об’єднують багато галузей людської діяльності. Сьогодні без комп’ютерів неможливо уявити системи управління рухом автомобільного та залізничного транспорту, літаків і суден. Комп’ютерні технології широко використовують у школах та університетах під час навчання. У науці за допомогою комп’ютерів моделюють експерименти й аналізують результати. Наприклад, дані з детекторів Великого адронного колайдера в Європейській організації
з ядерних досліджень (Женева, Швейцарія), що

на сьогодні є найбільшим фізичним приладом
Мал. 77.3. Конвеєри використовують як на автомобілебудівних, так і на хлібозаводах
Мал. 77.4. Вітрові та сонячні електростанції — основа «зеленої» енергетики

3. Досліджуємо діяльність людини
людства,
виконує не лише комп’ютерний центр організації, але й тисячі комп’ютерів по всьому світу (мал. 77.5). Важливу роль при створенні комп’ютерної мережі Інтернет у сучасному вигляді відіграв зручний протокол http та концепція гіперпосилань, розроблені співробітниками лабораторій Європейської організації з ядерних досліджень.
Мал. 77.5. Сучасний комп’ютерний центр



Людина завжди цікавилася тим, що відбувалося на небі, спостерігала за сходом і заходом Сонця, зміною вигляду Місяця від нового до повного, появою на нічному небі впродовж року тих чи інших сузір’їв і завжди мріяла дотягнутися до зір.
Сьогодні спостереження за астрономічними об’єктами в земних астрономічних обсерваторіях проводять за допомогою сучасних оптичних і радіотелескопів.
1957 року почався космічний етап дослідження космосу — було запущено перший штучний супутник Землі. А згодом і польоти людини в космос стали буденною справою. За останні 65 років у космосі побувало майже 600 осіб. Під час польотів астронавти виконують біологічні, хімічні, фізичні й інші експерименти за умов невагомості.
Мал. 77.6. Космічний телескоп Хаббл та його «нащадок» Спітцер
Від початку космічної ери в космос було запущено тисячі автоматичних космічних апаратів. Вони в дистанційному автоматичному режимі досліджують Сонце, планети Сонячної системи, астероїди та комети.
Навколо Землі орбітами рухається велика кількість космічних наукових обсерваторій, серед яких космічні телескопи Хаббл, Спітцер, Джеймс Вебб та інші (мал. 77.6). За їх допомогою людина «зазирнула» у найвіддаленіші куточки Всесвіту. Космічні дослідження допомагають у прогнозуванні погоди, зокрема завдяки використанню супутників, які збирають дані про атмосферні явища. Супутники стежать за рухом повітряних мас, передають дані про температуру поверхні
Землі, вологість, хмарність, сонячне випромінювання та інші параметри, які необхідні для точного прогнозування погоди. Супутники також можуть збирати дані про розміщення та кількість
лісів, стан ґрунту, рівень води в річках тощо. Це дозволяє ефективніше використовувати природні ресурси та зберігати їх.
Отже, космічні дослідження мають великий потенціал у багатьох сферах людської діяльності. Сьогодні через супутники працює глобальна система позиціонування GPS, що дозволяє визначати точне місцезнаходження та шлях до потрібної точки на Землі. А станції глобальної супутникової системи Starlink дають доступ до супутникового Інтернету (мал. 77.7).
Ключова ідея
Людство винайшло безліч технічних пристроїв, створило багато різних технологій, які сприяли розвитку цивілізації. Усі галузі життя людини пов’язані з розвитком техніки і технологій.
Дізнайтеся більше
1. Чому винайдення колеса дало великий поштовх розвитку людства?

2. Складіть перелік речей у вашому домі, де використовується обертальний рух.
3. У чому перевага використання конвеєру на виробництві?
4. Опишіть одну конкретну перевагу й один конкретний недолік використання вітру для вироблення електроенергії порівняно з використанням органічного палива, як-от вугілля та нафта.
5. Наведіть приклади корисних наслідків використання комп’ютерних технологій із власного досвіду.

6. 1900 року французькі художники створили серію малюнків «Франція у 2000 році», де зобразили своє бачення світу майбутніх технологій. Ці малюнки вже стали надбанням громадськості і є у вільному доступі в інтернеті. Перегляньте (за можливості) ці малюнки та оцініть, наскільки художникам вдалося вгадати майбутнє.
Марина В’язовська — українська математикиня, яка першою розв’язала
задачу оптимальної упаковки куль у 8-вимірному та 24-вимірному евклідовому просторі. Це відкриття може допомогти виправляти помилки мобільного
зв’язку, інтернету та космічних досліджень. За свою роботу отримала медаль
Філдса — ця премія є аналогом Нобелівської премії в галузі математики.

Що сприяє розвитку медичних технологій?
y Які винаходи людина «підглянула» у природи?
y Які винаходи змінили світ?
y Які переваги синтетичних матеріалів над природними?
Мал. 78.1. Без цього винаходу багато людей залишилися б прикутими до інвалідного візка
Технологічний прогрес людства не оминув жодної галузі виробництва, зокрема медичної. Медичні винаходи спрощують лікувальні процедури, пришвидшують процес одужання та реабілітації. Створено навіть штучні органи. 2015 року наукова група з Національної академії наук України представила ендопротез кульшового суглоба, зроблений із титану (мал. 78.1). Титанові ендопротези є найкращими для імплантації в організм: вони не відторгаються тканинами тіла людини, на відміну від інших сплавів. А ще вони зношуються в шість разів повільніше, ніж з інших матеріалів. Ця розробка українських науковців дозволяє людині вільно рухатися, не відчуваючи дискомфорту. Значний внесок у розвиток медичних технологій за останні роки зробила не лише українська медична спільнота. Ідею розрізати тканини людини водяним струменем втілили інженериавіатори. Узявши за основу технології, що використовуються в авіапромисловості, винахідники під керівництвом професора Віктора Бочарова 2012 року винайшли рідинний струменевий скальпель. Він ріже тканину та капіляри, не пошкоджуючи великих судин Гідроструменевий скальпель уже почали використовувати в хірургії.
Хімічні технології
Сьогодні для того, щоб зробити відкриття, потрібні знання з багатьох дисциплін. Тому зазвичай відбувається співпраця дослідників і дослідниць у різних наукових галузях.
Мал. 78.2. Так виглядають напівпровідники у смартфоні
Для того, щоб ми могли користуватися різноманітними ґаджетами, потрібні напівпровідники (мал. 78.2). Основною відмінною властивістю цих матеріалів є збільшення електричної провідності з підвищенням температури. Саме такі речовини

синтезує хімічна спільнота в лабораторіях по всьому світу.
У сучасній техніці широко використовують рідкі кристали. Вони дуже чутливі до зміни зовнішніх умов. Навіть за незначної зміни температури, тиску, електричного або магнітного поля вони можуть змінювати свій колір. Цю властивість рідких кристалів використовують у різних приладах, зокрема в рідкокристалічних медичних термометрах. Рідкі кристали застосовують і для виготовлення дисплеїв — від годинників і мобільних телефонів до комп’ютерів і телевізорів (мал. 78.3).
Хімічні технології дозволяють створювати нові ліки від поки що невиліковних захворювань. Випускники Львівського національного університету імені Івана Франка Олена та Олег Таратули працюють над створенням ліків для лікування злоякісних пухлин. У лабораторії штату Орегон вони розробили речовину, що виявляє в організмі ракові клітини та допомагає їх знищувати. Подружжя українських професорів, яке нині мешкає у США, сподівається, що подальші дослідження підтвердять дієвість їхніх ліків у боротьбі з тяжкими захворюваннями. Ключова ідея
Медичні технології пов’язані з такими науками, як фізика, хімія та біологія: хіміки й хімікині синтезують речовини з наперед заданими властивостями, фізики й фізикині досліджують їхні властивості, а біологи й біологині вивчають вплив цих речовин на організм тварин і людей.
Мал. 78.3. Завдяки хімічним технологіям ми маємо якісні зображення на екранах
1. Наведіть приклади сучасних медичних винаходів.
2. Поясніть, як медичні технології впливають на покращення життя людей.
3. Поміркуйте, який внесок роблять хіміки і хімікині в наукові відкриття.
4. Які причини, на ваш погляд, спонукають наукову спільноту різних галузей працювати над однією проблемою?

5. Із чого починається новий винахід, технологія? Відповідь аргументуйте.
6. За допомогою мережі інтернет знайдіть простий рецепт виготовлення антисептика для рук. За допомогою дорослих спробуйте його відтворити. Дізнайтеся більше Ту Юю — китайська хімікиня та фармацевтка, лавреатка Нобелівської пре -
мії з медицини 2015 року за відкриття артемізиніна для лікування малярії.
Основою ліків є розроблений 1400 років тому метод традиційної китайської медицини. У медичному трактаті Ге Хун, який жив у IV столітті, запропонував використовувати для лікування малярії екстракт полину й описав процес його виготовлення.

Видавництво

За даними ООН 2021 року майже 828 мільйонів людей в усьому світі страждали від голоду. Що можна зробити для того, щоб усі люди мали достатню кількість їжі?
y Які обов’язкові компоненти має містити їжа?
y Для чого організму людини потрібні білки, жири, вуглеводи?
Із розвитком цивілізації змінювалися харчові традиції людей, впроваджувалися нові технологій виготовлення, обробки й зберігання їжі. Насамперед удосконалювалися способи виробництва харчових продуктів, що мали забезпечити продовольством населення, адже проблема голоду існувала завжди.
Голод — стан людини, за якого їй бракує їжі для життєдіяльності організму, а недоїдання — це стан, за якого організм не отримує належної кількості поживних речовин. Сьогодні до вирішення проблеми голоду залучена наукова спільнота провідних країн світу. До прикладу, проблему нестачі м’яса наука намагається вирішити шляхом його вирощування «у пробірці». Сучасні дослідження з отримання штучного м’яса розпочалися з експериментів НАСА (Національне управління з аеронавтики і дослідження космічного простору, США), де намагалися знайти найкращі варіанти харчування для астронавтів / астронавток у космосі. Від 2001 року розпочалися експерименти з виробництва м’яса з клітин індички (мал. 79.1).
У грудні 2020 року в сінгапурському ресторані відбувся перший у світі комерційний продаж м’яса, вирощеного з клітин.
Певна річ, такі експерименти мають як переваги, так і недоліки. Але розвиток і вдосконалення харчових технологій спрямовані на вирішення проблеми голоду на планеті.
Мал. 79.1. Схема експерименту НАСА
У розв’язанні продовольчої проблеми важливий внесок агрономії. Селекціонери й селекціонерки виводять нові сорти високоврожайних
сільськогосподарських культур, агрохімічна спільнота створює нові види добрив, що також підвищує врожайність.
Родючих ґрунтів на Землі не так багато, як потрібно людству. Тому сьогодні активно впроваджують технологію гідропоніки — вирощування рослин без ґрунту, коли рослина отримує всі

необхідні поживні речовини в потрібних кількостях через розчин (мал. 79.2).
Дослідження: розкладання харчових продуктів (хліба) бактеріями та грибами
Пліснява з’являється на хлібі в разі його тривалого зберігання. Її спричиняють бактерії і плісняві гриби, які потрапляють на хліб із навколишнього середовища. Мікроорганізми змінюють зовнішній вигляд, запах і смак хліба. Оптимальними умовами для розвитку плісняви є температура 25–35 °С і достатня вологість.
Для проведення дослідження вам знадобляться свіжий хліб і прозорий щільний пакет (краще із зіп-застібкою).
1. Візьміть невеликий шматок свіжого хліба. Змочіть водою руки й легенько зволожте хліб з обох боків.
2. Покладіть хліб у прозорий пакет, закрийте і залиште на декілька днів у теплому місці.
3. Спостерігайте за змінами, за можливості зафіксуйте їх на фотографіях. Пам’ятайте, що пліснявий хліб не можна вживати в їжу!
4. За результатами дослідження зробіть висновки.
Ключова ідея
Проблема нестачі продовольства — одна з найдавніших глобальних проблем людства. Метою сучасних харчових та агротехнологій є забезпечення їжею всіх людей на планеті.
Запитання і завдання
1. Наведіть приклади новітніх розробок у виготовленні харчових продуктів.

2. Чи можна вирощувати рослини без ґрунту?
3. Як можна збільшити врожайність рослин?
4. У чому переваги виготовлення штучного м’яса? Які недоліки?
Мал. 79.2. Поживні речовини для рослин продукують риби Дізнайтеся більше
5. Як пов’язані харчові та агротехнології з продовольчою проблемою?
6. За додатковими джерелами інформації підготуйте повідомлення про агротехнології майбутнього. Результат можна представити у вигляді ілюстрованої доповіді або презентації.
Володимир Моргун — Герой України, український генетик-селекціонер. Його роботи з вирощування нових сортів кукурудзи та створення нового типу напівкарликових сортів озимої пшениці започаткували «зелену революцію» в Україні.
Отримав перші в Україні трансгенні рослини кукурудзи, вивів 86 нових сортів і гібридів різних культур. А створена ним колекція злаків визнана національним надбанням.
Чи завжди розвиток цивілізації має позитивні наслідки?
y До чого може призвести посилення парникового ефекту?
y Що таке невідновлювані природні ресурси?
загадка
У 1958–1962 роках у Китаї була оголошена війна з горобцями, бо вони з’їдали багато зерна.
Горобці були знищені, але замість збільшення врожаю, навпаки, отримали його зменшення.
Яку роль відігравали ці птахи у природі? Яка ланка харчового ланцюга була порушена?
Людина є частиною природи. Проте від самого початку розвитку цивілізації люди намагалися впливати на навколишнє середовище, перебудовувати його для своїх потреб. Перші сільськогосподарські цивілізації змінили вигляд долин Нілу в Стародавньому Єгипті, Тигру та Євфрату в Стародавній Месопотамії, Янцзи та Хуанхе в Стародавньому Китаї та інших куточках нашої планети. Сьогодні людська діяльність призводить насамперед до забруднення природного середовища: атмосферного повітря, природних вод, ґрунтів тощо.
Неможливо уявити сучасний світ без потужного промислового виробництва. Одним із наслідків технологічних процесів є забруднення атмосфери. У повітря викидаються продукти згоряння вугілля, нафти, бензину, природного газу (мал. 80.1).
Транспорт забруднює атмосферу вихлопними газами, що містять шкідливі для здоров’я людини речовини. Через велику кількість автомобілів найбільше забруднене повітря у великих містах. Забруднення атмосфери негативно впливає на здоров’я людей. Наприклад, великі концентрації часток пилу можуть проникати в легені та спричиняти захворювання дихальних шляхів. У повітря потрапляють речовини, що можуть спричинити подразнення очей і носових проходів, а також підвищувати ризик захворювань серцевосудинної системи. Саме тому мешканці промислових районів частіше страждають на різноманітні захворювання, насамперед органів дихання.
Глобальне потепління
Мал. 80.1. Промислові підприємства та теплові електростанції щодня забруднюють атмосферу
Значні викиди парникових газів призводять
до посилення парникового ефекту, що спричиняє нагрівання нашої планети. Від ХVІІІ століття температура підвищилася в середньому на 0,7 °С. На перший погляд це дуже мало, але таке

майбутньогопідручникаВидавництво «Ранок»
потепління вже позначилося на змінах клімату в різних регіонах Землі (мал. 80.2). Так, в Україні влітку температури стають дедалі вищими. Через підвищення температури почали танути
льодовики Антарктиди та льодовий покрив Арктики. Зростає рівень Світового океану, тому зменшується площа, придатна для життя тварин у приполярних регіонах Землі (мал. 80.3).
Глобальною проблемою людства є великі обсяги сміття. Це побутове й будівельне сміття, відходи виробництва тощо. Зазвичай його звозять на спеціальні полігони — сміттєзвалища. Від звалищ, розташованих поблизу міст, поширюється неприємний запах. Вони є джерелом розмноження комах і гризунів, які є переносниками небезпечних захворювань.
Сьогодні, на жаль, лише невелику частину сміття переробляють на спеціальних заводах. Це переважно скло, метали, папір і пластик. У багатьох країнах, зокрема в Україні, установлюють окремі смітники для різних видів відходів (мал. 80.4).
Позначка на упаковці товарів означає можливість вторинної переробки цього пакування.



Шкідливі викиди промисловості потрапляють не лише в атмосферу, а й у води морів, річок, озер і ґрунтові води. Стічні побутові та промислові води забруднюють водойми, що негативно впливає на життєдіяльність їхніх мешканців. Залишки мінеральних добрив із дощовою водою потрапляють у річки й озера, де сприяють розвитку нетипових для цих водойм організмів. Через це зменшується біорізноманіття, порушується баланс водних екосистем.
Щороку у Світовий океан викидається 300–400 млн т сміття, що становить небезпеку для його мешканців. Риби, кити, дельфіни, тюлені, черепахи та інші тварини гинуть, ковтаючи сміття (мал. 80.5 на с. 21).
Мал. 80.2. Колись родючі землі через зміну клімату перетворюються на пустелю
Мал. 80.3. Танення полярного льоду скорочує ареал поширення білих ведмедів
Мал. 80.4. Наявність окремих сміттєвих баків полегшує сортування сміття для подальшої переробки

Мал. 80.5. Щороку до Світового океану потрапляють мільйони тонн сміття
Мал. 80.6 На гугл-мапі видно, якої «рани» Землі завдало видобування залізної руди у відкритому кар’єрі


ресурсів
1. Як людина впливає на навколишнє середовище?
2. Поясніть, як забруднення
довкілля впливає на людей.
3. Наведіть приклади наслідків глобального потепління.
4. Яку небезпеку для довкілля становлять сміттєзвалища?
5. Поясніть, із якою метою встановлюють окремі сміттєві баки для різних видів сміття. Чи є у вашому населеному пункті такі баки?
6. Висловіть своє ставлення до забруднення довкілля у вигляді есе, малюнка тощо.
Для своїх потреб люди видобувають корисні копалини: нафту, вугілля, газ, руду, будівельне каміння, пісок, глину тощо. Але їх видобуток і транспортування можуть негативно впливати на довкілля. Так, аварії на нафтових і газових родовищах, нафтових танкерах спричиняють екологічні катастрофи. Під час видобутку вугілля та руди утворюються величезні кар’єри та відвали породи, а порожнини в шахтах можуть спричинити просідання ґрунту та локальні землетруси (мал. 80.6).
Ключова ідея
Людська діяльність негативно впливає на довкілля. Забруднення атмосфери, спричинене промисловістю, енергетикою і транспортом, створює небезпечні умови для життя. Забруднення Світового океану загрожує мешканцям водойм. А видобуток природних копалин залишає «шрами» на поверхні нашої планети.
Дізнайтеся більше Одним із джерел парникових газів, зокрема метану, є розведення корів. Травлення рослинної їжі в багатокамерних шлунках цих тварин відбувається за допомогою численних бактерій і супроводжується виділенням великої кількості метану. Наукова спільнота Нової Зеландії — країни з дуже розвиненим тваринництвом — шукає шляхи зменшення викидів метану цією галуззю сільського господарства.
Видавництво «Ранок»


Людина була і є частиною природи. На планеті ми співіснуємо з мільйонами інших живих істот, але іноді ставимо себе вище за всіх. Згадайте лише вираз: «Людина— цариця природи!» (мал. 81.1). Так, люди розумні, уміють не лише пристосовуватися до навколишнього середовища, а й перетворювати, змінювати його для задоволення своїх потреб. Однак людина так само залишається лише частиною природи.
Технології, винайдені людством, здатні докорінно перетворювати природу. А безконтрольна господарська діяльність здатна завдати шкоди природі, спровокувати екологічні проблеми (мал. 81.2).
До прикладу, Україна завжди пишалася своїми чорноземами. Орні землі в деяких областях України сьогодні становлять понад 80 % території. Але це певною мірою погіршує стан природних вод, зменшує родючість ґрунту тощо.
Також актуальною є проблема порушення екосистем боліт і степової зони. На Поліссі за останні 100 років було осушено понад 1 млн га боліт. А площа степів, яка раніше становила 40 %
y Як людина втручається у природу? Чи завжди таке втручання позитивне?
y Від кого потрібно охороняти природу?
y Що таке біосфера?
y Що таке навколишнє середовище?
y Як відбувається забруднення атмосфери та гідросфери?
Мал. 81.2. Екологічні проблеми та шляхи їх вирішення
Мал. 81.1. Его-мислення
території України, за останні десятиліття скоротилася до кількох відсотків.
Мал. 81.3. Річка Десна
Станом на 1 січня 2020 року в Україні лише 6,77 % площі є природоохоронними територіями. Це території, створені з метою охорони природних ландшафтів від надмірних змін унаслідок господарської діяльності людини. Найважливішими з таких об’єктів є заповідники, національні парки, заказники. Загальна площа природно-заповідного фонду України становить 2,8 млн га. Стратегія з біорізноманіття Євросоюзу, заявку на входження до якого подала Україна, передбачає, що щонайменше 30 % території ЄС мають стати природоохоронними. Тому цей показник в Україні необхідно суттєво збільшити. Насамперед охоронний статус мають отримати українські праліси та природні ліси Карпат, природні луки вздовж Десни та Сейму, які знищуються посівами кукурудзи, соняшнику, рапсу тощо (мал. 81.3).


загадка
Джеральд Даррелл — британський зоолог, засновник Джерсійського тресту збереження диких тварин — сказав, що тварини й рослини є своєрідним барометром. Вони попереджають, що з екосистемою щось негаразд. Як саме вони це роблять?
Масова вирубка лісів, полювання, а також забруднення навколишнього середовища спричинили зменшення популяцій тварин, риб, рослин в усіх куточках Землі. За оцінками ООН, сьогодні близько мільйона видів організмів перебувають на межі вимирання. Згідно з дослідженням «Жива Планета 2020», з яким ви можете ознайомитись на сайті Всесвітнього фонду дикої природи (World Wildlife Fund, WWF), за останні 50 років чисельність популяцій ссавців, птахів, амфібій, рептилій і риб в усьому світі скороти-
Видавництво
через збільшення населення Землі, інтенсивну економічну діяльність і надмірне споживання природних ресурсів.
Наша держава видає закони, якими забороняються дії, що мають негативний вплив на природу, зокрема Закон України «Про охорону навколишнього середовища». Червона книга України — це основний документ, у якому узагальнено матеріали про сучасний стан рідкісних і таких, що перебувають під загрозою зникнення, видів тварин і рослин.
Зелена книга України акцентує увагу не на охороні окремих видів, а на збереженні біологічного різноманіття в цілому в межах певного рослинного угруповання. Вона містить 126 рідкісних і типових рослинних угруповань, що потребують охорони, як-от найбільший у Європі масив букових пралісів на Закарпатті, угруповання глечиків жовтих у Шацькому національному парку, угруповання ковили вузьколистої в Луганському природному заповіднику тощо.
Ключова ідея

Безконтрольна господарська діяльність здатна спровокувати певні екологічні проблеми. Природоохоронні території створені з метою охорони природних комплексів або об’єктів від надмірних змін під впливом людської діяльності. Червона книга України містить інформацію про окремі види рослин, грибів, тварин, які потребують охорони на державному рівні. Зелена книга акцентує увагу на охороні цілісних рослинних угруповань, що перебувають під загрозою зникнення.
1. Чим небезпечне споживацьке ставлення людини до природи?
2. У чому причина скорочення біорізноманіття в наш час?
3. До липня в Дунаї зазвичай відбувається скат молоді осетрових. Але 2020 року українські науковці та рибалки зафіксували лише поодиноких особин. Яка найбільш імовірна причина невдалої нерестової кампанії?
4. За можливості знайдіть на сайті «Червона книга України» https://redbook-ua.org/ представників рослинного і тваринного світу, що мешкають у вашому регіоні та створіть власну Червону чи Зелену книгу своєї місцевості.
5. Підготуйте лист від імені Природи, в якому вона звертається до людства за допомогою у вирішенні питання її захисту.
6. З’ясуйте ситуацію із забрудненням навколишнього середовища у вашому населеному пункті. Запропонуйте план дій із вирішення цієї проблеми. Презентуйте свою роботу в будь-який зручний спосіб.
Світлана Зиман — українська біологиня. Досліджувала рідкісні високогірні
рослини Українських Карпат у межах Карпатського біосферного заповідника та національного природного парку «Синевир». Підготувала тексти про 25 видів рідкісних високогірних рослин Карпат до нового видання Червоної книги України.
Дізнайтеся більше

y Чому сьогодні актуальною є проблема збереження довкілля?
y Чи потрібно нам сьогодні дбати про майбутні покоління?
y Назвіть базові потреби людини.
y Що таке «зелена енергетика»?
y У чому полягає глобальна продовольча проблема?
Кожне покоління людей на нашій планеті мало свої потреби — у їжі, питній воді, чистому повітрі, житлових умовах, забезпеченні прав і свобод, мирному співіснуванні, доступі до культурних цінностей і традицій тощо (мал. 82.1).
Для задоволення своїх потреб люди виготовляють необхідні продукти. Але кожне покоління має залишити достатній запас природних та економічних ресурсів для майбутніх поколінь. Тому задоволення цих потреб має здійснюватися з урахуванням впливу на довкілля.
Сталий розвиток — це такий шлях розвитку людства, що дає змогу задовольнити потреби нинішнього покоління без шкоди для можливості наступних поколінь задовольняти свої потреби. Наприклад, розвиток "зеленої" енергетики зменшує викиди шкідливих газів і має менший негативний вплив на довкілля.
Мал. 82.1. Базові потреби людини
До середини ХХ століття розвиток пов’язували лише з економічним прогресом. Сьогодні людство усвідомлює, що для забезпечення сталого розвитку потрібний еколого-економічний і соціальний баланс. Саме тому сталий розвиток називають збалансованим. Отже, основою сталого розвитку є економічні й екологічні інтереси суспільства та його соціальний прогрес. Порушення рівноваги між ними погіршує якість життя (мал. 82.2).
Глобальні цілі сталого
2015 року на саміті ООН були затверджені Глобальні цілі сталого розвитку. Ось декілька з них: подолання бідності в усьому світі, забезпечення всіх людей на планеті достатньою кількістю їжі та чистої води, доступ кожного до медичної допомоги, а також зменшення захворювань і смертності, забезпечення
Основи сталого розвитку
»
Мал. 82.2. Баланс між різними сферами людської діяльності є запорукою сталого розвитку
Мал. 82.3. Глобальні цілі сталого розвитку

всіх людей отримувати освіту, забезпечення рівних прав і можливостей для всіх людей, незалежно від статі, раси, національності й інших ознак, зменшення впливу на довкілля тощо.
2017 року до цієї ініціативи доєдналася й Україна та представила Національну доповідь «Цілі сталого розвитку: Україна» з урахуванням особливостей національного розвитку (мал. 82.3).
Ключова ідея
Головними принципами сталого/збалансованого розвитку
є поєднання збереження природи і розвитку суспільства; задоволення основних потреб людини; досягнення рівності та соціальної справедливості; забезпечення соціального самовизначення та культурного різноманіття; підтримання цілісності екосистем.
1. Як ви розумієте поняття «сталий розвиток»?
2. Чи можуть мешканці однієї країни чи континенту змінити ситуацію зі збереження природи та ресурсів усієї планети?

3. Чому для сталого розвитку необхідний баланс між сферами людської діяльності?

4. Складіть пам’ятку ваших щоденних дій, спрямованих на збереження ресурсів нашої планети.
5. Поясніть, як кожна із 17 цілей сталого розвитку впливає на зміни в майбутньому.
6. Які цілі є найбільш актуальними для вас / вашої родини / вашого міста / регіону? Поясніть свій вибір.
Дізнайтеся більше На сучасному етапі розвитку людство використовує таку кількість ресурсів, що для існування в найближчому майбутньому нам буде потрібно дві такі планети, як Земля. А іншої такої планети наразі не існує. Тому потрібно змінювати своє ставлення до природних ресурсів, щоб наші нащадки також могли жити на Землі.
1 У додаткових джерелах знайдіть інформацію про те, до яких рас мають належати батьки, якщо в них народжуються метиси, мулати, креоли або самбо.
2 До якого типу населених пунктів належить місце вашого постійного проживання? Яка густота вашого населеного пункту? Порівняйте її з середньою густотою населення України та світу станом на 2020 рік. Зробіть висновок про те, до густонаселених чи малозаселених територій належить ваше місце проживання.
3 Доповніть таблицю (за зразком), вписуючи види відходів, які потрібно класти у відповідні контейнери, і які не придатні до переробки.
можна
Пластик
не можна
Органіка
пляшки з під води
скляні пляшки з під олії
можна лушпиння овочів
не можна деревина
Папір
Скло
можна газети
не можна фотографії
можна бите скло
не можна дзеркала
можна консервні бляшанки
Метал
неможна використана фольга
Спеціальні
пункти прийому потрібно термометри
4 Закарпатська область єдина в
в бджолярів Закарпаття. Спрогнозуйте, якими будуть наслідки зникнення бджіл на Землі, зокрема для людства.
5 Складіть свою мапу думок або скористайтесь шаблоном.

6 Визначте, які з перелічених матеріалів та речовин є природними, а які — синтетичними.
Поролон, вовна, деревина, бетон, глина, скло, граніт, пластмаса, мед, папір, сталь, молоко.
7 Знайдіть у мережі Інтернет відомості про наукові дослідження, що виконуються за допомогою космічних обсерваторій. Підготуйте невелику доповідь про одне таке дослідження. Проілюструйте доповідь презентацією.
8 Різноманітні дослідження визначають, що середньостатистичний мешканець нашої країни продукує за місяць близько 8 кг побутових відходів. Оцінить масу побутових відходів нашої країни
за рік. Необхідну кількість населення України знайдіть самостійно.
9
Технологія — це певна послідовність дій, спрямована на отримання
бажаного результату / продукту, або використання певних
технічних, хімічних або інших засобів. Кожен може віднайти власніі технологіїї, приміром, смаження яєчні, виконання домашнього завдання, прибирання квартири тощо. Чи є у вас якась власна технологія, навіть маленька? Розкажіть про неї в есе.
10 У Світовому
Проєктна діяльність
Об’єднайтеся в групи, оберіть одну із запропонованих тем та виконайте проєкт. Результат роботи презентуйте у зручний для вас спосіб.
1. 5 проблем, які необхідно розв’язати людству, щоби вижити.
2. 5 проблем, до розв’язування яких потрібно залучити громаду мого

населеного пункту.
3. Культура — двигун сталого/збалансованого розвитку.
Ми занурюємося у світ природничих наук
y Назвіть три факти, які ви дізналися з розділу.
y Наскільки важливими є ті завдання, які ви виконали?
y Де ви зможете використати знання з вивченого розділу?
y Під час вивчення матеріалу ви досягли певних успіхів. Що ви робили для цього?
y Де вам знадобиться новий досвід?
y Із якими перешкодами ви зіткнулися під час опанування розділу?
y Як ви подолали труднощі?

